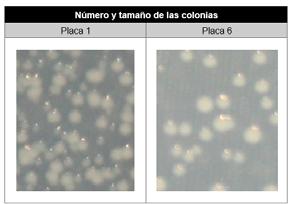
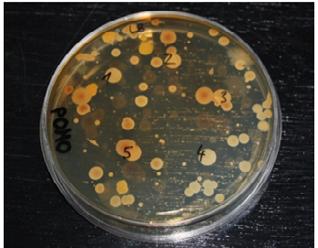

Posibles aplicaciones del óxido de grafeno para mejorar las complicaciones de los accesos venosos
8. BIBLIOGRAFÍA
Novoselov, K.S., Geim, A.K., Morozov, S.V., Jiang, D., Zhang, Y, Dubonos, S.V., Grigorieva, I.V., Firsov, A.A. (2004). ELECTRIC FIELD EFFECT IN ATOMICALLY THIN CARBON FILMS. Science, Vol. 306, [5696], pp. 666-669 . DOI: 10.1126/science.1102896. http://www.condmat.physics.manchester.ac.uk/pdf/mesoscopic/ publications/graphene/Science_2004.pdf
Rodríguez, A.; (Junio 2016) GRAFENO: SINTESIS, PROPIEDADES Y APLICACIONES BIOMÉDICAS. TFG, Facultad de Farmacia. UCM, Madrid
http://147.96.70.122/Web/TFG/TFG/Memoria/ALBA%20RODRIGUEZ%20VILLALON.pdf
Graphenano Nanotechnologies; (Julio 2017) EL GRAFENO: PROPIEDADES Y APLICACIONES
https://www.graphenano.com/uploads/2017/11/Que-es-el-grafeno.pdf
Bosch, D.; (2014) ESTUDIO, APLICACIONES Y OBTENCIÓN DEL GRAFENO. Trabajo Bachillerato. Escuela Vedruna, Girona
http://www.nanomadrid.es/wp-content/uploads/2014/10/Trabajo-del-Grafeno.pdf
ABC; (Actualizado:10/07/2015 11:51h) EL GRAFENO, UN NUEVO ALIADO EN LA LUCHA CONTRA EL CÁNCER. ABC Ciencia
https://www.abc.es/ciencia/20150710/abci-grafeno-quimioterapia-tratamientos-201507100919.html
Applynano Solutions; (Marzo 2018) QUÉ ES EL GRAFENO: DEFINICIÓN Y DESCRIPCIÓN
http://www.applynano.com/es/que-es-el-grafeno-definicion-y-descripcion/
The Graphene Box; MÉTODOS DE SÍNTESIS DEL ÓXIDO DE GRAFENO https://www.thegraphenebox.com/es/documentacion-tecnica/metodos-de-sintesis-del-oxido-de-grafeno-26
Bellido, J.C.; Carrascosa, M.I.; García, F.P.; Tortosa, M.P. (Mayo 2006) GUÍAS CLÍNICAS, CUIDADOS EN ACCESOS VENOSOS PERIFÉRICOS Y CENTRALES DE INSERCIÓN PERIFÉRICA. Complejo Hospitalario de Jaén
(CHJ) | http://www.index-f.com/evidentia/n9/218articulo.php
Gago, M.; García, F.;García, S.; Carrero, M.; (Directores académicos), (2018) ACTUALIZACIÓN DE CONOCIMIENTOS EN TERAPIA INTRAVENOSA. (pág 11). Hospital Vall d’ Hebron. Barcelona |
http://www.vygon.es/wp-content/uploads/sites/4/2015/08/terapia_intravenosa1.pdf
Tunkel, A.R.; (Mayo 2016) BACTERIEMIA. Warren Alpert Medical School of Brown University
https://www.msdmanuals.com/es-es/professional/enfermedades-infecciosas/biolog%C3%ADa-de-las-enfermedades-infecciosas/bacteriemia
Akhavan, O.; Ghaderi, E.; (2010) TOXICITY OF GRAPHENE AND GRAPHENE OXIDE NANOWALLS AGAINST BACTERIA. Institute for Nanoscience and Nanotechnology, Sharif University of Technology. Iran
https://pubs.acs.org/doi/10.1021/nn101390x
251
31º CERTAMEN JÓVENES INVESTIGADORES / Ciencias de la Tierra y la Vida
Hess, L.H.; Seifert, M.; Garrido, J.A.; (Julio 2013) GRAPHENE TRANSISTORS FOR BIOELECTRONICS. Institute of Electrical and Electronics Engineers |
https://arxiv.org/ftp/arxiv/papers/1302/1302.1418.pdf
Aguirre, J.A.; Rodríguez, N.; (Marzo 2017) CELL SURVIVAL AND DIFFERENTIATION WITH NANOCRYSTALLINE GLASS-LIKE CARBON USING SUBSTANTIA NIGRA DOPAMINERGIC CELLS DERIVED FROM TRANSGENIC MOUSE EMBRYOS. Departamento de Fisiología de la Facultad de Medicina, Universidad de Málaga
https://journals.plos.org/plosone/article?id=10.1371/journal.pone.0173978
Wells, J.; Kjaer, H.; Cooil, S.; Mazzola, F.; Hu, D.; Kjaervik, M.; Ramleth, E.; Trinh, T.; (Noviembre 2017) DEGRADATION OF THE CHEMOTHERAPY DRUG 5-FLUOROURACIL ON MEDICAL-GRADE SILVER SURFACES. Applied Surface Science, Elsevier
https://www.researchgate.net/publication/321329081_Degradation_of_the_chemotherapy_drug_5-fluorouracil_on_medical-grade_silver_surfaces
Muñoz, E.; (Septiembre 2016) EL GRAFENO: QUÍMICA Y APLICACIONES. Instituto de Carboquímica ICB-CSIC
http://www.gecarbon.org/boletines/articulos/BoletinGEC_041_art2.pdf
Dreyer, D.; Park, S.; Bielawski, C.; Ruoff, R.; (Noviembre 2009) THE CHEMISTRY OF GRAPHENE OXIDE. Department of Chemistry and Biochemistry, Department of Mechanical Engineering. The University of Texas at Austin |
https://pubs.rsc.org/en/content/articlehtml/2010/cs/b917103g
Fiorillo, M.; Verre, A.F.; Iliut, M.; Gandara, R.; Sotgia, F.; (Febrero 2015) GRAPHENE OXIDE SELECTIVELY TARGETS CANCER STEM CELLS, ACROSS MULTIPLE TUMOR TYPES: IMPLICATIONS FOR NON-TOXIC CANCER TREATMENT, VIA “DIFFERENTIATION-BASED NANO-THERAPY” MCCM, Institute of Cancer Science, University of Manchester, UK
http://www.oncotarget.com/index.php?journal=oncotarget&page=article&op=view&path%5B%5D=3348
Gago, I.; Molina, I.; León, G.; Miguel, B.; (Noviembre 2016) INTRODUCCIÓN
AL ESTUDIO DE LAS PROPIEDADES ANTIBACTERIANAS DEL GRAFENO. Departamento de Ingeniería Química y Ambiental, Universidad Politécnica de Cartagena
https://www.academia.edu/29975053/Posibles_aplicaciones_del_grafeno_como_bactericida
Liu, S.; Hu, M.; Zeng, T. H.; Wu, R.; Jiang, R.; Wei, J.; Wang, L.; Kong, J.; Chen, Y. (Julio 2012). LATERAL DIMENSION-DEPENDENT ANTIBACTERIAL ACTIVITY OF GRAPHENE OXIDE SHEETS. Langmuir.
https://pubs.acs.org/doi/10.1021/la3023908
Ji, H.; Sun, H.; Qu, X. (Octubre 2016). ANTIBACTERIAL APPLICATION OF GRAPHENE-BASED NANOMATERIALS. RECENT ACHIEVEMENTS AND CHALLENGES. Advanced Drug Delivery Reviews
http://dx.doi.org/10.1016/j.addr.2016.04.009
252
Posibles aplicaciones del óxido de grafeno para mejorar las complicaciones de los accesos venosos
Khan, M. S.; Abdelhamid, H. N.; Wu, H. F. (Marzo 2015). NEAR INFRARED (NIR) LASER MEDIATED SURFACE ACTIVATION OF GRAPHENE OXIDE NANOFLAKES FOR EFFICIENT ANTIBACTERIAL, ANTIFUNGAL AND WOUND HEALING TREATMENT. Colloids and Surfaces B: Biointerfaces.
https://www.sciencedirect.com/science/article/pii/S092777651400736X
Krishnamoorthy, K.; Umasuthan, N.; Mohan, R.; Lee, J.; Kim, S. J. (Noviembre 2012b). ANTIBACTERIAL ACTIVITY OF GRAPHENE OXIDE NANOSHEETS. Science of Advanced Materials.
https://www.researchgate.net/publication/235327332_Antibacterial_Activity_of_Graphene_Oxide_ Nanosheets
Krishnamoorthy, K.; Veerapandian, M.; Zhang, L.; Yun, K.; Kim, S. J. (Julio 2012a). ANTIBACTERIAL EFFICIENCY OF GRAPHENE NANOSHEET AGAINST PATHOGENIC BACTERIA VIA LIPID PEROXIDATION. The Journal of Physical Chemistry C
https://pubs.acs.org/doi/abs/10.1021/jp3047054
Wang, Y; Wu, S; Zhao, X; Su, Z; Du, L; Sui, A. (2007). IN VITRO TOXICITY EVALUATION OF GRAPHENE OXIDE ON HUMAN RPMI 8226 CELLS. Department of Hematology, Medical College of Qingdao University, China
https://www.ncbi.nlm.nih.gov/pubmed/25226897
Pelin, M; Fusco, L; León, V; Martín, C; Criado, A; Sosa, S; Vázquez, E; Tubaro, A; Prato, M. (Enero 2017) DIFFERENTIAL CYTOTOXIC EFFECTS OF GRAPHENE AND GRAPHENE OXIDE ON SKIN KERATINOCYTES. Department of Life Sciences, University of Trieste, 34127 Trieste, Italy
https://www.nature.com/articles/srep40572
Orecchioni, M.; Bedognetti, D.; Newman, L.; et al. (Octubre 2017) SINGLE-CELL MASS CYTOMETRY AND TRANSCRIPTOME PROFILING REVEAL THE IMPACT OF GRAPHENE ON HUMAN IMMUNE CELLS. Department of Chemistry and Pharmacy University of Sassari, Italy
https://www.nature.com/articles/s41467-017-01015-3
LINK AL TRABAJO COMPLETO Academia.edu:
https://www.academia.edu/40701925/Posibles_aplicaciones_del_óxido_de_grafeno_para_mejorar_ las_complicaciones_de_los_accesos_venosos?source=swp_share
253
de Cataluña
/ ACCESIT
AUTORA | ITZIAR LARUMBE BELLOSTES
COORDINADORA | MARÍA DEL ROSER LÓPEZ DE ZAMORA USÓN
CENTRO | IES MARIUS TORRES
CIUDAD | LLEIDA
RESUMEN |
Una especie exótica invasora (EEI) puede traer consecuencias muy graves para un ecosistema. Por este motivo, he abordado el tema de las EEI en Cataluña, escogiendo para ello una de las 100 especies más dañinas y que generan más impacto en sistemas de todo tipo: el mejillón cebra.
El trabajo se estructura en tres bloques: primeramente he llevado a cabo una búsqueda de información de las EEI en general y particularmente del mejillón cebra para conocer la especie, así como he entrevistado a biólogos y expertos en el bivalvo. Seguidamente he realizado un muestreo en un embalse de la plana de Urgell (Lleida), donde se hizo un tratamiento de agua oxigenada y vinagre en 2017, y se quería ver si, un año después, el tratamiento fue efectivo. Finalmente, he hecho una modelización que me ha permitido conocer las zonas de Cataluña por donde puede expandirse el mejillón y ver las capacidades de aplicación a otros EEI. Hay varias herramientas de modelización, yo he optado por el programa MAXENT. Este programa compara la presencia de citaciones del animal (lugar donde se encuentra el mejillón) con una serie de mapas de parámetros en un territorio como lo es Cataluña. Según la relación entre los parámetros y la localización actual de la especie, el programa es capaz de realizar un mapa general previsible de presencia por todo el territorio considerado, en este caso, Cataluña. De esta manera he podido saber en qué áreas sería de vital importancia aplicar medidas de prevención y así evitar grandes pérdidas económicas y medioambientales.
El mejillón cebra, Dreissena polymorpha. Biología y modelización de la distribución por las aguas continentales
CIENCIAS DE LA TIERRA Y LA VIDA 254
ABSTRACT |
An invasive alien species (IAS) can have very serious consequences for an ecosystem. For this reason, I have addressed the issue of IAS in Catalonia, choosing for this one of the 100 most harmful species and that generate more impact on systems of all kinds: the zebra mussel.
The work is structured in three blocks: first, I have carried out a search for information on the IAS in general and particularly the zebra mussel to know the species, as well as interviewing biologists and experts in the bivalve. Next, I carried out a sampling in a reservoir of the Urgell plan where a treatment of oxygenated water and vinegar was made in 2017 and we wanted to see if the treatment was effective. Finally, I have done a modeling that has allowed me to know the areas of Catalonia where the mussel can expand and see the application capabilities to other IAS. There are several modeling tools, I opted for the MAXENT program. This program compares the presence of citations of the animal (where the mussel is located) with a series of parameter maps in a territory such as Catalonia. According to the relationship between the parameters and the current location of the species, the program is capable of making a general predictable map of presence throughout the territory considered, in this case, Catalonia. In this way I have been able to know in which areas it would be of vital importance to apply preventive measures and thus avoid great economic and environmental losses.
255
31º CERTAMEN JÓVENES INVESTIGADORES / Ciencias de la Tierra y la Vida
1.INTRODUCCIÓN
En Cataluña en particular, las EAI son un problema creciente. La prueba es que la Generalitat ha tenido que generar una página llamada EXOCAT (http://exocatdb.creaf.cat/base_dades/) sobre la presencia de EAI que cuenta ya con más de 1.270 especies, lo que da una idea de la magnitud del problema durante los próximos años. Por este motivo, me ha parecido oportuno abordar en mi Trabajo de Investigación el tema de las EAI en Cataluña, escogiendo para ello una de las especies que todos los expertos coinciden en que puede ser más nociva y generar más impacto en sistemas de todo tipo: el mejillón cebra.
2. HIPÓTESIS Y OBJETIVOS
2.1. HIPÓTESIS
• Cuando hay un animal alóctono en un territorio con unas condiciones medioambientales y hábitat determinados hay una probabilidad alta de que este se expanda hacia los territorios con las mismas condiciones ambientales o similares.
• Se pueden prever las zonas más propensas a ser colonizadas por mejillón cebra.
• Los muestreos son una buena técnica preventiva contra el mejillón cebra
• El mejillón cebra, con su propagación, afecta al medioambiente y a sectores económicos estratégicos.
2.2. OBJETIVOS
• Obtener un conocimiento exhaustivo del mejillón cebra para aplicarlo en la modelización en la parte práctica II.
• Averiguar los lugares hacia donde es más posible que la especie del mejillón cebra se expanda durante los próximos años.
• Saber interpretar los resultados de los mapas y gráficos obtenidos.
• Prever los impactos que puede causar en zonas determinadas.
• Estudiar estrategias de reducción del impacto y de prevención por la posible invasión del mejillón cebra en las masas de agua de Cataluña.
• Aprender a utilizar herramientas y programas informáticos de estadísticas MAXENT y ARCGIS: modelos predictivos de distribución de especies.
3. MARCO PRÁCTICO I: MUESTREO EN EL CANAL DE URGELL
El año pasado (2017) se hizo un tratamiento de agua oxigenada y vinagre en la zona de la plana de Urgell. Un año después (2018) se quiere ver si el tratamiento ha sido efectivo. El objetivo concreto en este embalse es recoger muestras de agua en un medio acuífero con el fin de detectar si dentro de este hay larvas de mejillón cebra. Se llevarán a cabo diferentes recogidas de agua de la balsa, tanto
256
El mejillón cebra, Dreissena polymorpha. Biología y modelización de la distribución por las aguas continentales de Cataluña de la parte superior (en el embalse) como de la inferior (en la arqueta).
3.1. MATERIAL
- Bomba de extracción de agua - Generador
- Dos mangueras
- Cuerda
- Contador eléctrico de litros
- Filtro de 50 micras
- Pote esterilizado - Cubo
- Agua destilada
- Peróxido
- Pote de formol - Cuentagotas
- Centrifugadora
- Cuentagotas
- Contraste de fases
- Placas de Petri
- Microscopio de contraste de fases - Cuatro vasos centrífugos
3.2. METODOLOGIA
1. La recogida de agua en la arqueta y recogida de agua en el embalse: Recoger una cantidad de agua suficiente, para tener la seguridad de que en caso de haber larvas circulantes, alguna debe estar en la cantidad de litros recogido. En nuestro caso se recogen 200L en la arqueta y 200L en el embalse. Una vez recogida la muestra, filtrar el agua para que toda partícula por encima de las 50 micras quede en un pequeño bote.
2. Limpieza del equipo: Como posiblemente habrán quedado larvas de mejillón en el material, limpiar el material con peróxido para evitar la contaminación a otras aguas.
3. Observación de las muestras: Someter las muestras a un centrifugado, separando la parte del agua limpia de los posos donde quedan las larvas que hubiera. Finalmente, examinar el poso concentrado a través un microscopio de contraste de fases, ya que se ha comprobado que la luz polarizada deja evidente una marca cálcica peculiar que tienen las larvas de mejillón cebra, pudiéndose así no sólo determinar la presencia de estas larvas, sino también su abundancia por litro de agua recogido.
4. MARCO PRÁCTICO II: MODELIZACIÓN DE LA EXPANSIÓN DEL MEJILLÓN CEBRA EN CATALUÑA
La modelización es una herramienta informática que se está convirtiendo indispensable para el trabajo de prevención y erradicación de EEI, ya que permite optimizar medidas de gestión donde se pueda prever que las especies invasoras
257
31º CERTAMEN JÓVENES INVESTIGADORES / Ciencias de la Tierra y la Vida
alcanzarán las máximas densidades y, en consecuencia, generarán los efectos nocivos.
Hay varias herramientas de Modelización, yo he optado por el programa MAXENT, que es una aplicación relativamente poco complicada que se ha utilizado para hacer otras modelizaciones en Cataluña.
4.1. MATERIAL
• APLICACIÓN ArcMap 10.5: Se ha utilizado para transformar los datos de las variables que posteriormente introduciré al MAXENT a formato Raster, el formato con el que trabaja MAXENT.
• PROGRAMA MAXENT: Es el programa que lleva a cabo la modelización. A partir de las citaciones y los parámetros nos proporciona un conjunto de gráficas, tablas y mapas que nos advierten de la distribución potencial del mejillón cebra.
• CITACIONES - SITIOS CON PRESENCIA DE MEJILLÓN CEBRA: Para modelizar la presencia de mejillón cebra debemos partir de un mapa de datos de presencia detectadas.
• MAPAS DE LOS PARÁMETROS: También se ha partido de los parámetros restrictivos o favorecedores para la presencia del mejillón cebra. El trabajo se ha centra en la obtención de los siguientes parámetros: temperatura media del agua, pH, concentración de materia orgánica disuelta (condiciona la nutrición del animal), concentración de calcio disuelto y conductividad.
4.2. METODOLOGÍA
1. Recopilación de datos: El programa MAXENT necesita dos ficheros. Por un lado necesita un registro de muestras encontradas dentro del territorio que se quiere estudiar (en este caso es Cataluña), y por otro un registro de los factores que condicionan la presencia de la especie también de Cataluña. Con estos datos, el programa nos mostrará los lugares del territorio donde existen condiciones óptimas por el mejillón, por lo tanto, los más propensos a ser colonizados.
a. Obtener datos de dónde se encuentra el mejillón cebra en Catalunya – en la web exocat
b. Obtener datos de parámetros que condicionan la presencia del mejillón cebra – proporcionados por la agencia catalana del agua.
2. Adecuación de datos para su posterior introducción al MaxEnt: MAXENT, como todos los programas informáticos, trabaja con un formato determinado de archivos. Por lo tanto, transformar las citaciones, que estan en formato base de datos DBF en CSV separado por comas, y los parámetros en formato excel XLS en formato TEXTO (ASCII).
3. Introducción de los datos al MaxEnt
258
El mejillón cebra, Dreissena polymorpha. Biología y modelización de la distribución por las aguas continentales de Cataluña
5. RESULTADOS
5.1. RESULTADOS DEL MUESTREO
Se ha detectado la presencia de ejemplares de larvas de mejillón cebra en el embalse donde se llevó a cabo el muestreo, por lo tanto, también hay mejillón cebra adulto.
Sin embargo, después de hacer el recuento de las larvas que se han obtenido en las muestras del embalse, la hemos comparado con el número de larvas que se encontraron en el mismo embalse del año pasado (2017) y hemos visto que la concentración de larvas ha disminuido desde el último muestreo, el cual se hizo antes de hacer la limpieza con agua oxigenada y vinagre. Por este hecho, podemos concluir que la razón de esta disminución de la concentración del número de larvas en el agua es debido a esta limpieza.
5.2. RESULTADOS DE LA MODELIZACIÓN
Después de introducir los datos en el programa MAXENT los resultados obtenidos son los que se muestran a continuación:
Análisis pormenorizado de las variables (jacknife)
Figura 01
Análisis pormenorizado de las variables.
Fuente: propia.
La barra roja nos muestra que el modelo, llega a un nivel de significación del 0.91 (91%). Esto indica que el modelo, con estas variables, tiene un alto nivel predictivo. Por lo tanto, la inclusión de nuevos parámetros en la modelización no aportará una mayor fiabilidad al modelo, por el que podemos darlo por significativo y fiable. El análisis del gráfico también indica que hay tres factores que condicionan más intensamente la presencia y densidad del mejillón cebra en una zona una vez la haya colonizado: calcio, materia orgánica disuelta y pH.

Response curves
CALCIO (mg de CaCO3 / L)
El rango más interesante para la presencia del MC está entre los 100-150 mg de Carbonato Cálcico por litro de agua. Estas condiciones se dan en toda Catalu-
259
31º CERTAMEN JÓVENES INVESTIGADORES / Ciencias de la Tierra y la Vida
ña excepto los extremos más bajos y los más altos: Pirineos y en las zonas de Cataluña Central.
CONDUCTIVIDAD (μS / cm)
Las aguas que presentan una conductividad por debajo de los 1.000 μS / cm no son muy aptos para el animal, como ocurre con las zonas pirenaicas. Pero a partir de llegar a estos niveles de conductividad, no parece ser un factor que incida mucho en la presencia del mejillón cebra.
pH
Las aguas serán poco aptas para este hasta que no lleguen a un pH de 7,5. Este hecho que podría parecer un factor limitante muy determinante, no lo es tanto en Cataluña, ya que la mayoría de nuestras aguas tienen un pH por encima de este 7’5, excepto en los Pirineos axiales.
TEMPERATURA (° C)
El mejillón cebra muestra predilección por temperaturas entre 11 y 15 grados. Estas temperaturas óptimas, en Cataluña se encuentran en buena parte del territorio menos el Pirineo y la veguería de Barcelona.
MATERIA ORGÁNICA (TOC, total organic carbon) (mg C / L)
El rango óptimo de su presencia oscila entre 1 y 5 mg C / L. A partir de este nivel se reduce hasta que desaparece por completo. En Cataluña, las zonas que tienen la MO óptima para el mejillón cebra cubren la mayoría de territorio, excepto Tarragona.
Mapa resultante del análisis y la modelización de Cataluña

260
Figura 02
Mapa de la distribución del MC en Cataluña. Fuente: propia.
El mejillón cebra, Dreissena polymorpha. Biología y modelización de la distribución por las aguas continentales de Cataluña
Atendiendo al análisis previamente efectuado y en función de los parámetros existentes en los ríos, MAXENT realiza un mapa de Modelización de la posible ocupación del mejillón cebra tras transcurrir el tiempo necesario.
El mapa obtenido de la modelización se puede dividir en zonas como se ven en la anterior imagen. En particular una serie de seis zonas presentan una alta potencialidad para la presencia de mejillón cebra (color amarillo) y otras cinco una muy alta potencialidad (color marrón). Estas últimas cinco zonas son muy relevantes y es donde se debería aplicar una especial atención en la lucha contra este animal invasor. Es una superficie que sobrepasa los 4.560 km2, que representa el 14% del territorio catalán.
Con el fin de probar la veracidad del modelo, MAXENT realiza un análisis representado en un gráfico:
Porcentaje de superficie del modelo tomado en base a las áreas de máxima probabilidad hasta las de menor probabilidad. Fuente: propia.
El significado de este gráfico se encuentra en la relación entre el porcentaje de citaciones (eje de las ordenadas) y la superficie prevista de máxima probabilidad según el modelo (eje de abscisas).
Para calcular el porcentaje de fiabilidad de los resultados que nos da y MAXENT, calcularemos el área que se encuentra bajo las curvas, en ángulos Area Under Curve (AUC). En nuestro caso, la valoración con los datos con las que hemos realizado el modelo básico alcanza el 88’5% (área bajo la curva roja). Incluso se supera el 91% si hacemos el mismo análisis para los datos del test (un 25% de los datos totales escogidas al azar), lo que ya había sido señalado en el análisis Jacknife. Nuestro modelo tiene un gran nivel de fiabilidad de predicción. Estos niveles de significación son suficientes para considerar fiable el modelo y obtener conclusiones.

6. CONCLUSIONES
Erradicar el mejillón cebra es a día de hoy imposible en masas de agua naturales una vez se ha instalado en ellas, los efectos de su propagación pueden afectar a la diversidad biológica, a la extinción de especies nativas, e incluso,
261
Figura 03
CERTAMEN JÓVENES INVESTIGADORES / Ciencias de la Tierra y la Vida
puede llegar a cambiar el paisaje. Por esto es necesario una actuación que debe orientarse hacia la prevención de su expansión y la mitigación de los impactos. Los muestreos, como se ha podido ver, es un ejemplo de las técnicas útiles para prevenir el mejillón cebra.
6.1. CONCLUSIONES DE LA MODELIZACIÓN
Como se ha podido ver gracias al programa MAXENT, cuando un animal como el mejillón cebra se encuentra en un territorio con unas condiciones medioambientales y hábitat determinados hay una probabilidad alta de que este se expanda hacia los territorios con las mismas condiciones ambientales o similares. También se han podido prever estas zonas con las condiciones ambientales óptimas para la supervivencia del mejillón cebra hacia las cuales es más posible que sean colonizadas por el bivalvo.
El modelo territorial nos indica que no toda Cataluña presenta la misma aptitud para la presencia del mejillón cebra. En el mapa siguiente se ven indicadas las cinco zonas con mas probabilidades de ser colonizadas por el animal invasor (zonas en rojo) y otras seis zonas de importancia secundaria (en amarillo).
Mapa per zonas de la aptitud per a la presencia del mejillón cebra. Fuente: propia.

ZONA 1: RIBERA DEL EBRO
Toda la zona de la Ribera del Ebro, con el centro en Flix, presenta una alta vulnerabilidad para la presencia de mejillón cebra. Si el mejillón cebra llega a colonizar esta zona nos encontramos con dos tipos de actividades humanas que se verán muy afectadas: una amplia zona agrícola de regadío, que se verá muy afectada ya que el mejillón cebra colapsará los canales de riego y algunas industrias, en particular la Central Nuclear de Ascó y su sistema previsto de refrigeración.
262
31º
Figura 04
El mejillón cebra, Dreissena polymorpha. Biología y modelización de la distribución por las aguas continentales de Cataluña
ZONA 2: COMARCA DE BALAGUER
Toda la zona agrícola de Balaguer es también muy propensa a la presencia del mejillón cebra. En los sistemas de riego debe plantearse poner filtros para garantizar la no entrada de larvas de mejillón cebra. Esto puede representar fuertes inversiones que encarecerían los productos. La alternativa de no hacerlo puede representar unas consecuencias muy graves para el sector primario en Lleida.
ZONA 3: AREA DE MANRESA
Manresa, ligada al río Llobregat, parece ser también muy apta para la presencia de mejillón cebra. En la zona de Manresa se encuentran más de 500 empresas, muchas de ellas utilizan el agua para la producción. El trabajo de prevención en este importante foco industrial puede convertirse en vital para la zona, ya que pueden causar la obstrucción parcial o total de rejas, conducciones de agua y equipos de bombeo entre otros. También pueden sobre calentar los cirquitos de refrigeración.
ZONA 4: ZONA DE VALLMANYA
Vallmanya, de unos 260 km2, mostró también una mayor predisposición a la presencia del mejillón cebra. Para solucionar el problema debe plantearse poner filtros en los sistemas de riego para garantizar la no entrada de larvas de mejillón cebra. Aunque esto represente una fuerte inversión, la alternativa de no hacerlo puede representar unas consecuencias muy graves para el sector primario.
ZONA 5: SUBCONCA DEL CARDENER (LA COMA)
La zona de La Coma, cerca del río Cardener, también se da unos condicionantes propicios que justifican la presencia del mejillón. El río Cardener atraviesa pueblos de atractivo turístico (Port del Compte, St. Llorenç de Morunys, Cardona), y las actividades de ocio relacionadas con el agua podrían verse afectadas. También se podrán ver afectadas las 5 estaciones de aguas residuales domésticas que se encuentran en su cuenca debido al fouling.
ZONAS 6, 7. 8, 9, 10 Y 11
Tras estas cinco zonas principales pueden determinarse otras seis zonas de importancia secundaria, es decir, que no tienen una probabilidad tan alta de ser colonizada como la de las zonas anteriores, aunque esta siga siendo bastante elevada.
Zona 6: zonas de regadío alrededor de carrascal a la frontera con la comunidad valenciana; zona 7: comarca del penedés; zona 8: castelldefels; zona 9: área de
263
31º CERTAMEN JÓVENES INVESTIGADORES / Ciencias de la Tierra y la Vida
girona, en el entorno del fluvià; zona 10: bahía de roses, alrededor de empúria brava; zona 11: olot.
ZONAS CON BAJA SUSCEBILIDAD DE PRESENCIA DEL MEJILLÓN
Se puede observar que también hay zonas no susceptibles para la presencia de mejillón cebra. La franja pirenaica y buena parte de la pre pirenaica muestran temperaturas del agua por debajo los 10 e incluso los 9 grados, lo que dificulta mucho la implantación del mejillón cebra. Contribuyen a ello un pH más ácido, por debajo de 8, una baja conductividad y una baja concentración de Calcio.
6.3. RESUMEN
• El rango óptimo para la presencia del bivalve está entre 50 y 200 mg de CaCO3/L.
• Las aguas con una conductividad más apta son las de a partir de 1.000 μS/cm.
• El pH óptimo del mejillón cebra es a partir del 7’5. Este condiciona en un grado muy alto la presencia del mejillón pero como generalmente las aguas continentales de Cataluña tienen un pH óptimo este factor no será tan condicionante en nuestro territorio.
• El mejillón muestra predilección por temperaturas de agua entre 11 y 15°C.
• El rango óptimo de materia orgánica disuelta en el agua es entre 1 y 5 mg C/L.
• En Cataluña encontramos una serie de cinco zonas que tienen muy alta potencialidad para la presencia de mejillón cebra. En estas es donde se debería aplicar una especial atención en la lucha contra este animal invasor. Estas zonas se encuentran en la Ribera del Ebro, en la comarca de Balaguer, a la del área de Manresa, a Vallmanya y la subcuenca del Cardoner.
• En Cataluña también encontramos otras seis zonas que presentan una alta potencialidad para la presencia del animal invasor.
• La franja pirenaica de Cataluña y buena parte de la prepirenaica es una zona con baja susceptibilidad de presencia de mejillón cebra.
• Los impactos causados el mejillón cebra en Cataluña son: colapso de los canales de riego, colapso del circuito del sistema de refrigeración en industrias como la Central Nuclear de Ascó, obstrucción parcial o total de rejas, conducciones de agua y equipos de bombeo entre otros y pérdida de atractivo turístico.
264
El mejillón cebra, Dreissena polymorpha. Biología y modelización de la distribución por las aguas continentales de Cataluña
BIBLIOGRAFIA
Murphy, T. (2008). Dreissena polymorpha.
https://animaldiversity.org/accounts/dreissena_polymorpha/ Álvarez, R. (2010). Diez preguntas y respuestas fundamentales sobre la presecia del mejillón cebra en España.
http://www.naturalezadearagon.com/fauna/mejillon.php
Wikipedia. (2018). Zebra mussel. https://en.wikipedia.org/wiki/zebra_mussel Confederación hidrográfica del Ebro. (2006, Septiembre). Características generales de la biología y el comportamiento del mejillón cebra.
www.chebro.es/contenido.streamFichero.do?idBinario=9943
Cia Abaurre, I. (2008). Ecología del mejillón cebra (Dreissena polymorpha) en el tramo inferior del río Ebro. Problemática y posibilidades de control.
http://www.anhidra.com/Publicaciones/Entradas/2008/10/20_La_tesis_doctoral_sobre_el_mejillon_ cebra_(Dreissena_polymorpha)_files/MEJILLON_CEBRA_INT.pdf
Agencia Vasca del Agua.(2011, Diciembre) Asistencia técnica en relación a la Susceptibilidad de las masas de agua de la Comunidad Autónoma del País Vasco al asentamiento del mejillón cebra (Dreissena polymorpha)
http://www.uragentzia.euskadi.eus/u81-000376/es/contenidos/informacion/invasoras_mejillon_cebra_2014/es_def/adjuntos/0%20memoria.pdf
Agencia Vasca del Agua. (2009) Asistencia técnica para el control larvario de Dreissena polymorpha en aguas del país vasco.
http://www.uragentzia.euskadi.eus/u81-000376/es/contenidos/informacion/invasoras_mejillon_cebra_2014/es_def/adjuntos/MC_URA_2009_deteccion_larvas_cast.pdf
Agencia Vasca del Agua. (2014) Evaluacióndelimpactocausadoporelmejillón cebra (dreissena polymorpha) sobre las poblaciones de bivalvos autóctonos en el sistema de embalses del zadorra (urrúnaga y ullíbarri-gamboa)
http://www.uragentzia.euskadi.eus/u81-000376/es/contenidos/informacion/invasoras_mejillon_cebra_2014/es_def/adjuntos/nayades_2014.pdf
Arenas Camps, M. (2015, 23 de Julio). ¿Quéesunaespecieexóticayunainvasora?
https://allyouneedisbiology.wordpress.com/2015/07/23/especies-exotica-invasora/
IAGUA. (2017) El Dreissena polymorpha. Lo que debes conocer de esta especie invasora
https://www.iagua.es/noticias/espana-brasil-portugal/technoymar-soluciones/17/04/28/dreissena-polymorpha-lo-que-debes
Agencia Vasca del Agua. (2018, Marzo) Plan de acción para el control del mejillón cebra en la Comunidad Autónoma del País Vasco.
http://www.uragentzia.euskadi.eus/u81-000376/es/contenidos/informacion/invasoras_mejillon_cebra_2014/es_def/adjuntos/Plan_MC_2018-2020.pdf
265
31º CERTAMEN JÓVENES INVESTIGADORES / Ciencias de la Tierra y la Vida
Durán, C; Montoro, C; Maña, M. (2017) Plan de choque contra la invasión del mejillón cebra en la confederación hidrográfica del Jucar 2017-2021
https://www.chj.es/es-es/medioambiente/mejilloncebra/Documents/Plan%20de%20choque%20mejill%C3%B3n%20cebra%20Fase%20I%202017%20Nov%2020.pdf
Dogc. (2010, 15 de Noviembre) Pla especial de protecció del medi natural i del paisatgedelsespaisnaturalsprotegitsdelaplanadeLleidaielPladegestió d’aquests espais. http://mediambient.gencat.cat/web/.content/home/ambits_dactuacio/patrimoni_natural/senp_catalunya/ espais_sistema/n707_docs_comuns/acord_gov_185_2010.pdf
Esri. (2016) Qué es ArcMap.
https://desktop.arcgis.com/es/arcmap/10.3/main/map/what-is-arcmap-.htm
266
267
Análisis de las propiedades bactericidas de la plata
/ ACCESIT
AUTORES | ADRIÁN GIL KORILIS, JAVIER GONZÁLEZ DE ECHÁVARRI ORBAIZ Y MIHAIL COJOCARU
COORDINADOR | PABLO ALVIRA IRAIZOZ
CENTRO | CC SAN IGNACIO
CIUDAD | PAMPLONA-NAVARRA
RESUMEN |
La resistencia adquirida a antibióticos por parte de las bacterias ha hecho que cada vez un mayor número de estas sustancias se tornen inefectivas. Por lo tanto, resulta imprescindible determinar nuevos materiales que puedan sustituir a aquellos cuyas funciones son ya nulas. La presente investigación se llevó a cabo con el objetivo de constituir la plata como un componente habitual de los antibióticos, partiendo de sus ya conocidas propiedades bactericidas. El método experimental utilizado fue el conocido como antibiograma disco-placa o método Kirby-Bauer. En el proceso experimental la plata se usó en forma de plata coloidal, mientras que la bacteria Escherichia coli fue utilizada como material biológico. Finalmente, se determinó que la actividad antibacteriana del metal era observable a partir de los 50 mg/L. El equipo de investigación, formado por alumnos del Colegio San Ignacio Jesuitas Pamplona, llevó a cabo este estudio entre los meses de octubre de 2018 y enero de 2019, teniendo lugar parte de la fase experimental en los laboratorios de Ciencias del Medio Natural de la Universidad Pública de Navarra (UPNA).
268
CIENCIAS DE LA TIERRA Y LA VIDA
ABSTRACT |
The resistance that some bacteria have acquired to antibiotics means that an increasing number of these substances is turning ineffective. Therefore, it is essential to find new materials that can replace those that do not work anymore. The present investigation was carried out with the objective of making silver a usual component of antibiotics, starting from its already known bactericidal properties. The experimental method used is known as the diskplate antibiogram or Kirby-Bauer method. In the experimental process, silver was used in colloidal form, while Escherichia coli was used as the biological material. Finally, it was determined that the antibacterial activity of the metal was observable at a concentration of 50 mg/L. The research team, made up of students from the San Ignacio Jesuitas Pamplona School, carried out this study between October 2018 and January 2019, and a part of the experimental work took place in the laboratories of Natural Sciences of the Public University of Navarra (UPNA).
269
31º CERTAMEN JÓVENES INVESTIGADORES / Ciencias de la Tierra y la Vida
1. INTRODUCCIÓN Y ANTECEDENTES
Las propiedades antibacterianas de la plata se conocen desde la antigüedad, dado que este material se lleva utilizando con fines médicos desde la Edad Antigua. En la Grecia Clásica ya se usaba un polvo obtenido a partir de este metal como bálsamo para heridas o como desinfectante de recipientes de almacenaje de alimentos. Sin embargo, no tardó en observarse que si era ingerida podía llegar a resultar tóxica, por lo que se redujo su uso a simples aplicaciones tópicas. En el siglo XIX se descubrió que su absorción por parte de los tejidos humanos es limitada. La introducción de los antibióticos en la década de 1940 contribuyó a que la plata mantuviese su campo de actuación tópico, como pomadas para quemaduras y heridas [www.smith-nephew.com].
La acción bactericida de la plata está relacionada con los radicales libres de oxígeno (O2.-), los cuales son productos normales del metabolismo de toda célula. Al estar cargados negativamente, pueden unirse a proteínas y causar daños, aunque es cierto que la propia célula posee mecanismos para eliminarlos. La plata es capaz de alterar los procesos de producción de radicales libres, provocando tal aumento de la producción de O2.- que la bacteria no es capaz de eliminarlos. Por lo tanto, tras sufrir inflamaciones y daños en el ADN el microbio acaba por morir [Huma et al, 2018; Dayem et al, 2017; www.cun.es]. Para el año 2025 se prevé la producción de más de 800 toneladas de plata, formando parte de más de 1800 productos diferentes. Sin embargo, sólo una proporción muy pequeña de este volumen será destinada al campo de los antibióticos. Esto es debido, como ya se ha mencionado anteriormente, a que la plata puede llegar a ser tóxica para el ser humano.
El desarrollo de sistemas de medición capaces de estudiar la escala nanométrica ha permitido la caracterización de las conocidas como nanopartículas de plata. Según la ISO (International Organization for Standardization), “un nanomaterial es un material con cualquier dimensión externa en la escala nanométrica (“nano-objeto”) o que tenga una estructura interna o superficial en la escala nanométrica (“material nanoestructurado”)”. Sin embargo, cabe destacar la polémica existente entre esta y más descripciones, pues aún no se ha establecido si lo que es llamado como “material nanoestructurado”, como una nanofibra, puede ser considerado una nanopartícula a pesar de que una de sus dimensiones sea mayor que la escala nanométrica. Esta está definida como el rango desde aproximadamente 1 a 100 nanómetros, 1 nm = 10-9 m).
Lo que sí que se puede entender es que las nanopartículas de plata presentan un tamaño realmente reducido, lo que les permite introducirse en el interior de las bacterias, y de cualquier célula, sin prácticamente impedimento alguno. Esta entrada puede darse bien por endocitosis, la célula incorpora partículas extracelulares englobándolas con la membrana plasmática, o también por difusión, flujo de moléculas a través de una membrana permeable [Nowack, Krug y Height, 2011; Calderón-Jiménez et al, 2017; www.iso.org].
270
Análisis de las propiedades bactericidas de la plata
Aunque el desarrollo de aparatos que permitiesen medir en la escala nanométrica abrió las puertas al estudio de la toxicidad de la plata, lo cierto es que aún no se ha logrado avanzar lo suficiente como para producir antibióticos a partir de ella. En estos casos, se suele utilizar un método conocido como antibiograma disco-placa o de difusión en agar, estandarizado por Bauer et al. en 1966 y que ha derivado en el aceptado como método Kirby-Bauer, recomendado por la FDA (Food and Drug Administration) y el NCCLS (National Committee for Clinical Laboratory Standards). El objetivo de este método es determinar la sensibilidad bacteriana a los antimicrobianos. Consiste en depositar discos de papel de filtro impregnados con antibióticos en la superficie de un medio de cultivo sólido en el que previamente se hayan sembrado bacterias. Al hacer contacto el disco con el medio sólido, la sustancia bactericida difunde radialmente a través del espesor de dicho medio. Pasado el tiempo de incubación de las bacterias, los discos aparecen rodeados de una zona en la que no han crecido bacterias, conocida como “halo de inhibición” [Gamazo, López-Goñi y Díaz, 2005; www.seimc.org]. El método Kirby-Bauer es el más utilizado para determinar la sensibilidad bacteriana ante una sustancia considerada antimicrobiana. Por este motivo, será del que se partirá en este trabajo para estudiar las propiedades bactericidas de las nanopartículas de plata.
2. OBJETIVOS E HIPÓTESIS DE TRABAJO
2.1. OBJETIVOS DE LA INVESTIGACIÓN
La presente investigación se llevó a cabo con la motivación de establecer la plata como un componente habitual de los antibióticos y luchar contra la resistencia antibiótica adquirida, la cual genera la inefectividad de muchos de ellos. Una vez establecido el método a utilizar, se debe aclarar una serie de aspectos más para poder comprender el objetivo del presente estudio. Se está haciendo referencia a la MIC (Concentración Inhibitoria Mínima, por sus siglas en inglés). Ésta es la cantidad más pequeña de un agente necesaria para inhibir completamente el crecimiento de un microorganismo. La MIC no es constante para un agente concreto, sino que depende de factores tan variables como la versatilidad del microorganismo utilizado. Cabe destacar que para la plata aún no se ha establecido este valor mínimo de concentración. Por tanto, el objetivo de esta investigación no corresponde solamente a determinar la MIC, pues esto requeriría una gran cantidad de estudios, sino a un acotamiento del posible valor. Determinar la MIC de la plata es clave para contar con una concentración de partida sobre la que se pueda estudiar la toxicidad de este metal en el ser humano [Gamazo, López-Goñi y Díaz, 2005; www.seimc.org; Madigan et al., 2015].
2.2. HIPÓTESIS DE TRABAJO
En la presente investigación se utilizó la bacteria Escherichia coli (E. coli). Para desarrollar todo el estudio se partió de la siguiente hipótesis de trabajo: “La
271
31º
CERTAMEN JÓVENES INVESTIGADORES / Ciencias de la Tierra y la Vida
concentración de nanopartículas de plata y su acción bactericida siguen una tendencia concentración-dependiente, es decir, a mayor concentración del agente antibacteriano mayor inhibición de bacterias”.
La acción antibacteriana de la plata y su posible efecto en las cepas de E. coli ya son conocidas, pero se ha querido demostrar que el diámetro del halo de inhibición es proporcional a la cantidad de agente antibacteriano añadido a los discos. Además, se partió de la idea de que cualquier concentración de nanopartículas de plata, por mínima que fuese, tendría una consecuencia directa en el crecimiento de los cultivos.
3. MATERIALES Y MÉTODOS
3.1. MATERIALES
• Papeles de filtro circulares de 6 mm de diámetro, obtenidos mediante sacabocados de esa medida (modelo Uni-Core, marca Whatman, GE Healthcare) y papel de filtro de la misma marca.
• Agua ultrapura, obtenida mediante una estación Wasserman y dispensada en botellas de borosilicato estériles.
• Placas de Petri de plástico de 9 cm de diámetro.
BACTERIA E. COLI
La cepa utilizada en este experimento fue obtenida de una colección de bacterias preexistente en el laboratorio y conservada en glicerol a -20 ºC. Además, había sido tratada con el objetivo de retirársele los factores de virulencia, queriendo esto decir que a grandes rasgos se le fue desprovista de su acción patógena.
PLATA COLOIDAL
La plata coloidal utilizada en esta investigación fue adquirida de www.amazon. es. Se trata de un producto suplementario vegano de la firma alemana fairvital de 30 mL con una concentración de 500 ppm, es decir, 500.000 μg/L. Cabe destacar que esta es la plata coloidal más concentrada que se ha podido encontrar en el mercado. Aunque el tamaño de las nanopartículas de plata de este material se suele encontrar entre 1 y 10 nm de diámetro, el producto no especificaba este dato. Su color era ciertamente oscuro, casi negro [www.nccih.nih.gov].
MEDIO DE CULTIVO
Un medio de cultivo es un conjunto de nutrientes, factores de crecimiento y otros componentes que crean las condiciones necesarias para el desarrollo de microorganismos. Hay muchos tipos diferentes, como el caldo EC, agar chocolate, caldo Giolitti-Cantoni, Moeller o agar sangre. En el presente experimento
272
Análisis de las propiedades bactericidas de la plata
se prepararon dos cultivos diferentes, uno líquido y otro sólido, fundamentados ambos en el medio LB, (Luria-Bertani) [Gamazo, López-Goñi y Díaz, 2005; Willey, Sherwood y Woolverton, 2008; Robledo, 2010].
Los componentes del medio se disolvieron en un litro de agua ultrapura, obteniendo así un medio de cultivo líquido. Para obtener el medio sólido se utilizaron 15 g de agar, sustancia muy común desde que Robert Koch y Frederick Loeffler la usasen por primera vez en 1881. El agar, que permitió el paso del medio líquido al sólido y el aislamiento de cultivos puros, es un polisacárido sulfatado complejo que suele ser extraído de algas rojas. La solidificación del medio se debe a su elevada acción gelificante [Gamazo, López-Goñi y Díaz, 2005; Willey, Sherwood y Woolverton, 2008].
3.3. TÉCNICAS EMPLEADAS
3.3.1.
TÉCNICAS DE ESTERILIZACIÓN
La esterilización es un proceso que destruye cualquier tipo de vida microbiana. Esto incluye, por tanto, otras formas además de bacterias, como esporas, formas vegetativas y virus. En este estudio el material de vidrio se esterilizó en estufa, mientras que en la cámara de flujo laminar, donde se desarrolló la fase experimental, se aplicó luz ultravioleta y etanol.
3.3.2. TÉCNICAS DE SEMBRADO
El procedimiento habitual consiste en cultivar la cepa en un caldo líquido para después distribuirlo en los medios sólidos. Sin embargo, el día previo a la experimentación se llevó a cabo un sembrado en LB agar (sólido), con el objetivo de asegurar el correcto crecimiento de la cepa y la inexistencia de contaminaciones antes de llevar a cabo el citado cultivo líquido.
El día de la práctica a primera hora se llevó a cabo el sembrado del cultivo líquido en 5 mL de medio LB a partir de lo crecido en el LB agar del día anterior. Se incubó a 37 ºC durante 4 h hasta alcanzar el nivel de densidad óptica idóneo para el sembrado definitivo. La densidad óptica (turbidez) es una medida cuantitativa de la dispersión de la luz por un medio de cultivo. Para organismos unicelulares resulta proporcional al número de células, y en bacterias alcanza su momento idóneo tras finalizar la fase exponencial de su desarrollo, en la fase estacionaria. La escala de McFarland relaciona la turbidez con el número de bacterias, precisándose aquí una equivalente al 0,5 estándar (1,5 ∙ 108 bacterias) de esta escala. Una vez alcanzado el grado de turbidez deseado, se procedió a sembrar parte del cultivo diluido en las placas de Petri, que contenían medio LB agar hasta una altura de 4 mm. Se pipeteó un volumen, inferior a 1 mL, del caldo líquido en el interior de cada recipiente. Después se realizó una siembra por extensión, es decir, se extendió cada muestra de manera regular en la totalidad de la superficie del medio, utilizando para ello un asa de vidrio estéril.
273
31º CERTAMEN JÓVENES INVESTIGADORES / Ciencias de la Tierra y la Vida
El objetivo fue el crecimiento de colonias en la totalidad de la superficie de la placa, al contrario de lo que sucede, por ejemplo, en una siembra por estrías [Gamazo, López-Goñi y Díaz, 2005; Madigan et al, 2015; Willey, Sherwood y Woolverton, 2008; Bell y Kyriakides, 2000].
VARIANTES
Con el fin de comprobar si la acción bactericida de la plata coloidal se podía extender a otras bacterias que no fuesen E. coli, se plantearon dos variantes del experimento. En estas, las bacterias no fueron obtenidas de una colección del laboratorio, sino que fueron extraídas del pomo de la puerta de los servicios públicos del laboratorio y de la pantalla táctil de un teléfono móvil. Tras la recogida de muestras mediante hisopos humedecidos, se procedió a su sembrado por extensión en las placas de Petri con medio LB agar.
3.4. METODOLOGÍA CIENTÍFICA
Con un rotulador, se enumeraron recipientes del 1 al 6. Los cinco primeros fueron destinados a acoger las disoluciones de plata coloidal, mientras que en el sexto se introdujo agua ultrapura, sin plata, constituyendo así un control.
A continuación se prepararon las cinco disoluciones de plata coloidal siguiendo un proceso de dilución en serie, es decir, estableciendo una disolución de referencia a partir de la cual se prepararon las demás mediante dilución. En concreto, la relación de concentraciones fue de 10:1, queriendo representar que la siguiente disolución poseía una concentración de soluto diez veces menor que la inmediatamente anterior. La disolución madre, la plata sin diluir, fue colocada en el recipiente 1, siguiendo así un orden de concentración decreciente, como se observa en la tabla 3.1.
Las placas de Petri, contando ya con su contenido, fueron numeradas del 1 al 6 para sí acoger papeles de filtro impregnados con una disolución diferente. A continuación, se impregnaron tres discos de papel de filtro con la disolución 1 y, tras retirar el exceso de líquido, se colocaron en la respectiva placa formando un triángulo. Se hizo lo mismo con el resto de disoluciones.

274
Figura 3.1
Relación de recipientes, concentraciones y cultivo. Fuente: propia.
Análisis de las propiedades bactericidas de la plata

Una vez preparadas todas las placas con su disolución correspondiente, los cultivos se dejaron desarrollar en una estufa a 37 ºC, temperatura óptima de crecimiento para E. coli, durante 24 h. Obviamente, la luminosidad en el interior era nula. Cabe destacar que fueron colocadas boca abajo, con el cultivo en la parte superior. De manera contraria, la condensación haría caer gotas de agua sobre las bacterias y podría alterar el experimento.

Con respecto a las variantes, se optó por alterar la colocación de los filtros. Así, cada variante fue alojada en una placa donde se colocaron cinco discos impregnados con las cinco disoluciones diferentes siguiendo la forma de un pentágono regular.
4. ANÁLISIS DE RESULTADOS Y DISCUSIÓN
Un aspecto ciertamente destacable es que los halos de inhibición aparecieron desde el primer día, y sus medidas permanecieron constantes a lo largo de las jornadas. Detalles de los filtros y de la longitud del diámetro del halo se incluyen en la tabla 4.1.
Comparativade las colonias a las 72 h. Fuente: propia.
Por otro lado, las colonias de las placas 1 a 5 destacaron por ser pequeñas y regulares, siendo blancas pero tendiendo al color amarillo con el paso del tiempo. Sin embargo, en la placa 6, de control, habían crecido menos colonias que en el resto de cultivos, aunque con mayor tamaño. Estas observaciones se ilustran en la tabla 4.2.
Las variantes, al no saber exactamente qué microorganismos habían sido cultivados, se dejaron desarrollar durante 16 días. Sin embargo, desde prácticamente el segundo día se hizo notar que las colonias que iban apareciendo se acercaban en gran cantidad a los discos impregnados de las disoluciones de plata coloidal, siendo inexistentes los halos de inhibición, como se ve en la figura 4.1.
Aunque a las 24 h el crecimiento de lo sembrado había sido mínimo, cierto es que ambas variantes se desarrollaron enormemente hasta la sexta jornada, observándose asimismo muy pocos cambios entre ese día y el decimosexto. Se observaron, sobre todo en el cultivo de la pantalla del móvil, colonias bacterianas de distintos colores (blanco, amarillo e incluso marrón) y de diversos tamaños
275
Figura 4.2
JÓVENES INVESTIGADORES / Ciencias de la Tierra y la Vida
(las amarillas eran generalmente de mayor tamaño), así como la presencia de hongos. Estos últimos eran especialmente notorios en el cultivo del pomo, reconocibles por un centro más oscuro, un borde fibroso y por producir una sustancia de tonos marrones.
Para poder discutir los resultados obtenidos, resulta conveniente recordar la hipótesis de trabajo: “La concentración de nanopartículas de plata y su acción bactericida siguen una tendencia concentración-dependiente, es decir, a mayor concentración del agente antibacteriano mayor inhibición de bacterias”.
Es indudable que la hipótesis planteada no ha sido verificada. En ella se partía de la idea de que cualquier concentración de nanopartículas de plata, por mínima que fuese, tendría una consecuente acción antibacteriana visible. Sin embargo, solo puede notarse mínimamente a partir de los 5.000 μg/L (placa 3), pero para poder hacerlo con total seguridad habría que extenderse hasta los 50.000 μg/L (placa 2). A partir de ahí sí que podría decirse que existe cierta relación entre la concentración de nanopartículas de plata y el diámetro del halo de inhibición obtenido. Recuérdese que con los 50.000 μg/mL (placa 2) la medida era de 2 mm, mientras que con los 500.000 μg/L (placa 1), de 4 mm. Se trataría del doble de longitud al aumentar 10 veces la concentración. Obviamente habría que realizar más ensayos para poder asegurar esta conclusión, aunque cabe mencionar que la plata coloidal era la de mayor concentración del mercado, por lo que habría que buscar otras alternativas.

Retomando los objetivos, se podría decir que esta investigación ha ayudado a reducir los posibles valores de la MIC de la plata. Se menciona esto último porque en cepas de E. coli las sustancias antibacterianas suelen producir un halo mayor, aspecto que deberá tenerse en cuenta en investigaciones futuras en una búsqueda de disoluciones más concentradas.
Teniendo en cuenta que las colonias de la placa de control eran más grandes y menos numerosas, se podría afirmar que la plata ha interferido en el crecimiento de alguna forma. Partiendo de la idea de que las disoluciones podrían
31º
276
CERTAMEN
Figura 4.1
Variante del pomo a los 16 días.
Análisis de las propiedades bactericidas de la plata
haberse extendido por el LB agar y afectar a la totalidad de las superficies de las placas, no solo en lo circundante al disco, podría argumentarse que incluso una mínima cantidad de plata afecta a la capacidad de las bacterias de formar colonias (no se observan diferencias notables entre las distintas concentraciones). Aunque podría constituir un punto a incluir en estudios futuros, la verdad es que este aspecto resulta bastante evidente.
Por último, los resultados con ambas variantes dan a entender que las disoluciones de plata no han sido lo suficientemente concentradas como para poder inhibir el crecimiento de los microorganismos cultivados. Es posible que se necesite una mayor concentración para neutralizarlas, aunque hay que añadir que no se sabe qué especies crecieron en las placas. También se podría poner en duda las propiedades antifúngicas de la plata, o puede ser que estas se desarrollen con concentraciones mayores. Como ya se ha comentado a lo largo de este apartado, se necesitarán más ensayos con otros tipos de bacterias y hongos para poder afirmar esto con seguridad.
5. FUTURAS LÍNEAS DE INVESTIGACIÓN
Con relación al objetivo, futuros estudios podrían centrarse en establecer la MIC de la plata o en analizar su toxicidad y la respuesta del organismo humano frente a ella. Con relación al experimento, se podrían estudiar otras variables como modificar la viscosidad del medio LB añadiendo distintas proporciones de agar, utilizar otro medio de cultivo de diferente naturaleza o sintetizar nanopartículas de plata por otros procedimientos no comerciales. Partiendo del nitrato de plata y procesos como la electrólisis, se podrían obtener concentraciones más elevadas que pueden resultar tóxicas, pero que son necesarias teniendo en cuenta los resultados obtenidos.
6. RESUMEN Y CONCLUSIÓN FINAL
En esta investigación se ha hecho un especial hincapié en los antibióticos. La resistencia antimicrobiana a estos fármacos ya es una de las principales segadoras de vidas humanas en un futuro a corto plazo. Algunas fuentes, como la OECD (OrganisationforeconomicCo-operationandDevelopment), afirman que más de 2,4 millones de personas morirán en los 30 próximos años como resultado de infecciones de microorganismos con resistencia adquirida. Otras, como la WHO (World Health Organization) declaran que ya en el expirado 2018 más de 700.00 personas (33.000 en la Unión Europea) han perdido sus vidas por la misma causa. Y la estimación para el año 2050 es de 10.000.000 de defunciones, una cifra realmente alarmante [Hofer, 2019; www.who.int (a); www.amr-review. org; www.who.int (b)].
La resistencia bacteriana a los antibióticos no se debe solamente a su exceso o uso inadecuado, ya que el hecho que los animales no puedan aprovechar todo el potencial de estos fármacos hace que en el medio existan cantidades de ellos
277
CERTAMEN JÓVENES
INVESTIGADORES / Ciencias de la Tierra y la Vida
muy pequeñas. Por tanto, no es de extrañar que los microorganismos evolucionen para sobrevivir. Por eso es importante que se sigan desarrollando nuevos antibióticos, y el papel de la plata en esto puede ser trascendental [www.ghdx.healthdata.org].
Recuérdese, además, que este metal de transición tiene un problema añadido: es tóxico. Es por esto por lo que determinar la MIC es tan importante, para así poder trabajar con tal cantidad y observar los posibles daños que cause en los seres vivos. Tras el establecimiento de la MIC, se deberán realizar los estudios de genotoxicidad pertinentes para ayudar a solventar este asunto. Se habla del prefijo geno- en referencia a los daños genéticos que la plata puede causar, alterando el ADN y pudiendo derivar en mutaciones genéticas a largo plazo
Tras asegurarse que la plata es segura, se pondría en marcha la fase clínica, comenzando por estudios in vitro, en células, para pasar a animales y finalmente a los seres humanos. Puede parecer un proceso largo y tedioso, aunque necesario para que la plata pueda formar parte, en un futuro no muy lejano, de los antibióticos y otros elementos antibacterianos. Y todo esto depende de la paciencia y del método científico.
7. Agradecimientos
En primer lugar, desearíamos agradecer al Dr. César Arrese-Igor Sánchez, Catedrático de Fisiología Vegetal y profesor de la Universidad Pública de Navarra (UPNA), por permitirnos el acceso a sus laboratorios. Tampoco podemos olvidarnos de Mikel Domínguez Arrizabalaga, estudiante de doctorado del Departamento de Agronomía, Biotecnología y Alimentación de la UPNA, por facilitarnos el material biológico que tanta importancia ha tenido a lo largo del proyecto. También nos resultó verdaderamente útil la información aportada por Adriana Rodríguez Garraus, estudiante de doctorado del Departamento de Farmacología y Toxicología de la Facultad de Farmacia y Nutrición de la Universidad de Navarra (UNAV). Los datos que nos proporcionó fueron de vital importancia para la comprensión del estudio. Además, querríamos agradecer también al Dr. Jesús Echeverría Morrás, docente de Química Inorgánica de la UPNA, por la orientación que nos proporcionó antes de iniciar la investigación. Asimismo, el Dr. Miguel Ángel Vicente Rodríguez, Catedrático de Química Inorgánica de la Universidad de Salamanca (USAL), no dudó en informarnos sobre procedimientos sencillos para sintetizar nanopartículas de plata. Por último, cabría mencionar a aquellas otras personas que no trabajaron directamente con nosotros, pero que sin cuya colaboración todo hubiese sido distinto, como Ainhoa Garraus Baquedano.º
31º
278
Análisis de las propiedades bactericidas de la plata
8. BIBLIOGRAFÍA Y WEBGRAFÍA
Bell, C.; Kyriakides, A. (2000) ‘E. coli Una aproximación práctica al microorganismo y su control en los alimentos’, Editorial ACRIBIA, S.A., 1ª. edición.
Calderón-Jiménez, B.; Johnson, M.E.; Bustos, A.R.M.; Murphy, K.E.; Winchester, M.R.; Baudrit, J.R.V. (2017) ‘Silver nanoparticles: technological advances, societal impacts, and metrological challenges’, frontiers in Chemistry, 5, 6.
Dayem, A.A.; Hossain, M.K.; Lee, S.B.; Kim, K.; Saha, S.K.; Yang, G-M.; Choi, H.Y.; Cho, S-G. (2017) ‘The role of reactive oxygen species (ROS) in the biological activities of metallic nanoparticles’, Int. J. Mol. Sci, 18, 120.
Gamazo, C.; López-Goñi, I.; Díaz, R. (2005) ‘Manual práctico de microbiología’, Elsevier Masson, 3ª. edición.
Hofer, U. (2019) ‘The cost of antimicrobial resistance’, Nature Reviews Microbiology, 17, 3.
Huma, Z.; Gupta, A.; Javed, I.; Das, R.; Hussian, S.Z.; Mumtaz, S.; Hussain, I.; Rotello, V.M. (2018) ‘Cationic silver nanoclusters as potent antimicrobials against multidrug-resistant bacteria’, ACS Omega, 3, 16721-16727.
Madigan, T.M.; Martinko, J.M.; Bender, K.S.; Buckley, D.H.; Stahl, D.A. Brock. (2015) ‘Biología de los microorganismos’, Pearson, 14ª. edición.
Nowack, B.; Krug, H.F.; Height, M. (2011) ‘120 years of nanosilver history: implications for policy makers’, Environ. Sci. Technol, 45, 1177-1183.
Robledo, M. (2010) ‘Análisis molecular y funcional de la celulasa CelC2 en la simbiosis Rhizobia-leguminosas’, tesis doctoral, Universidad de Salamanca
Willey, J.M.; Sherwood, L.M.; Woolverton, C.J. (2008) ‘Microbiología de Prescott, Harley y Klein’, Mc Graw Hill, 7ª. edición.
Página oficial de la Clínica Universidad de Navarra: www.cun.es/diccionario-medico/terminos/radical-libre-oxigeno
Página oficial del Institute for Health Metrics and Evaluation: Global Burden of Disease: www.ghdx.healthdata.org/gbd-results-tool
Página oficial de la International Organization for Standardization: www.iso.org/standard/54440.html
Página oficial del National Center for Complementary and Integrative Health: www.nccih.nih.gov/health/colloidalsilver
Página oficial de la Organización Mundial de la Salud (a): www.who.int/bulletin/volumes/94/9/16-020916/en/
279
31º CERTAMEN JÓVENES INVESTIGADORES / Ciencias de la Tierra y la Vida
Página oficial de la Organización Mundial de la Salud (b):
www.who.int/medicines/publications/WHO-PPL-Short_Summary_25Feb-ET_NM_WHO.pdf?ua=1
Página oficial de Review of Antimicrobial Resistance:
www.amr-review.org/sites/default/files/AMR Review Paper - Tackling a crisis for the health and wealth of nations_1.pdf
Página oficial de Science Buddies:
www.sciencebuddies.org/science-fair-projects/project-ideas/MicroBio_p031/microbiology/can-silver-nanoparticles-neutralize-e-coli-bacteria
Página oficial de smith&nephew España:
www.smith-nephew.com/espana/productos/curacion-de-heridas/control-de-la-infeccion/acticoat1/ acticoat/
Página oficial de la Sociedad Española de Enfermedades Infecciosas y Microbiología Clínica:
www.seimc.org/contenidos/documentoscientificos/procedimientosmicrobiologia/seimc-procedimientomicrobiologia11.pdf
280
CRISPR-Cas9 y el Déficit de Merosina: el camino hacia la cura
/ ACCESIT
AUTORAS | CLARA MUSACH VILLA, NÚRIA ESPINOSA CHECA Y EVA MARÍA FERRER BELTRÁN
COORDINADORA | LAIA HERNÁNDEZ GARCÍA
CENTRO | ESCOLA SANT GERVASI COOPERATIVA CIUDAD | MOLLET DEL VALLÈS-BARCELONA
RESUMEN |
La Distrofia Muscular por Déficit de Merosina es una enfermedad genética congénita autosómica recesiva, causada por una mutación en el gen LAMA2, que codifica la cadena de laminina α2 de la merosina. Los pacientes afectados por este trastorno normalmente presentan una hipotonía severa, debilidad muscular y dificultades motrices.
En este trabajo, hemos estudiado detalladamente el Déficit de Merosina (CMD1A) desde diversas perspectivas, tanto desde el punto de vista clínico y de investigación, como desde una perspectiva social. Así, hemos podido conocer de cerca el impacto de esta enfermedad en los afectados y su entorno más cercano, hacer divulgación científica y, por último, recaudar fondos para colaborar con la asociación ImpulsaT para la investigación de un posible tratamiento.
Además, en el trabajo se han analizado también diferentes herramientas de terapia genética para acabar centrándonos en CRISPR-Cas9. Hemos estudiado su origen, sus aplicaciones, sus ventajas e inconvenientes… Finalmente, hemos propuesto un procedimiento mediante esta técnica de ingeniería genética con el fin de corregir la mutación del gen LAMA2 y restablecer la integridad de la fibra muscular de los individuos afectados por esta enfermedad.
CIENCIAS DE LA TIERRA Y LA VIDA 282
ABSTRACT |
Merosin Deficient Muscular Dystrophy is a congenital autosomal recessive genetic disorder caused by a mutation in the gene LAMA2, which codifies laminin α2 chain of merosin. Patients affected by this disorder usually have severe hypotonia, muscle weakness and motor difficulties.
In this project, we have studied in detail the Merosin Deficient Muscular Dystrophy (CMD-1A) from different perspectives, both from a clinical and research point of view, and from a social perspective. Thus, we have been able to learn up close about the impact of this disorder on those affected and their immediate environment, to disseminate science and, finally, to raise funds to collaborate with ImpulsaT association for the investigation of a possible treatment.
In addition, in the project we have also analysed different genetic therapy tools to end up focusing on CRISPR-Cas9. We have studied its origin, its applications, its advantages and disadvantages… Finally, we have proposed a procedure using this genetic engineering technique in order to correct the mutation of the LAMA2 gene and to restore the integrity of the muscle fibre of the individuals affected by this disorder.
283
31º CERTAMEN JÓVENES INVESTIGADORES / Ciencias de la Tierra y la Vida
1. INTRODUCCIÓN
La terapia génica ha supuesto una revolución en la manera de abordar el tratamiento de las enfermedades genéticas, abriendo nuevos horizontes para la cura de enfermedades para las cuales solo existían tratamientos enfocados en paliar los síntomas. Las técnicas de edición del genoma atacan la raíz del problema mediante la transferencia de la versión funcional de un gen defectuoso, el causante de la enfermedad. En los últimos años, la prometedora técnica CRISPR-Cas9, más fácil, económica y eficaz que sus antecesoras, ha estado en boca de todos.
Sentíamos mucha curiosidad por la técnica CRISPR-Cas9. Pero deseábamos conocer la técnica de la mano de una enfermedad genética rara, partiendo de la hipótesis que se podría hacer servir para curarla.
Cuando nuestra tutora nos habló de unos conocidos suyos que tenían una hija con Distrofia Muscular por Déficit de Merosina, y de la asociación ImpulsaT, ¡no lo dudamos!
La Distrofia Muscular Congénita por Déficit de Merosina (CMD-1A) es una enfermedad hereditaria muy minoritaria y grave, que se clasifica dentro de las distrofias musculares. Estas se caracterizan por provocar debilidad muscular desde la infancia, generalmente antes de los 2 años.
ImpulsaT es la asociación oficial española que representa a las personas afectadas por la CMD-1A.
Acompañadnos en este viaje por la historia de la terapia genética, conoced cómo surgió CRISPR-Cas9 y sus múltiples aplicaciones, y acercaos a la realidad más humana de la enfermedad CMD-1A. ¿Será posible su cura?
¿Qué obstáculos nos encontraremos en el camino?
2. ANTECEDENTES (ANTECEDENTES, ESTADO DE LA CUESTIÓN E INVESTIGACIONES PREVIAS SOBRE EL TEMA)
Desde que CRISPR-Cas9 se convirtió en una herramienta de edición del genoma en el año 2012, los artículos publicados que la mencionan han aumentado de forma relevante. Esto se debe a que es una técnica barata, rápida y relativamente fácil de utilizar. Se ha convertido en imprescindible para el estudio de enfermedades, la generación de nuevas variedades de plantas, la producción de fármacos o los avances en terapia génica, entre otras aplicaciones. Se espera que la herramienta pueda ser utilizada para curar numerosas enfermedades hereditarias, muchas de las cuales tienen pocos o inexistentes tratamientos en la actualidad.
284
CRISPR-Cas9 y el Déficit de Merosina: el camino hacia la cura
La Distrofia Muscular Congénita por Déficit de Merosina (CMD-1A) es una enfermedad genética, congénita recesiva, muy minoritaria y grave, causada por mutaciones en el gen LAMA2, que codifica para la cadena ⍺2 de la laminina-211 (merosina). Esta proteína se encuentra en la matriz extracelular y es el componente predominante de la membrana basal del músculo estriado. La enfermedad se caracteriza por provocar hipotonía, debilidad muscular y dificultades motoras desde la infancia, así como problemas respiratorios y nutricionales. El pronóstico de la enfermedad es grave, y los tratamientos existentes están enfocados únicamente en paliar los síntomas.
La terapia génica es un tratamiento médico que se basa en manipular información genética de células que presentan una mutación para corregir un defecto genético. Una de las técnicas de terapia génica son las enzimas que cortan ADN, conocidas como nucleasas inginierizadas. Estas permiten insertar, eliminar o sustituir partes del genoma de los organismos con el objetivo de restaurar la función de un gen mutado. Realizan cortes de doble cadena (DSBs) en localizaciones deseadas del genoma. Los DSBs inducidos son reparados por mecanismos propios de la célula; por recombinación no homóloga (NHEJ) o por recombinación dirigida por homología (HDR), obteniendo como resultado la mutación objetivo. Se conocen tres familias de este tipo de nucleasas que están siendo empleadas: Nucleasas de dedos de zinc (ZFNs), Nucleasas tipo activadoras de transcripción (TALENs) y Nucleasas de secuencias palindrómicas repetidas inversas (CRISPR-Cas9).
La técnica CRISPR-Cas9 se originó a partir de un sistema de defensa adaptativo procariótico, conservado en los genomas bacterianos. Las nucleasas Cas9 RNA-programables cortan el ADN, dirigidas por secuencias de orientación de pocos nucleótidos dentro de un RNA guía (sgRNA). De este modo, el sistema permite editar el genoma de forma específica. La Cas9 en presencia de sgRNA se dirige al ADN objetivo y realiza un corte (DSB) gracias a sus dominios catalíticos HNH y RuvC. El corte es entonces reparado por NHEJ o por HDR (si la célula dispone de un molde de reparación). El tipo de alteración genómica, por lo tanto, será diferente dependiendo de si se da una o otra vía, en función del cambio que el investigador/a quiera fomentar. CRISPR-Cas9 permite realizar muchos tipos de mutaciones, desde inhabilitaciones de genes, a inserciones o correcciones específicas, inversiones y translocaciones, activación o represión de la transcripción, …
En cuanto a la aplicación de la técnica a la CMD-1A, se han utilizado diferentes métodos tanto para intentar erradicar la enfermedad, como para desarrollar fármacos que mejoren la condición de los afectados.
Para evitar la degeneración del músculo propia de la CMD-1A, muchos grupos han trabajado para manipular la apoptosis, la acción de lo proteasomas y las vías de señalización de la autofagia. Estas estrategias desembocaron en el desa-
285
31º CERTAMEN JÓVENES INVESTIGADORES / Ciencias de la Tierra y la Vida
rrollo de numerosos fármacos en uso, que han conseguido mejorar el fenotipo de la enfermedad.
Además, se han planteado estrategias centradas en reintroducir la expresión normal del gen LAMA2. Kuang et al. lo expresaron de forma transgénica en ratones dyW/dyW i dy2j/dy2j mediante un promotor específico para el músculo. Los resultados mostraron una mejora en la morfología del músculo y su integridad, así como un aumento en la esperanza de vida y la salud de los ratones tratados. Otros dos experimentos exitosos implicaron la expresión de un transgen mini agrina, o del transgen LAMA1. La proteína mini agrina hizo de conectora entre la molécula de ⍺-distroglicano y las moléculas de laminina-411. A su vez, el gen LAMA1 codifica para la cadena de laminina ⍺1, estructuralmente similar a la cadena de laminina ⍺2. Por lo tanto, la laminina-111 sintetizada puede sustituir la laminina-211 y realizar su función. Gawlik et al. demostraron que la expresión transgénica de la cadena de laminina ⍺1 en ratones dy3k/dy3k tenía un efecto altamente beneficioso en la severidad de la enfermedad. Lo mismo corroboraron Rooney et al., que liberaron sistemáticamente la proteína laminina-111 en ratones dyw/ dyw.
3. OBJETIVOS DE LA INVESTIGACIÓN
Objetivos conceptuales: Tenemos como objetivos investigar y aprender sobre las técnicas de terapia genética, enfocando nuestro trabajo en CRISPR-Cas9. En los últimos años ha destacado por ser la técnica más prometedora, por este motivo queremos profundizar en su funcionamiento y sus aplicaciones actuales. Finalmente, queremos investigar sobre la aplicabilidad de CRISPR-Cas9 en la posible cura de la CMD-1A. En el camino para averiguarlo, intentaremos conocer en profundidad la enfermedad: causas, diagnóstico, tratamiento, afectaciones…
Objetivos procedimentales: Nos proponemos entender cómo se diseñaría un plan de actuación sobre la enfermedad mediante el método CRISPR-Cas9. Además, queremos presenciar los primeros pasos del proceso en el laboratorio. Asimismo, nos proponemos realizar entrevistas a médicos, investigadores, a diversos pacientes y a sus respectivos familiares.
Objetivos actitudinales: Tenemos la intención de mejorar nuestro trabajo en equipo, así como seguir el método científico. También queremos contemplar la terapia genética desde un punto de vista ético, y poder empatizar con los pacientes que conozcamos. Nos proponemos también hacer una campaña de divulgación científica y, por último, realizar una recogida de fondos para ayudar a la asociación ImpulsaT.
4. MATERIALES Y MÉTODOS
Investigación documental: Nos hemos documentado a través de búsqueda de
286
CRISPR-Cas9 y el Déficit de Merosina: el camino hacia la cura
información en diferentes plataformas científicas, artículos, investigaciones previas… También hemos usado libros de texto y hemos hablado con científicos que investigan usando CRISPR-Cas9, con médicos que estudian la enfermedad de la Distrofia Muscular por Déficit de Merosina, con familiares de infantes afectados, con dos adultas afectadas…
Experimentación y observación: Gracias a la búsqueda por internet sobre CRISPR-Cas9 pudimos ponernos en contacto con Marc Güell (investigador del Parc de Recerca Biomèdica de Barcelona, PRBB, que actualmente conduce proyectos relacionados con la herramienta genética CRISPR-Cas9). Gracias a él y a su equipo, hemos podido llevar a cabo una serie de experimentos en el PRBB en los que hemos efectuado algunos de los pasos que se necesitaban seguir para aplicar la técnica CRISPR-Cas9 al Déficit de Merosina. Pudimos realizar solo el procedimiento previo a la aplicación de CRISPR-Cas9 a escala celular, ya que nosotras no teníamos acceso al laboratorio donde se realizaban los experimentos con células a causa de los requisitos de seguridad necesarios.
Trabajo de campo: Hemos podido entender el proceso completo desde la aplicación de CRISPR-Cas9 en bacterias hasta la aplicación en humanos, de forma teórica. Hemos realizado diversas entrevistas a investigadores sobre CRISPR-Cas9, y a miembros de la asociación ImpulsaT (que promueve la investigación de un tratamiento para la enfermedad). Además, también hemos entrevistado a una neuropediatra que trata con pacientes afectados y finalmente, a los familiares de los afectados y a dos adultas que la padecen. Las entrevistas nos han aportado mucha información sobre el diagnóstico de la CMD-1A, su tratamiento, la repercusión que tiene sobre los afectados y su entorno y las investigaciones en marcha para encontrar una cura. Por otro lado, nos han permitido realizar un vídeo divulgativo sobre la CMD-1A y las esperanzas que la terapia genética con CRISPR-Cas9 ha generado. Además, hemos realizado más difusión sobre el tema mediante las redes sociales y hemos recaudado fondos para colaborar con la asociación ImpulsaT. También hemos creado un póster con el objetivo de explicar de forma más visual cómo CRISPR-Cas9 podría corregir la enfermedad.
5. RESULTADOS
Finalmente nos dedicamos a conocer de cerca el desarrollo de una estrategia para erradicar el fenotipo de la CMD-1A: la reintroducción del gen LAMA2. Esta una buena opción al tratarse de una terapia universal para tratar a todos los pacientes con la enfermedad, a diferencia de otras planteadas. Es necesario programar la CRISPR-Cas9 para que escinda el gen con la mutación, realizando dos DSBs. Debe introducirse también un molde de reparación con el gen LAMA2 para proporcionar que los DSBs sean reparados por HDR, insertando el nuevo gen sin la mutación.
Otros miembros del equipo del PRBB habían diseñado con un programa
287
JÓVENES INVESTIGADORES / Ciencias de la Tierra y la Vida
bioinformático lo elementos del sistema. Junto con Jésica Jaraba producimos las construcciones de DNA en el laboratorio. Clonamos los siguientes componentes dentro de un vector, un plásmido: un promotor U6 (humano/ratón), el gen que codifica para la Cas9, un gen de florescencia como EGFP (que sirve como marcador de una buena transfección del plásmido) y un gen de resistencia a un antibiótico (en nuestro caso Ampicilina), que sirve para seleccionar las bacterias que contienen el plásmido. Ligamos el sgRNA al plásmido mediante enzimas de restricción.
Después, transformamos exitosamente las bacterias competentes (les introducimos el plásmido) y seleccionamos las bacterias transformadas en placas con Ampicilina. A continuación, extrajimos el ADN plasmídico de las bacterias purificándolo y cuantificando su concentración. También realizamos otra comprobación, digiriendo el plásmido con enzimas de restricción. Las muestras digeridas se corrieron en un gel de agarosa para comprobar qué colonias se habían transformado correctamente. Aquellas que eran correctas se enviaron a secuenciar para verificar que no contuvieran ninguna mutación. Una vez hechas todas las comprobaciones, se produjo más cantidad del plásmido para que este estuviera disponible para futuros experimentos en células humanas. Además, se hizo un glicerinado de las bacterias competentes transformadas con el plásmido de interés para preservarlos durante mucho tiempo. Los pasos siguientes los conocimos solamente de forma teórica por la necesidad de titulación a la hora de trabajar con células humanas y ensayos con animales.
Tomamos consciencia de las principales dificultades de la técnica y la estrategia escogida. En primer lugar, es necesario que la Cas9 encuentre la secuencia PAM, que en algunos genomas no es muy abundante. Por otro lado, encontramos la posible actividad off-target, es decir, fuera del objetivo de la herramienta. Esta es de frecuencia variable y puede resultar difícil de predecir. Aparecen un elevado número de mutaciones no puntuales y translocaciones cromosómicas no deseadas, asociadas a cortes fuera del ADN diana. El gran tamaño del gen LAMA2 dificulta la tarea de introducirlo intacto, pero el equipo estaba trabajando en diferentes alternativas basada en nanopartículas y vectores virales para solucionar el problema. Por último, otro reto por superar es el de conseguir cubrir un tejido tan grande como el músculo con garantías.
Pudimos también entrevistar a una neuropediatra que trata con pacientes que padecen esta enfermedad, a miembros de la asociación ImpulsaT, a investigadores que trabajan con la técnica CRISPR-Cas9 y finalmente, a los familiares de los afectados y a dos adultas que padecen esta enfermedad. Las entrevistas nos aportaron mucha información sobre el diagnóstico de la enfermedad, su tratamiento, la repercusión que tiene sobre los afectados y su entorno, los cimientos de ImpulsaT y las investigaciones en marcha para encontrar una cura.
El vídeo divulgativo que llevamos a cabo, una síntesis de las entrevistas realizadas y la parte más social de nuestro trabajo puede visualizarse en el siguiente
31º
288
CERTAMEN
CRISPR-Cas9 y el Déficit de Merosina: el camino hacia la cura
enlace: https://youtu.be/I7Fi1Uhq738. La cuenta de Instagram que utilizamos para hacer seguimiento del trabajo es @distrofia_muscular_tdr.
6. CONCLUSIONES
Podemos concluir que hemos cumplido todos nuestros objetivos. Tal y como nos propusimos, hemos estudiado a fondo la enfermedad Distrofia Muscular por Déficit de Merosina. Después de hacer un recorrido por varias técnicas de terapia génica, nos hemos centrado en CRISPR-Cas9, comprendiendo los mecanismos que le confieren la capacidad de editar el genoma de forma dirigida, cosa que no pueden hacer otras nucleasas.
Por otro lado, hemos tenido la suerte de recibir la ayuda de algunos investigadores expertos en este campo. Marc Güell, que participó durante su post doctorado en una investigación de la Harvard Medical School, colaborando con algunos de los más prestigiosos investigadores de CRISPR a escala mundial, nos guio durante la realización del trabajo. Además, nos proporcionó información sobre el proyecto de corrección del gen LAMA2 en el cual trabajaba su equipo de investigación del PRBB. Otros expertos que entrevistamos fueron la neuropediatra de la Vall d’Hebron Francina Munell, la biotecnóloga Georgina Sancho, y la directora del comité científico de la asociación ImpulsaT Laura Coch.
Además con la ayuda de Jéssica Jaraba, una estudiante de máster que participaba en el proyecto del PRBB en las primeras fases laboratorio, pudimos presenciar algunos pasos de la estrategia seguida por el grupo de investigación. De forma teórica, conocimos todo el proceso, des del diseño de los componentes del sistema CRISPR-Cas9 hasta los ensayos clínicos. Llegamos a la conclusión de que, después de llevar a cabo los avances necesarios en relación con la transfección del gen LAMA2 y la reducción de la actividad off-target de CRISPR-Cas9, la estrategia propuesta será totalmente viables para corregir el fenotipo de la CMD1A.
En cuanto a la parte más social del trabajo, hemos creado un video divulgativo i una cuenta de Instagram relacionada con el trabajo. Durante la filmación del video hemos conocido a dos niñas con Distrofia Muscular por Déficit de Merosina y a sus respectivas familias, y hemos podido compartir un día con ellas para acercarnos a su día a día. También hemos entrevistado a sus padres, a dos adultas con la enfermedad y al presidente de ImpulsaT, Xavi Bulbena. No solo eso, hemos llevado a cabo un acto de recogida de fondos en nuestro centro educativo (Escola Sant Gervasi) para propiciar la búsqueda de una cura para la enfermedad.
Finalmente, podemos decir que estamos muy satisfechas con el resultado final del trabajo. Hemos aumentado de forma sustancial nuestros conocimientos y hemos visto cómo se aplicaría la técnica CRISPR-Cas9 para corregir la CMD1A. Del mismo modo, adquirir la perspectiva de pacientes, familiares, médicos
289
CERTAMEN JÓVENES
INVESTIGADORES / Ciencias de la Tierra y la Vida
y demás personas ha resultado muy enriquecedor. Nos ilusiona la idea de continuar con esta investigación en el futuro y descubrir si la enfermedad puede ser finalmente corregida.
7. AGRADECIMIENTOS
Primero de todo, queremos agradecer a Xavier Bulbena y Olga Barrero, padres de Júlia, así como a Pau Martí y Esther, padres de Èlia, su total cooperación con nosotras para poder realizar el vídeo divulgativo, así como su ayuda para entender las implicaciones que supone esta enfermedad en el día a día de un afectado y en la vida de aquellos que lo rodean.
También queremos dar las gracias a Júlia y a Èlia por su colaboración con el vídeo divulgativo y por contagiarnos su alegría de vivir. Queremos, además, felicitarlas por ser tan valientes, llevando siempre la enfermedad con una sonrisa de oreja a oreja.
Gracias a Alba Izquierdo y a Montse por hacernos partícipes de toda una vida conviviendo con la enfermedad, compartiendo con nosotras las dificultades que se han encontrado en el camino y cómo éstas les han hecho crecer y evolucionar a nivel personal.
Agradecemos a Meritxell Torres, coordinadora de la asociación ImpulsaT, su participación en el vídeo divulgativo, así como el interés mostrado en la recogida de fondos y su esfuerzo por proporcionarnos recursos.
Queremos agradecer también a Laura Coch, miembro del comité científico de ImpulsaT, el haber colaborado con nosotras proporcionándonos información sobre la técnica CRISPR-Cas9 y la enfermedad.
También queremos agradecer a Francina Munell, neuropediatra de Vall d’Hebron, por transmitirnos todos sus conocimientos sobre la enfermedad y participar en nuestro vídeo divulgativo.
Queremos agradecer, además, a Marc Güell, investigador del PRBB, por haber hecho posible que conociéramos la aplicación práctica de la técnica CRISPR-Cas9, por proporcionarnos valiosas ideas y por tomar partido en nuestro vídeo divulgativo y sobre todo, por encontrar tiempo para dedicarnos a pesar de tener una agenda tan apretada.
Queremos también agradecer a Jessica Jaraba, investigadora del PRBB, por haberse puesto a nuestra disposición, ayudándonos con la parte práctica del trabajo y compartiendo con nosotras material de trabajo que ella había realizado y que nos ha sido de gran utilidad para comprender la parte experimental.
Queremos agradecer también la colaboración de nuestra amiga y compañera
290
31º
Medline Plus (Marzo 2019). Disponible en Internet: https://medlineplus.gov/spanish/musculardystrophy.html
Mohanraju, Prathana; S. Makarova, Kira (Agosto 2016). Disponible en Internet: http://science.sciencemag.org/content/353/6299/aad5147
Medline Plus (Marzo 2019). Disponible en Internet: https://medlineplus.gov/spanish/musculardystrophy.html Mohanraju, Prathana; S. Makarova, Kira (Agosto 2016). Disponible en Internet: http://science.sciencemag.org/content/353/6299/aad5147
CRISPR-Cas9 y el Déficit de Merosina: el camino hacia la cura

Montoliu, Lluís (Febrero 2019). Disponible en Internet: http://wwwuser.cnb.csic.es/~montoliu/CRISPR/
Mullin, Emily (Diciembre 2017). Disponible en Internet:
https://www.technologyreview.com/s/609722/crispr-in2018coming-to-a-human-nearyou/
Montoliu, Lluís (Febrero 2019). Disponible en Internet: http://wwwuser.cnb.csic.es/~montoliu/CRISPR/ Mullin, Emily (Diciembre 2017). Disponible en Internet: https://www.technologyreview.com/s/609722/crispr-in2018coming-to-a-human-nearyou/
Maria Casanova, tanto a la hora de grabar alguna de las entrevistas, como por la composición de la banda sonora de nuestro vídeo divulgativo.
Muntada, Mireia (Septiembre 2016). Disponible en Internet:
Muntada, Mireia (Septiembre 2016). Disponible en Internet:
https://allyouneedisbiology.wordpress.com/2016/09/23terapia-genica/
https://allyouneedisbiology.wordpress.com/2016/09/23terapia-genica/
National Institute of Neurological Disorders and Stroke (Diciembre 2016). Disponible en Internet:
National Institute of Neurological Disorders and Stroke (Diciembre 2016). Disponible en Internet:
https://espanol.ninds.nih.gov/trastornos/distrofia_muscular.htm
https://espanol.ninds.nih.gov/trastornos/distrofia_muscular.htm
National Center for Biotechnology Information (Octubre 1955). Disponible en Internet:
National Center for Biotechnology Information (Octubre 1955). Disponible en Internet:
https://www.ncbi.nlm.nih.gov/clinvar/RCV000015359/
Además, queremos agradecer a Marta Muntaner y a Rosa Gutiérrez, docentes de la escuela Sant Gervasi que nos hayan dado la oportunidad de organizar una recogida de fondos para colaborar con la asociación ImpulsaT. Queremos dar las gracias a nuestros amigos y familiares por apoyarnos y animarnos siempre y por tener tanta paciencia con nosotras.
National Center for Biotechnology Information EEUU (Abril 2019). Disponible en Internet:
https://www.ncbi.nlm.nih.gov/clinvar/RCV000015359/ National Center for Biotechnology Information EEUU (Abril 2019). Disponible en Internet:
https://ghr.nlm.nih.gov/primer/mutationsanddisorders/possiblemutations
https://ghr.nlm.nih.gov/primer/mutationsanddisorders/possiblemutations

PureLink™ HiPure Plasmid Miniprep Kit [en línia]. Thermo Fisher Scientific.US. Disponible en Internet:
PureLink™ HiPure Plasmid Miniprep Kit [en línia]. Thermo Fisher Scientific.US. Disponible en Internet:
http://www.thermofisher.com/order/catalog/product/K210002
http://www.thermofisher.com/order/catalog/product/K210002
Finalmente, queremos agradecer a nuestra tutora, Laia Hernández, por proporcionarnos la idea y los contactos que nos introdujeron en este gran proceso de aprendizaje. Gracias por mostrar la misma implicación e ilusión por este trabajo que nosotras, por darnos los empujones que necesitábamos y verter un poco de luz en los momentos más oscuros.
PureLink™ HiPure Plasmid Maxiprep Kit [en línia]. Thermo Fisher Scientific.US. Disponible en Internet:
PureLink™ HiPure Plasmid Maxiprep Kit [en línia]. Thermo Fisher Scientific.US. Disponible en Internet:
https://www.thermofisher.com/order/catalog/product/K210006
https://www.thermofisher.com/order/catalog/product/K210006
Gracias, en definitiva, a todos aquellos que nos han acompañado en este viaje, y han aportado algo a nuestro Trabajo de Investigación.
S. Lander, Eric (Gener 2016). Disponible en Internet:
https://www.cell.com/cell/fulltext/S0092-8674(15)01705-5
S. Lander, Eric (Gener 2016). Disponible en Internet: https://www.cell.com/cell/fulltext/S0092-8674(15)01705-5
8. IMÁGENES Y GRÁFICOS
10. Imágenes y gráficos
10. Imágenes y gráficos
http://wwwuser.cnb.csic.es/~montoliu/CRISPR/cri sprcas.jpg -
de http://wwwuser.cnb.csic.es/~montoliu/CRISPR/ -
http://wwwuser.cnb.csic.es/~montoliu/CRISPR/ -

291
Figura 1. Esquema que ilustra el mecanismo de acción de CRISPR-Cas9. - Adaptación de
Figura 2. Vías de reparación celular después de la actuación de CRISPR-Cas9. La vía NHEJ permite inhabilitar genes, mientras que por HDR se pueden hacer modificaciones específicas. - Adaptación
Figura 1. Esquema que ilustra el mecanismo de acción de CRISPR-Cas9. - Adaptación de http://wwwuser.cnb.csic.es/~montoliu/CRISPR/cri sprcas.jpg -
Figura 2. Vías de reparación celular después de la actuación de CRISPR-Cas9. La vía NHEJ permite inhabilitar genes, mientras que por HDR se pueden hacer modificaciones específicas. - Adaptación de
Figura 6. Etapas de aplicación de CRISPR-Cas9 para corregir la Distrofia Muscular por Déficit de Merosina. - Realización propia –
31º CERTAMEN JÓVENES INVESTIGADORES / Ciencias de la Tierra y la Vida
9. WEBGRAFÍA Y BIBLIOGRAFÍA
PUBLICACIONES ESCRITAS
Parramón Ediciones S.A., “Atlas básico de anatomía” Parramón (Junio 2014, pág. 24).
PUBLICACIONES ELECTRÓNICAS
F. Ann, Ran; D.Hsu, Patrick; Wright, Jason; Agarwala, Vineeta; A. Scott, David; Zhang, Feng (Octubre 2013). Disponible en Internet:
https://www.nature.com/articles/nprot.2013.143.pdf
Holmberg, Johan; Durbeej, Madeleine (Enero 2013). Disponible en Internet:
https://www.ncbi.nlm.nih.gov/pmc/articles/PMC3544775/
Jimenez, Nathalia (Agosto 2013). Disponible en Internet:
https://www.orpha.net/data/patho/Pro/en/Merosin-En.pdf
Joung, J.Keith; d. Sander, Jeffry (Noviembre 2012). Disponible en Internet:
https://www.ncbi.nlm.nih.gov/pmc/articles/PMC3547402/
Lammoglia, María Fernanda (Agosto 2016). Disponible en Internet: http://www.medigraphic.com/pdfs/invdis/ir-2016/ir162e.pdf
Navaridas, Raúl (Julio 2016). Disponible en Internet:
https://repositori.udl.cat/bitstream/handle/10459.1/58889/rnavaridasf.pdf?sequence=1& isAllowed=y
Quijano-roy, Susana (Junio 2012). Disponible en Internet:
https://www.ncbi.nlm.nih.gov/books/NBK97333/
Palermo, Giulia; Miao, Yinglong; C. Walker, Ross; Jinek Martin; McCammon, J. Andrew (Junio 2017). Disponible en Internet: http://www.pnas.org/content/114/28/7260
PÁGINAS WEB
Carafoli, F. (Agosto 2009). Disponible en Internet: https://www.ncbi.nlm.nih.gov/pubmed/19553699
Cortez, Chari (Marzo 2015) Disponible en Internet: https://blog.addgene.org/crispr-101-homology-directed-repair
Fardeau, Michel (Abril 2009). Disponible en Internet: https://www.orpha.net/consor/cgi-bin/OC_Exp.php?Lng=ES&Expert=258
Helbling, Leclerc A(Octubre 1955). Disponible en Internet:
292
CRISPR-Cas9 y el Déficit de Merosina: el camino hacia la cura
https://www.ncbi.nlm.nih.gov/pubmed/7550355
Medline Plus (Marzo 2019). Disponible en Internet: https://medlineplus.gov/spanish/musculardystrophy.html
Mohanraju, Prathana; S. Makarova, Kira (Agosto 2016). Disponible en Internet: http://science.sciencemag.org/content/353/6299/aad5147
Montoliu, Lluís (Febrero 2019). Disponible en Internet: http://wwwuser.cnb.csic.es/~montoliu/CRISPR/
Mullin, Emily (Diciembre 2017). Disponible en Internet:
https://www.technologyreview.com/s/609722/crispr-in2018coming-to-ahuman-near-you/
Muntada, Mireia (Septiembre 2016). Disponible en Internet:
https://allyouneedisbiology.wordpress.com/2016/09/23terapia-genica/
National Institute of Neurological Disorders and Stroke (Diciembre 2016). Disponible en Internet:
https://espanol.ninds.nih.gov/trastornos/distrofia_muscular.htm
National Center for Biotechnology Information (Octubre 1955). Disponible en Internet: https://www.ncbi.nlm.nih.gov/clinvar/RCV000015359/
National Center for Biotechnology Information EEUU (Abril 2019). Disponible en Internet:
https://ghr.nlm.nih.gov/primer/mutationsanddisorders/possiblemutations
PureLink™ HiPure Plasmid Miniprep Kit [en línia]. Thermo Fisher Scientific. US. Disponible en Internet:
http://www.thermofisher.com/order/catalog/product/K210002
PureLink™ HiPure Plasmid Maxiprep Kit [en línia]. Thermo Fisher Scientific. US. Disponible en Internet:
https://www.thermofisher.com/order/catalog/product/K210006
S. Lander, Eric (Gener 2016). Disponible en Internet:
https://www.cell.com/cell/fulltext/S0092-8674(15)01705-5
293
Biomecánica aplicada a la natación: salida y viraje
AUTORA | ANNA FONTANALS JORBA
COORDINADOR | ALBERT CARRIÓ CRUCES
CENTRO | EUROPEAN INTERNATIONAL SCHOOL OF BARCELONA
CIUDAD | SANT CUGAT DEL VALLÉS-BARCELONA
RESUMEN |
El objetivo principal de este estudio sería mejorar el rendimiento en la salida y viraje en nadadores de un club de natación amateur a través del diseño de un entrenamiento pliométrico del tren inferior. El estudio se realizó en 10 nadadores federados de un club de natación amateur. Se aleatorizaron en dos grupos: grupo control y grupo entreno. Al grupo entreno además de las sesiones de entrenamiento habituales se le aplicó un entrenamiento pliométrico de tren inferior de 4 semanas de duración. En el primer día y en el último se realizó a todos los nadadores una batería de saltos (SJ, CMJ, ABK) y también se grabaron las salidas y virajes en natación. Los resultados del grupo entreno en los saltos fueron equiparables con los que se obtienen en nadadores profesionales sometidos a entrenamientos pliométricos de mayor duración (6 semanas). El tiempo y la velocidad en la salida y en el viraje mejora en los nadadores del grupo entreno con respecto al grupo control con diferencias estadísticamente significativas. Se objetiva una relación significativa del porcentaje de variación de la potencia de los saltos SJ / CMJ con todas las variables de tiempo y velocidad en la salida y el viraje. Conclusión: La correcta planificación de un entrenamiento específico pliométrico de tren inferior durante 4 semanas en nadadores amateurs son suficientes para poder mejorar el rendimiento, de manera estadísticamente significativa, en las salidas y los virajes.
Palabras clave: Natación, Fisiología, Cualidad Anaeróbica, Test de Abalakov, Test de Bosco, salidas, Virajes.
/ ACCESIT
CIENCIAS DE LA TIERRA Y LA VIDA 294
ABSTRACT |
The main objective of this study was to improve the performance in the exit and turn in swimmers of an amateur swim club through the design of a lower body plyometric training. The study was conducted on 10 federated swimmers from an amateur swim club. These swimmers were randomized into two groups: control group and training group. The trained group, in addition to regular training sessions, applied a lower body plyometric training of 4 weeks. The first day and the last day all swimmers were asked to perform a battery jump (SJ, CMJ,ABK) and at the same time the outings and turns in swimming during the first and the last day were also recorded. The results of the trained group were comparable with those obtained with professional swimmers subjected to longer plyometric training (6 weeks). The time and the speed in the exit and in the turn improve in the swimmers of the trained group with respect to the control group with statistically significant differences. We objectify a significant relation of the percentage of variation of the power of the SJ / CMJ Jumps with all the variables of time and speed in the exit and the turn. Being able to conclude that the correct planning of specific lower train plyometric training for 4 weeks in amateur swimmers is sufficient to be able to improve the performance, in a statistically significant way, in the exits and the turns.
Keywords: Swimming, Physiology, Anaerobic Quality, Abalakov Test, Bosco Test, Exits, Turns.
295
31º CERTAMEN JÓVENES INVESTIGADORES / Ciencias de la Tierra y la Vida
EXPOSICIÓN DEL TRABAJO:
A) INTRODUCCIÓN
En todos los deportes, concretamente en la natación, es muy importante obtener la mayor información posible sobre los deportistas con el objeto de poder diseñar un correcto entrenamiento y así poder obtener el mayor rendimiento de cada uno de ellos.
En la mayoría de los movimientos que se realizan en la práctica de la natación se produce una contracción muscular. Esta acción se relaciona con la pliometría que se define como un movimiento rápido y potente que involucra el pre-estiramiento del músculo y activa el ciclo de elongar y acortar la fibra para producir inmediatamente una contracción concéntrica más fuerte.
La motivación principal de esta investigación sería demostrar que un equipo de natación de un club amateur mediante la realización de un entrenamiento pliométrico específico en un período inferior a 6 semanas puede llegar a mejorar el rendimiento en la salida y viraje en natación.
B) HIPÓTESIS DEL TRABAJO Y OBJETIVOS DE LA INVESTIGACIÓN
La hipótesis seria confirmar que a través del diseño de entrenamientos específicos (Pliométricos de tren inferior) con la ayuda de la Biomecánica se puede mejorar el rendimiento del salto en nadadores de un Club amateur y su mejor rendimiento en las salidas y virajes en natación.
El objetivo principal sería mejorar el rendimiento en las salidas y virajes en los nadadores de un Club amateur a través del diseño de un entrenamiento físico específico.
C) MATERIALES Y MÉTODOS
Para la realización del presente trabajo se utilizaron 10 nadadores de un club amateur de edad comprendida entre 16-20 años.
Se randomizaron los nadadores en dos grupos: El grupo control (GC) formado por 5 nadadores y el grupo entreno (GE) formado por otros 5 nadadores.
1. DISEÑO DEL ESTUDIO.
Se trata de un estudio prospectivo aleatorizado que consta de las siguientes fases.
1.1.ALEATORIZACIÓN
Mediante una tabla de nombres aleatorizados los nadadores fueron divididos
296
Biomecánica aplicada a la natación: salida y viraje
en dos grupos de 5 nadadores. Estos grupos se diferenciaban en la realización o no de un programa de entrenamiento complementario al habitual que se basó en unos ejercicios de pliometría de tren inferior seguidos de unos ejercicios de estiramiento.
1.2. PREPARACIÓN DEL NADADOR
1.2.1.BATERÍA DE SALTOS
Se citaron a los diez nadadores el primer día para la realización de una batería de saltos (Tiempo basal) mediante una plataforma de contacto Chronojump.
Los diez nadadores realizaron tres pruebas de salto vertical:
• Salto de Media Sentadilla o Squat Jump (SJ)
• Salto en contramovimiento (CMJ)
• Test de “Abalakov” (ABK)
Se registraron los siguientes datos de cada nadador: altura de vuelo (cm), potencia de salto (w/kg), tiempo de salto (s), velocidad inicial (m/s).
1.2.2. SALIDA DE NATACIÓN
Para poder realizarlo se efectuó el siguiente procedimiento en la piscina:
• Se colocó la cámara de video (Nex-5. Sony®) a la altura del poyete para poder tener el enfoque preciso cuando un nadador efectuase la salida.
• Se colocó una de las dos cámaras deportivas GoPro Hero a una distancia de 10 metros del poyete.
• Se ubicó la otra cámara deportiva GoPro Hero, encima de una escalera para así tener la perspectiva cuando un nadador llegase a la distancia de los 15 metros.
• Se registraron los siguientes datos:
• Tiempo de Salida (s)
• Velocidad de Salida (m/s)
Estos datos fueron recogidos de forma manual con un cronómetro y las grabaciones fueron tratadas mediante un programa nombrado Kinovea.
1.2.3. VIRAJE DE NATACIÓN
Para poder realizarlo se efectuó el siguiente procedimiento en la piscina:
• Se ubicó la cámara de video (Nex-5. Sony®) a la altura de los banderines. Desde allí se tuvo un buen enfoque en el punto donde se inicia el viraje (5 metros
297
31º
CERTAMEN JÓVENES INVESTIGADORES / Ciencias de la Tierra y la Vida
de distancia de la pared).
• Se colocó en el interior de la piscina el soporte metálico para fijar la cámara deportiva dentro del agua. Con este dispositivo pude grabar el viraje dentro del agua.
• Por último se emplazó la segunda cámara deportiva a una distancia de 10 metros de la pared en el recorrido de vuelta del nadador. Este punto es donde acaba el viraje
• Se registraron los siguientes datos:
• Tiempo de Viraje (s).
• Velocidad de Viraje (m/s).
Estos datos fueron recogidos de forma manual con un cronómetro y las grabaciones fueron tratadas mediante un programa nombrado Kinovea.
1.3. PROGRAMA DE EJERCICIOS DE ENTRENAMIENTO
Se diseñó un programa de ejercicios de entrenamiento. Los ejercicios que realizaron fueron de Pliometría (ejercicios de fuerza reactiva). Durante la realización de estos ejercicios se utiliza la fuerza, la elasticidad, la inervación del músculo y de sus tejidos circundantes. La mayoría de los ejercicios pliométricos están diseñados para aumentar la velocidad y fuerza reactiva en las extremidades inferiores.
El programa de entrenamientos se ejecutó, o no, por cada nadador dependiendo al grupo al cual perteneciera:
Grupo Entrenamiento (GE): Consta de 5 nadadores que tuvieron que realizar la tabla de entrenamiento 4 días a la semana (lunes-martes-miércoles-jueves) durante 40 minutos en un período de 4 semanas consecutivas, además del entrenamiento habitual del equipo.
Grupo Control (GC): Consta de 5 nadadores que tuvieron que realizar solamente el entrenamiento habitual del equipo durante 4 semanas consecutivas.
1.4.TIEMPOS DEL ESTUDIO
Durante todo el estudio se procedió al registro de todas las variables descritas anteriormente, en los siguientes tiempos.
Tiempo inicial (TI): Primera semana del estudio.
Tiempo final (TF): A las 4 semanas del inicio del estudio.
298
Biomecánica aplicada a la natación: salida y viraje
1.5. PARÁMETROS A ANALIZAR
Los parámetros analizados tienen como finalidad la evaluación de la eficacia del programa de entrenamiento que se ha establecido.
1.5.1.Rendimientos en el salto vertical
Los parámetros que se analizan para poder evaluar el rendimiento en el salto vertical son:
• La altura del salto
• La potencia del salto
• El índice de elasticidad
• La velocidad inicial del salto
• El tiempo final del salto
• El índice de aprovechamiento de los brazos en el salto vertical con contramovimiento CMJ
1.5.2.Rendimientos en la salida / viraje en natación
Los parámetros que se analizan para poder evaluar la salida y el viraje son:
• El tiempo de salida de natación (15m)
• La velocidad de salida de natación (15 m)
• El tiempo de viraje de natación (5+10 m)
• La velocidad de viraje de natación (5+10 m)
2. INFRAESTRUCTURA Y APARATAJE DEL MECANISMO DEL SALTO
La investigación se ha llevado a cabo en las instalaciones deportivas del Club Natación Cerdanyola (Cerdanyola del Valles. Barcelona)
3. MÉTODOS DE ANÁLISIS
Los resultados se mostrarán como media y +/- desviación estándar, considerándose significativas si p<0,05. El análisis de los resultados se realizó mediante el programa Chronojump y un programa de análisis estadístico SPSS 15.0 para Windows
Mediante un análisis estadístico se comprobó la homogeneidad de los dos grupos a estudio.
En el análisis entre-grupos las variables fueron expresadas en incrementos porcentuales del valor basal de cada grupo para poder evaluar el cambio experi-
299
31º CERTAMEN JÓVENES
INVESTIGADORES / Ciencias de la Tierra y la Vida
mentado en la fase final independientemente del valor inicial. Se realizó la prueba U de Mann-Whitney para muestras independientes, por tener la muestra un número reducido de nadadores en cada grupo
En el análisis intra-grupos no fue necesario expresar las variables en incrementos porcentuales del valor basal ya que la comparación estadística en esta medición se realiza dentro de cada grupo con el resultado final y el inicial. Se realizó la prueba Wilcoxon para muestras relacionadas, por tener la muestra un número reducido de nadadores.
El presente proyecto de investigación cumple en todos sus extremos las exigencias del Real Decreto 223/ de 6 de febrero de 2004 acerca de las personas utilizadas para la investigación. El presente proyecto de investigación ha sido sometido al Comité Ético del Centro Escolar “Europa International School” para su valoración y aprobación.
d) Resultados
En relación a las variables demográficas de los 10 nadadores de los 2 grupos de estudio fueron homogéneos respecto a las variables de edad, peso y talla. (Tabla 1)
d.1.Resultados batería de saltos
Se obtuvieron unos resultados en la medición de los tres saltos (SJ, CMJ, ABK), mediante la realización de la batería de máximos de BOSCO y el test de Abalakov. Así pues se realizaron una serie de determinaciones de parámetros (Tiempo total del salto, Altura total del salto, Potencia Total del salto y Velocidad total del salto). Estos datos serán expresados en incrementos porcentuales del valor basal ± SD para poder evaluar el cambio experimentado en la fase final independientemente del valor inicial.
Como se puede ver, en estas tablas, el grupo entreno ha mejorado su porcentaje. Siendo esta mejoría estadísticamente significativa en todos los datos medidos del salto SJ y CMJ. En el salto ABKV no se objetivan diferencias significativas entre grupos. Por el contrario el grupo control ha mejorado levemente su rendimiento sin ser significativo.
300
EDAD PESO TALLA Grupo Entreno 17,60 ± 3,2863 años 70,20 ± 4,76 kg 180,6 ± 0,0991 cm Grupo Control 17,50 ± 4,2761 años 64,7142 ± 9,9952 kg 173,38 ± 0,1151 cm
Tabla 01
Variables demográficas.
Biomecánica aplicada a la natación: salida y viraje
Para poder evidenciar que no existe diferencias significativas con respecto al valor basal del grupo control se realizó la prueba Wilcoxon para muestras relacionadas, por tener la muestra un número reducido de nadadores. Este cálculo estadístico se realizó, con los parámetros en números absolutos obtenidos de la batería de saltos, para poder afirmar que los cambios se relacionaban exclusivamente con la introducción y realización de un entrenamiento pliométrico del tren inferior.
d.2.Resultados tiempos y velocidades en las salidas y virajes Comparación entre los dos grupos
Para poder comparar mejor a cada uno de los grupos se han convertido los valores absolutos en variaciones porcentuales (%) con respecto a su valor basal. De esta forma se pueden evidenciar incrementos o descensos de dichos valores con mayor objetividad.
Tabla 02
% Tiempo Total de la Salida medido en segundos (STT).
NºN= Número total de nadadores
% Tiempo SF vs SB= Incremento porcentual del tiempo de la salida final respecto al tiempo de la salida basal
SD= Desviación Estándar *p< 0.05;** p<0.01. Diferencias estadísticamente significativas intergrupos
Tabla 03
% Tiempo Total del Viraje medido en segundos (VTT).
NºN= Número total de nadadores
% Tiempo SF vs SB= Incremento porcentual del tiempo de la salida final respecto al tiempo de la salida basal
SD= Desviación Estándar *p< 0.05;** p<0.01. Diferencias estadísticamente significativas intergrupos
Tabla 04
% Velocidad Total de la Salida medido en metros/segundos (SVT).
NºN= Número total de nadadores
% Velocidad SF vs SB= Incremento porcentual de la velocidad de la salida final respecto a la velocidad de la salida basal
SD= Desviación Estándar *p< 0.05;** p<0.01. Diferencias estadísticamente significativas intergrupos
301
NºN % TIEMPO SF VS SB SD Grupo Entreno 4 -6,3063* 10,10070 Grupo Control 5 1,8312 2,55281 NºN % TIEMPO SF VS SB SD Grupo Entreno 4 -13,2257 * 7,97546 Grupo Control 5 2,0987 2,30551 NºN % TIEMPO SF VS SB SD Grupo Entreno 4 7,78255* 13,009062 Grupo Control 5 -1,74883 2,466329
31º CERTAMEN JÓVENES INVESTIGADORES / Ciencias de la Tierra y la Vida
Tabla 05
% Velocidad Total del Viraje medido en metros/segundos (VVT).
NºN= Número total de nadadores
% Velocidad SF vs SB= Incremento porcentual de la velocidad de la salida final respecto a la velocidad de la salida basal
SD= Desviación Estándar *p< 0.05;** p<0.01. Diferencias estadísticamente significativas intergrupos
d.3.Resultados relación entre potencia saltos con tiempo y velocidad en salidas y virajes.
Tabla 06
Relación de la Potencia del Salto SJ con las variables de la salida en natación.
*p< 0.05;** p<0.01. Diferencias estadísticamente significativas
Tabla 07
Relación de la Potencia del Salto SJ con las variables del viraje en natación.
*p< 0.05;** p<0.01. Diferencias estadísticamente significativas
Tabla 08
Relación de la Potencia del Salto CMJ con las variables de la salida en natación.
*p< 0.05;** p<0.01. Diferencias estadísticamente significativas
Tabla 09
Relación de la Potencia del Salto CMJ con las variables del viraje en natación
*p< 0.05;** p<0.01. Diferencias estadísticamente significativas
302
DE RANGOS CON SIGNO DE WILCOXON NºN % TIEMPO SF VS SB SD Grupo Entreno 4 15,91758* 9,811156 Grupo Control 5 -2,01546 2,219701 POTENCIA SJ (%) TIEMPO SALIDA (%) 0,017* VELOCIDAD SALIDA (%) 0,036* POTENCIA SJ (%) TIEMPO VIRAJE (%) 0,014* VELOCIDAD VIRAJE (%) 0,031* POTENCIA CMJ (%) TIEMPO SALIDA (%) 0,036* VELOCIDAD SALIDA (%) 0,050* POTENCIA SJ (%) TIEMPO VIRAJE
0,032* VELOCIDAD VIRAJE (%) 0,012*
PRUEBA
(%)
Biomecánica aplicada a la natación: salida y viraje
d.4.Discusión y valoración de los datos obtenidos
Los resultados obtenidos en este estudio con nadadores amateurs tras 4 semanas de entrenamiento, son equiparables a los obtenidos en nadadores de elite tras someterse a un entreno pliométrico de 6 semanas de evolución (Tabla 10).
Se aleatorizó un “grupo control” para poder afirmar que el incremento en la capacidad de salto en los tres saltos medidos, es debido exclusivamente a la aplicación del entrenamiento pliométrico.
En mi estudio se implementó un entrenamiento pliométrico de tren inferior de menor duración (4 semanas) obteniendo un incremento estadísticamente significativo de la altura de salto, tiempo de salto, velocidad y potencia de salto, en los saltos SJ y CMJ. Pero este dato se tenía que corroborar logrando un menor tiempo con una mayor velocidad en la salida y virajes en la natación.
En la mayoría de los estudios las mejoras en la habilidad de salto en el laboratorio no se traducen en la mejoría del rendimiento en la salida. Por el contrario en mi trabajo si se objetivan mejorías significativas en las cualidades de los saltos SJ y CMJ. Estas mejorías se traducen en mejorías significativas en el tiempo, velocidad de salida y mejorías significativas en el tiempo, velocidad de viraje.
El cálculo de la potencia de los saltos no se debe de comparar ni realizar con las mismas ecuaciones que cuando se calcula la potencia de los saltos en el laboratorio.
A pesar de ello en mi trabajo objetivamos una relación significativa del porcentaje de variación de la potencia de los Saltos SJ y CMJ con todas las variables de tiempo y velocidad en la salida y el viraje.
e) Conclusiones
• La altura media alcanzada por los nadadores de mi equipo, en los tres saltos medidos (SJ, CMJ, ABK) tras 4 semanas de entrenamiento , es equiparable a la altura media de nadadores de élite tras 6 semanas de entrenamiento.
• Tras 4 semanas de entrenamiento pliométrico se evidencia una mejoría significativa del rendimiento en la natación (mejoría de tiempo y velocidad en salida y viraje).
303
NIVEL SJ
Garrido y cols (2012) Nadadores Alto Nivel 24,75 ± 3,47 25,72 ± 3,36 29,78 ± 5,44 Fontanals y cols (2017) Club Natación Amateur 22,33 ± 5,63 25,11 ± 7,42 30,43 ± 6,66
CMJ ABK
Valores medios
Desviación Estándar.
Tabla 10 Capacidad de salto en nadadores.
±
31º
CERTAMEN
JÓVENES
INVESTIGADORES / Ciencias de la Tierra y la Vida
• El incremento de potencia en los saltos SJ/CMJ tras 4 semanas de entrenamiento pliométrico se correlaciona directamente con la mejoría del tiempo y la velocidad en salida/viraje.
• Así pues la planificación de Entrenamiento Pliométrico de Tren Inferior de 4 semanas en nadadores amateurs puede ser suficiente para mejorar el rendimiento en las salidas/virajes.
BIBLIOGRAFÍA Y WEBGRAFÍA
Acero, JA. (2014). “Principio de la confiabilidad en la medición de la fuerza: Tecnología Biomecánica”. Disponible en:
http://g-se.com/es/biomecánica/blog/princiio-de-la-confiabilidad-en-la-medición-de-la-fuerza-tecnologia-biomecanica (Consultado:15 enero 2017).
Arellano R, Balius X, Escoda P. (2007). “Campeonato del mundo de natación: características técnicas de las pruebas de 50 m”. ISSN 1136-0003 pp. 39-44. Disponible en:
www.ugr.es/~swimsci/SwimmingScience/page4/page16/page57/.../Documento06.pdf (Consultado: 16 enero 2017).
Arellano R, LLana S, Tella V, Morales E, Mercade J. (2005).“Estudio de la fuerza de impulso en la salida de natación” Trabajo presentando en “5 Congreso internacional de Técnicos de natación”. Madrid 21-23 Octubre 2005. Disponible en:
www.ugr.es/~swimsci/SwimmingScience/page4/page16/.../AETN_05_Salidas.pdf (Consultado: 3 abril 2017).
Arellano R. (2010). “Análisis Cinemático de la competición en Natación”. Publicado en XI campeonato de España “Open” Absoluto . 22-25 Abril 2010. Disponible en:
www.rfen.es/publicacion/campeonatos/files/rfen100/.../AnalisisCompeticion2010.pdf (Consultado: 10 septiembre 2017).
Ayala, C. (2012). “Análisis biomecánico de la natación”. Disponible en:
https://prezi.com/jxytmjeoyhno/analisis-biomecanico-de-la-natacion/ (Consultado: 15 enero 2017).
“Biomecánica de la Natación” Especial Mundial de natación 2013. Disponible en: http://principiodeintercambio.blogspot.com.es/2013/07/biomecanica-de-la-natacion-especial.html (Consultado: 16 enero 2017).
304
Biomecánica aplicada a la natación: salida y viraje
Bosco, C. (1994).“La valoración de la fuerza con el test de Bosco”. Disponible en:
https://www.casadellibro.com/...valoracion-de-la-fuerza-con-el-test-de-bosco/.../4719 (Consultado: 14 enero 2017).
Canó G. (2013). “Cuaderno de Biomecánica de natación”. Disponible en:
https://previa.uclm.es/profesorado/...Cuaderno/Ejemplosdecuadernos/GabrielCano.pdf (Consultado:15 enero 2017).
Carrera D, Luque J. (2013). “Revisión documental acerca de los efectos en el rendimiento de un nadador tres entrenaminetos de fuerza y potencia en seco y/o dentro del agua” , Revista digital de Educación Física. Año 5. Num 25. Disponible en http://emasf.webcindario.com (Consultado 16 enero 2017).
E.Makover, Michael. (2011). “Medline Plus” Biblioteca Nacional de Medicina de EEUU – NIH- Institutos Nacionales de la Salud. Disponible en: http://www.nlm.nih.gov/medlineplus/spanish/ency/esp_imagepages/19841.htm
(Consultado: 29 agosto 2017).
Gutierrez, M. (1997). “Bases biomecánicas de la natación” Disponible en: https://upcommons.upc.edu/bitstream/handle/2099/6636/Article10.pdf?sequence=1 (Consultado:16 enero 2017).
Izquierdo, Mikel. (2008). “Biomecánica y Bases Neuromusculares de la Actividad Física y el Deporte”.
Fuentes BDL, García López F, Arellano R. “Análisis Cinemático y cinético de las salidas en natación en nadadores de alto nivel” Comunicaciones técnicas, ISSN 1135-111X, Nº 3, 2003, p.p. 3-23. Disponible en: https://Análisis Cinemático y cinético de las salidas en natación en nadadores de alto nivel. (Consultado: 15 enero 2017).
Llana S. (2008). “ El anàlisis biomecánico en natación”. Disponible en: http://www.notinat.com.es/docs/analisisbomecanicoennatación.pdf (Consultado: 23 enero 2017).
Llana S, PriegoJI, Pérez P, Soriano, Lucas A . (2013) ”La investigación en biomecánica aplicada a la natación: Evolución histórica y situación actual”. Disponible en:
http://cdeporte.rediris.es/revcaf/Numeros%20de%20revista/.../Vol6_n2_Llana_Priego.Pdf (Consultado: 15 enero 2017).
Llana S, Priego JI: (2013) “La investigación en biomecánica aplicada a la natación olímpica: evolución histórica y situación actual” Disponible en: http://revistas.uam.es (Consultado: 22 enero 2017).
Manzaneda Martínez, Antonio Manuel (2008). “La rotura del tendón de Aquiles en el deporte y su protocolo de recuperación”. Disponible en:
http://www.efdeportes.com/efd127/la-rotura-del-tendon-de-aquiles-en-el-deporte.htm (Consultado: 3 septiembre 2017).
305
31º CERTAMEN JÓVENES INVESTIGADORES / Ciencias de la Tierra y la Vida
Pardo M. (2016). “Biomecánica de la Natación”. Disponible en: https://www.iesjuangris.com/index.php?option=com_attachments&task=download (Consultado: 16 enero 2017).
Rosa A. (2014).“Biomecanica de la actividad física y el deporte: objetivos, principios y aparatos de medición” EFDeportes. Com, Revista Digital. Buenos Aires, Año 18, Nº 188, Enero 2014. Disponible en: http://www.efdeportes.com/ (Consultado: 22 enero 2017).
Sánchez Molina JA, Arellano R. “El anàlisis de la competición en natación: estudio de la situación actual; variables y metodologia”. Comunicaciones técnicas, ISSN 1135-111X, Nº 1, 2003, p.p. 55-80. Disponible en: https://revistasdigitales.csd.gob.es/index.php/ICD/article/view/284 (Consultado: 15 enero 2017).
“Análisis biomecánico de la técnica en natación: Programa de control del deportista de alta competición” . Icd- N°32 Estudios sobre Ciencias del Deporte. Serie de Investigación Ministerio de Educación, Cultura y Deporte Consejo Superior de Deportes 2001 Disponible en: http://sede.educacion.gob.es/.../analisis-biomecanico-de-la-tecnica-en-natacion--programa-d... (Consultado: 17 enero 2017).
306
TECNOLOGÍAS E INGENIERÍAS
PRIMER PREMIO Y PREMIO ALAN TURING|
- 310 -
Prueba de concepto sobre la construcción de prótesis accesibles
JAVIER SIMANCAS RUESGAS
PRIMER PREMIO |
- 322 -
- 335 -
Sea energy project: la revolución de las olas ARIADNA GONZÁLEZ NAVARRO
Factorización cuántica del número 15 JAVIER PAGÁN LACAMBRA
SEGUNDO PREMIO |
- 344- 356 -
Comunicación inalámbrica mediante luz visible: Implementación con Arduino UNO DAVID LOZANO CAMPILLO
Valorización de los residuos de marisco. Síntesis de nanopartículas de quitosano con efecto antimicrobiano XAVIER MANUEL DE RADA PIÑEIRO
TERCER PREMIO |
Baby Safety: Desarrollo de sistemas para la prevención de la muerte súbita del lactante
IRIA OLLERO CADILLA
12 Terrones y 4 cafés
LIDIA SOFÍA VICENTE GÓMEZ
Diseño y construcción de un túnel aerodinámico para la visualización del flujo alrededor de objetos y la comparación de estos con dinámica de fluidos computacional
CARLOS ESTEBAN NAVARRO Y CARLOS BELLANCO ORTIZ
308
- 370- 382- 395 -
- 405 -
TECNOLOGÍAS E INGENIERÍAS
PREMIO ESPECIAL DE LA UNIVERSIDAD POLITÉCNICA DE MADRID |
Generating success – ecomochila SERGIO BRAVO RODRÍGUEZ Y MARCOS JÁTIVA MUÑOZ
ACCESIT |
- 414 -
Esferificaciones de lactasa como tratamiento para la intolerancia a la lactosa: Efectividad de la lactasa inmovilizada sobre dos variables: concentración de alginato de sodio y tiempo transcurrido JAVIER RODRÍGUEZ CASTELLÓ
309
Prueba de concepto sobre la construcción de prótesis accesibles
/ PRIMER PREMIO
AUTOR | JAVIER SIMANCAS RUESGAS
COORDINADOR | RAÚL MARTÍN GÓMEZ
CENTRO | IES PINTOR ANTONIO LÓPEZ
CIUDAD | TRES CANTOS-MADRID
RESUMEN |
Gracias a la impresión 3D y a la electromiografía las prótesis se han desarrollado en gran medida y cuentan con numerosas funcionalidades hasta ahora impensables. El problema que presentan es su precio extremadamente elevado.
El objetivo de este proyecto es comprobar si es posible producir una prótesis funcional a partir de la impresión 3D y programación en Arduino y Android. Para ello se ha realizado un estudio del mercado actual y se ha contrastado según su relación calidad-precio. El siguiente paso ha sido seleccionar un modelo 3D gratuito, el cual se ha impreso y se han ensamblado sus piezas y sus componentes mecánicos. A continuación, se ha elaborado una aplicación Android y un programa en Arduino que permite controlar los movimientos de la prótesis.
El desarrollo del proyecto ha resultado ser exitoso: se ha conseguido construir una prótesis con características similares a las de las comercializados, con lo que se ha comprobado que es posible hacerlas accesibles mediante la impresión 3D.
Palabras clave: Android, Arduino, Brazo, Electromiografía, Impresión 3D, Prótesis.
TECNOLOGÍAS E INGENIERÍAS 310 PREMIO ESPECIAL ALAN TURING, DOTADO POR LA SOCIEDAD CIENTÍFICA INFORMÁTICA DE ESPAÑA Y LA CONFERENCIA DE DECANOS Y
INGENIERÍA INFORMÁTICA DE ESPAÑA
DIRECTORES DE
ABSTRACT |
Thanks to the 3D printouts and the electromyography, prosthetics have developed intensely and had made a huge variety of movements possible. The problem is that their price is extremely high.
The aim of this project is to prove whether is possible to produce a low-cost prosthetic hand by using 3D printouts and Arduino code and Android app. In order to do that a market study has been carried and it has been contrasted with the price and quality relation. The next step was selecting a free 3D model to print and connect all his mechanical parts. Once all the pieces were joined, an Android app and an Arduino code were assembled to control the prosthetic hand.
The project proved to be successful: a prosthetic hand was made with similar characteristics to those prosthetics’ products commercialized. This proves that it is possible to make them affordable to the society.
Keywords: 3D printouts, Android, Arduino, Arm, Electromyography, Prosthetic.
311
CERTAMEN JÓVENES INVESTIGADORES / Tecnologías e Ingenierías
AGRADECIMIENTOS
Quiero dar las gracias a Raúl por el apoyo que me ha prestado en todo momento y por la gran dedicación en este proyecto; sin su ayuda no habría sido posible llevarlo a cabo.
A mis padres y hermanos, por haberme soportado a lo largo de este trabajo y haber contribuido con sus diversos puntos de vista.
Al IES Pintor Antonio López por haberme facilitado los medios necesarios para la construcción del prototipo.
Por último, a la empresa Autofabricantes que me ha ayudado a comprender la realidad del sector desde la perspectiva empresarial.
INTRODUCCIÓN
Las prótesis, al igual que todos los demás productos tecnológicos, se encuentran en un estado de auge continuo. Los avances de los últimos años han provocado un desarrollo sin precedentes que ha ocasionado un aumento de su sofisticación. Esta modernización se debe principalmente a los avances de dos campos en particular: la electromiografía y la impresión 3D.
• La aparición de prótesis mioélectricas ha supuesto una revolución en la biónica, desembocando en una gran variedad de funciones y posibilidades.
• La impresión 3D se ha adaptado de una forma prácticamente perfecta a la producción de estos artículos.
En este sentido lo que se ha conseguido ha sido perfeccionar estos artículos y se han comenzado a fabricar de forma especializada con materiales de alta calidad. La comercialización de estos productos ha supuesto un encarecimiento de las prótesis asumible por una ínfima parte de la población.
En ocasiones aparecen noticias de cómo, gracias a subvenciones o al crowdfunding, se ha conseguido adquirir un producto prostético de última generación. En la mayoría de los casos se trata de niños, que tienen una gran repercusión mediática, pero ¿qué ocurre con las demás personas que no cuentan con tanta difusión en los medios?
Para intentar responder a esta pregunta este proyecto busca comprobar si es posible hacer accesibles las prótesis, en este caso una mano, a partir de impresiones 3D con un coste bajo. Para ello la construcción se ha dividido en tres fases.
La primera ha consistido en analizar el mercado protésico actual y el margen de beneficios de cada producto. Se han estudiado las principales compañías
31º
312
Prueba de concepto sobre la construcción de prótesis accesibles
que los comercializan y se ha comparado sus relaciones de calidad-precio y coste-beneficio.
A continuación, se ha seleccionado un modelo 3D gratuito como prototipo a realizar y se ha procedido al montaje de la parte mecánica. La impresión, el ensamblaje y la electrónica engloban la mayor parte de este proceso.
Finalmente se ha realizado un programa en lenguaje Arduino y una aplicación Android para controlar la prótesis. Esta ha sido la parte más laboriosa, puesto que tanto el programa como la aplicación han sido escritos desde cero.
Por último, el proyecto concluye con un pequeño resumen de todas las fases de este y una valoración del resultado final.
1. ESTADO DEL ARTE
1.1. TECNOLOGÍA ACTUAL
Como se ha comentado previamente, las dos tecnologías predominantes que impactan sobre este tipo de proyectos son la electromiografía y la impresión 3D.
1.2. ELECTROMIOGRAFÍA
La electromiografía se define como la técnica de diagnóstico de la actividad eléctrica producida por los músculos. En el caso de las personas que han sufrido algún tipo de amputación o malformación estos impulsos se siguen produciendo, pero no hay ningún músculo que reciba esta señal. Las prótesis que emplean esta técnica detectan estas señales EMG y las convierten en movimiento, habilitando al portador a mover la prótesis como si fuera su propio cuerpo.
Esta tecnología todavía cuenta con algunas limitaciones, como el ruido (interferencias) en el procesado de las señales. Este problema, sumado a la dificultad técnica de este procedimiento y a la falta de medios, ha hecho que se haya descartado a la hora de elaborar el prototipo.
1.1.2. IMPRESIÓN 3D
La impresión 3D es una tecnología que ha revolucionado la ciencia. Consiste en la impresión de modelos tridimensionales en distintos materiales, siendo el más habitual el ácido poliláctico (PLA). La impresora, en el caso del PLA, calienta el filamento del material hasta llegar a su punto de fusión, y entonces empieza a construir el modelo 3D superponiendo capas de plástico.
Gracias a la impresión 3D la personalización e individualización de un modelo estándar de prótesis se ha facilitado en gran medida. En Internet podemos en-
313
CERTAMEN JÓVENES INVESTIGADORES / Tecnologías e Ingenierías
contrar cientos de modelos gratuitos, de entre los cuales se ha seleccionado una prótesis para el prototipo.
1.2. PRINCIPALES FABRICANTES
Para concretar y puesto que el prototipo se trata de un brazo, el análisis de mercado se ha realizado solamente de los llamados “brazos robots”.
En el mercado protésico actual existe un oligopolio entre las principales compañías protésicas, que comercializan sus productos a un precio elevado. El portal Vocativ realizó el estudio “What a $100,000 Bionic Arm Can Do” [3] en el que analiza las funciones de las prótesis y su precio.
El modelo más simple, Robohand, tiene un precio de 2,000 $ y únicamente permite abrir y cerrar los dedos. Un modelo de gama media como el bebionic3 permite una movilidad más completa habilitando el movimiento independiente de los dedos y de la muñeca. Esta prótesis asciende a 30,000 $. Finalmente, el modelo con más funcionalidades es el DEKA Arm, que es controlado mediante electrodos situados en el pie y tiene un precio de más de 100,000 $.
1.3. ELECCIÓN DEL PROTOTIPO
Para el prototipo se han estudiado varios modelos 3D gratuitos. A la hora de elegir el definitivo se ha tenido en cuenta la cantidad de material que necesita y los movimientos que permite realizar. El modelo que se ha seleccionado ha sido publicado por Mahdi Elsayed Hussein en su tesis “3D Printed Myoelectric Prosthetic Arm” [1]. Este brazo es una modificación del proyecto Inmoov [2] Langevin, que consiste en la fabricación de un robot a tamaño real mediante la impresión 3D.

El código para la programación del prototipo no está publicado en Internet por lo que ha sido necesario implementarlo. Para ello se ha optado por el lenguaje Arduino, que es una plataforma de creación de electrónica de código abierto.

314
31º
Figura 1a
Modelo 3D del pulgar.
Figura 1b
Modelo 3D del antebrazo.
Prueba de concepto sobre la construcción de prótesis accesibles
Los modelos 3D se descargaron en un formato stl1 de CAD2, que define la geometría de objetos tridimensionales.


Para procesarlos se ha hecho uso del programa Ultimaker Cura3. Una vez procesados se guardaron como formato gcode4, ya listo para ser impreso usando la impresora Witbox 2. El proceso de modificación de los archivso stl se explicará más adelante. Una vez seleccionado este prototipo la siguiente fase es su construcción.
2. CONSTRUCCIÓN DEL PROTOTIPO
Tras haber seleccionado el modelo a construir se ha procedido a elaborar un plan de trabajo para su construcción. El montaje ha comenzado con diversas modificaciones en los modelos 3D y su posterior impresión. A continuación,
se han ensamblado todas sus piezas y elementos necesarios para su correcto funcionamiento. La última fase se corresponde con la implementación del código Arduino y la elaboración de una aplicación Android para el control del prototipo.
2.1. DISEÑO E IMPRESIÓN 3D
En primer lugar, se estudiaron los modelos 3D escogidos para maximizar la eficacia de la impresión. Para ello se han tenido en cuenta dos factores relacionados
1 Standard Triangle Language
2 Diseño asistido por computadora
3 https://ultimaker.com/en/products/ultimaker-cura-software
4 Conocido como RS-274, lenguaje de programación más usado en control numérico

315
Figura 1c
Modelo 3D de la mano completa.
31º CERTAMEN JÓVENES INVESTIGADORES / Tecnologías e Ingenierías
entre ellos: la cantidad de material de soporte y el tiempo de impresión.
El material de soporte consiste en capas finas de la impresión cuya función es sostener las partes de la impresión que no tienen ninguna base, por ejemplo, los orificios que sirven de unión entre las partes articuladas de las manos.
El tiempo de impresión depende en parte de esta variable: a mayor cantidad de material de soporte mayor tiempo de impresión.

Se han modificado los planos para convertir la mano, que era la derecha, en la izquierda y se ha procedido a la impresión.
Por último, debido a los desperfectos de la impresión se han lijado y pulido las piezas y orificios necesarios para el correcto ensamblaje del prototipo.
En la siguiente tabla se muestra los componentes de la prótesis en relación con el número de piezas, el tiempo de impresión y el peso correspondiente a cada una.

PROCESO DE IMPRESIÓN
316
Figura 3a
Ejemplo piezas impresas.
Figura 3b
Ejemplo de piezas acondicionadas.
Tabla 01
Proceso de impresión.
COMPONENTE PIEZAS TIEMPO DE IMPRESIÓN PESO (GR) Antebrazo 2 10:28:00 120 Muñeca 2 1:47:00 20 Palma 2 5:04:00 56 Pulgar 2 1:39:00 17 Índice 3 1:02:00 13 Corazón 3 1:26:00 12 Anular 3 1:30:00 12 Meñique 3 0:52:00 7 Conectores servomotor 3 0:21:00 4 TOTAL 23 24:09:00 261
Prueba de concepto sobre la construcción de prótesis accesibles
2.2. MECÁNICA
Una vez impresas todas las partes del prototipo se elaboró el mecanismo de movimiento de los dedos. Mediante hilo de nylon se simula el tendón del dedo. Al contar el modelo con tres falanges permite que haya tres puntos articulables, imitando a un dedo real. Mediante la tensión de un extremo o del otro se realiza la flexión o elongación del dedo. Una vez completado todo el mecanismo se unieron todas las piezas mediante alambre para minimizar el coste.

Ya concluido el ensamblado se conectaron los tres primeros servomotores5 al hilo de nylon y el cuarto servomotor a la muñeca. Mediante el giro del servomotor se tensan o se destensan los “tendones” y comunican el movimiento al dedo. El cuarto motor tiene como única función el giro de la muñeca.

Para alimentar los motores inicialmente se probó con 8 pilas alcalinas AAA. Al no aportar el amperaje necesario se optó por emplear una batería de polímero de Litio de 10000mAh. Este tipo de alimentación tiene la ventaja de ser recargable.
Posteriormente se conectaron los motores y la batería a la placa Arduino, especificada más adelante.
2.3. ELECTRÓNICA
Con el ensamblaje y la mecánica ya terminados se organizó la fase de programación. Los elementos esenciales han sido la placa Arduino y la aplicación Android, componentes sin los que el brazo no podría moverse. Las especificaciones se encuentran desarrolladas en los Anexos del trabajo original.
De cara a obtener una óptima integración entre la placa y la aplicación, se determinó escribir el código en lenguaje Arduino mediante la web Bitbloq y la aplicación Android en la web MIT App Inventor. Ambos sitios web permiten la programación por bloques, que facilita mucho su compilación y la detección de errores.
317
5 Motor que permite controlar el giro del mecanismo. Está diseñado para moverse una determinada cantidad de grados y luego mantenerse fijo en esa posición.
Figura 4
Servomotores unidos a los hilos de los dedos.
Figura 5
Mecanismo del dedo, por Mahdi Elsayed Hussein. [1]
CERTAMEN JÓVENES INVESTIGADORES / Tecnologías e Ingenierías
El funcionamiento del brazo es sencillo. La app6 envía información mediante Bluetooth a la placa Arduino, que la transforma en movimiento. Dependiendo de la información que se envíe los movimientos serán distintos.
Los datos que se transmiten a la placa pueden ser muy variados.
En la aplicación existen tres modos de control: El primero funciona por botones y sliders7, cada uno asociado a un dedo y a una acción de abrir y cerrar. El siguiente modo consiste en un control por voz en el que al acercar el móvil al oído se activa el reconocimiento por voz. Por último, la aplicación también dispone de un control consistente en el uso del giroscopio del móvil: según la posición del teléfono en las coordenadas X, Y y Z del espacio el prototipo realiza un movimiento acorde a esa posición.

Los tres modos de control se basan en enviar datos a la placa; para simplificar el código, los tipos de datos son semejantes.
El control por voz y el control por botones envían el mismo tipo de información: el dedo que se va a mover y la posición a la que hay que moverlo (abierto o cerrado).
6 Aplicación móvil.
7 Control deslizante con el que un usuario puede establecer un valor moviendo un indicador, generalmente en forma horizontal.


318
31º
Figura 6 Comandos por botones.
Figura 7 Comandos por voz.
Figura 8 Comandos por giroscopio.
Los tres modos de control se basan en enviar datos a la placa; para simplificar el código, los tipos de datos son semejantes.
Prueba de concepto sobre la construcción de prótesis accesibles
El control por voz y el control por botones envían el mismo tipo de información: el dedo que se va a mover y la posición a la que hay que moverlo (abierto o cerrado).
Por otro lado, el slider y el control del giroscopio se basan en el mismo principio: la información que se envía consiste en el dedo y la posición parcial a la que hay que moverlo. El ángulo de giro que permite el servomotor es de 180º, por lo que para convertir la posición del slider en la posición parcial del dedo se divide el slider en 180 partes.
Por otro lado, el slider y el control del giroscopio se basan en el mismo principio: la información que se envía consiste en el dedo y la posición parcial a la que hay que moverlo. El ángulo de giro que permite el servomotor es de 180º, por lo que para convertir la posición del slider en la posición parcial del dedo se divide el slider en 180 partes.
En el caso del giroscopio la conversión es más complicada. El eje X se corresponde con el movimiento de la muñeca y el Y con el movimiento de los dedos. El rango de datos que aporta el giroscopio varía entre -10 y 10, lo que implica que hay que convertirlo a un intervalo positivo. Para ello se suma 10 unidades a cualquier dato que se obtenga y el intervalo pasa a ser de 0 a 20. Finalmente, para transformar el dato en un ángulo para el motor hay que multiplicarlo por el cociente de 180 entre 20, es decir, 9.
En el caso del giroscopio la conversión es más complicada. El eje X se corresponde con el movimiento de la muñeca y el Y con el movimiento de los dedos. El rango de datos que aporta el giroscopio varía entre -10 y 10, lo que implica que hay que convertirlo a un intervalo positivo. Para ello se suma 10 unidades a cualquier dato que se obtenga y el intervalo pasa a ser de 0 a 20. Finalmente, para transformar el dato en un ángulo para el motor hay que multiplicarlo por el cociente de 180 entre 20, es decir, 9.
Si, por ejemplo, el giroscopio recibe el dato -7 antes de enviarlo por Bluetooth le suma 10 unidades y lo multiplica por 9. Por tanto, el resultado, 27, sería el equivalente al grado de la posición a la que tendría que girar el servomotor.
Si, por ejemplo, el giroscopio recibe el dato -7 antes de enviarlo por Bluetooth le suma 10 unidades y lo multiplica por 9. Por tanto, el resultado, 27, sería el equivalente al grado de la posición a la que tendría que girar el servomotor.
Mientras que en el primer caso los datos enviados son caracteres alfabéticos (dos letras, una asociada al dedo y otra a la posición de estirado o abierto) en el segundo se trata de caracteres alfanuméricos (la letra asociada al dedo y el ángulo al que se debe mover el motor).
Mientras que en el primer caso los datos enviados son caracteres alfabéticos (dos letras, una asociada al dedo y otra a la posición de estirado o abierto) en el segundo se trata de caracteres alfanuméricos (la letra asociada al dedo y el ángulo al que se debe mover el motor).
La placa recibe los datos transmitidos por Bluetooth y los procesa. Si se reciben datos cuya longitud es uno se asocia ese dato con una variable. Estas variables son letras, cada una asociada a un dedo y al movimiento que este realiza. Si la longitud es igual a cuatro los datos están formados por una letra y un número de tres cifras. En este caso la letra está asociada al dedo que se va a mover, y el número a la posición que debe tomar el servomotor.
La placa recibe los datos transmitidos por Bluetooth y los procesa. Si se reciben datos cuya longitud es uno se asocia ese dato con una variable. Estas variables son letras, cada una asociada a un dedo y al movimiento que este realiza. Si la longitud es igual a cuatro los datos están formados por una letra y un número de tres cifras. En este caso la letra está asociada al dedo que se va a mover, y el número a la posición que debe tomar el servomotor.
CONCLUSIONES
La situación actual es bastante prometedora. Las técnicas actuales como la electromiografía y la impresión 3D están siendo cada vez más utilizadas, aportando funcionalidad y reduciendo costes y tiempo de fabricación. Si a esto se le
319
Figura 9
Ecuación de la extrapolación de los datos del giroscopio.
Figura 10 Bloque de programación de la ecuación.
9. Ecuación de la extrapolación de los datos del giroscopio
10. Bloque de programación de la ecuación
31º CERTAMEN JÓVENES INVESTIGADORES / Tecnologías e Ingenierías
añade el crecimiento de modelos gratuitos que se encuentran disponibles en internet y los códigos de programación de libre uso que se puedan publicar, es previsible que mejore la accesibilidad a procesos de fabricación de prótesis “low cost” perfectamente funcionales.
Esto es lo que se ha querido demostrar y se ha corroborado en este proyecto:
• Se ha obtenido gratuitamente modelos 3D y se han modificado según nuestras necesidades.
• Se ha imprimido y se ha realizado el ensamblaje de las piezas.
• Se han integrado en el modelo las partes mecánicas y la fuente de alimentación.
• Se ha realizado la programación de la aplicación y el código de control. Esta fue la parte más compleja del proyecto.
Como resultado, se ha conseguido construir una prótesis que presenta las mismas funcionalidades que las que se comercializan en el rango de gama media, con un coste sensiblemente inferior, y con la posibilidad de hacerlas accesibles a personas que no puedan adquirirlas en el mercado.
El coste detallado del prototipo ha sido el siguiente:
ESTUDIO ECONÓMICO
El gasto energético de la impresora durante el proceso de impresión se ha desestimado puesto que es mínimo (65 céntimos). Tampoco está contemplado el coste de mano de obra.
320
Tabla 02
COMPONENTE UNIDADES PRECIO UNIDAD/KG IMPORTE Servomotor 4,00 4,96 € 19,84 € Placa Arduino 1,00 34,90 € 34,90 € PLA 0,30 11,94 € 3,58 € Fuente alimentación 1,00 14,99 € 14,99 € COSTE TOTAL 73,31 €
Coste del prototipo.
Prueba de concepto sobre la construcción de prótesis accesibles
BIBLIOGRAFÍA
ALVA CORAS, Carlos Arturo, 2012. Procesamiento de señales de electromiografíasuperficialparaladeteccióndemovimientodedosdedosdelamano [en línea]. Tesis para optar el título profesional de ingeniero electrónico. Universidad Ricardo Palma, Facultad de Ingeniería Electrónica [consulta: 13 de octubre de 2018]. Disponible en: http://repositorio.urp.edu.pe/bitstream/handle/urp/416/Alva_ca.pdf?sequence=1&isAllowed=y
[1] ELSAYED HUSSEIN, Mahdi, 2004. 3D Printed Myoelectric Prosthetic Arm [en línea]. Graham Brooker, dir. Tesis doctoral. Australian Centre for Field Robotics, Sydney. [consulta: 11 de abril de 2018]. Disponible en:
https://drive.google.com/file/d/0B70A6QACCyueR3hOSnJBUVk1ZHM/view
[2] LANGEVIN, Gael (2018). Inmoov [en línea]. [consulta: 8 de abril de 2018]. Disponible en: http://inmoov.fr/
[3] MARKOWITZ, Eric (2014). “What a $100,000 Bionic Arm Can Do” [en línea]. En Vocativ. [consulta: 26 de septiembre de 2018]. Disponible en:
https://www.vocativ.com/money/industry/prosthetic-boom-3d-printed-mind-controlled-limbs/index.html
RAEZ, M; HUSSAIN, M; MOHD-YASIN, F. “Techniques of EMG signal analysis: detection, processing, classification and applications”. En US National Library of Medicine [en línea]. [consulta: 7 de julio de 2018]. Disponible en:
https://www.ncbi.nlm.nih.gov/pmc/articles/PMC1455479/
Nota: las imágenes, modelos 3D, diagramas y tablas cuyo origen no está especificado son de fuente propia.
A continuación, se adjunta un código QR el cual enlaza a una carpeta de Google Drive en la que se pueden descargar la aplicación Android y el código Arduino. En dicha carpeta se pueden visualizar dos videos del prototipo además del trabajo original entregado en el IES Pintor Antonio López en toda su extensión.

321
Sea energy project: la revolución de las olas
/ PRIMER PREMIO
AUTORA | ARIADNA GONZÁLEZ NAVARRO
COORDINADOR | IVÁN NADAL LATORRE
CENTRO | IES D’ARGENTONA
CIUDAD | ARGENTONA- BARCELONA
RESUMEN |
El constante aumento de la demanda de energía eléctrica a escala mundial, junto con la problemática de los sistemas actuales para generarla (combustibles fósiles, energía nuclear) ha empujado a la sociedad a buscar nuevas formas de obtenerlas, buscando la manera respetar el medio ambiente. Las energías hidráulica, eólica o fotovoltaica, entre otras renovables, están en continua expansión y desarrollo, pero empieza a surgir una nueva forma de obtenerla, relacionada con la fuerza de las olas. Actualmente existen algunos dispositivos tipo boya que permiten obtener una cierta cantidad de energía, pero que presentan un solo apoyo que monitoriza el movimiento vertical de las olas. Este único apoyo considero que reduce su eficiencia. Es por ello que se ha diseñado un sistema con tres puntos de anclaje equidistantes en un ángulo de 120º que, de manera independiente, pueden generar electricidad, gracias al movimiento vertical de cada uno de ellos. En condiciones controladas, se ha podido obtener un total de 18 V de potencial que ha permitido encender una pequeña pantalla LED, gracias a la conversión de la energía eléctrica de tipo alterna originada en los tres motores, en una de tipo continuo gracias a un sistema de puentes de diodos. El siguiente paso es probarlo en un simulador de olas y observar su viabilidad. Para ello, ya se ha contactado con la UPC-Tech de Barcelona. Aunque és un primer prototipo; por tanto, mejorable, es una primera modificación de los sistemas ya existentes.
Palabras clave: energía undimotriz, olas, medio ambiente, tecnología, innovación.
TECNOLOGÍAS E INGENIERÍAS 322
ABSTRACT |
The constant increase in the demand for electricity on a global scale, together with the problems of current systems to generate it (fossil fuels, nuclear energy) has pushed society to look for new ways to obtain them, seeking ways to respect the environment. The hydraulic, wind or photovoltaic energies, among other renewable energies, are in continuous expansion and development, but a new way to obtain it begins to emerge, related to the strength of the waves. Currently there are some buoy-type devices that allow a certain amount of energy to be obtained, but with only one support that monitors the vertical movement of the waves. This only support I think reduces its efficiency. That is why a system has been designed with three anchoring points equidistant at an angle of 120º that, independently, can generate electricity, thanks to the vertical movement of each of them. Under controlled conditions, it has been possible to obtain a total of 18 V of potential that has allowed to light a small LED screen, thanks to the conversion of the alternating electric power originated in the three engines, in a continuous type thanks to a system of diode bridges. The next step is to test it in a wave simulator and observe its viability. For this, it has already contacted the UPC-Tech of Barcelona. Although it is a first prototype; therefore, improvable, it is a first modification of existing systems.
Keywords: wave energy, waves, environment, technology, innovation.
323
31º CERTAMEN JÓVENES INVESTIGADORES / Tecnologías e Ingenierías
INTRODUCCIÓN
¿Hasta qué punto las energías tradicionales tienen un límite de existencia? ¿Se aprovechan al máximo las energías renovables? ¿Realmente se conoce la energía producida por las olas? Y los sistemas existentes actualmente, ¿son eficientes? Estas son alguna de las preguntas que me han permitido realizar el presente trabajo.
Si comenzamos por la tercera pregunta y la quisiéramos responder, nos encontraríamos con la sorpresa de que no existe aún en el diccionario de la Real Academia de la Lengua española ningún término que defina la “energía producida por las olas”, siendo el término más próximo, aunque no igual, el de energía maremotriz, definida como “energía obtenida a partir del movimiento de las mareas”. El término que queremos indagar se conoce como “undimotriz”, palabra compuesta que significa motor por olas (de “undo”, ola, y “motriz, motor). En consecuencia, nos encontramos con un término utilizado aún en áreas muy concretas y poco familiar para el público en general (fig. 1).
Como toda energía indicada como renovable, y definida por la RAE como “energía cuyas fuentes se presentan en la naturaleza de modo continuo y prácticamente inagotable”, cada vez está teniendo más auge para sustituir las llamadas energías no renovables (combustibles fósiles, energía nuclear, entre otras). Ello es debido a un aumento progresivo de la demanda de la energía eléctrica a escala mundial, el aumento en la dificultad de los sistemas actuales en generarlas y las problemática ambientales asociadas. Es por ello que, cada vez, se están buscando alternativas para respetar el medio ambiente (Diaz, 2011).
Las energías hidráulica, eólica, térmica, fotovoltaica, están en continua expansión y desarrollo, pero empieza a surgir una nueva forma de obtenerlas y es aprovechando la fuerza de las olas y las mareas. Denominadas energía undimotriz u olamotriz, tienen un gran potencial energético y se estima que sólo Europa sería capaz de generar entre 120 a 190 TWh/año (2011); comparándola
Física del movimiento de las olas. Fuente: http://www.mecanica.frba .utn.edu.ar/energiaundimotriz/


Alguno de los sistemas existentes. Fuente: https://energias-renovables-ylimpias.blogspot.com/2012/08/ definicion-de-energia-undimotriz-y-sistemas-de-captacion.html
Sistema de boyas en el mar del Norte (Suecia).Fuente: https://twenergy. com/a/energia-undimotriz-comercial-suecia-aprovecha-la-energia-de-olas-2697
 Figura 01
Figura 02
Figura 03
Figura 01
Figura 02
Figura 03
Sea energy project: la revolución de las olas
con una central nuclear media, ésta es capaz de generar de 8 a 10 GWh / año suficiente para 2 millones de hogares (2017).
Finalmente, actualmente existen algunos dispositivos tipo boya que permiten obtener una cierta cantidad de energía, pero que presentan un solo soporte (Ría de Bilbao, España; Sotenäs, Suecia, fig. 2; o Fortaleza, Brasil) que monitoriza el movimiento vertical de las olas. Todos ellos se caracterizan por presentar un solo apoyo en la boya, aunque existen otros sistemas, no analizados en este trabajo, con diseño diferente (fig. 3).
Con todos estos datos, la motivación para realizar el presente trabajo es clara y doble. Por una parte, dar a conocer este término en mi entorno, tanto educativo como social (y, por qué no, investigador), e intentar mejorar los sistemas existentes, centrándome en el caso de las boyas de un solo punto de apoyo. El diseño y creación de una propuesta es la base que se presenta en este estudio. Además, existe un componente personal y académico detrás de esta doble motivación. El tutor del trabajo siempre nos dice que en una investigación ha de haber una aportación propia y, junto con el hecho de que en mi familia el interés por la tecnología y las ingenierías siempre ha sido alto, me ha llevado a buscar temas que cumplieran con este conjunto de propósitos y que, además, fuera interdisciplinario, como es este caso: tecnología y medio ambiente.
Los dispositivos para el aprovechamiento de la energía de las olas deben hacer frente a diversas dificultades para su desarrollo: entorno corrosivo, trabajo en condiciones meteorológicas extremas y variabilidad en la potencia y baja frecuencia de las olas. Para tratar de dar respuesta a estas dificultades, se han propuesto un gran número de dispositivos para el aprovechamiento de este tipo de energía, en claro contraste con cualquier otro tipo de aprovechamiento de energía renovable. Según datos del 2011, sólo unos pocos han alcanzado la etapa de ensayo a escala real en el mar y sólo uno de los desarrollos (Pelamis de Pelamis Wave Power) puede considerarse cercano a la fase de explotación comercial.
OBJETIVOS
El objetivo es el diseño y construcción de un sistema de boya que mejore el rendimiento para la obtención de energía a partir del movimiento de las olas (energía undimotriz) a partir de un aumento de puntos de fijación que tengan un recorrido vertical, siguiendo este movimiento.
En este sentido, el sistema de boya que existe actualmente, fijada en un punto tiene una menor eficiencia que el propuesto dado que sólo monitoriza un punto de cara a la obtención de energía por movimiento vertical de las partículas de agua que pasan por este punto. Es posible obtener más energía si monitorizamos una mayor cantidad de puntos que presenten este movimiento vertical.
325
CERTAMEN JÓVENES INVESTIGADORES / Tecnologías e Ingenierías
MATERIALES Y METODOLOGÍA SEGUIDA
Con el fin de obtener una mínima precisión en el montaje del prototipo, para su construcción se han recurrido a diferentes programas (fig. 4) de C.A.D., solidworks y sketchup para el diseño de piezas, así como a máquinas controladas por ordenador (figs. 5 y 6), fresador C.N.C., corte de hilo caliente C.N.C, cortadora láser, impresora 3D, y otras manuales como el torno, columna de taladrar y varias herramientas, llaves allen, hexagonales, tornavises, entre otras.


Una vez realizada la búsqueda bibliográfica correspondiente, se hizo un diseño del prototipo y se comenzó su fabricación. Se han diseñado diversos tipos de boya hasta encontrar un sistema que considero potencialmente viable, basándose en el existente de la central undimotriz de Porto do Pacem (Brasil). De todo el sistema planteado, el elemento principal es ésta, ya que se debe tener en cuenta que ésta ha de generar la suficiente fuerza para mover y soportar el peso de todo el conjunto que genera energía. Una vez definida (fig. 7), se pasó a la construcción del sistema mecánico basado en tres ejes equidistantes en sectores de 120º, fijados entre dos piezas circulares que formarían el esqueleto del prototipo, con una estructura tipo Delta, igual a la que se utiliza en los sistemas de impresora 3D (fig. 8).
Con el fin de cumplir el propòsito, se ha optado por un sistema piñón-cremallera por su facilidad de ejecución (fig. 9). Las bielas que forman parte de la estructura soportan toda la fuerza del movimiento de la boya. Para aumentar su eficiencia, se ha añadido un sistema de rótula para que tenga un poco de movilidad en lugar de varillas fijas como se había pensado para los dos primeros sistemas. El conjunto se acompaña con tres motores de paso situados en cada uno de los ejes y que permiten el movimiento vertical del sistema de piñón-cremallera.

31º
326
Figura 04
Pantalla principal de SolidWorks.
Figura 05 Torno.
Figura 06 Fresadora CNC.
Sea energy project: la revolución de las olas
Una vez diseñada ésta, se comenzó con la parte electrónica (fig. 10), conectada al sistema mecánico. Consta de tres elementos: una base superior del sistema de alucobond (mezcla de aluminio y metacrilato) que aprovecha la sujeción superior de los ejes verticales. En ella se sitúan, entre otros, los motores generadores de energía y el sistema de transmisión formado por los piñones que mueven las cremalleras. En segundo lugar, un sistema de simulación de olas (fig. 11) que contiene, entre otros, la placa Arduino Mega, los drivers de alimentación de los motores de paso. Finalmente, un sistema de aprovechamiento de la energía (fig. 12) donde se sitúan todos los componentes electrónicos que permiten el aprovechamiento de la energía, entre los cuales podemos destacar la placa prototipo donde están soldados los componentes y el conversor dc-dc.





 Figura 07
Tercer modelo de boya.
Figura 10
Trabajando en las piezas de la parte electrónica.
Figura 08
Modelo compacto de boya incorporada en el cuerpo del prototipo
Figura 11
Circuito electrónico para simular el funcionamiento mecánico de las olas.
Figura 09
Sistema piñón-cremallera utilizado para el movimiento vertical del simulador.
Figura 12
Figura 07
Tercer modelo de boya.
Figura 10
Trabajando en las piezas de la parte electrónica.
Figura 08
Modelo compacto de boya incorporada en el cuerpo del prototipo
Figura 11
Circuito electrónico para simular el funcionamiento mecánico de las olas.
Figura 09
Sistema piñón-cremallera utilizado para el movimiento vertical del simulador.
Figura 12
Placa electrónica para el aprovechamiento de la energía.
CERTAMEN JÓVENES INVESTIGADORES / Tecnologías e Ingenierías
RESULTADOS
Los resultados que se explicaran a continuación se centrarán en dos grandes puntos: la explicación del prototipo final y su funcionamiento, tanto desde el punto de vista mecánico como electrónico. Consta de tres partes:
La boya y estructura delta, con una parte mecánica y una electrónica (fig. 13): el prototipo presenta una serie de tres puntos de fijación sobre una boya de 50 cm, y que a la realidad, debería tener entre 5 y 10 m de diámetro, para conseguir la fuerza necesaria para poder mover todo el sistema de generación de energía. Esta centrada en el conjunto y sujetada por tres puntos (estructura tipo delta) mediante unas varillas en cuyos extremos hay unas cabezas articuladas. Éstas están unidas a los patines que se deslizan por la estructura de aluminio. En éstos, a su vez, se sujetan las cremalleras que atacan los piñones en cuyo eje se halla la polea que mueve cada motor de paso utilizado para genera energía, cuya relación es de 1:10.
Simulador de olas (“caja verde”; fig. 14): con toda la parte electrónica que simulará el efecto sinusoidal de una ola. En este sentido, crea un movimiento de la boya en los distintos ejes, hacia arriba y abajo. Esto también hará que todo el sistema de generación de energía entre en funcionamiento. Éste es sencillo: sólo controlamos sentido de giro (derecha o izquierda) y cuánto queremos desplazar cada eje. Mediante un temporizador hacemos que cada uno arranque con un desfase de un segundo, consiguiendo un efecto de vaivén. El programa usa la libreria AccelStepper, muy fácil de usar, solo hemos de introducir velocidad, aceleración y desplazamiento, la librería genera todos los cálculos necesarios, la parte repetitiva del programa se encarga de invertir el sentido giro de los motores una vez alcanzan el desplazamiento introducido así como de la secuencia de puesta en marcha de los motores con un desfase de un segundo mediante temporizador para simular el efecto de la ola..
Sistema generación de energía (“caja roja”; fig. 15): el sistema se reparte en tres zonas del prototipo: en los ejes (motores de paso), en la base superior (motores generadores de energía) y en el sistema convertidor de energía (“caja roja”). Los motores generadores de energía producen una tensión de tipo alterna. Cada uno cuenta con cuatro bobinas, se conectan en serie dos a dos según especificaciones fabricante para conseguir el mayor voltaje posible. El par de bobinas se conecta a un circuito rectificador formado por dos puentes de diodos modelo DC W02M. Su salida se filtra mediante condensadores electrolíticos 35 V y 2200 microfaradios, convirtiendo esta tensión a continua, este circuito se repite por cada generador, todos los componentes electrónicos se soldan a una placa de prototipos.
Éstos, a su salida, están conectados en serie, consiguiendose unos 15 V - 18 V continuos que convertimos a 5 V mediante conversor dc-dc, permitiendo alimentar un display de leds.
31º
328
CONCLUSIONES
En primer lugar, se ha podido realizar un primer prototipo viable siguiendo el modelo de sistema de boya y estructura tipo delta. Si se compara con alguno parecido, el presentado es más compacto y, posiblemente, soportaría las duras condiciones del mar, ya que el propio sistema delta (en tres ejes) facilitaría esta resistencia, más que el sistema de un solo punto de apoyo. Actualmente, el sistema presentado ha intentado analizar algunos modelos ya existentes y minimizar algunos impactos que éstos podrían ocasionar, pero se ha centrado en la idea que podría ser más efectivo energéticamente por el sistema de tres puntos de monitoreo que presenta la boya.


Dado que este es un primer paso, el objetivo que vendría a continuación sería contactar con algún centro de investigación que trabaje esta energía para evaluar el producto conseguido hasta ahora, y cómo se podría continuar. Dos posibles lugares de contacto son, el Instituto de Ciencias del Mar (ICM), centro del CSIC, y la Escuela Técnica de Ingenieros de Caminos, Canales y Puertos de la Universidad Politécnica de Cataluña, dos de los espacios donde hay piscinas que producen olas y que podría ser un punto de ensayo para el sistema.

329
Sea energy project: la revolución de las olas
Figuras 13, 14 y 15
Visión general del prototipo finalizado, con la boya y la estructura delta (izquierda), el simulador de olas y el generador de energía (centro), y el display funcionando (derecha).
CERTAMEN JÓVENES INVESTIGADORES / Tecnologías e Ingenierías
BIBLIOGRAFÍA
NOTA: La bibliografia que se indica en el presente apartado es una parte de la totalidad utilizada en el trabajo completo.
AccelStepper library for Arduino (n.d.). Consultada el 5 de enero de 2019, http://www.airspayce.com/ mikem/arduino/AccelStepper/index.html
Ametek (2012). Size 23 Stepper Motor Data. Catálogo. Consultada el 16 diciembre de 2018, https://www.elmeq.es/ftp/productsFiles/1402/MOTOR-PAP-HY2226-ES.pdf
Arrieta, J.(2016). Euskadi se enchufa al Cantábrico. El Correo. Consultada el 2 de setiembre de 2018, https://www.elcorreo.com/alava/economia/201608/04/ primer-captador-flotante-energia-20160804122631.html
Castaño, M. (2015). Sistema de monitorización y supervisión de una boya para generación de energía undimotriz. UPCommons. Consultada el 21 de octubre de 2018, https://upcommons.upc.edu/handle/2099.1 /12799
Darvil, A. (2018). Energy Resources:Wave Power. Consultada el 24 de noviembre de 2018, http://www.darvill.clara.net/altenerg/wave.htm
Díaz, C. (2011). Haciaunaéticadelabiosferaparacrisisambiental(tesis). UCM. Consultada el 2 de setiembre de 2018, https://eprints.ucm.es/12646/1/T3 2767.pdf
EcoPortal.net (2014). Central undimotriz en Brasil. Consultada el 23 de setiembre de 2018, https://www.ecoportal.net/paises/brasil/central-undimotriz-en-brasil/
EcoWavePower (2018). Wave Energy. Consultada el 2 de setiembre de 2018, https://www.ecowavepower.com/
Energía Limpia XXI (2015). Brasil y Argentina aprovechan energía de las olas del mar. Consultada 23 de setiembre de 2018, https://energialimpiaparatodos.com/2015/01/13/brasil-aprovecha-energia-de-las-olas -del-mar
ER (2017). Energías del mar. La boya undimotriz diseñada por Oceantec sobrevive un año de pruebas en el Cantábrico. Consultada el 2 de setiembre de 2018, https://www.energias-renovables.com/energias_del_ mar/el-prototipo-undimotriz-disenado-por-oceantec-sobrevive-20171226
Etymol.com (2017). Brochure Undimotriz. Consultada el 2 de setiembre de 2018, http://www.etymol.com /downloads/brochure%20 _undimotriz _etymol.pdf
Fernández, S. (2017). Analizamos los datos de la Central de Motriku. DiarioRenoblables. Consultada el 2 diciembre de 2018, https://www.diariorenovables. com/2017/12/central-undimotriz-de-mutriku-analisis-datos-produccion-problemas.html
Foro nuclear (2017). Uranio, energía y piscinas de combustible. Consultada el 2 de setiembre de 2018, https://www.foronuclear.org/es/consultas-al- experto/122837-uranio-energia-y-piscinas-de-combustible
Fundéu BBVA (2011). Undimotriz. Consultada el 26 de agosto de 2018: https://www.fundeu.es/consulta /undemotriz-4342/
31º
330
Sea energy project: la revolución de las olas
Gómez, D. (2010). Análisis de los generadores de accionamiento directo en tecnología undimotriz. Universidad de Sevilla. Consultada el 7 de diciembre de 2018, http://bibing.us.es/proyectos/abreproy/4994/fichero/5. An%C3%A1lisis+de+los+Generadores+de+Accionamiento+Directo.pdf
Greenteach (2019). Energía undimotriz comercial. Consultada el 2 de setiembre de 2018, https://www.greenteach.es/energia-undimotriz-comercial -suecia/ Grupo de trabajo I+D+I (2019). Tipos de onda. Universidad Tecnológica Nacional, Facultad Regional Buenos Aires. Consultada el 26 de agosto de 2018, http://www.mecanica.frba.utn.edu.ar/energiaundimotriz/? page_id=270
Ibañez, P. (2008). Energías de la olas: Situación y Futuro. Universidad da Coruña, Consultada el 16 diciembre de 2018, https://www.udc.es/iuem/documentos/ doc_xornadas/anaeco/APROVEITAMENTODAENERXIADASOLAS.pdf
McCormick, M.E. (2007). Ocean Wave Energy Conversion. Chapter 2. Ocean waves. Pp. 7-25. Dover Publications, USA. ISBN-13: 9780486462455
Mutriku Turismoa (2018). Planta undimotriz de Mutriku. Consultada el 23 de setiembre de 2018, https://www.mutriku.eus/es/turismo/mutriku/planta-olas
Navarro, A. (2019). Youtube. Sea Energy Project. Resumen del proyecto: https://youtu.be/B6j21nwGuys
Navarro, R (2011). Producción de energía a partir de las olas del mar. Madrid+. Consultada el 2 de setiembre y el 21 de octubre de 2018, y el 17 de febrero de 2019, http://www.madrimasd.org/informacion Idi/analisis/analisis/ analisis.asp?id=50609
Paschoa, C. (2013). Marine Technology. Wave energy research in Brazil Taking Off. Consultada el 21 de octubre de 2018,
https://www.marinetechnologynews.com/blogs/wave-energy-research-in-brazil-taking -off-700004
Píriz, H. (2017). Cálculoydiseñodeunacentralundimotriz(TFG). Universidad Carlos III. Consultada el 2 de setiembre de 2018,
https://orff.uc3m.es/bitstream/handle/10016/27621/TFG_Gonzalo_Piriz_Hurtado.pdf?sequence=1&isAllowed=y
RAE (n.d.). Energía. Consultada el 26 de agosto de 2018, https://dle.rae.es/?id=FGD8otZ
RAE (n.d.). Energía maremotriz. Consultada el 26 de agosto de 2018, https://dle.rae.es/?id=FGD8otZ
RAE (n.d.). Energía renovable. Consultada el 26 de agosto de 2018, https://dle.rae.es/?id=FGD8otZ
Sitiosolar.com (2013). La nueva central de captación de energía de las olas en Portugal y otros sistemas de obtención de energía en el mar. Consultada el 2 de setiembre de 2018, http://www.sitiosolar.com/la-nueva- central-de-captacion-de-energiade-las-olas-en-portugal-y-otros-sistemas-de-obtencion-de-energia-en-el-mar/
331
31º CERTAMEN JÓVENES INVESTIGADORES / Tecnologías e Ingenierías
Size 23 Stepper Motor Data (n.d.). Consultada el 4 de enero de 2019, https://www.elmeq.es/ftp/products Files/1402/MOTOR-PAP-HY2226-ES.pdf
Universidad de Alicante (n.d.). Mecánica de fluídos. Consultada el 7 de diciembre de 2018, https://rua.ua.es/dspace/bitstream/10045/20299/4/tema2_impulsion.pdf
Universidad Politécnica de Valencia (2002). Control de motores paso a paso mediante microcontroladores (Stepper motor). Consultada el 23 de diciembre de 2018, http://server-die.alc.upv.es/asignaturas/lsed/2002-03/motorespasoapaso/motorespasoapaso.pdf
Universidad Veritas (n.d.). Impresora 3D Delta. Consultada el 7 de diciembre de 2018, http://dp4.yolasite.com/
US EIA (2018). Energy Explained. Wave Power. Consultada el 26 de agosto de 2018, https://www.eia.gov/energyexplained/index.php?page =hydropower_wave
Vera, R. (2014). Youtube. Energía con las olas del mar. Consultada el 21 de octubre de 2018, https://www.youtube.com/watch?v=v2xA_sRedKI
Wedge Global (2014). Energía de las olas. Consultada el 26 de agosto de 2018, https://www.wedgeglobal.com/es/noticias/item /16-energia-de-las-olas
Wikipedia (2018). Energía undimotriz. Consultada el 26 de agosto de 2018, https://es.wikipedia.org/wiki/Energ%C3%ADa_undimotriz
Yayí, Ch. (2017). Energía Undimotriz Comercial. Twenergy. Consultada el 2 de setiembre de 2018, https://twenergy.com/a/energia-undimotriz-comercial-suecia-aprovecha-la-energia-de-sus-olas-2697
332
Factorización cuántica del número 15
/ PRIMER PREMIO
AUTOR | JAVIER PAGÁN LACAMBRA
COORDINADORA | EVA LÓPEZ PÉREZ
CENTRO | IES SAN MATEO
CIUDAD | MADRID
RESUMEN |
Se ha diseñado un sencillo sistema óptico para factorizar el número 15 utilizando el Algoritmo de Shor. Para ello se ha utilizado un lenguaje binario basado en el estado de polarización de la luz, se ha diseñado un circuito cuántico que combina puertas de Hadamard y CNOT; y se ha estudiado cómo implementar estas operaciones utilizando divisores de haz polarizados y láminas de onda.
ABSTRACT |
We have designed a simple optical scheme to factorize number 15 using Shor’s Algorithm. To do this, we have used a binary language based on the polarization of light, we have designed a quantum circuit that combined Hadamard and CNOT gates; and we have studied how to implement these operations using polarizing beam splitters and wave plates.
TECNOLOGÍAS E INGENIERÍAS 335
31º CERTAMEN JÓVENES INVESTIGADORES / Tecnologías e Ingenierías
1.INTRODUCCIÓN
Para hacer computación es necesario un lenguaje lógico, que consta de una unidad de información y una serie de operaciones que nos permiten trabajar con ella. De esta manera podemos crear algoritmos, que son una serie de pasos mecánicos para resolver un problema. Sin embargo, si queremos construir un ordenador, es decir, un sistema físico capaz de ejecutar un algoritmo, necesitamos portadores de información: objetos físicos que representan la información. Por ejemplo, en el caso de un ordenador electrónico la unidad de información es el bit (0 o 1), y se codifica en la carga eléctrica que se almacena en un condensador. De esta manera, si el condensador excede un mínimo de carga representa un 1 y si no, un 0.
2. Estado de polarización de un fotón
2. Estado de polarización de un fotón
Los ordenadores cuánticos se diferencian de los clásicos en que trabajan con qubits: unidades de información que no sólo pueden valer 0 o 1, sino cualquier combinación de ambos. Además, los portadores de información experimentan fenómenos cuánticos, que pueden utilizarse para aumentar exponencialmente la velocidad de los algoritmos. Nosotros nos centraremos en el problema de la factorización de enteros, y utilizaremos fotones como portadores de información.
La luz es una onda electromagnética compuesta por un campo eléctrico y un campo magnético que vibran de forma perpendicular entre sí y a la dirección de propagación. Estas ondas se transmiten en múltiplos de una energía mínima, y a la onda que lleva esta cantidad mínima se le llama fotón. Este tipo de objetos, que se transmiten en paquetes de onda, se denominan objetos cuánticos.
La luz es una onda electromagnética compuesta por un campo eléctrico y un campo magnético que vibran de forma perpendicular entre sí y a la dirección de propagación. Estas ondas se transmiten en múltiplos de una energía mínima, y a la onda que lleva esta cantidad mínima se le llama fotón. Este tipo de objetos, que se transmiten en paquetes de onda, se denominan objetos cuánticos.
2. ESTADO DE POLARIZACIÓN DE UN FOTÓN
La luz es una onda electromagnética compuesta por un campo eléctrico y un campo magnético que vibran de forma perpendicular entre sí y a la dirección de propagación. Estas ondas se transmiten en múltiplos de una energía mínima, y a la onda que lleva esta cantidad mínima se le llama fotón. Este tipo de objetos, que se transmiten en paquetes de onda, se denominan objetos cuánticos.
La polarización de una onda hace referencia a la dirección en la que vibra. En los fotones, el campo eléctrico puede vibrar verticalmente (polarización vertical) u horizontalmente (polarización horizontal), pero también puede girar sobre el eje de propagación. Esto significa que si representamos el campo eléctrico como una onda plana
La polarización de una onda hace referencia a la dirección en la que vibra. En los fotones, el campo eléctrico puede vibrar verticalmente (polarización vertical) u horizontalmente (polarización horizontal), pero también puede girar sobre el eje de propagación. Esto significa que si representamos el campo eléctrico como una onda plana
(1)
(1)
donde es el vector de onda, ω es la frecuencia angular y representa el vector de polarización; podemos escribir
donde k es el vector de onda, es la frecuencia angular y E0 representa el vector de polarización; podemos escribir
La polarización de una onda hace referencia a la dirección en la que vibra. En los fotones, el campo eléctrico puede vibrar verticalmente (polarización vertical) u horizontalmente (polarización horizontal), pero también puede girar sobre el eje de propagación. Esto significa que si representamos el campo eléctrico como una onda plana , (1) donde es el vector de onda, ω es la frecuencia angular y representa el vector de polarización; podemos escribir
(2)
(2)
(2)
donde es el ángulo entre y . El factor imaginario que acompaña a la componente representa el desfase entre las dos componentes, lo que da lugar a polarizaciones circulares y elípticas en las que el vector de polarización gira sobre . Si hacemos pasar el campo eléctrico descrito en (1) y en (2), de intensidad , por un polarizador horizontal (que solo deja pasar la componente ), obtendremos una onda polarizada horizontalmente y de intensidad . Ahora pensemos en qué sucede cuando hacemos pasar un
donde es el ángulo entre y . El factor imaginario que acompaña a la componente representa el desfase entre las dos componentes, lo que da lugar a polarizaciones circulares y elípticas en las que el vector de polarización gira sobre . Si hacemos pasar el campo eléctrico descrito en (1) y en (2), de intensidad , por un polarizador horizontal (que solo deja pasar la componente ), obtendremos una onda polarizada horizontalmente y de intensidad . Ahora pensemos en qué sucede cuando hacemos pasar un
donde Ө es el ángulo entre E0 y e1 . El factor imaginario que acompaña a la componente e2 representa el desfase entre las dos componentes, lo que da lugar a polarizaciones circulares y elípticas en las que el vector de polarización gira sobre e3=e1 x e2 . Si hacemos pasar el campo eléctrico descrito en (1) y en (2), de intensidad I0, por un polarizador horizontal (que solo deja pasar la compo-
336
,
,
,
único fotón por el polarizador. El fotón no puede dividirse, sino que tiene una
Factorización cuántica del número 15
nente e1), obtendremos una onda polarizada horizontalmente y de intensidad I0cos2 Ө. Ahora pensemos en qué sucede cuando hacemos pasar un único fotón por el polarizador. El fotón no puede dividirse, sino que tiene una probabilidad cos2 Ө de atravesar el polarizador y una probabilidad sin2 Ө de ser absorbido. Escribimos el estado cuántico de polarización de un fotón como
donde es el ángulo entre y . El factor imaginario que acompaña a la componente representa el desfase entre las dos componentes, lo que da lugar a polarizaciones circulares y elípticas en las que el vector de polarización gira sobre . Si hacemos pasar el campo eléctrico descrito en (1) y en (2), de intensidad , por un polarizador horizontal (que solo deja pasar la componente ), obtendremos una onda polarizada horizontalmente y de intensidad . Ahora pensemos en qué sucede cuando hacemos pasar un único fotón por el polarizador. El fotón no puede dividirse, sino que tiene una probabilidad de atravesar el polarizador y una probabilidad de ser absorbido. Escribimos el estado cuántico de polarización de un fotón como (3)
Donde H y V representan polarización horizontal y vertical. En mecánica cuántica, estos estados se entienden como vectores en un espacio de Hilbert sobre el cuerpo de los números complejos. Los vectores de la base representan los distintos posibles resultados de un experimento y el módulo al cuadrado de cada componente da la probabilidad de medir su respectivo resultado. Por esto decimos que un fotón es un qubit, porque no sólo puede tomar el valor H=0 o V=1, sino cualquier combinación de ambos. No obstante, una vez el fotón atraviesa el polarizador, su estado de polarización cambia y pasa a ser horizontal, decimos que ha colapsado.
Donde y representan polarización horizontal y vertical. En mecánica cuántica, estos estados se entienden como vectores en un espacio de Hilbert sobre el cuerpo de los números complejos. Los vectores de la base representan los distintos posibles resultados de un experimento y el módulo al cuadrado de cada componente da la probabilidad de medir su respectivo resultado. Por esto decimos que un fotón es un qubit, porque no sólo puede tomar el valor H=0 o V=1, sino cualquier combinación de ambos. No obstante, una vez el fotón atraviesa el polarizador, su estado de polarización cambia y pasa a ser horizontal, decimos que ha colapsado.
esos fotones. Los posibles resultados que podemos obtener son , donde el primer ket representa la polarización medida en A, y el segundo, la polarización medida en B. Hemos encontrado un nuevo espacio vectorial que describe el sistema cuántico compuesto por A y B. Debido a la estructura de este espacio vectorial, podemos encontrar estados con propiedades especiales, en los que una sola medición puede provocar el colapso de dos sistemas distintos. En este caso se dice que A y B están entrelazados, ya que un estado guarda información sobre el otro.
Consideremos ahora un sistema compuesto por dos fotones: A y B. Cada uno de los fotones constituye por sí mismo un sistema cuántico con su propio espacio de Hilbert: y . Imaginemos que medimos la polarización de
3. Transformaciones de la información: puertas cuánticas
Consideremos ahora un sistema compuesto por dos fotones: A y B. Cada uno de los fotones constituye por sí mismo un sistema cuántico con su propio espacio de Hilbert: HA y HB . Imaginemos que medimos la polarización de esos fotones. Los posibles resultados que podemos obtener son {|H>|H>,|H>|V>,|V>|H>, |V>|H>} , donde el primer ket representa la polarización medida en A, y el segundo, la polarización medida en B. Hemos encontrado un nuevo espacio vectorial HAB que describe el sistema cuántico compuesto por A y B. Debido a la estructura de este espacio vectorial, podemos encontrar estados con propiedades especiales, en los que una sola medición puede provocar el colapso de dos sistemas distintos. En este caso se dice que A y B están entrelazados, ya que un estado guarda información sobre el otro.
3.
TRANSFORMACIONES DE LA INFORMACIÓN: PUERTAS CUÁNTICAS
Ya hemos visto que los fotones son buenos candidatos para ser portadores de información cuántica (qubits). Diremos que un estado de polarización horizontal equivale a 0 y un estado de polarización vertical equivale a 1. Ahora tenemos que entender las operaciones que podemos realizar sobre esta información. Estas operaciones son las puertas cuánticas, y pueden actuar sobre un qubit o sobre varios. Utilizaremos las siguientes.
3.1. Puertas sobre un qubit
Ya hemos visto que los fotones son buenos candidatos para ser portadores de información cuántica (qubits). Diremos que un estado de polarización horizontal equivale a 0 y un estado de polarización vertical equivale a 1. Ahora tenemos que entender las operaciones que podemos realizar sobre esta información. Estas operaciones son las puertas cuánticas, y pueden actuar sobre un qubit o sobre varios. Utilizaremos las siguientes.
• Puerta de Hadamard (H): Se trata de una de las transformaciones más importantes en computación cuántica. Se le asocia la siguiente matriz en la base :
3.1. PUERTAS SOBRE UN QUBIT
• Puerta de Hadamard (H): Se trata de una de las transformaciones más importantes en computación cuántica. Se le asocia la siguiente matriz en la base {|0>,|1>}:
• Corrimiento de fase ( ): Multiplica la componente por un factor de módulo uno: .


(3)
337
(4)
31º CERTAMEN JÓVENES INVESTIGADORES / Tecnologías e Ingenierías
• Corrimiento de fase ( ): Multiplica la componente por un factor de módulo uno: .
• Puerta de Hadamard (H): Se trata de una de las transformaciones más importantes en computación cuántica. Se le asocia la siguiente matriz en la base : (4)
3.2. Puertas sobre varios qubits
• Corrimiento de fase ( Z n ): Multiplica la componente |1> por un factor de módulo uno:

• Corrimiento de fase ( ): Multiplica la componente por un factor de módulo uno: .





• Negación condicionada (CNOT): Niega un qubit cuando otro qubit de control vale 1. Más adelante representaremos esta puerta como un círculo sobre un qubit, unido por una línea vertical al qubit de control.
3.2. Puertas sobre varios qubits
3.2. PUERTAS SOBRE VARIOS QUBITS
• Puerta Swap: Intercambia dos qubits. Se representa con dos aspas, una en cada qubit, unidas por una línea vertical.
• Negación condicionada (CNOT): Niega un qubit cuando otro qubit de control vale 1. Más adelante representaremos esta puerta como un círculo sobre un qubit, unido por una línea vertical al qubit de control.
• Puerta Swap: Intercambia dos qubits. Se representa con dos aspas, una en cada qubit, unidas por una línea vertical.
• Negación condicionada (CNOT): Niega un qubit cuando otro qubit de control vale 1. Más adelante representaremos esta puerta como un círculo sobre un qubit, unido por una línea vertical al qubit de control.
• Transformada cuántica de Fourier (QFT): Es la transformada de Fourier discreta aplicada a un estado cuántico. Se escribe como , (5)
• Transformada cuántica de Fourier (QFT): Es la transformada de Fourier discreta aplicada a un estado cuántico. Se escribe como
• Puerta Swap: Intercambia dos qubits. Se representa con dos aspas, una en cada qubit, unidas por una línea vertical.
donde es la primera raíz 2n -ésima de la unidad. Como se demues-
• Transformada cuántica de Fourier (QFT): Es la transformada de Fourier discreta aplicada a un estado cuántico. Se escribe como ,


donde es la primera raíz -ésima de la unidad. Como se demuestra en (De Lacalle, 2004), podemos construir la QFT combinando puertas de Hadamard y corrimientos de fase condicionadas como se muestra en la Figura 1.
donde es la primera raíz -ésima de la unidad. Como se demuestra en (De Lacalle, 2004), podemos construir la QFT combinando puertas de Hadamard y corrimientos de fase
tra en (De Lacalle, 2004), podemos construir la QFT combinando puertas de Hadamard y corrimientos de fase condicionadas como se muestra en la Figura 1.
condicionadas como se muestra en la Figura 1.
El símbolo <k| representa el conjugado complejo del estado |k> , uno de los vec tores de la base del sistema con el que estamos trabajando. Normalmente trabajamos en una base ortonormal, es decir, en la que el producto escalar <k| j> es igual a 1 si k=j y a 0 si k≠j
El símbolo representa el conjugado complejo del estado , uno de los vectores de la base del sistema con el que estamos trabajando. Normalmente trabajamos en una base ortonormal, es decir, en la que el producto escalar es igual a 1 si y a 0 si
4. PROBLEMA CLÁSICO DE LA FACTORIZACIÓN
El símbolo representa el conjugado complejo del estado , uno de los vectores de la base del sistema con el que estamos trabajando. Normalmente trabajamos en una base ortonormal, es decir, en la que el producto escalar es igual a 1 si y a 0 si .
El teorema fundamental de la aritmética nos dice que podemos expresar un
4.
4. Problema clásico de la factorización
El teorema fundamental de la aritmética nos dice que podemos expresar un entero de modo único como producto finito de números primos. Este proceso se llama factorización.
El teorema fundamental de la aritmética nos dice que podemos expresar un
338
(5)
(5)
Figura 1: Circuito cuántico para la QFT.
(4)
Figura 1: Circuito cuántico para la QFT.
Problema clásico de la factorización
Figura 01 Circuito cuántico para la QFT.
Por lo tanto, para poder crear este estado necesitaremos usar fotones, donde representa el entero más cercano a . Estos fotones formarán el primer registro. A continuación, preparamos mediante un ordenador
Por lo tanto, para poder crear este estado necesitaremos usar fotones, donde representa el entero más cercano a . Estos fotones formarán el primer registro. A continuación, preparamos mediante un ordenador
Por lo tanto, para poder crear este estado necesitaremos usar fotones, donde representa el entero más cercano a . Estos fotones formarán el primer registro. A continuación, preparamos mediante un ordenador
31º CERTAMEN JÓVENES INVESTIGADORES / Tecnologías e Ingenierías
clásico un segundo registro de fotones en el estado y los entrelazamos obteniendo
clásico un segundo registro de fotones en el estado y los entrelazamos obteniendo
clásico un segundo registro de fotones en el estado y los entrelazamos obteniendo
y los entrelazamos obteniendo (11)
Supongamos ahora que medimos en el segundo registro. Como la MEF es periódica, esta medición puede corresponder a cualquier número de la forma donde es entero. Estos pasan a ser, por lo tanto, los valores permitidos del primer registro. Ahora nos olvidamos del segundo registro y hacemos actuar otra QFT sobre el primer registro. Es fácil comprobar que el estado del sistema se puede escribir como (12)
Supongamos ahora que medimos en el segundo registro. Como la MEF es periódica, esta medición puede corresponder a cualquier número de la forma donde es entero. Estos pasan a ser, por lo tanto, los valores permitidos del primer registro. Ahora nos olvidamos del segundo registro y hacemos actuar otra QFT sobre el primer registro. Es fácil comprobar que el estado del sistema se puede escribir como
Supongamos ahora que medimos αxe en el segundo registro. Como la MEF es periódica, esta medición puede corresponder a cualquier número de la forma x =x0+yr donde y es entero. Estos pasan a ser, por lo tanto, los valores permitidos del primer registro. Ahora nos olvidamos del segundo registro y hacemos actuar otra QFT sobre el primer registro. Es fácil comprobar que el estado del sistema se puede escribir como
Supongamos ahora que medimos en el segundo registro. Como la MEF es periódica, esta medición puede corresponder a cualquier número de la forma donde es entero. Estos pasan a ser, por lo tanto, los valores permitidos del primer registro. Ahora nos olvidamos del segundo registro y hacemos actuar otra QFT sobre el primer registro. Es fácil comprobar que el estado del sistema se puede escribir como (12)
Los sumandos anteriores son nulos salvo aquellos con . Es decir, solo puede tomar valores ,
Los sumandos anteriores son nulos salvo aquellos con . Es decir, solo puede tomar valores
Los sumandos anteriores son nulos salvo aquellos con . Es decir, j solo puede tomar valores
Los sumandos anteriores son nulos salvo aquellos con . Es decir, solo puede tomar valores
donde es un número entero. Por lo tanto, cuando midamos el estado final obtendremos múltiplos de . Como conocemos , podemos despejar , que recordamos es entero. De esta manera, reducimos los posibles valores del periodo a múltiplos de .
(13)
donde es un número entero. Por lo tanto, cuando midamos el estado final
donde es un número entero. Por lo tanto, cuando midamos el estado final
, (13) donde es un número entero. Por lo tanto, cuando midamos el estado final obtendremos múltiplos de . Como conocemos , podemos despejar , que recordamos es entero. De esta manera, reducimos los posibles valores del periodo a múltiplos de
obtendremos múltiplos de . Como conocemos , podemos despejar , que recordamos es entero. De esta manera, reducimos los posibles valores del periodo a múltiplos de .
obtendremos múltiplos de . Como conocemos , podemos despejar , que recordamos es entero. De esta manera, reducimos los posibles valores del periodo a múltiplos de .
donde es un número entero. Por lo tanto, cuando midamos el estado final obtendremos múltiplos de . Como conocemos , podemos despejar , que recordamos es entero. De esta manera, reducimos los posibles valores del periodo a múltiplos de .
donde es un número entero. Por lo tanto, cuando midamos el estado final obtendremos múltiplos de . Como conocemos n, podemos despejar , que recordamos es entero. De esta manera, reducimos los posibles valores del periodo a múltiplos de .
donde es un número entero. Por lo tanto, cuando midamos el estado final obtendremos múltiplos de . Como conocemos , podemos despejar , que recordamos es entero. De esta manera, reducimos los posibles valores del periodo a múltiplos de
6. Factorización cuántica del número 15
6. Factorización cuántica del número 15
6. FACTORIZACIÓN CUÁNTICA DEL NÚMERO 15
6. Factorización cuántica del número 15
6. Factorización cuántica del número 15
6. Factorización cuántica del número 15
6. Factorización cuántica del número 15
Ahora aplicaremos todo lo que hemos explicado para factorizar el 15. Primero estudiaremos la combinación de puertas necesaria para ejecutar el algoritmo minimizando el número de operaciones y luego discutiremos como implementar dicho circuito utilizando dispositivos ópticos.
Ahora aplicaremos todo lo que hemos explicado para factorizar el 15. Primero estudiaremos la combinación de puertas necesaria para ejecutar el algoritmo minimizando el número de operaciones y luego discutiremos como implementar dicho circuito utilizando dispositivos ópticos.
Ahora aplicaremos todo lo que hemos explicado para factorizar el 15. Primero estudiaremos la combinación de puertas necesaria para ejecutar el algoritmo minimizando el número de operaciones y luego discutiremos como implementar dicho circuito utilizando dispositivos ópticos.
6.1. Modelo teórico
Ahora aplicaremos todo lo que hemos explicado para factorizar el 15. Primero estudiaremos la combinación de puertas necesaria para ejecutar el algoritmo minimizando el número de operaciones y luego discutiremos como implementar dicho circuito utilizando dispositivos ópticos.
Ahora aplicaremos todo lo que hemos explicado para factorizar el 15. Primero estudiaremos la combinación de puertas necesaria para ejecutar el algoritmo minimizando el número de operaciones y luego discutiremos como implementar dicho circuito utilizando dispositivos ópticos.
Ahora aplicaremos todo lo que hemos explicado para factorizar el 15. Primero estudiaremos la combinación de puertas necesaria para ejecutar el algoritmo minimizando el número de operaciones y luego discutiremos como implementar dicho circuito utilizando dispositivos ópticos.
6.1. Modelo teórico
6.1. MODELO TEÓRICO
Ahora aplicaremos todo lo que hemos explicado para factorizar el 15. Primero estudiaremos la combinación de puertas necesaria para ejecutar el algoritmo minimizando el número de operaciones y luego discutiremos como implementar dicho circuito utilizando dispositivos ópticos.
6.1. Modelo teórico
6.1. Modelo teórico
6.1. Modelo teórico
6.1. Modelo teórico
La MEF más sencilla se consigue eligiendo α=11 en la Ecuación (6), con periodo r=2 . Como discutimos en la sección anterior, necesitaremos dos registros de qubits: uno de 2[log2=15]=8 y otro de [log2=15]=4 . Sin embargo, observamos que si expandimos ax en términos de la forma binaria de x












La MEF más sencilla se consigue eligiendo en la Ecuación (6), con periodo . Como discutimos en la sección anterior, necesitaremos dos registros de qubits: uno de y otro de . Sin embargo, observamos que si expandimos en términos de la forma binaria de ( ), podemos escribir .
La MEF más sencilla se consigue eligiendo en la Ecuación (6), con periodo . Como discutimos en la sección anterior, necesitaremos dos registros de qubits: uno de y otro de . Sin embargo, observamos que si expandimos en términos de la forma binaria de ( ), podemos escribir . (14)
La MEF más sencilla se consigue eligiendo en la Ecuación (6), con periodo . Como discutimos en la sección anterior, necesitaremos dos registros de qubits: uno de y otro de . Sin embargo, observamos que si expandimos en términos de la forma binaria de ( ), podemos escribir
La MEF más sencilla se consigue eligiendo en la Ecuación (6), con periodo . Como discutimos en la sección anterior, necesitaremos dos registros de qubits: uno de y otro de . Sin embargo, observamos que si expandimos en términos de la forma binaria de ( ), podemos escribir
La MEF más sencilla se consigue eligiendo en la Ecuación (6), con periodo . Como discutimos en la sección anterior, necesitaremos dos registros de qubits: uno de y otro de . Sin embargo, observamos que si expandimos en términos de la forma binaria de ( ), podemos escribir
( ), podemos escribir
La MEF más sencilla se consigue eligiendo en la Ecuación (6), con periodo . Como discutimos en la sección anterior, necesitaremos dos registros de qubits: uno de y otro de . Sin embargo, observamos que si expandimos en términos de la forma binaria de ( ), podemos escribir .
Por lo que la MEF se convierte en una serie de multiplicaciones controladas.
Por lo que la MEF se convierte en una serie de multiplicaciones controladas. Como si elevamos a una potencia par obtenemos 1 mod15, y si lo hacemos a una potencia impar, 11 mod15; la multiplicación está controlada por (el
Por lo que la MEF se convierte en una serie de multiplicaciones controladas.
Por lo que la MEF se convierte en una serie de multiplicaciones controladas. Como si elevamos a una potencia par obtenemos 1 mod15, y si lo hacemos a una potencia impar, 11 mod15; la multiplicación está controlada por (el



se convierte en una serie de multiplicaciones controladas.
Por lo que la MEF se convierte en una serie de multiplicaciones controladas.
340
(12)
(13)
(14)
(11)
(11)
(13)
. (14) Por lo
la
, (13)
que
MEF
. (14)
, (13)
. (14)
,
(13)
(14)
dígito correspondiente a en binario). Esto nos permite reducir el número de ,
(14)
(11)
(12)
observamos que si expandimos en términos de la forma binaria de ( ), podemos escribir
Factorización cuántica del número 15
Por lo que la MEF se convierte en una serie de multiplicaciones controladas. Como si elevamos a una potencia par obtenemos 1 mod15, y si lo hacemos a una potencia impar, 11 mod15; la multiplicación está controlada por (el dígito correspondiente a en binario). Esto nos permite reducir el número de qubits a dos en el primer registro y cuatro en el segundo.
Por lo que la MEF se convierte en una serie de multiplicaciones controladas. Como si elevamos a una potencia par obtenemos 1 mod15, y si lo hacemos a una potencia impar, 11 mod15; la multiplicación está controlada por x0 (el dígito correspondiente a 20 en binario). Esto nos permite reducir el número de qubits a dos en el primer registro y cuatro en el segundo.




Eligiendo n=2 el estado (11) queda
Eligiendo el estado (11) queda
Observamos que cuando el segundo fotón del primer registro vale 1, el primer y el tercer fotón del segundo registro también valen 1, y de lo contrario valen 0. Por lo tanto, podemos conseguir este estado con dos puertas CNOT controladas por el segundo fotón del primer registro. Para la segunda QFT seguimos el circuito de la Figura 1. El circuito final se muestra en la Figura 2.
Observamos que cuando el segundo fotón del primer registro vale 1, el primer y el tercer fotón del segundo registro también valen 1, y de lo contrario valen 0. Por lo tanto, podemos conseguir este estado con dos puertas CNOT controladas por el segundo fotón del primer registro. Para la segunda QFT seguimos el circuito de la Figura 1. El circuito final se muestra en la Figura 2.
Circuito cuántico para factorizar el 15. La parte negra representa la primera QFT y la modulación exponencial, mientras que la azul representa la segunda QFT. Las puertas dentro del rectángulo azul se cancelan entre sí, ya que H actuando sobre si misma da la matriz identidad y la puerta Z solo afecta a la componente 1.
ura 2: Circuito cuántico para factorizar el exponencial, mientras que la azul representa la entre sí, ya que H actuando sobre si misma da Es sencillo comprobar que el . Es decir, con probabilidad como un fallo; y con probabilidad eligiendo obtenemos encontramos .
Es sencillo comprobar que el estado que devuelve este circuito es Es decir, con probabilidad 1/2 mediremos 0, que interpretamos como un fallo; y con probabilidad 1/2 mediremos 2. Sustituyendo en (13) y eligiendo m=1 obtenemos r=2 . Finalmente, según las Ecuaciones (8) y (9) encontramos p=3, q=5.
Es sencillo comprobar que el estado que devuelve este circuito es . Es decir, con probabilidad 1/2 mediremos 0, que interpretamos como un fallo; y con probabilidad 1/2 mediremos 2. Sustituyendo en (13) y eligiendo obtenemos . Finalmente, según las Ecuaciones (8) y (9) encontramos .
1. Es sencillo comprobar que el estado que devuelve este circuito es . Es decir, con probabilidad 1/2 mediremos 0, que interpretamos como un fallo; y con probabilidad 1/2 mediremos 2. Sustituyendo en (13) y eligiendo obtenemos . Finalmente, según las Ecuaciones (8) y (9) encontramos .
6.2. Sistema óptico
6.2. Sistema óptico
6.2. SISTEMA ÓPTICO
6.2. Sistema óptico
Existen unos dispositivos llamados refracción distinto para componente
Existen unos dispositivos llamados láminas de onda, que tienen un índice de refracción distinto para componente H y V y que, por lo tanto, son capaces de retardar una de las polarizaciones una fracción de onda (en función de n serán láminas de media onda, de cuarto de onda…). En este caso, el índice de refracción se convierte en un tensor, y podemos encontrar una base en la que su representación sea diagonal. Las láminas de onda son, en general, uniaxiales,
Existen unos dispositivos llamados láminas de onda, que tienen un índice de refracción distinto para componente H y V y que, por lo tanto, son capaces de retardar una de las polarizaciones una fracción de onda (en función de serán láminas de media onda, de cuarto de onda…). En este caso, el índice de refracción se convierte en un tensor, y podemos encontrar una base en la que su representación sea diagonal. Las láminas de onda son, en general, uniaxiales, lo que significa que solo una de las componentes del tensor de refracción es distinta a las demás. El eje correspondiente a esta componente se denomina eje óptico.
Existen unos dispositivos llamados láminas de onda, que tienen un índice de refracción distinto para componente H y V y que, por lo tanto, son capaces de retardar una de las polarizaciones una fracción de onda (en función de serán láminas de media onda, de cuarto de onda…). En este caso, el índice de refracción se convierte en un tensor, y podemos encontrar una base en la que su representación sea diagonal. Las láminas de onda son, en general, uniaxiales, lo que significa que solo una de las componentes del tensor de refracción es distinta a las demás. El eje correspondiente a esta componente se denomina eje óptico.
retardar una de las polarizaciones serán láminas de media onda, de refracción se convierte en un tensor, su representación sea diagonal. uniaxiales, lo que significa que solo refracción es distinta a las demás. se denomina eje óptico.
Si hacemos pasar luz polarizada horizontalmente (estado 0) por una lámina de
Si hacemos pasar luz polarizada horizontalmente (estado 0) por una lámina de media onda (HWP) cuyo eje óptico está a de la horizontal, obtenemos luz
Si hacemos pasar luz polarizada horizontalmente media onda (HWP) cuyo eje óptico polarizada a . Este es el resultado
341
(15)
.
(14)
.
(15)
Figura 2: Circuito cuántico para factorizar el 15. La parte negra representa la primera QFT y la modulación exponencial, mientras que la azul representa la segunda QFT. Las puertas dentro del rectángulo azul se cancelan entre sí, ya que H actuando sobre si misma da la matriz identidad y la puerta Z solo afecta a la componente
Figura 2: Circuito cuántico para factorizar el 15. La parte negra representa la primera QFT y la modulación exponencial, mientras que la azul representa la segunda QFT. Las puertas dentro del rectángulo azul se cancelan entre sí, ya que H actuando sobre si misma da la matriz identidad y la puerta Z solo afecta a la componente 1.
Figura 02
CERTAMEN JÓVENES INVESTIGADORES / Tecnologías e Ingenierías
lo que significa que solo una de las componentes del tensor de refracción es distinta a las demás. El eje correspondiente a esta componente se denomina eje óptico.
deja pasar la luz polarizada horizontalmente y refleja la luz polarizada verticalmente.
deja pasar la luz polarizada horizontalmente y refleja la luz polarizada verticalmente.
Si hacemos pasar luz polarizada horizontalmente (estado 0) por una lámina de media onda (HWP) cuyo eje óptico está a 22.5º de la horizontal, obtenemos luz polarizada a 45º . Este es el resultado de aplicar una puerta de Hadamard al estado 0, por lo que implementaremos la puerta de Hadamard con láminas de media onda.
Después de varios intentos llegamos el circuito de la Figura 3, que procedemos a demostrar.
Después de varios intentos llegamos el circuito de la Figura 3, que procedemos a demostrar.
deja pasar la luz polarizada horizontalmente y refleja la luz polarizada
Para diseñar el sistema óptico de las CNOT, nos inspiramos en los modelos propuestos en (Nemoto, 2004), que están basados en divisores de haz polarizados (PBS): dispositivos formados por una lámina semiplateada que deja pasar la luz
Sistema óptico para factorizar el 15. Se muestran los fotones 1 y 2 del primer registro (números 1 y 2) y el primer y el tercer fotón del segundo registro (números 3 y 5). Los fotones 4 y 6 se han omitido ya que no es necesario realizar ninguna operación sobre ellos. Los recuadros al final de los caminos 2 y 5 representan el aparato de medida.
Figura 3: Sistema óptico para factorizar el 15. Se muestran los fotones 1 y 2 del primer registro (números 1 y 2) y el primer y el tercer fotón del segundo registro (números 3 y 5). Los fotones 4 y 6 se han omitido ya que no es necesario realizar ninguna operación sobre ellos. Los recuadros al final de los caminos 2 y 5 representan el aparato de medida.



Observamos que los fotones 1, 3 y 5 atraviesan una lámina de media onda, por lo que salen de ella en un estado
Observamos que los fotones 1, 3 y 5 atraviesan una lámina de media onda, por lo que salen de ella en un estado
Observamos que los fotones 1, 3 y 5 atraviesan una lámina de media onda, por lo que salen de ella en un estado
(16)
Observamos que los fotones 1, 3 y 5 atraviesan una lámina de media onda, por lo que salen de ella en un estado (16)
(16)
Si pusiéramos un detector al final del camino 3, podríamos medir un fotón 3 en estado 0 o un fotón 1 en estado 1. Podemos escribir esto como (17)
Si pusiéramos un detector al final del camino 3, podríamos medir un fotón 3 en estado 0 o un fotón 1 en estado 1. Podemos escribir esto como (17)
Si pusiéramos un detector al final del camino 3, podríamos medir un fotón 3 en estado 0 o un fotón 1 en estado 1. Podemos escribir esto como
Si pusiéramos un detector al final del camino 3, podríamos medir un fotón 3 en estado 0 o un fotón 1 en estado 1. Podemos escribir esto como (17)
(17)
En cualquier otro caso, esta puerta funcionaría con probabilidad , pero en nuestro caso, podemos poner un polarizador vertical antes del detector. De esta manera, si el fotón 1 vale 1, podremos medir un estado 1, que es la negación del fotón 3. Por el contrario, si el fotón 1 vale 0, ningún fotón atraviesa el polarizador y asignamos un valor 0 al fotón 3. De hecho, como en este caso
En cualquier otro caso, esta puerta funcionaría con probabilidad , pero en nuestro caso, podemos poner un polarizador vertical antes del detector. De esta manera, si el fotón 1 vale 1, podremos medir un estado 1, que es la negación del fotón 3. Por el contrario, si el fotón 1 vale 0, ningún fotón atraviesa el polarizador y asignamos un valor 0 al fotón 3. De hecho, como en este caso el polarizador formaría parte del aparato de medida, el Principio de la Medición en Diferido nos garantiza que no tenemos que gastar recursos en incluirlo en el circuito. La validez de la segunda puerta CNOT se demuestra igual que la de la primera, ya que son idénticas.
En cualquier otro caso, esta puerta funcionaría con probabilidad , pero en nuestro caso, podemos poner un polarizador vertical antes del detector. De esta manera, si el fotón 1 vale 1, podremos medir un estado 1, que es la negación del fotón 3. Por el contrario, si el fotón 1 vale 0, ningún fotón atraviesa
342
31º
Figura 3: Sistema óptico para factorizar el 15. Se muestran los fotones 1 y 2 del primer registro (números 1 y 2) y el primer y el tercer fotón del segundo registro (números 3 y 5). Los fotones 4 y 6 se han omitido ya que no es necesario realizar ninguna operación sobre ellos. Los recuadros al final de los caminos 2 y 5 representan el aparato de medida.
Figura 03
(16)
el polarizador y asignamos un valor 0 al fotón 3. De hecho, como en este caso
Figura 3: Sistema óptico para factorizar el 15. Se muestran los fotones 1 y 2 del primer registro (números 1 y 2) y el primer y el tercer fotón del segundo registro (números 3 y 5). Los fotones 4 y 6 se han omitido ya que no es necesario realizar ninguna operación sobre ellos. Los recuadros al final de los caminos 2 y 5 representan el aparato de medida.
Factorización cuántica del número 15
En cualquier otro caso, esta puerta funcionaría con probabilidad 1/2 , pero en nuestro caso, podemos poner un polarizador vertical antes del detector. De esta manera, si el fotón 1 vale 1, podremos medir un estado 1, que es la negación del fotón 3. Por el contrario, si el fotón 1 vale 0, ningún fotón atraviesa el polarizador y asignamos un valor 0 al fotón 3. De hecho, como en este caso el polarizador formaría parte del aparato de medida, el Principio de la Medición en Diferido nos garantiza que no tenemos que gastar recursos en incluirlo en el circuito. La validez de la segunda puerta CNOT se demuestra igual que la de la primera, ya que son idénticas.
7. CONCLUSIÓN
Para concluir, hemos logrado nuestro objetivo inicial de diseñar un sistema óptico capaz de implementar el Algoritmo de Shor para factorizar el 15. Para ello, hemos estudiado la naturaleza cuántica de la luz y hemos visto cómo se transmite en ondas discretas: los fotones, cuyo estado de polarización hemos usado para crear un sistema de qubits. Hemos estudiado el Algoritmo de Shor y hemos logrado implementar puertas de Hadamard y CNOT utilizando materiales sencillos: láminas de media onda y divisores de haz polarizados. No obstante, también cabe mencionar lo que no hemos conseguido: no hemos logrado construir un circuito general para factorizar cualquier semiprimo, ya que hemos particularizado para el 15. Por lo tanto, una forma de construir sobre la base de este proyecto sería programar una red neuronal capaz de hacer lo mismo que hemos hecho aquí y generar un circuito cuántico para cualquier semiprimo dado. Si esto se consiguiera, significaría el fin del sistema de encriptación RSA (el algoritmo de clave pública más extendido) y el comienzo de una nueva era de la información, esta vez cuántica.
BIBLIOGRAFÍA
De Lacalle, J.G.L. (2004): “Factorización polinomial de números enteros”. La Gaceta de la RSME 7, 515-537.
Mataix, C., Rodríguez, A. R., Rivadulla, A. (2002): Física cuántica y realidad, vol.18. Editorial Complutense.
Montañez, S. (2017), “Curso de mecánica cuántica para estudiantes de Bachillerato”, Divulgamadrid, [en línea], disponible en http://divulgamadrid.blogspot.com/
Nemoto, K., Munro, W. J. (2014): “Nearly deterministic optical controlled-not gate”. Phys. Rev. Lett. 93.
343
Comunicación inalámbrica mediante luz visible: Implementación con Arduino UNO
/ SEGUNDO PREMIO
AUTOR | DAVID LOZANO
CAMPILLO
COORDINADOR | LUIS VICENTE VICENTE
CENTRO | I.E.S. FRANCISCO DE GOYA
CIUDAD | MOLINA DE SEGURA-MURCIA
RESUMEN |
Nuestra sociedad actual, altamente dependiente de Internet y de las TIC, ha demandado de forma exponencial la transmisión de datos de manera inalámbrica, como la tecnología Wi-Fi, Bluetooth, NFC, etc. Este tipo de intercambio de información ha experimentado una limitación muy importante en las dos últimas décadas: la saturación de la franja del espectro electromagnético empleada para dichas transmisiones, ocasionando la consiguiente reducción de la velocidad, el incremento en la interferencia entre dispositivos y la pérdida de datos. En un mundo globalizado y en constante expansión, esto supone un problema que debe ser resuelto con la mayor celeridad posible. El siguiente proyecto usa lámparas LED para transmitir información por medio de pulsos de luz variables, lo que sortea la saturación del espectro al emplear una franja distinta a las ondas de radio. Además, este sistema puede potencialmente alcanzar una velocidad mayor a las redes Wi-Fi actuales, ya que emplea tecnología basada en la óptica. El sistema implementado cumple dos funcionalidades: la ya mencionada y la de iluminar el espacio de trabajo o convivencia, consiguiendo un substancial ahorro de energía. El siguiente trabajo desarrollará los circuitos electrónicos del sistema, la codificación de los programas necesarios para su funcionamiento y su implementación en la realidad, con el objetivo principal de enviar texto codificado en formato ASCII. La comunicación será bidireccional en el sentido de la creación un sistema de feedback vía infrarrojos que permite detectar errores en la transmisión y paquetes perdidos.
TECNOLOGÍAS E INGENIERÍAS 344
ABSTRACT |
Our current society, highly dependent of Internet and Information Technologies, has been progressively demanding for more data transmission in a wireless way (Wi-Fi technology, Bluetooth, etc.), which have been limited by the increasing saturation of the electromagnetic spectrum, producing consequently reductions of velocity and the rise of interferences. In a globalized world and in continuous growth, this represents an issue that must be faced with the highest priority. The following project uses LED (Light Emitting Diode) technology for conveying information via light pulses with varying width, which solves the obstacle of continuous interference due to the medium saturation. Besides, a higher hypothetical velocity compared to Wi-Fi networks may be reached due to the usage of optical technology, and the system meets two functionalities: the first mentioned and the illumination one, achieving a substantial save of energy. This project will consist of the development of the communication system’s circuits, the required computer programs to exchange information and its implementation in a real system, with the objective of transmitting text codified in the ASCII format. The communication will be bidirectional in the sense of the developing of a system that allows the receiver to send a code to the transmitter acknowledging that the data has been received correctly with infrared sensors.
345
31º CERTAMEN JÓVENES INVESTIGADORES / Tecnologías e Ingenierías
1. INTRODUCCIÓN
El ser humano ha necesitado comunicarse desde su inicio, y por ello ha desarrollado numerosos medios con este propósito, entre los que se encuentran la escritura, el correo postal, el telégrafo, el teléfono y, en las últimas décadas del siglo XX, Internet. Para comunicarse por Internet es necesaria una conexión de red, y la comunicación inalámbrica es la más empleada y cómoda hoy día. Sin embargo, el gran número de diferentes tecnologías wireless, como Wi-Fi, Bluetooth y 4G, y el gran número de dispositivos que las emplean han causado una progresiva congestión y saturación del espectro electromagnético. Esto ha causado una gran congestión en el tráfico de datos, reducción de la velocidad y pérdida de información debido a interferencias. La saturación del espectro, y el empeoramiento de esta situación en un futuro muy próximo, sumado al aumento del tráfico móvil (inherentemente inalámbrico), la creación del Internet of Things, y la instauración del protocolo IPv6, al haberse acabado el número de direcciones IPv4 disponibles, hace evidente la necesidad de una revolución en las tecnologías wireless.
El siguiente proyecto tiene como principal motivación solventar el problema previamente mencionado, la saturación del espectro electromagnético, proponiendo explotar una franja que hasta hoy día ha sido utilizada en escasas ocasiones: la de la luz visible. Aunque ya ha sido empleada para comunicación veloz y fidedigna entre satélites militares y centros de control en la tierra, o entre satélites con línea de visión directa, no ha encontrado una aplicación práctica en el mercado común de redes inalámbricas. El sistema de comunicación planteado en este proyecto emplea el alumbrado propio de la casa para transmitir los datos, necesitando solamente un microcontrolador programado que actúe a modo de coordinador entre emisor y receptor. Esto podría conllevar un sustancial ahorro energético, ya que se realizaría la función de iluminar y de transmitir información a la misma vez.
Hay sistemas en los que la fiabilidad de la transmisión de datos es crucial: es el caso de los dispositivos electrónicos presentes en los hospitales o aviones, lo que tiene como consecuencia la prohibición del uso de dispositivos electrónicos ajenos al propio sistema en el caso más extremo o la necesidad de deshabilitar la funcionalidad wireless, el conocido modo avión. La tecnología propuesta en este proyecto, al usar el espectro visible, no requiere que se interrumpa la conexión con Internet para el correcto funcionamiento de dichos instrumentos. Otra motivación para desarrollar este sistema es el aumento de la privacidad y la seguridad que ofrecería, reduciéndose la posibilidad de que se realicen ataques informáticos a los usuarios para robar información: solo se puede recibir señal si existe una línea de visión directa con el emisor, ya que la luz visible no atraviesa las paredes y los objetos sólidos, a diferencia de las ondas de radio empleadas por el estándar Wi-Fi o Bluetooth.
346
Comunicación inalámbrica mediante luz visible: Implementación con Arduino UNO
2. OBJETIVOS
El principal objetivo de este proyecto de investigación es el desarrollo de un transceptor, un dispositivo capaz de emitir y recibir información, que emplee la luz visible de color blanco para transmitir datos. El objetivo no es desarrollar un sistema de alta velocidad que sustituya, al menos de forma inmediata, a la tecnología convencional, sino uno fiable, eficaz, con los menores errores en la transmisión posibles y que presente una funcionalidad básica con aplicaciones inmediatas.
Las especificaciones mínimas del sistema a desarrollar se resumen en los siguientes: debe emplear luz visible, de color blanco y con una iluminación mímina de 300 lúmenes para poder cubrir una distancia de 1 metro y cumplir el objetivo de servir como fuente de iluminación estándar; emplea materiales low-cost; el parpadeo del LED al transmitir información no debe ser apreciable, luego la frecuencia de transmisión tiene que ser mayor a 1 KHz; debe implementar un sistema de acuse de recibo con el objetivo de recuperar paquetes perdidos y subsanar la posible corrupción de datos al ser enviados; debe ser portable a placa PCB con el objetivo de aumentar la capacidad del sistema para ser embebido en otros; una tasa de error inferior al 10%, una velocidad mínima de 500 bps y distancia mínima de transmisión de 30cm. En cuanto a las aplicaciones posibles a las que se debe ajustar se encuentran la transmisión de texto en formato ASCII, de órdenes (para implementar sistemas de domótica), e incluso la posibilidad de controlar un robot de forma remota, con comandos en forma de texto.
3. MÉTODO
Para desarrollar los planos y schematics de dicho sistema, se empleará el programa de software libre Fritzing, que permite desarrollar planos con componentes, vistas de esquema y diseños de placa PCB. Además, se empleará para codificar el algoritmo de funcionamiento del emisor y el receptor un IDE o entorno de desarrollo integrado, en este caso el Arduino IDE, de código abierto y con una gran cantidad de recursos online.
3.1. MATERIALES
Los materiales usados en este proyecto han sido low-cost, procurándose reutilizar los que ya poseía el instituto I.E.S. Francisco de Goya. Han sido los siguientes:
Dos microcontroladores Arduino. Este fue uno de los puntos más difíciles a tratar, ya que el microcontrolador es el núcleo del sistema de comunicación, encargado tanto de enviar como de recibir la información. Debe recibir los datos introducidos por el usuario en el PC, transformarlos en lenguaje binario, para posteriormente emitir una señal eléctrica que el LED transformará en luz. En el
347
CERTAMEN JÓVENES INVESTIGADORES / Tecnologías e Ingenierías
lado del receptor, debe poseer una frecuencia de muestreo suficientemente alta, término que será detallado con más profundidad posteriormente. La placa Arduino (más concretamente su ADC, analog-to-digital converter) tiene una tasa de muestreo de aproximadamente 10 KHz, pero como las llamadas a funciones al ejecutar el código responsable de procesar el código ocupan pulsos de reloj, esta frecuencia se reduce hasta los 5 KHz, lo que nos limita la velocidad máxima a aproximadamente 1 KB. Por lo tanto, la única limitación técnica a la hora de aumentar la velocidad del sistema sería dicha tasa de muestreo (junto con la frecuencia máxima del reloj), fácilmente solucionable conectando un ADC externo, por lo que a pesar de esta desventaja se decidió usar una placa Arduino UNO debido a su bajo coste, a que es software y hardware libre y a que posee una cómoda interfaz de uso para la programación del sistema.
Lámpara LED, de tipo ojo de buey, modelo JZMR16-D5E2, con una luminosidad de 450 lúmenes, un ángulo de haz luminoso de 60 grados, y color blanco neutro, es decir, suficientemente cálido para no producir cansancio en los ojos, pero con la intensidad luminosa necesaria para servir como emisor en este medio de comunicación.
Transistor de tipo MOSFET, necesario para operar con voltajes superiores a 5V, ya que la lámpara disminuye su luminosidad al transmitir información por medio de parpadeos por lo que es necesario potenciarla con un voltaje mayor. Alimentada por el puerto USB del PC a través de la placa Arduino alcanza una luminosidad inferior a los 300 lúmenes, pero la alimentación a la luminaria puede ser por medios externos, ya que este proyecto está planteado para ser aplicado a luminarias de una habitación, que ya se hayan potenciadas por la red eléctrica del edificio. Por ello el transistor debe poder resistir un voltaje alto, y los modelos BJT son descartados. El empaquetado TO-220AB es el preferido para los MOSFET, capaz de disipar hasta 50W y que posee un agujero para montar un disipador sobre él.
Fototransistor. El primer dilema para el diseño del receptor fue la elección de un fototransistor o un fotodiodo. Resultaría claro elegir el fototransistor para este proyecto, ya que realiza una amplificación que el fotodiodo no hace debido a la posibilidad de emplear un transistor como un amplificador. Se escogieron como modelos idóneos para este proyecto: el LPT 80 A y el SFH 310, que presentan estructuras diferentes: mientras que el modelo LPT 80 A está diseñado para recibir luminosidad de frente (hay que pensar que ambos componentes se colocarán de manera vertical), el modelo SFH 310 está diseñado para recibir la señal desde arriba. Como comprobaremos posteriormente, debido a la disposición de la lámpara LED, el modelo LPT 80 A será el que mejor cumpla nuestras necesidades.
Emisor y receptor infrarrojo. Para cumplimentar el requisito de la comunicación bidireccional, se deberá emplear un LED y un fototransistor adicional para enviar datos en el espectro electromagnético infrarrojo. Debido a que en
31º
348
Comunicación inalámbrica mediante luz visible: Implementación con Arduino UNO
este campo hay poca alternativa, se optó por emplear los dos módulos emisor-receptor disponibles en el instituto, más concretamente, de la marca Exile.
Amplificador operacional. El amplificador es empleado en la parte analógica del receptor para generar ganancia de voltaje en la señal y transformarla en una señal “legible” por el microprocesador. Debido a que la señal no será todo lo elevada a la salida del fototransistor como gustaría, ya que existe interferencia del medio y que la frecuencia pico emitida por el LED no coincide con la frecuencia pico en el fototransistor, será necesario que la ganancia proporcionada por el amplificador operacional sea grande. El modelo LM358P fue el escogido, debido a la poca diferencia de ganancia de los op-amps y a su alto voltaje de entrada. La razón principal por la que ha sido elegido es por su disponibilidad.
Condensador. Existen tres tipos de condensadores que consideraremos: de cerámica, de papel y electrolíticos. Debido a que, como se comprobará, necesitamos condensadores con una capacidad de alrededor de 100 nF. Se escogió finalmente un condensador de papel: u1J63, con 100 nF de capacidad.
Osciloscopio: El proyecto se inició sin la ayuda de esta herramienta, pero debido a los numerosos obstáculos durante el desarrollo analógico y a las recomendaciones del coordinador, se decidió buscar diferentes modelos de osciloscopios. El osciloscopio DSO138 fue finalmente el escogido para desarrollar este proyecto.
4. RESULTADOS
4.1. EMISOR
En el diseño inicial del emisor, se pensó en emplear LED de bajo coste en paralelo para transmitir datos. La ventaja de estos es que podrían ser potenciados por la salida digital de Arduino y no necesitarían de un transistor para funcionar. Sin embargo, como se comprobó posteriormente, este diseño no es escalable. Es por esto que fue diseñado con una bombilla de ojo de buey LED mediante un transistor de tipo MOSFET PNP. El esquema de la implementación electrónica se muestra en la Figura 4. La Figura 3 muestra la vista en breadboard o protoboard del emisor. La diferencia de esta con la primera es clara: mientras que la primera se desarrolló en la primera etapa, con los valores de las resistencias, el tipo de MOSFET y el tipo de LED, la segunda muestra la implementación física del proyecto.
4.2. RECEPTOR
El receptor convierte la luz recibida en corriente empleando un fototransistor. Los componentes electrónicos del receptor deben transformar la corriente en voltaje para amplificar y filtrar la señal. Debido a que el diseño es un prototipo
349
31º CERTAMEN JÓVENES INVESTIGADORES / Tecnologías e Ingenierías
inicial y a que no se pretende que el LED del emisor se desplace, no se ha considerado necesario el uso de un Controlador de Ganancia Automática, o AGC. Este dispositivo amplifica o reduce la señal a un voltaje de salida previamente especificado. Para asegurarse de que la señal es digital, esto es, comprendida entre dos valores discretos y que sea estable, un op-amp fue empleado para procesar la señal analógica obtenida y un filtro de paso alto para reducir el ruido. El diseño general del receptor es mostrado en la Figura 5.
Divisor de voltaje: Un fototransistor, al ser conectado a la alimentación, permite el paso de corriente del emisor al colector si su base recibe intensidad lumínica suficiente. La placa Arduino, es incapaz de interpretar la corriente eléctrica, por lo que deberemos transformar dicha corriente en voltaje. Para ello emplearemos un divisor de voltaje: usando solo dos resistencias en serie, podemos crear un voltaje de salida que es una fracción del de entrada
Filtro de paso alto: Para eliminar el ruido indeseado, procedente del propio circuito o de interferencias electromagnéticas, tanto fuera del espectro visible como dentro de él, un filtro de paso alto fue incluido en el diseño. Fue elegido un filtro pasivo en vez de uno activo (que proporciona ganancia de señal) ya que la señal será amplificada posteriormente en el op-amp. Para evitar la distorsión de los datos enviados, el filtro se ha diseñado con una frecuencia umbral relativamente baja. Por lo tanto, está formado por una resistencia de 10 kΩ y un condensador de 100 nF. El filtro escogido nos da una función de transferencia (función que muestra la curva característica de frecuencias permitidas por el filtro paso alto). Las frecuencias mayores a 1000 Hz permanecen inalteradas; Sin embargo, las frecuencias menores a dicha frecuencia se ven atenuadas por el filtro paso alto. Debido a que la señal a transmitir se halla en torno a 1 KHz y el ruido ambiental causado por la luz solar tiene una frecuencia baja, esta función de transferencia es idónea para el sistema planteado.
Condensador: El condensador en este diseño cumple un doble propósito: el primero es el mencionado en el apartado anterior, formar un filtro paso alto adecuado para el posterior procesamiento de la señal. En dicho apartado se debió determinar la capacitancia adecuada del condensador para que el HPF bloquease las señales deseadas. Sin embargo, la segunda función de dicho condensador no es otra que la conversión de la señal DC, que solo tiene voltaje positivo, en una señal AC de voltaje tanto positivo como negativo.
Amplificador operacional: Al comenzar el proyecto, y basándose en la bibliografía encontrada, se planteó la posibilidad de no procesar la señal, e introducirla directamente al pin analógico de Arduino, recibiendo los datos con su función analogRead() y procesar matemáticamente la señal obtenida para descodificar los datos. Sin embargo, este enfoque no tardó en mostrar problemas: Por ello, este sistema fue finalmente descartado a favor de un comparador. Un comparador es un dispositivo que compara dos voltajes o corrientes y produce una señal digital indicando cuál es mayor. Tiene dos terminales analógicas,
350
Comunicación inalámbrica mediante luz visible: Implementación con Arduino UNO
V + y V-, y un terminal de salida binario V0. Por lo tanto, uno de los voltajes de entrada sería la señal del fototransistor procesada por el HPF y transformada a AC por el condensador, y el único reto sería el de averiguar el valor idóneo del valor de la tensión del otro terminal, que resultó coincidir con la alimentación de 5V que proporciona la placa Arduino. El comparador transforma la señal triangular de entrada en una señal cuadrada; la ventaja de este sistema es la menor sensibilidad ante cambios de la forma de la señal.
4.3. CODIFICACIÓN DE LA SEÑAL
Para envíar los datos de manera inalámbrica, es necesario modularlos. Entre todos los diferentes tipos de modulaciones, que no serán explicados aquí, como ASK, PSK, QAM o PWM, esta última empleada por la placa Arduino de forma nativa, nos hemos decantado por la modulación Manchester. La codificación o modulación Manchester, también denominada codificación bifase-L, es un método de codificación eléctrica de una señal binaria en el que en cada tiempo de bit hay una transición entre dos niveles de señal. Es una codificación autosincronizada, ya que en cada bit se puede obtener la señal de reloj, lo que hace posible una sincronización precisa del flujo de datos. Una desventaja es que consume el doble de ancho de banda que una transmisión asíncrona. Esta codificación es una variación de la modulación por desplazamiento de fase (PSK), en el que la onda modulante varía la fase de una onda cuadrada modulada. Por regla general, el 0 se codifica como 01 y el 1 como 10.
Hay un aspecto que es clave para el desarrollo del sistema y la principal razón de por qué este tipo de modulación fue el empleado en el prototipo final a pesar de que ralentizaría la velocidad de emisión de datos: un requisito necesario para el correcto funcionamiento del sistema era que el LED no debía emitir un parpadeo reconocible por el usuario. La codificación Manchester nos asegura que el ciclo de trabajo de la señal transmitida es del 50%.
4.4. DIAGRAMA DE MÁQUINA DE ESTADO FINITO
Esta sección tratará sobre el algoritmo empleado para la transmisión de datos y la recepción en el sistema.
Emisor: Después de ser inicializado, el emisor inicia su modo de espera de datos. Cuando los datos son enviados, la transmisión es iniciada enviando un preámbulo para sincronizarse con el receptor e indicarle que se prepare para recibir datos. Posteriormente se envía la longitud en bits del paquete, los datos en sí con el número de secuencia y finalmente una cantidad denominada checksum o suma de verificación. Esta suma de verificación toma todos los datos enviados y los introduce como entrada a una función hash o digest, que para una cadena de bits genera otra cadena de 8 bits única. Por lo tanto, en el receptor se volverá a realizar la función hash sobre todos los datos recibidos y se comprobará si coincide con el checksum recibido en el paquete. Si no, el emisor
351
31º CERTAMEN JÓVENES INVESTIGADORES / Tecnologías e Ingenierías
no recibirá la señal de confirmación del receptor y lo enviará de nuevo hasta que se reciban de forma correcta.
Receptor: El receptor está en standby hasta que detecta un preámbulo. Cuando es detectado, la longitud de los datos y el número de secuencia son leídos y la transmisión de datos comienza. Si la transmisión de datos es satisfactoria, esto es, los datos coinciden con el checksum tras aplicarle la función digest, el receptor envía mediante infrarrojos una señal de confirmación al emisor. Si no, o si no se recibe checksum, se vuelve a esperar un preámbulo ya que al detectar el emisor que no se ha recibido una confirmación, será enviado el paquete de nuevo.
Los dos diagramas de estado finito, tanto del emisor como receptor, se pueden visualizar en la Figura 8 (emisor), y en la Figura 9 (receptor).
4.2. ESTRUCTURA DEL PAQUETE
Empaquetar los datos a transmitir es una técnica útil en transmisión de datos, debido a que mejora la sincronización emisor-receptor con un preámbulo, y en el caso de que un paquete se corrompiera, solo habría que transmitir de nuevo el paquete y no el archivo o cadena de texto entero. El paquete básico para la transmisión de datos en este sistema tiene la siguiente estructura: 10 bits de preámbulo, 1 bit separador, 10 bits de número de secuencia, 128 bits de datos, 1 bit separador, 10 bits de checksum y 1 bit que indica el final del paquete. Para notificar que un paquete está a punto de ser enviado y que necesita ser registrado, el transmisor enviará un preámbulo. Para detectar el preámbulo, se empleará un buffer circular en forma de queue o cola. Todos los paquetes son numerados, y el número de secuencia es enviado con el paquete. Esto sirve para manejar las duplicaciones de paquetes. Tras enviar el número de secuencia, el algoritmo de envío de datos se dispone a enviar hasta 128 bits de datos, que consisten en 16 caracteres de 8 bits separados cada uno por 1 bit. Todos estos datos serán codificados en modulación Manchester y posteriormente desmodulados en el receptor. Finalmente, tras enviar la totalidad de los datos, se envía un checksum que servirá para el manejo de errores.
5. CONCLUSIONES
El proyecto de comunicación por luz visible ha conseguido su propósito de diseñar e implementar un sistema en funcionamiento. La transmisión de datos es satisfactoria. El sistema es capaz de transmitir y recibir datos determinados de una manera arbitraria a una distancia de 20 cm, aunque esta distancia es ampliable si se proporciona más potencia a la lámpara LED, ya que la proporcionada actualmente es de 5V, bastante inferior a la recomendada por el fabricante (debido a que es la máxima que proporciona la placa), y a que el LED podría ser sustituido por uno de mayor potencia. Se transfieren datos a una velocidad hipotética de 500 bps, pudiendo parecer considerablemente baja comparada
352
Comunicación inalámbrica mediante luz visible: Implementación con Arduino UNO
con los sistemas de comunicación actuales, pero hay que tener en cuenta que los recursos empleados en este proyecto han sido low-cost, y que la mayoría de los sistemas de comunicación, tanto inalámbricos como por fibra óptica o cable de cobre, poseen sistemas empotrados especializados que reducen los costes y aumentan la potencia. Sin embargo, requiere una gran inversión económico desarrollarlos. Se ha conseguido transmitir una cantidad arbitrariamente larga de datos de manera satisfactoria, ya que, aunque la trasmisión de un paquete puede fallar, el sistema es consciente de que dicha transmisión ha fallado (mediante el acuse de recibo realizado por el módulo de emisión y recepción infrarrojos) y reenvía el paquete hasta que se transmitan los datos de manera satisfactoria. Esto reduce la velocidad real del sistema, y esta reducción está determinada por la tasa de fallos del sistema, aproximadamente un 10% de datos enviados, por lo que la velocidad real alcanzaría unos 450 bps.

6. AGRADECIMIENTOS
Gracias a Sergio Gallardo, Ángel Molina y especialmente a Luis Vicente por guiarme en el desarrollo de este proyecto de investigación, a mis padres y a mis amigos por su apoyo.
7. FIGURAS

353
Figura 01
Diagrama de bloques.
Figura 02
Diagrama del emisor.
31º CERTAMEN JÓVENES INVESTIGADORES / Tecnologías e Ingenierías
Figuras 03 y 04
Schematic del emisor (derecha) y vista de componentes en Fritzing (izquierda).















Figuras 06 y 07
Schematic del emisor (izquierda) y vista de componentes en Fritzing (derecha).
Leyenda:
Leyenda:
ED: Esperar datos
ED: Esperar datos
Leyenda:
EPB: Emitir Preámbulo
Leyenda:
ED: Esperar datos
EPB: Emitir Preámbulo
EL: Emitir Longitud
EPB: Emitir Preámbulo
ED: Esperar datos
ED: Emitir Datos
EL: Emitir Longitud
EL: Emitir Longitud
EPB: Emitir Preámbulo
ECK: Emitir Checksum
ED: Emitir Datos
ED: Emitir Datos
ECK: Emitir Checksum
EC: Esperar Confirmación
EL: Emitir Longitud
ECK: Emitir Checksum
EC: Esperar Confirmación
dt: Datos
ED: Emitir Datos
dt: Datos
EC: Esperar Confirmación
!dt: No datos
ECK: Emitir Checksum



dt: Datos
cf: Confirmación
EC: Esperar Confirmación
!cf: No confirmación
dt: Datos
354
Figura 08
Diagrama de estado finito del emisor.
Figura 05
Diagrama del receptor.
Figuras 3 y 4: del emisor (derecha) y vista de componentes en Fritzing (izquierda)
Figura 5: Diagrama del receptor
Figura 6 y 7: del emisor (izquierda) y vista de componentes en Fritzing (derecha)
Figuras 3 y 4: del emisor (derecha) y vista de componentes en Fritzing (izquierda)
Figura 6 y 7: schematic del emisor (izquierda) y vista de componentes en Fritzing (derecha)
Figura 5: Diagrama del receptor
Figura 6 y 7: schematic del emisor (izquierda) y vista de componentes en Fritzing (derecha)
Comunicación inalámbrica mediante luz visible: Implementación con Arduino UNO
!dt: No datos
cf: Confirmación
!cf: No confirmación
Figura 8: Diagrama de estado finito del emisor
EPB: Esperar Preámbulo
RL: Recibir Longitud
EPB: Esperar Preámbulo
RD: Recibir Datos
RL: Recibir Longitud
RCK: Recibir Checksum
RD: Recibir Datos
CCK: Confirmar Checksum
RCK: Recibir Checksum
EC: Enviar Confirmación
CCK: Confirmar Checksum
EC: Enviar Confirmación
pa: Preámbulo
ck: Checksum
pa: Preámbulo
ck: Checksum
!ck: No Checksum
crt: Checksum correcto
!ck: No Checksum
crt: Checksum correcto
!crt: Checksum no correcto
!crt: Checksum no correcto
8. BIBLIOGRAFÍA Y WEBGRAFÍA
[1] Cisco Visual Networking Index: Forecast and Trends, 2017–2022 White Paper (27 de febrero de 2019) Disponible en:
https://www.cisco.com/c/en/us/solutions/collateral/service-provider/visual-networking-index-vni/ white-paper-c11-741490.html
Aboul-Magd, O., Kim, J., Yang, D., Wentik, M. et al. (Septiembre de 2013) Status of Project IEEE 802.11ac. Disponible en:
http://www.ieee802.org/11/Reports/tgac_update.htm
Ambady, S., Bredes, M., Nguyen, C. (26 de marzo de 2015) Visible Light Communication. Disponible en:
https://web.wpi.edu/Pubs/E-project/Available/E-project-032615-203414/unrestricted/Visible_Light_Communication_MQP_Report_Final_2014-2015.pdf
Tamayo Balas, A. (2016) Estudio del estándar 802.15.7 del IEEE sobre sistemas de comunicación por luz visible. Disponible en:
https://idus.us.es/xmlui/bitstream/handle/11441/53164/TFG_Antonio_Tamayo_Balas_versi%C3%83%C2%B3n_final.pdf?sequence=1&isAllowed=y
Tuite, D. (9 de abril de 2013) UnderstandingLEDApplicationTheoryAndPractice. Disponible en:
http://www.electronicdesign.com/components/understanding-led-application-theory-and-practice

Márquez Flores, J. (2013) Amplificadoresoperacionales,IntroducciónaInstrumentaciónySeñales. Disponible en: http://www.academicos.ccadet.unam.mx/jorge.marquez/cursos/Instrumentacion/AmplificadoresOperacionales.pdf
Márquez Flores, J. (2013) Amplificadores operacionales, Introducción a Instrumentación y Señales. Disponible en:
http://www.academicos.ccadet.unam.mx/jorge.marquez/cursos/Instrumentacion/AmplificadoresOperacionales.pdf
355
Figura 09
Diagrama de estado finito del emisor.
Valorización de los residuos de marisco. Síntesis de nanopartículas de quitosano con efecto antimicrobiano
/ SEGUNDO PREMIO
AUTOR | XAVIER MANUEL DE RADA PIÑEIRO
COORDINADORA | MARÍA ROSARIO GARCÍA-ECHAVE LÓPEZ
CENTRO | IES ROSALÍA DE CASTRO
CIUDAD | SANTIAGO DE COMPOSTELA-A CORUÑA
RESUMEN |
El objetivo del trabajo es valorizar los residuos del consumo de crustáceos por medio de la obtención de quitosano, una molécula con unas propiedades físicoquímicas y biológicas que le confieren importantes aplicaciones.
Se extrajo quitina a partir de exoesqueletos de crustáceos y por desacetilación de la misma se obtuvo quitosano con un 94% de desacetilación.
Con el quitosano se formaron nanopartículas por gelación ionotrópica con TPP (Tripolifosfato). Se probaron diferentes proporciones de quitosano-TPP, obteniéndose partículas de 110 nm, 240 nm y 440 nm de diámetro. El diámetro de las nanopartículas se determinó con la técnica DLS. Se comprobó la actividad inhibitoria, por el método de difusión en agar y por microdilución, de soluciones de nanopartículas de los tres tamaños y del polímero libre, frente a tres microorganismos, Escherichia coli, Staphylococcus aureus y la levadura Candida albicans.
Se observó un efecto inhibitorio, pero débil, de las tres soluciones de nanopartículas, de 110 nm, 240 nm y 440 nm, y de la solución de quitosano libre, sobre los tres microorganismos probados.
Las nanopartículas de 110 nm provocaron una fuerte aglutinación de las bacterias E. coli y S. aureus y solo muy ligera en C. albicans. El polímero libre aglutinó también muy severamente a E. coli, más ligeramente a S. aureus y no provocó aglutinación de C. albicans. Pensamos que sería de mucho interés investigar si esta actividad del quitosano probada sobre al menos estos microorganismos, sería útil para impedir la formación de biofilms bacterianos.
TECNOLOGÍAS E INGENIERÍAS 356
ABSTRACT |
The aim of this project is value the waste produced in the consumption of crustaceans through the obtention of chitosan, a molecule with physicalchemical properties that confer it important applications.
Chitine was extracted from crustaceans’ exoeskeletons and by deacetylation of it, chitosan with a 94% deacetylation degree was extracted.
With the chitosan, nanoparticles were created by ionotropic gelation with TPP (Tripoliphosphate). Different chitosan-tripoliphosphate proportions were tested, obtaining particles of 110 nm, 240 nm and 440 nm of diameter. The diameter was determined with DLS.
The inhibitory activity was checked, by the method of agar diffusion and by microdilution, of nanoparticle solutions of the three sizes and of the free polymer against three microorganisms, Escherichia coli, Staphylococcus aureus and the yeast Candida albicans.
An inhibitory, but weak effect of the three solutions of nanoparticles, 110 nm, 240 nm and 440 nm, and the free chitosan solution was observed on the three microorganisms tested.
The 110 nm nanoparticles caused a strong agglutination of E. coli and S. aureus bacteria and only very slight agglutination in C. albicans. The free polymer also agglutinated very severely E. coli, more slightly to S. aureus and did not cause agglutination on C. albicans. We think it would be very interesting to investigate if this activity of the chitosan tested on at least these microorganisms, would be useful to prevent the formation of bacterial biofilms.
357
31º CERTAMEN JÓVENES INVESTIGADORES / Tecnologías e Ingenierías
1. QUITOSANO
El quitosano es un polímero lineal formado por monómeros de D-glucosamina y N-acetil-D-glucosamina, colocados al azar en la cadena y unidos por medio de enlaces β(1-4). Es un polímero hidrofílico porque los grupos básicos amino se cargan positivamente, el porcentaje de acetilación e incluso la distribución de los monómeros acetilados en las cadenas, tienen un efecto decisivo en la solubilidad y en la conformación de las moléculas de quitosano en medios acuosos (García Fuentes y Alonso, 2012).
Su alto potencial catiónico, junto con la baja toxicidad del quitosano y su biocompatibilidad y biodegradabilidad elevadas (Agnihotri et al.,2004; Lu et al., 2009; Chua et al., 2012), hacen que este producto pueda tener un importante uso terapéutico.
1.1. APLICACIONES TERAPÉUTICAS DEL QUITOSANO
El quitosano libre tiene varias aplicaciones como son la disminución del colesterol (Sugano et al.,1988), cicatrización de heridas (Azad et al.,2004), antiulceroso (Felt et al.,1998) o antimicrobiano (Rabea et al. 2005).
Realizándose estudios de citotoxicidad en animales y humanos se comprobó que por vía oral el quitosano no provoca problemas clínicos relevantes (Tapola et al., 2008). Está admitido por la FDA (Food Drug Administration) como suplemento alimentario.
El quitosano posee interés en el campo del “drug delivery” (De la Fuente et al., 2008; Csaba et al., 2006; Csaba et al., 2009; De la Fuente et al. 2010), que pensaron en el empleo de nanotransportadores de este polímero para el transporte de fármacos.
Se han elaborado nanopartículas de quitosano con muy numerosos fármacos tales como Nanopartículas para la administración de antígenos por vía nasal para vacunación (Vila et al., 2002), para la administración de otras proteínas y péptidos como la calcitonina de salmón y la insulina (Sarmento et al., 2007) o como sutituto de vectores virales en terapia génica (Leong et al., 1998).
1.2. EFECTO ANTIMICROBIANO DEL QUITOSANO
Numerosas investigaciones han demostrado la actividad antimicrobiana del quitosano sobre bacterias, hongos filamentosos y levaduras. Su actividad bactericida es de amplio espectro, tanto contra bacterias grampositivas como gramnegativas (No et al., 2002).
Según algunos investigadores, las nanopartículas tienen menos efecto inhibitorio que el polímero libre, porque las nanopartículas tienen menos carga po-
358
Valorización de los residuos de marisco. Síntesis de nanopartículas de quitosano con efecto antimicrobiano.
sitiva para la unión (Kong et al, 2010). Sin embargo, en otras publicaciones se constata más actividad con las nanopartículas y lo atribuyen a que tienen una elevada relación superficie/volumen, es decir, una muy alta área superficial y además, tienen mayor afinidad por las bacterias, y pueden ser adsorbidas en la superficie bacteriana, rompiéndose la membrana y liberándose los componentes celulares al exterior con la consiguiente muerte de la bacteria. (Qi et al, 2004).
1.2.1. NANOMATERIALES PARA EL TRATAMIENTO DE BIOFILMS ANTIBACTERIANOS
Se ha demostrado que las nanopartículas pueden prevenir la formación de biofilms, porque se colocan recubriendo la superficie del film o porque interrumpen el crecimiento del mismo (Hajipour et al., 2012).
Un biofilm contiene sustancias extracelulares poliméricas, compuestas por polisacáridos y proteínas, entre otras, que forman una red muy bien estructurada y resistente a la penetración de moléculas terapéuticas. Sin embargo, la habilidad de penetración de las nanopartículas catiónicas como las del quitosano las convierte en una herramienta muy prometedora.
La formación de biofilms es una respuesta a un mecanismo de comunicación celular por medio de la excreción de moléculas señalizadoras cuando la población alcanza una densidad determinada. Esas moléculas, que se llaman autoinductores, van a regular la expresión génica de las bacterias haciéndolas más patógenas y optimizando su trabajo en grupo.
2. OBTENCIÓN DE QUITOSANO A PARTIR DE QUITINA DEL EXOESQUELETO DE LOS ARTRÓPODOS
El quitosano se obtiene mediante la desacetilación de la quitina presente en los exoesqueletos de gambas, langostinos, cangrejos y demás artrópodos.
2.1. OBTENCIÓN DE NANOPARTÍCULAS DE QUITOSANO
El quitosano es fácilmente soluble en soluciones ácidas debido a que los grupos amino se encuentran protonados. La carga positiva resultante hace posible la obtención de nanopartículas por gelación ionotrópica con aniones polivalentes multivalentes como el tripolifosfato (TPP) (Jonassen et al., 2012). La gelación consiste en la formación de una matriz porque el agente aniónico, el TPP, se coloca entre los grupos catiónicos y los liga formando una red.
La concentración de quitosano, la relación quitosano-TPP, el peso molecular de las moléculas de quitosano, su grado de acetilación y la salinidad del medio en el que se preparan las nanopartículas son los factores que afectan a la formación de las mismas (Tsai et al., 2011). En este trabajo se estudiarán especial-
359
CERTAMEN JÓVENES INVESTIGADORES / Tecnologías e Ingenierías
mente la relación quitosano-TPP, bibliográficamente, unas relaciones de peso quitosano-TPP entre 4/1 y 6/1 dan buenos resultados (Janes y Alonso, 2003).
3. OBJETIVOS E HIPÓTESIS
3.1. OBJETIVOS
• Extraer la quitina del exoesqueleto del langostino austral.
• Obtener quitosano a partir de la quitina extraída y caracterizar el quitosano obtenido.
• Preparar nanopartículas de quitosano utilizando el método de gelación ionotrópica con tripolifosfato (TPP) e investigar que proporción de quitosano-TPP es la mejor para la obtención de nanopartículas y caracterizarlas.
• Estudiar la acción antimicrobiana de las nanopartículas en comparación con la del quitosano lineal.
3.2. HIPÓTESIS
Se espera obtener quitosano desde la quitina, mediante el proceso de desacetilación.
En cuanto a la formación de las nanopartículas se espera la obtención de las más adecuadas en aquellas proporciones con más quitosano.
Finalmente, se espera la comprobación del efecto antimicrobiano del quitosano, en especial con las nanopartículas, cuyo efecto antimicrobiano se espera que sea mayor.
4. Extracción de quitina del exoesqueleto de langostinos
Mediante el método de Benhabiles et al. (2012) y No et al. (1995).
Se utilizaron 28,08 g de restos del exoesqueleto de langostinos australes (Pleoticus muelleri) propios de aguas del Atlántico suroeste. El material contenía restos de carne y los pleópodos de la estructura.
Se sometieron a los siguientes procesos:
• Lavado, secado, triturado y tamizado: los restos se lavaron con agua caliente y detergente con el fin de eliminar todos los restos. Posteriormente se secaron en una estufa a 50ºC durante 48 horas. Los restos secos y limpios se molieron en un molinillo de aspas (molinillo de café de la marca Taurus©) y se tamizaron en un tamiz de 0,1 mm de luz.
• Despigmentado: Para despigmentar los caparazones molidos se utilizó acetona Panreac© 1/6 p/v. Para eliminar los pigmentos β-carotenos.
360
31º
Valorización de los residuos de marisco. Síntesis de nanopartículas de quitosano con efecto antimicrobiano.
• Desmineralizado: Para desmineralizar el material se utilizó HCl 2M. Para eliminar el CaCO3 presente en el exoesqueleto del langostino.
• Desproteinizado: Para desproteinizar el material se utilizó una disolución de NaOH 2M.
4.1.
Ya que el quitosano es la quitina con un grado de desacetilación mayor al 50% se procedió a desacetilar la quitina con una disolución de NaOH 50% p/v.
El material obtenido en forma de pequeñas escamas se molió en un mortero de porcelana para homogeneizarlo.
En un primer intento no se logró desacetilar lo suficiente, por lo que se repitió este paso una segunda vez.
4.1.1.
El grado de acetilación del quitosano que obtuvimos se determinó por espectroscopía RMN siguiendo el método de Fernández-Megia et al. (2005).
Se añadieron 5 mg de quitosano en un tubo de RMN de 5 mm que contenía 0,5 ml de disolución al 2% DCL/D2O (v/v) y se calentó a 70ºC durante una hora. La determinación se realizó con un espectrómetro de 500 MHz.
Este procedimiento se llevó a cabo en el CQUS (Centro Singular de Investigación en Química Biolóxica e Materiais Moleculares) de Santiago de Compostela.
4.2. OBTENCIÓN DE NANOPARTÍCULAS DE QUITOSANO
Para la obtención de nanopartículas de quitosano utilizamos el método de gelación ionotrópica con el tripolifosfatopentabásico (TPP) propuesto por Calvo et al. (2007).
Se ensayaron diferente proporciones de quitosano y TPP para determinar la más adecuada. Las proporciones fueron las siguientes:
• Una proporción de quitosano/ TPP de 5/0,5 (peso/peso)
• Una proporción de quitosano/ TPP de 5/1 (p/p)
• Una proporción de quitosano/ TPP de 5/2 (p/p)
• Una proporción de quitosano/ TPP de 5/4 (p/p)
El procedimiento de preparación de las nanopartículas fue el siguiente:
361
OBTENCIÓN DE QUITOSANO POR DESACETILACIÓN DE LA QUITINA
CARACTERIZACIÓN DEL QUITOSANO OBTENIDO: GRADO DE ACETILACIÓN
31º CERTAMEN JÓVENES INVESTIGADORES / Tecnologías e Ingenierías
En un tubo de vidrio con tapa se añadió 1 ml de disolución de quitosano y se agregaron 9 ml de agua desionizada, se calentó hasta 60°C en un baño de agua y se mantuvo durante 15 minutos a 60ºC y agitación a 500 rpm.
A los 15 minutos se retira el tubo y se lleva a un baño de hielo. Cuando se enfría la disolución, todavía en el baño de hielo se añaden 0,5/1/2/4 ml de disolución de TPP respectivamente.
Se mantiene la mezcla en agitación a 500 rpm durante 30 minutos.
4.2.1. CARACTERIZACIÓN DE LAS NANOPARTÍCULAS DE QUITOSANO
Se midió el tamaño hidrodinámico de las nanopartículas obtenidas, utilizando la técnica DLS, (Dynamic Light Scattering), dispersión de luz dinámica, con un MALVERN NANO-ZS. Un método que se emplea para la caracterización del tamaño de partículas proteicas, polímeros etc.
La técnica se basa en la dispersión de la luz causada por las partículas o moléculas que se encuentran en suspensión en un líquido. Esas partículas o moléculas están en movimiento, el movimiento Browniano, y este provoca que la luz láser incidente se disperse con diferentes intensidades. Según la intensidad de la fluctuación se deduce la velocidad del movimiento Browniano y de este dato se obtiene el tamaño de las partículas.
Este procedimiento también se realizó en el CQUS de Santiago de Compostela.
4.3. DETERMINACIÓN DE LA ACTIVIDAD ANTIMICROBIANA DEL QUITOSANO.
4.3.1. Determinación de la actividad antimicrobiana por el método de difusión en agar.
La actividad antimicrobiana se determinará usando cepas no patogenas de una bacteria grampositiva, una gramnegativa y una levadura. S.aureus E.coli y C. albicans respectivamente, facilitadas por el Dr. Llovo Taboada del CHUS.
4.3.1.1. Preparación de los céspedes de microorganismos.
Se utilizaron cultivos jóvenes para la preparación de los céspedes, esto se logró pasando los cultivos facilitados a un nuevo medio y dejando estos en una estufa a 34ºC.
Se prepararon inóculos de los tres microorganismos, suspendiendo muestras de los mismos en suero fisiológico en un pequeño tubo de ensayo. La concentración de cada inóculo se midió en un turbidímetro, con turbidez de 1,0 0,5 y 2,0 McFarland para E. coli, S. aureus y C. albicans, respectivamente.
362
Valorización de los residuos de marisco. Síntesis de nanopartículas de quitosano con efecto antimicrobiano.
Para la siembra se usó el método de estriado con isopo estéril. Las placas cerradas se pusieron a secar durante 30 minutos en la estufa a 34°C. Todo el trabajo se realizó tomando las medidas de asepsia adecuadas.
4.3.1.2. Realización de los antibiogramas
Se cargaron discos blancos para antibiogramas de 6 mm de diámetro con la disolución de quitosano en forma lineal y con la solución que contenía nanopartículas de quitosano mediante inmersión en las soluciones y se colocaron los discos sobre las placas sembradas. Se hicieron todas las pruebas por triplicado. Se utilizaron placas con medio Muller-Hinton de Oxoid®.
4.3.2. Determinación de la actividad antimicrobiana por el método de microdilución para determinar la mínima concentración inhibitoria del quitosano
Se probó la eficacia de los tres tipos de nanopartículas obtenidas y del quitosano lineal frente a los mismos tres microorganismos empleados con el método de difusión en agar.
El medio de cultivo utilizado fue Muller-Hinton broth en placas microtiter estériles de 96 pocillos, 8 filas y 12 columnas.
4.3.3. Observación microscópica del comportamiento de los microorganismos en presencia de quitosano
Se quiso observar el efecto inmediato del quitosano sobre los microorganismos.
Solo se probó la solución con las nanopartículas de de 110 nm y la solución de quitosano en forma de moléculas libres.
Para ello, en un portaobjetos se depositaron unas gotas de la solución con nanopartículas o con quitosano y con un asa de siembra se tomaron unas colonias de microorganismo y se dispersaron en las gotas, a continuación se colocó un cubreobjetos y se llevó la preparación a un microscopio de contraste de fases.
5. RESULTADOS Y ANÁLISIS
5.1. OBTENCIÓN DE QUITOSANO POR DESACETILACIÓN DE LA QUITINA
La cantidad de quitosano obtenido fue de 1,78 g. Como el peso de los residuos utilizados fue de 20,08 g , elrendimiento obtenido fue un 8,9%.
5.1.1. CARACTERIZACIÓN DEL QUITOSANO OBTENIDO: GRADO DE ACETILACIÓN
Se determinó que el grado de acetilación del quitosano obtenido fue del 6%, es decir se desacetiló un 94%.
363
31º CERTAMEN JÓVENES INVESTIGADORES / Tecnologías e Ingenierías
5.1.2. CARACTERIZACIÓN DE LAS NANOPARTÍCULAS DE QUITOSANO OBTENIDAS
En la Gráfica 1 del documento se observan los resultados obtenidos por DLS de los tamaños de las nanopartículas que obtuvimos.
Gráfica 01
Diámetro de las tres clases de nanopartículas obtenidas determinado por DLS.

110 nm
240 nm
440 nm
Las líneas azul roja y negra se corresponden con las proporciones quitosano/ TPP 5/2 5/0,5 y 5/1 respectivamente. Las más adecuadas son las de la proporción 5/2 por poseer un menor diámetro. La cuarta proporción, 5/4 no aparece dado a que precipitó instantáneamente, descartándose de inmediato.
5.2. ACTIVIDAD ANTIMICROBIANA DEL QUITOSANO EN FORMA LINEAL Y EN NANOPARTÍCULAS
5.2.1. POR EL MÉTODO DE DIFUSIÓN EN AGAR
Tabla 01
Medidas de los halos de inhibición (mm±1).
Con Quitosano lineal y nanopartículas
Los datos de las tablas son los diámetros medios de los halos obtenidos en las tres repeticiones. Se observa en las tablas que los halos de inhibición obtenidos tenían un diámetro pequeño, pero eran visualmente muy definidos. Los halos se obtuvieron con E. coli y con S. aureus pero en ningún
caso con C. albicans
En todos los casos los halos con S. aureus tenían un diámetro ligeramente superior a los halos con E. coli. En todos los casos los diámetros de los halos de inhibición son ligeramente más elevados con la solución de nanopartículas que con la del polímero lineal. Debido a la actividad tan baja demostrada se llevó a cabo una segunda prueba, por la posible dificultad del quitosano para difundir en medio sólido debido a su tamaño.
364
Microorganismo Quitosano lineal NP 110 nm NP 440 nm NP 240 nm E. coli 7 7 8 8 S. aureus 8 9 10 9 C. albicans Sin halo Sin halo Sin halo Sin halo
Valorización de los residuos de marisco. Síntesis de nanopartículas de quitosano con efecto antimicrobiano.
5.2.2. Por el método de microdilución
Después de 48 horas de incubación se observaron las placas microtiter bajo la lupa. Se pudo comprobar que todos los microorganismos ensayados crecieron bien en el medio de cultivo empleado, el Muller-Hinton. En todos los pocillos con soluciones de nanopartículas y del quitosano libre sin dilución no creció ningún microorganismo, demostrando el efecto inhibitorio del quitosano.
En los pocillos con la dilución 1/ 2 de nanopartículas o quitosano libre y medio de cultivo si que crecieron microorganismos, excepto en el caso de S. aureus con nanopartículas de 240 nm, y C. albicans con nanopartículas de 440 nm.
Se puede afirmar que las nanopartículas de quitosano y el quitosano libre tienen efecto antimicrobiano, pero muy débil en las concentraciones trabajadas. Junto con los datos obtenidos por el método de difusión en agar, se puede afirmar que el quitosano tiene efecto inhibitorio, siendo esto comprobable de mejor manera en este último método.
5.2.3. OBSERVACIÓN MICROSCÓPICA DEL COMPORTAMIENTO DE LOS MICROORGANISMOS FRENTE AL QUITOSANO
Al observar las preparaciones al microscopio vimos que la bacteria E. coli es la que más se aglutina de los tres microorganismos, tanto con las nanopartículas como con el quitosano lineal sin diferenciarse una preparación de otra.
Las células de S. aureus, también se aglutinaron de una forma muy importante con las nanopartículas, quedando entre los agregados muy pocas bacterias libres. Muy parecida a los resultados obtenidos con E.coli. Sin embargo con el polímero lineal se observan agregados de menor tamaño y muchas bacterias libres entre los mismos.
En donde observamos menos efecto es en las preparaciones con C. albicans, con el polímero lineal apenas vemos aglutinación celular, y con las partículas de quitosano observamos agregación celular pero mucho menor que en E. coli y S. aureus, en presencia de las nanopartículas.
6. CONCLUSIONES
Se logró extraer quitina y quitosano a partir de restos de exoesqueleto de langostino austral, con un rendimiento del 8,9% y una acetilación del 6%.
Se sintetizaron nanopartículas de quitosano por el método de gelación ionotrópica.
De las cuatro proporciones probadas entre quitosano y TPP la proporción 5/2 en peso es la más recomendable por el menor diámetro de las nanopartículas obtenidas que fue de 110 nm.
365
31º CERTAMEN JÓVENES INVESTIGADORES / Tecnologías e Ingenierías
Con las proporciones 5/0,5 y 5/1 los diámetros de las nanopartículas fueron 240 nm y 440 nm, respectivamente. Con la proporción 5/4 no se obtuvieron nanopartículas.
Las nanopartículas de 110 nm provocaron una fuerte aglutinación de las bacterias E. coli y S. aureus y solo muy ligera en C. albicans. El polímero libre aglutinó también muy severamente a E. coli, más ligeramente a S. aureus y no provocó aglutinación de C. albicans.
Se observó un efecto inhibitorio, pero débil, de todas las soluciones de nanopartículas, las de 110 nm, de 240 nm y de 440 nm, y de la solución de quitosano libre sobre los tres microorganismos probados E. coli, S. aureus y C. albicans
Por lo tanto se puede afirmar que las nanopartículas sintetizadas a partir de quitosano obtenido de restos del exoesqueleto de langostino austral tienen actividad antimicrobiana.
7. BIBLIOGRAFÍA
Agnihotri, S. A., Mallikarjuna, N. N., & Aminabhavi, T. M. (2004). Recent advances on chitosan-based micro-and nanoparticles in drug delivery. Journal of controlled release, 100(1), 5-28.
Ahmed, T. A., & Aljaeid, B. M. (2016). Preparation, characterization, and potential application of chitosan,chitosan derivatives, and chitosan metal nanoparticles in pharmaceutical drug delivery. Drug design,development and therapy, 10, 483.
Anthonsen, M. W., & Smidsrød, O. (1995). Hydrogen ion titration of chitosans with varying degrees of N-acetylation by monitoring induced 1H-NMR chemical shifts. Carbohydrate Polymers, 26(4), 303-305.
Azad, A. K., Sermsintham, N., Chandrkrachang, S., & Stevens, W. F. (2004). Chitosan membrane as awound-healing dressing: Characterization and clinical application. Journal of Biomedical Materials Research Part B: Applied Biomaterials: An Official Journal of The Society for Biomaterials, The Japanese Society for Biomaterials, and The Australian Society for Biomaterials and the Korean Society for Biomaterials, 69(2), 216-222.
BENHABILES, M., SALAH, R., LOUNICI, H., DROUICHE, N., GOOSEN, M., & MAMERI, N. (2012)Antibacterial activity of chitin, chitosan and its oligomers prepared from shrimp Shell waste. Food Hydrocolloids. 48 – 56.
366
Valorización de los residuos de marisco. Síntesis de nanopartículas de quitosano con efecto antimicrobiano.
Boateng, J. S., Matthews, K. H., Stevens, H. N., & Eccleston, G. M. (2008). Wound healing dressings and drug delivery systems: a review. Journal of pharmaceutical sciences, 97(8), 2892-2923.
Calvo, P., Remuñan-López C., Vila-Jato JL., & Alonso M. J. (1997) Chitosan and chitosan/ethylene oxide-propylene oxide block copolymer nanoparticles as novel carriers for proteins and vaccines. PharmRes, 14(10), 1431-1436.
Chua, B. Y., Al Kobaisi, M., Zeng, W., Mainwaring, D., & Jackson, D. C. (2011). Chitosan microparticles and nanoparticles as biocompatible delivery vehicles for peptide and protein-based immunocontraceptive vaccines. Molecular pharmaceutics, 9(1), 81-90.
Csaba, N., Garcia-Fuentes, M., & Alonso, M. J. (2009). Nanoparticles for nasal vaccination. Advanced drug delivery reviews, 61(2), 140-157.
Csaba, N., Garcia-Fuentes, M., & Alonso, M. J. (2006). The performance of nanocarriers for transmucosal drug delivery. Expert opinion on drug delivery, 3(4), 463-478.
De La Fuente, M., Csaba, N., Garcia-Fuentes, M., & Alonso, M. J. (2008). Nanoparticles as protein and gene carriers to mucosal surfaces.
De la Fuente, M., Raviña, M., Paolicelli, P., Sanchez, A., Seijo, B., & Alonso, M. J. (2010). Chitosanbased nanostructures: a delivery platform for ocular therapeutics. Advanced drug delivery reviews, 62(1), 100-117.
Dutta, P. K., Dutta, J., & Tripathi, V. S. (2004). Chitin and chitosan: Chemistry, properties and applications. J. Sci. Ind. Res. India 63, 20-23.
Felt, O., Buri, P., & Gurny, R. (1998). Chitosan: a unique polysaccharide for drug delivery. Drug development and industrial pharmacy, 24(11), 979-993.
Fernandez-Megia, E., Novoa-Carballal, R., Quiñoá, E., & Riguera, R. (2005). Optimal routine conditions for the determination of the degree of acetylation of chitosan by 1H-NMR. Carbohydrate Polymers, 61(2), 155- 161.
Garcia-Fuentes, M., & Alonso, M. J. (2012). Chitosan-based drug nanocarriers: where do we stand?. Journal of Controlled Release, 161(2), 496-504.
Hajipour, M. J., Fromm, K. M., Ashkarran, A. A., de Aberasturi, D. J., de Larramendi, I. R., Rojo, T., ... & Mahmoudi, M. (2012). Antibacterial properties of nanoparticles. Trends in biotechnology, 30(10), 499511.
Janes, K. A., & Alonso, M. J. (2003). Depolymerized chitosan nanoparticles for protein delivery: preparation and characterization. Journal of applied polymer science, 88(12), 2769-2776.
Jonassen, H., Kjøniksen, A. L., & Hiorth, M. (2012). Stability of chitosan nanoparticles cross-linked with tripolyphosphate. Biomacromolecules, 13(11), 3747-3756.
367
CERTAMEN JÓVENES INVESTIGADORES / Tecnologías e Ingenierías
Kong, M., Chen, X. G., Xing, K., & Park, H. J. (2010). Antimicrobial properties of chitosan and mode of action: a state of the art review. International journal of food microbiology, 144(1), 51-63.
Kumar, M. R., Muzzarelli, R., Muzzarelli, C., Sashiwa, H., & Domb, A. J. (2004). Chitosan chemistry and pharmaceutical perspectives. Chemical reviews, 104(12), 6017-6084.
Leong, K. W., Mao, H. Q., Truong-Le, V. L., Roy, K., Walsh, S. M., & August, J. T. (1998). DNApolycation nanospheres as non-viral gene delivery vehicles. Journal of controlled release, 53(1-3), 183193.
Lu, B., Wang, C. F., Wu, D. Q., Li, C., Zhang, X. Z., & Zhuo, R. X. (2009). Chitosan based oligoamine polymers: Synthesis, characterization, and gene delivery. Journal of Controlled Release, 137(1), 54-62.
NO, et al.(1995) Preparation and characterization of chitin and chitosan: a review. Journal of Aquatic Food Product Technology, 4, 27 – 52.
No, H. K., Park, N. Y., Lee, S. H., & Meyers, S. P. (2002). Antibacterial activity of chitosans and chitosan oligomers with different molecular weights. International journal of food microbiology, 74(1-2), 65-72.
Qi, L., Xu, Z., Jiang, X., Hu, C., & Zou, X. (2004). Preparation and antibacterial activity of chitosan nanoparticles. Carbohydrate research, 339(16), 26932700.
Rabea, E. I., Badawy, M. E., Rogge, T. M., Stevens, C. V., Höfte, M., Steurbaut, W., & Smagghe, G. (2005).
Insecticidal and fungicidal activity of new synthesized chitosan derivatives. Pest Management Science, 61(10), 951-960.
Sarmento, B., Martins, S., Ferreira, D., & Souto, E. B. (2007). Oral insulin delivery by means of solid lipid nanoparticles. International journal of nanomedicine, 2(4), 743.
Sugano, M., Watanabe, S., Kishi, A., Izume, M., & Ohtakara, A. (1988). Hypocholesterolemic action of chitosans with different viscosity in rats. Lipids, 23(3), 187-191.
Tapola, N. S., Lyyra, M. L., Kolehmainen, R. M., Sarkkinen, E. S., & Schauss, A. G. (2008). Safety aspects and cholesterol-lowering efficacy of chitosan tablets. Journal of the American College of Nutrition, 27(1), 22-30.
Tsai, M. L., Chen, R. H., Bai, S. W., & Chen, W. Y. (2011). The storage stability of chitosan/tripolyphosphate nanoparticles in a phosphate buffer. Carbohydrate Polymers, 84(2), 756-761.
Vila, A., Sanchez, A., Tobıo, M., Calvo, P., & Alonso, M. J. (2002). Design of biodegradable particles for protein delivery. Journal of Controlled Release, 78(1-3), 15-24.
31º
368
Baby Safety: Desarrollo de sistemas para la prevención de la muerte súbita del lactante
/ TERCER PREMIO
AUTORA | IRIA OLLERO CADILLA
COORDINADOR | DAVID BALLESTEROS ÁLVAREZ
CENTRO | IES AS LAGOAS
CIUDAD | SAN CIBRAO DAS VIÑAS-OURENSE
RESUMEN |
La muerte súbita consiste en la muerte repentina del bebé sin una causa aparente. En la actualidad se desconocen sus causas exactas pero sí se sabe cómo prevenirla. Por lo que partiendo de las medidas preventivas como son la posición del bebé mientras duerme, la temperatura y el pulso, se han desarrollado cuatro dispositivos de bajo coste que permiten la monitorización del bebé en la cuna y de esta manera prevenir el síndrome de la muerte súbita del lactante considerada una de las principales causas de muerte en los bebés menores de un año. Dos de los sistemas nos permiten el control de su posición en la cuna, un tercero el control simultáneo de la temperatura de la habitación y del bebé y un cuarto sistema nos permitiría llevar un control de sus pulsaciones mientras duerme. Finalmente se difundieron encuestas entre 111 adultos y a 4 guarderías para conocer el interés acerca de los sistemas, preocupaciones y otras cuestiones.
Palabras clave: Muerte súbita, prevención, bebé, sistemas, Arduino, Processing y cuna.
TECNOLOGÍAS E INGENIERÍAS 370
ABSTRACT |
Sudden death is the sudden death of the baby without apparent cause. Today, its exact causes are unknown but it is known how to prevent it. So starting from preventive measures such as the position of the baby while sleeping, temperature and pulse, four low-cost devices have been developed that allow themonitoring of the baby in the crib and thus prevent the syndrome of death Sudden infant is considered one of the leading causes of death in babies under one year. Two of the systems allow us to control their position in the crib, a third the simultaneous control of the temperature of the room and the baby and a fourth system would allow us to keep track of their pulsations while sleeping. Finally, surveys were disseminated among 111 adults and 4 nurseries to learn about systems, concerns and other issues.
Keywords: Sudden death, prevention, baby, systems, Arduino, Processing and crib.
371
31º CERTAMEN JÓVENES INVESTIGADORES / Tecnologías e Ingenierías
1. INTRODUCCIÓN
La muerte súbita es la causa principal de muerte inexplicable en bebés entre 1 mes y 1 año de edad (postnatal). Este síndrome que afecta con más frecuencia a bebés de entre 1 y 4 meses de edad y el 85% de los casos, a bebés menores de 6 meses. Este ocurre con frecuencia mientras los bebés duermen, normalmente entre las 10 de la noche y las 10 de la mañana. Los principales factores a los que está ligado (aunque no se conocen con total precisión los desencadenantes) son problemas en el área cerebral que controla la respiración, arritmias, sobrecalentamiento o sofocación accidental.
Para la realización del proyecto se parte de las causas y de cómo se pueden evitar, para posteriormente diseñar 4 sistemas que permitan monitorizar el bebé mientras duerme y de esta forma poder reducir el riesgo de padecer este síndrome que se puede considerar uno de los más devastadores para las familias debido a que ocurre inesperadamente.
El motivo por el cual empecé a desarrollar este proyecto fue porque cada vez que leía una noticia relacionada con el tema quedaba muy impresionada y me preguntaba: ¿por qué no existirán tecnologías de monitorización del bebé en la cuna que sean mínimamente invasivas? Con la finalidad de responder a esta pregunta desarrollé los 4 sistemas para poder contribuir a reducir el números de casos del SMSL y de esta manera realizar mi pequeña aportación a la solución de este grave problema.
2. ANTECEDENTES
El síndrome de la muerte súbita del lactante (SMSL) también conocido como muerte súbita infantil, se define como el fallecimiento repentino e inesperado de un niño/a de menos de un año de edad aparentemente sano/a que ocurre durante el sueño y que permanece sin explicación después de una rigurosa investigación postmorten (esta incluye la práctica de la autopsia, examen del lugar del fallecimiento y revisión de la historia clínica)
2.1. CAUSAS
• Las causas de la muerte súbita infantil no se tienen claras, se desconocen. En la actualidad muchos médicos, investigadores y expertos creen que existen diversos factores implicados. Los más citados en la literatura científica son:
• La capacidad poco desarrollada del bebés para despertarse, así como la incapacidad de su cuerpo para detectar la excesiva acumulación de dióxido de carbono en la sangre. Por lo tanto el SMSL, podría originarse por un fallo en el microdespertar ante un episodio de apnea que se prolonga en el tiempo, bradicardia o hipotensión, arritmias o situaciones externas que pueden llegar a la asfixia. Por lo tanto no hay respuesta a un estímulo de amenaza a al vida durante el sueño.
372
Baby Safety: Desarrollo de sistemas para la prevención de la muerte súbita del lactante
• Recientemente, investigadores del Hospital de Niños de Weastmead de Sidney (Australia), después de estudiar muchos casos de muerte súbita infantil, descubrieron una coincidencia, estos bebés, presentaban en su cuerpo un 21% menos de orexina que los que habían muerto por causas conocidas. La orexina es una proteína que está presente en la zona de hipotálamo y cuya función es despertar al bebé cuando no le está llegando suficiente oxígeno y la regulación del sueño.
Hay investigadores que lo asocian con una anomalía de los mecanismos del sistema nervioso que controlan el corazón y la respiración.
2.2. ACTIVIDADES PREVENTIVAS
A pesar de que no se conocen las causas exactas que desencadenan la muerte súbita infantil, se ha visto que la puesta en marcha de una serie de medidas preventivas ha reducido en gran medida el número de casos de muerte súbita infantil, entre ellas destacan:
• Acostar al bebé boca arriba en la cuna
• Colchón firme y plano
• Dormir en la misma habitación del bebé
• Control de la temperatura (ambiente del dormitorio)
• No fumar ni consumir alcohol durante el embarazo
• Amamantar si es posible al bebé
• Uso del chupete al dormir
3. HIPÓTESIS DE TRABAJO Y OBJETIVOS DE INVESTIGACIÓN
3.1. HIPÓTESIS
El proyecto parte de una hipótesis de trabajo:
“Se pueden reducir los casos de muerte súbita en los bebés mediante el desarrollo de sistemas que nos permiten su monitorización mientras duermen.”
3.2. OBJETIVOS DE LA INVESTIGACIÓN
Los objetivos perseguidos durante la investigación fueron:
1. Diseñar un conjunto de sistemas de control integrables en la cuna
2. Reducir la probabilidad de que los bebés padezcan la muerte súbita del lactante gracias a su seguimiento mientras duermen.
373
31º CERTAMEN JÓVENES INVESTIGADORES / Tecnologías e Ingenierías
4. MATERIALES Y MÉTODOS
4.1. MATERIALES
10 sensores de presión, 2 Arduino Mega, 2 Arduino UNO, soldador y estaño, 4 placas VeroBoard, cables, NodeMCU, pulse sensor, PS3 Sony Eye, fuente de luz IR, negativo de fotografía, Adafruit AMG8833, pantalla LCD, 2 buzzer, ordenador, impresora 3D, filamento PLA y 4 módulos NRF24L01

4.2. METODOLOGÍA
4.2.1. BÚSQUEDA BIBLIOGRÁFICA Y ANÁLISIS DE PROYECTOS DEL ÁMBITO.
El proyecto comienza con una búsqueda de información acerca de la muerte súbita del lactante, sus causas y medidas preventivas. Finalmente se decide tomar las causas como base para el desarrollo del proyecto debido al desconocimiento de las causas exactas del SMSL. Posteriormente también se analizaron diferentes sistemas existentes para la monitorización de la salud del bebé, para de esta manera poder diseñar algo que fuese innovador y diferente a lo existente con la motivación principal de reducir el número de casos de muerte súbita del lactante.
4.2.2. DESARROLLO DE SISTEMAS
Una vez conocida la información necesaria sobre el SMSL, se comienzan a diseñar cuatro sistemas que permiten la monitorización del bebé en la cuna para de esta manera controlar al bebé mientras duerme y prevenir dicho síndrome. De forma cronológica, se siguió el siguiente orden a la hora de la fabricación de los sistemas:
4.2.2.1. Sistema de detección de giros por presión
El primer sistema permite mantener controlada la posición del bebé en la cuna asegurando de esta forma que el bebé no se haya girado. La postura recomendada actualmente por los médicos para dormir es boca arriba. Al controlar la
374
Figura 01
Montaje de los sensores sobre el colchón.
Baby Safety: Desarrollo de sistemas para la prevención de la muerte súbita del lactante
posición en la cuna descartamos una de las posibles causas de padecer este síndrome que es dormir boca abajo y que el bebé inhale el mismo aire que exhala.
Este sistema consiste en un cubre colchón que tiene incorporados 10 sensores de presión que detectan cualquier giro del bebé. Para ello partimos de esos 10 sensores que están colocados en 2 filas de 5 sensores cada una a ambos lados del lactante.
Los 10 sensores de presión están conectados a un Arduino Mega, este ha sido programado en lenguaje Arduino de manera que emita un aviso al sobrepasar un determinado valor de presión (variable según el peso del bebé) en una de las dos filas de sensores. Si se supera el valor establecido sonará una alarma procedente del buzzer, este está conectado en un segundo Arduino al cual se le envía la información mediante un módulo de conexión radio.

Una vez completo el sistema, con todo programado y con las piezas diseñadas e impresas se pasó al montaje sobre el cubre colchón. Para usarlo, se coloca al bebé boca arriba en el medio de las dos filas de sensores de presión. Estos sensores detectan si el bebé se gira durante la noche. Al girarse ejercería una cierta presión sobre los sensores y esto daría lugar a la activación de la señal sonora por parte del buzzer que se sería el que avisaría a los padres de que el bebé de ha girado.
4.2.2.2. Sistema de reconocimiento facial
El segundo sistema es complementario al anterior. Consiste en una cámara que va colocada en el lateral de la cuna. Esta nos permite controlar, de manera automática, la posición del bebé mientras duerme y nos avisa cuando su posición no sea la correcta.
Para la obtención de la cámara se partió de una PS3 Sony Eye que se desmontó con la finalidad de convertirla en una cámara IR. Cambiando su filtro por negativo de fotografía.
375
Figura 02 Cámara IR usada.
CERTAMEN JÓVENES INVESTIGADORES / Tecnologías e Ingenierías
La cámara fue programada mediante processing y OpenCV para que detectara caras. A partir del algoritmo de OpenCV que permite la identificación de caras, se fue elaborando un código que nos avisa cuando el bebé no está boca arriba, que es cuando no le detectaría la cara, posición favorable a sufrir el SMSL, el ordenador emitiría un sonido que avisaría a los padres de que la posición del bebé no es la recomendada.
Para finalizar este segundo sistema, se diseñó mediante Tinkercad una pieza para el soporte de la cámara en la cuna, para que fuese más cómoda su colocación, el agarre consta de imanes siendo más fácil así su encaje en cualquier cuna.
4.2.2.3. Control térmico del espacio y del lactante
El tercer sistema consiste en una cámara térmica hecha a partir de un sensor térmico y una pantalla LCD. Este sistema marca la temperatura aproximada de la habitación y del bebé. Gracias a la incorporación de la pantalla, podemos saber en qué parte del bebé se concentra más calor y si tuviese una temperatura elevada por un abrigo excesivo podríamos saber qué prendas de ropa tendríamos que quitarle para disminuirla. De esta manera, disminuimos el riesgo de que padezca un exceso de temperatura corporal y por lo tanto disminuimos el riesgo de padecer la muerte súbita del lactante. Ya que la temperatura es uno de los factores que recogen los libros y defienden los médicos a controlar para prevenir dicho síndrome.
Para el desarrollo de este sistema, partimos de un sensor Adafruit AMG8833 y de una pantalla LCD. Ambos están conectados a un Arduino Mega. Para facilitar el montaje de este sistema utilizamos dos placas VeroBoard de manera que cada uno de los componentes está soldado a una placa y conectado a sus respectivos pines en el Arduino.
Este sistema al superar una determinada temperatura, que son los 26ºC en el ambiente (temperatura superior a la recomendada debido a que al estar cerca del bebé la temperatura se eleva) y cuando es inferior a los 18ºC emitiría una señal sonora procedente del buzzer. Esta alarma, al igual que en el primer

376
31º
Figura 03
Sistema de la cámara térmica.
Baby Safety: Desarrollo de sistemas para la prevención de la muerte súbita del lactante

sistema, sonará en el Arduino central (receptor) al cual se conecta inalámbricamente el Arduino del sistema (emisor) mediante señal de radio, gracias a la incorporación del módulo NRF24L01 en ambos Arduinos.
En caso de que saltara la alarma, los padres podrían observar en la pantalla LCD como está la temperatura del bebé y de esta forma tomar medidas preventivas necesarias.

4.2.2.4. Monitorización del pulso del lactante
El cuarto sistema es un body que tiene incorporado un sensor de pulso, permitiéndonos así mantener controlado el pulso del bebé de manera continuada durante toda la noche y avisar en caso de cualquier arritmia.
Este sistema consta de un sensor de pulso que está conectado a un NodeMCU lolin que es una placa compatible con Arduino y que nos permite conectarlo a una red Wifi, de esta manera podemos acceder a los datos desde un dispositivo móvil. A él también se le conectó un portapilas de botón que se usa como fuente de alimentación.
Se decidió colocar el sensor de pulso en la zona de la axila, midiendo así el pulso axilar por ser el sitio más cómodo para el bebé debido a que no le impedía los movimientos y por ser el sitio más fácil para fijar el sensor y obtener así datos fiables.
Este sistema fue diseñado para que la señal de aviso fuese una notificación en el móvil de la madre/padre o tutor. Para ello se hace uso del programa Blynk que nos permite conectar el NodeMCU con un dispositivo móvil y poder recibir así una notificación que va acompañada de un sonido en caso de una alteración en el pulso cardíaco.
377
Figuras 04 y 05
Body con la electrónica escondida (izda.) y electrónica del body (dcha.)
Ante estas situaciones de arritmias habría que tomar decisiones, si el bebé las sufre de manera frecuente lo recomendable sería ir al médico porque son señal de peligro en muchos de los casos.
4.2.3. ELABORACIÓN DE LAS ENCUESTAS
Para completar el proyecto se realizaron unas encuestas para conocer el interés de las personas y guarderías en los sistemas y saber si los parámetros que se controlan son en los que está interesada la mayoría.
Se desarrollaron dos tipos de encuestas en drive. La primera de ellas -encuesta para adultos- constaba de 15 preguntas que se difundió por redes sociales tales como Facebook y Twitter y vía Whatsapp. Fue cubierta por un total de 111 personas, todas de ellas mayores de edad.
La segunda de las encuestas era para que cubrieran las guarderías. Finalmente se consiguió contactar con 4 guarderías de diferentes ciudades: Pontevedra, Zamora, Palencia y Segovia para conocer su interés en los respectivos sistemas y sus necesidades.
5. RESULTADOS
5.1. ANÁLISIS DE LOS SISTEMAS
El trabajo conjunto de los dos primeros sistemas es efectivo puesto que en las pruebas realizadas ambos sistemas les saltaba la alarma cuando el bebé se giraba manteniendo de esta forma controlada su posición. Evitamos así uno de los riesgos de padecer la muerte súbita del lactante que es que el bebé duerma boca abajo o de lado debido a que podría girarse fácilmente. Además como este sistema es fácilmente extraíble del cubre colchón no habría problema a la hora de echarlo a lavar.
Con el tercer sistema los resultados obtenidos también fueron muy satisfactorios porque permitía el control de la temperatura aproximada del bebé y de la habitación. Manteniendo de esta forma un sistema habitación-bebé cuya temperatura oscila entre los 26ºC y los 18ºC, la temperatura máxima está definida como superior a la recomendada en un habitación porque al estar la cámara térmica cerca del bebé la temperatura aumenta. Con este sistema una vez que saltaba la alarma por temperatura alta se podía ver en que parte del bebé había más calor y de esta forma quitarle prendas de ropa para que la temperatura bajase. Por lo tanto con este sistema descartamos otro factor de riesgo que es la temperatura alta tanto del bebé como de la habitación evitando así un sobrecalentamiento.
Con el último sistema se pudo comprobar como medía el pulso de manera continuada. Además se pudo ver que no resultaba molesto al bebé debido
31º CERTAMEN
378
JÓVENES INVESTIGADORES / Tecnologías e Ingenierías
a que no mostraba molestia alguna ni lloraba al ponérselo, lo cual significa que se cumplen los dos objetivos propuestos al desarrollar este sistema que eran que fuera cómodo y que midiera el pulso del bebé mientras dormía. Descartamos con este sistema otro de los posibles riesgos de padecer el SMSL que son las arritmias, debido a que nos avisaría y de esta manera podríamos tomar las medidas necesarias. Si el pulso fuera muy alto podría ser señal de que el bebé tiene fiebre debido a que por grado de fiebre el pulso puede llegar a aumentar en ocho pulsaciones por minuto. Este sistema fue diseñado también pensando en que fuera fácil lavarlo porque es muy habitual que los bebés vomiten, para ello los sensores se colocaron pensando en que fueran fácilmente extraíbles.
ANÁLISIS DE LOS RESULTADOS DE LAS ENCUESTAS
Una vez cubiertas las encuestas se pasó al análisis de estas. Se consiguieron un total de 111 respuestas, habiendo un 32,4% de respuestas masculinas y un 67,6% femeninas, de estos 111 un 81,5% eran padres siendo el intervalo de 31 – 35 años el más frecuentado con un 53,3% seguido por el de 36 – 40 años con un 33,3%, cabiendo la posibilidad de que algunos padres hubiesen marcado diferentes rango de edades porque tuvieron varios hijos/as sumando de esta manera un porcentaje de 137,6%.
Cuando se les pregunta qué es lo que más les preocupa cuando son bebés, pudiendo marcar un máximo de 3 respuestas, destacan las enfermedades que puedan padecer sus hijos (74,1%) así como el que puedan padecer la muerte súbita infantil (52,8%).
Si nos preguntamos cómo dormían los padres cuando sus hijos eran bebés, un 52% dicen de haber dormido tranquilos mientras que un 48% intranquilos, dentro de este porcentaje nos dicen que lo que les preocupaba era: “la muerte súbita”, “el bienestar del bebé”, “no atender cuando lo necesite”, “las necesidades del bebé durante la noche (lactancia, sueño, frío, enfermedad etc.)”, “que esté bien durante la noche”, “que se ahogara, que se quedara sin respiración. Era algo que me obsesionaba” pudiendo ver como muchas de estas preocupaciones estarían cubiertas con los cuatro sistemas explicados.
Si se les pregunta qué parámetros les gustaría tener controlados podemos ver que los más frecuentes son la posición del bebé en la cuna, la temperatura del bebé y que 36 personas se muestran interesados con todos los parámetros expuestos (temperatura de la habitación y del bebé, posición del bebé en la cuna, el pulso del el seguimiento del bebé de manera visual).
Para finalizar se les preguntó si estarían interesados en estos sistemas que les permiten prevenir la muerte súbita infantil así como la monitorización del bebé mientras duerme, un 88% dice de estar interesado y un 12% no.
379
Baby Safety: Desarrollo de sistemas para la prevención de la muerte súbita del lactante
31º CERTAMEN JÓVENES INVESTIGADORES / Tecnologías e Ingenierías
Cuando se les pregunta cuánto pagarían por estos sistemas podemos ver que un 24,1% pagaría menos de 60€, un 32,4% entre 60 – 120€, un 23,1% entre un 120 – 180€ y un 20,4% más de 180€.
Al analizar si las personas a las cuales les preocupa/preocupaba que su bebé pudiese padecer el SMSL les interesarían sistemas que sirvieran para prevenir y avisar ante determinados riesgos, podemos ver que un 89% se muestra estar interesado en los sistemas.
Para poder comprobar el interés del sistema también se contactó con 4 guarderías, de 4 ciudades distintas, Pontevedra, Zamora, Palencia y Segovia. Estas guarderías acogen niños de entre los 3 – 5 meses hasta los 3 años. En las 4 guarderías los bebés suelen dormir la siesta, siendo acostados en todas ellas menos en una de lado. Además afirman de conocer los riesgos de padecer el SMSL. Las 4 guarderías estarían interesados en estos 4 sistemas, 3 de ellas pagarían entre 60 – 120€ y una de ellas menos de 60€.
6. CONCLUSIONES
Se cumple la hipótesis inicial ya que se ha conseguido diseñar distintos dispositivos que permiten la monitorización del bebé en la cuna, controlando una serie de parámetros recomendados por lo médicos para de esta forma reducir el riesgo de padecer la muerte súbita infantil.
Este sistema podría ser utilizado por cualquier familia con bebés menores de un año, que es cuando hay mayor riesgo de padecer este síndrome, para de esta forma poder dormir más tranquilos sabiendo que cualquier situación que aumente el riesgo de padecer el SMSL será notificada con una alarma sonora.
Por lo tanto, con este proyecto se puede reducir la probabilidad de que un bebé padezca la muerte súbita del lactante.
7. AGRADECIMIENTOS
Para la realización de este proyecto fue imprescindible la presencia de mi tutor de proyecto, David Ballesteros, que sin él, este proyecto no hubiese sido posible y a quien le agradezco su apoyo constante y su ayuda en los aspectos más difíciles. También agradezco a las aulas Tecnópole en el Parque Tecnológico de Galicia que es donde he llevado a cabo el proyecto y que sin la existencia de esta actividad, este trabajo no se hubiera realizado.
Por último quiero agradecer a mis padres y a mi hermana su ánimo, apoyo y ayuda constante a lo largo de todo el proyecto y que me han ayudado a superar los peores momentos en los que las cosas no salían.
380
Baby Safety: Desarrollo de sistemas para la prevención de la muerte súbita del lactante
8. BIBLIOGRAFÍA
Niño, G. (2017). Cómo prevenir la muerte súbita del lactante. Guiadelnino.com.
https://www.guiadelnino.com/bebe/cuidados-del-bebe/como-prevenir-la-muerte-subita-del-lactante [Consulta: 28 Septiembre 2017].
Ascalema.es. Síndrome de la Muerte Súbita del Lactante (SMSL)
http://www.ascalema.es/wp-content/uploads/2014/10/Grupo-de-Trabajo-de-AEP.-Muerte-Súbitadel-Lactante-SMSL.-Libro-Blanco.2003.pdf [Consulta: 10 Octubre 2017].
García García, F. Síndrome de muerte súbita del lactante. Scielo.sld.cu.
http://scielo.sld.cu/scielo.php?script=sci_arttext&pid=S0034-75312008000200009 [Consulta: 18 Octubre 2017].
Sids.org.ar. Colecho y síndrome de muerte súbita del lactante: una relación conflictiva. http://www.sids.org.ar/pdf/228.pdf [Consulta: 20 Diciembre 2017].
Previnfad.aepap.org. Prevención del síndrome de muerte súbita en el lactante | Previnfad.
http://previnfad.aepap.org/monografia/muerte-subita-lactante [Consulta: 2 Enero 2018].
Libro blanco de la muerte súbita. Aeped.es. 2018
http://www.aeped.es/sites/default/files/documentos/libro_blanco_muerte_subita_3ed_.pdf [Consulta: 20 marzo 2018].
381
12 Terrones y 4 cafés
/ TERCER PREMIO
AUTORA | LIDIA SOFÍA VICENTE GÓMEZ
COORDINADORA | JUANA MARÍA CARRIÓN SIMÓN
CENTRO | IES INFANTA ELENA
CIUDAD | JUMILLA-MURCIA
RESUMEN |
Este proyecto de investigación centra su interés en las bebidas energéticas, un producto cargado de polémica pero que, pese a esto, está experimentando un incremento enorme a todos los niveles sociales: desde deportistas de alto rendimiento hasta simples usuarios de gimnasios y, lo más alarmante, cada vez más jóvenes.
“12 terrones y 4 cafés” nace con el objetivo de conocer más acerca de ellas y sobre cómo afecta su consumo en el organismo humano, en concreto, en determinados aspectos fisiológicos como son el nivel de glucosa en sangre, el ritmo cardíaco y la tensión arterial.
Así mismo, pretende analizar el comportamiento de compra del consumidor joven frente a dichas bebidas. Estableciendo, con ello, los factores que afectan al consumidor adolescente. Por último, este trabajo trata de identificar el índice de ventas de estas bebidas en los comercios de Jumilla, ya sean supermercados, tiendas 24 horas o tiendas de proximidad. Resaltando que tan sólo fue posible obtener los datos de dos cadenas importantes de supermercados, no por ello despreciando las innumerables ventas del resto de establecimientos. Con todo esto, dicha investigación pretende informar a los consumidores actuales y/o venideros acerca de las bebidas energéticas en cuanto a los objetivos citados anteriormente.
TECNOLOGÍAS E INGENIERÍAS 382
ABSTRACT |
This research project is focus on Energy drinks. A product full of polemic that nevertheless, it is experiencing a huge increment involving all the social areas: including high performance athletes as well as simple gym users and, which is more disquieting, every time younger people.
“12 terrones y 4 cafés” was born with the aim of knowing more about them and also to know how their consume affect the human organism, specifically, in certain physiological effects such as the level of sugar in blood, heart beats and the blood pressure.
Besides, it pretends to analyse the purchasing behaviour of young consumers in the face of these type of drinks. So that, set up what factors affects teenagers ‘consumption. Finally, this work deal with identify the sale rates of these drinks on Jumilla´s business, including supermarkets, 24-hours stores or common shops. Underline that just two important supermarket chains bring us the rates, not ignoring with these, the countless sales of the rest of establishments. To sum up, this project pretends to inform people who have these drinks and the ones who will drink them in a future about Energy drinks regarding the objectives previously cited.
383
31º CERTAMEN JÓVENES INVESTIGADORES / Tecnologías e Ingenierías
1. INTRODUCCIÓN
Las bebidas energéticas garantizan un incremento a todos los niveles del organismo humano, desde la estimulación física a la excitación psicológica. Podemos casi afirmar rotundamente que esta publicidad sí que tiene sus frutos ya que cada vez es más usual encontrarse con alguien que este consumiendo este tipo de bebidas como si de un refresco se tratase. Siendo un producto que, actualmente, está experimentando un gran auge en el mercado. Sin embargo, múltiples noticias acechan con datos que se contraponen a toda esa sensación de bienestar garantizada por estas bebidas. Lo que lleva a preguntarnos: ¿Qué hay de cierto en lo que nos venden estas bebidas?, ¿Realmente lo sabemos todo acerca de ellas? Y lo más importante, ¿son seguras?
2. ANTECEDENTES
Las bebidas energéticas son bebidas analcohólicas, carbonatadas por lo general. Son consideradas un alimento funcional, puesto que han sido creadas con el fin de proporcionar beneficios adicionales.
El origen de estas se traslada a Japón, donde en 1962 se introdujo un producto pionero bajo el nombre de “Lipovitan D”. Comercializadas por TaishoPharmaceutical dando paso a un nuevo mercado. La evolución de este, ha derivado en la infinidad de marcas que se comercializan actualmente.
2.1. COMPOSICIÓN DE LAS BEBIDAS ENERGÉTICAS
2.1.1. CAFEÍNA
La cafeína es un alcaloide: un tipo de metabolito secundario que pertenece a la familia de las xantinas. La cafeína es un potente estimulante del sistema nervioso central y en general, del músculo esquelético. Es una sustancia activa, que al ser ingerida por vía oral se absorbe rápidamente.
En cuanto a la dosis máxima recomendada el grupo científico de Productos
Dietéticos, Nutrición y Alergia la EFSA estipula 300 mg en cuanto a niños y adolescentes. Relacionándolo con las bebidas energéticas destacamos que los niveles de cafeína en las bebidas estudiadas oscilan entre 20 y 35 mg por cada 100 ml de bebida, por lo que la ingesta de una lata de 250 ml supondría una incorporación de 87.5 mg de cafeína al organismo.
2.1.2. GLUCOSA
La glucosa es un monosacárido, y por lo tanto, un glúcido, perteneciente al subgrupo de las aldosas y la fuente más importante de energía en las células.
En cuanto a la dosis máxima recomendada, la American Heart Association
384
y 4 cafés
(AHA) limita la cantidad de azúcares añadidos entre 25 - 36 g. Considerando que en las bebidas energéticas estudiadas encontramos niveles de azúcar dispares desde 4.9 g a 15 g por cada 100 ml de bebida. La ingesta de una lata de 250 ml con un nivel medio de 10 g de azúcar por cada 100 ml, supondría una incorporación de 25 g, alcanzando los niveles máximos diarios.
2.1.3. TAURINA
La taurina es un aminoácido no esencial, que puede ser sintetizado por el organismo, principalmente en el hígado, a partir de otro aminoácido, cisteína. La taurina es un potenciador de la cafeína. En cuanto a la dosis diaria media según el Laboratorio de Complementos Nutricionales 1955 (LCN) es cercana a los 58 mg. Por lo general, dentro de las bebidas estudiadas y en aquellas que indicaban contener, encontramos niveles de taurina de entre 0.35g y 0.40g por cada 100 ml.
2.1.4. GLUCURONOLACTONA
La glucuronolactona es un hidrato de carbono resultado de la metabolización natural a partir de la glucosa en el hígado. Entre aquellas bebidas energéticas que la contienen, las concentraciones pueden variar desde los 250 mg/L hasta 2500 mg/L. Cabe destacar que la mayor parte de bebidas estudiadas no indicaban contenerla.
2.1.5. L-CARNITINA
La L-Carnitina es un aminoácido sintetizado en el hígado, los riñones y el cerebro a partir de los aminoácidos esenciales metionina y lisina. Entre las funciones de este aminoácido destaca el transportador de lípidos. Entre las bebidas estudiadas se encontraban en proporciones entre 10mg y 40mg por cada 100 ml, en aquellas bebidas lo indicaban.
2.1.6. EXTRACTOS VEGETALES
Los extractos más comunes encontrados en las bebidas energéticas son: Ginseng, Guaraná, Ginkgo biloba y Extracto de Café Verde. Todos estos componentes se encuentran en dosis menores al 0.03mg por 100ml en las bebidas estudiadas. Todas las propiedades que le son atribuidas no son avaladas por ninguna entidad, estando muy relacionadas con la estimulación.
2.1.7. VITAMINAS
Las vitaminas son compuestos orgánicos indispensables en pequeñas cantidades para el correcto funcionamiento del organismo. Cuyo exceso o déficit provoca trastornos metabólicos. Aquellas presentes en las bebidas energéticas son: Niacina/Vitamina B3 y Vitamina B12/Cianobalamina
12 Terrones
385
31º CERTAMEN JÓVENES INVESTIGADORES / Tecnologías e Ingenierías
En cuanto a la dosis máxima recomendada según The National Institutes of Health (NIH) del Departamento de Salud y Servicios Humanos de USA son: 2.6μg en adolescentes si hablamos de la Vitamina B12, mientras que se encuentra en torno a 17/18mg si nos referimos a la Niacina.
En cuanto a las bebidas estudiadas encontramos desde 2.4mg a 8.5mg por cada 100ml de Niacina. Así como desde 0.21μg hasta 2.5μg por cada 100ml de Cianobalamina.
2.2. REGULACIÓN LEGAL DE LAS BEBIDAS ENERGIZANTES
Centrándonos en la legislación española, en el BOE número 166 del 12 de julio de 2003, es en el Real Decreto 906/2003 del 11 de julio donde encontramos todo lo relativo al etiquetado de los productos alimenticios que contienen quinina o cafeína. Y en el Real Decreto 650/2011 del 9 de mayo, publicado en el BOE número 119 del 19 de mayo de 2011, en el que se aprueba la reglamentación técnico-sanitaria en materia de bebidas refrescantes, donde se hace mención del etiquetado de este tipo de bebidas con altos niveles de cafeína.
Por último, añadir que, pese a las múltiples búsquedas bibliográficas, no hemos encontrado normativa acerca del resto de componentes que encontramos en las bebidas energéticas. Concluyendo que representan un vacío legal.
2.3. EFECTOS FISIOLÓGICOS DERIVADOS DEL CONSUMO DE DICHAS BEBIDAS
2.3.1. Nivel de glucosa en sangre
La glucemia es el nivel de azúcar que encontramos en sangre, este es regulado por dos hormonas: la insulina y el glucagón. Ambas producidas en el páncreas y mientras que una reduce el nivel de azúcar la otra lo aumenta, respectivamente, procurando así que permanezca estable. Intentando evitar los picos de glucosa que se producen, sobre todo, tras la ingesta de algún alimento, lo que se conoce como Hipoglucemias reactivas o postprandiales. Los niveles de glucosa en sangre, van oscilando entre 70 y 145 mg/dl de sangre a lo largo del día.
El ritmo cardíaco, comúnmente conocido como pulso, hace referencia a la cantidad de latidos sufridos en un minuto. La frecuencia cardiaca normal, tomada en reposo a una persona que no presenta enfermedades congénitas o incidencias cardíacas, de acuerdo con la Fundación Española del Corazón (FEC), oscila entre 50 y 100 pulsaciones por minuto.
La tensión arterial hace referencia a la presión ejercida en las paredes arteriales
386
2.3.2. Ritmo cardíaco
2.3.3. Tensión arterial
durante el trasporte de sangre. Dicha presión arterial tiene dos componentes: La presión arterial sistólica que corresponde al valor máximo de la presión arterial, que coincide con la contracción del corazón, siendo su valor arterial normal 120mmHg; y la presión arterial diastólica, que concierne al valor mínimo, y se identifica con la diástole del corazón, cuyo valor arterial normal sería 80mmHg.
3. OBJETIVOS DE LA INVESTIGACIÓN
OBJETIVO 1. Analizar cómo afectan las bebidas energéticas al organismo en determinados aspectos fisiológicos. Objetivos específicos (derivados del O.1.): Medir la variación en el nivel de glucosa en sangre antes y después de la ingesta de diferentes bebidas energéticas; Evaluar cómo afecta la ingesta en el ritmo cardíaco; y, Determinar si existe una diferencia en la tensión arterial del sujeto tras la ingesta de la bebida energética.
OBJETIVO 2. Analizar y conocer el comportamiento de compra del consumidor joven de las bebidas energéticas. Objetivos específicos (derivados del O.2.): Identificar el perfil socio-demográfico del consumidor frente a las bebidas energéticas, y estudiar qué factores afectan al consumidor.
OBJETIVO 3. Analizar el consumo de estas bebidas en la localidad de Jumilla.
4. METODOLOGÍA
4.1. PARTE EXPERIMENTAL (OBJETIVO 1)
Antes de llevar a cabo la parte experimental realizamos un estudio de las etiquetas de las bebidas energéticas, en el que hicimos una recopilación de todos los datos que se muestran en ellas y de las marcas y tipos, que pudimos encontrar en la fecha del estudio en establecimientos comerciales, supermercados y tiendas de proximidad de la localidad de Jumilla.
Tras la recogida de los datos que aparecían en las etiquetas, comparamos diferentes componentes para clasificar las bebidas en función del nivel de glucosa, otorgándole a cada bebida una numeración del 1 al 7. Así mismo, elaboramos una bebida inocua (bebida 0) elaborada de forma casera a base de bebida gaseosa ¨Soda¨ y refresco en polvo con sabor a naranja que contenía tan solo 2,7 g de azúcar por cada 100ml de bebida preparada y fue empleada como blanco.
Decidimos tomar una muestra de población de 16 participantes con un número ecuánime de hombres y mujeres (8 y 8), todos comprendidos entre 17 y 19 años. A los que previamente a la medición de los factores fisiológicos de nuestro trabajo, se les realizó un seguimiento de la tensión a lo largo de 7 días para conocer la tensión media normal.
12 Terrones y 4 cafés 387
JÓVENES INVESTIGADORES / Tecnologías e Ingenierías
La prueba experimental consistió en la medición de las variables contempladas (glucemia, tensión y pulso) antes y tras la ingesta de 250 ml de cada una de las bebidas citadas anteriormente (numeradas del 1 al 7) y repartidas al azar. Para poder medir todas estas variables empleamos diversos instrumentos de medida, siendo el glucómetro “Contour.next” de Bayer y el tensiómetro “BPM Wrist 3311”, marca TopCom, digital de muñeca y que también nos proporcionó el pulso.
Mencionar que tuvimos que realizar las medidas de estos parámetros dos veces ya que al llevar a cabo la primera de ellas y dejando trascurrir un tiempo de 40 minutos tras la ingesta de las bebidas energéticas, los resultados que obtuvimos fueron una bajada media generalizada en las variables estudiadas. Por lo que nos vimos comprometidos a realizar una prueba control en tres sujetos para decidir cuál era el intervalo de tiempo idóneo, de modo que así pudimos establecer que debían realizarse dichas medidas entre los 5´a 10´ y entre los 15´a 20´ tras la ingesta en los parámetros de pulso y tensión; mientras que la glucemia debía ser tomada entre los 10´a 15´. Gracias a esta prueba control también pudimos apreciar como pasados 40 minutos de la ingesta de bebidas energéticas, los niveles de nuestras variables retornaban a los normales o incluso bajaban como ocurría en las pruebas anteriores.
Tras estimar los tiempos idóneos de realización de las medidas, volvimos a realizarlas, pero sobre 10 sujetos, manteniendo el control.
4.2. ENCUESTA (OBJETIVO 2)
Elaboramos una encuesta a través de la plataforma online Google Forms que tras su validación por un grupo piloto (compuesto de 28 personas) procedimos a pasar a la población objeto de nuestro estudio, es decir, jóvenes de Jumilla de edades comprendidas entre los 15 y 20 años.
A partir de los datos del Instituto Nacional de Estadística (INE) del año 2017 sobre el número de jóvenes que cumplían dichos requisitos obtuvimos un número de 1428 personas. Dicho dato nos permitió calcular el tamaño muestral para nuestra experimentación, resultando que debíamos de realizar 264 encuestas. Tras lo cual realizamos un muestreo por conglomerado al azar, dentro de nuestra población: Jumilla, donde seleccionamos el IES Infanta Elena y dentro de nuestro rango de edades (15-20). Quedando así nuestra muestra estratificada en función de las edades. El modo de escoger a los sujetos que realizaron la encuesta fue aleatorio previa comprobación que no producía sesgos. Posteriormente, las encuestas tuvieron que ser volcadas a diversas tablas de EXCELL.
4.3. ESTUDIO DE CAMPO (OBJETIVO 3)
Para el estudio de campo recopilamos el índice de ventas de dichos productos en un mes (enero de 2018). Destacar que, aunque nuestra pretensión era abar-
31º
388
CERTAMEN
car todos los locales comerciales, tan sólo nos facilitaron dichos índices de compra las cadenas MERCADONA y DÍA. Estos datos también fueron recogidos en tablas de EXCELL, expresados tanto en litros como en unidades por mes.
5. ANÁLISIS DE RESULTADOS
5.1. PARTE EXPERIMENTAL
Comenzando por el pulso (Fig.1) (controlado entre 5´-10´ y 15´- 20´). El sujeto control (12) experimenta una variación imprecisa en cuanto a ambas mediciones. Por otra parte, tres de nuestros sujetos experimentaron una subida en ambas mediciones (7, 14 y 16), destacando que en los dos últimos, que son

hombres, esta subida es más acusada en la segunda medición, es decir, tras 15 minutos. Dos sujetos evidenciaron lo opuesto, una bajada en ambas ocasiones (10 y 11) siendo estas de aproximadamente 10mmHg. En cuanto al resto de sujetos (1, 2, 3 y 6), las mediciones fluctúan entre la subida y bajada o viceversa, destacando que todos estos corresponden a mujeres. Debido a las diferentes variaciones entre los sujetos estudiados, no se puede establecer un patrón fijo en cuanto a cómo afectan las bebidas energéticas al pulso de los participantes.
La segunda variable a analizar es la tensión, controlada en las mismas fracciones de tiempo que el pulso. En relación a la tensión sistólica (Fig.2), los sujetos 1,3 y 7 experimentan una subida de alrededor de 20mmHg en cuanto a

12 Terrones
389
y 4 cafés
Figura 01
Figura 02
JÓVENES INVESTIGADORES / Tecnologías e Ingenierías
la medición inicial (todas mujeres). Destacando el primer puesto que alcanza los 150mmHg, nivel situado por encima de los establecidos como normales en nuestro marco teórico. Por otra parte, los participantes número 2,11 y 14 experimentan una bajada, siendo la disparidad más acusada. En cuanto a nuestro sujeto control (12) que partía de un valor de 124 mmHg, se aprecia que desciende a un valor de 114mmHg donde permanece estable.


Pasamos a analizar la tensión diastólica (Fig.3), resaltamos que nuestro sujeto control (12) aunque experimenta una pequeña bajada, se encuentra dentro de los índices normales establecidos. El resto de sujetos, cabe situar una fracción que se encuentran por debajo del nivel normal (3, 6, 10 y 11). Tras estos, los que se sitúan por encima de este nivel (1, 2, 7 y 16) y destacando los sujetos 7 y 16 que alcanzan 102mmHg y 104mmHg, respectivamente, siendo estos niveles muy elevados.
Por último y dentro de nuestra parte experimental, estudiamos la glucemia (Fig.4) en sangre (controlada entre los 10´y 15´). Cabe resaltar que todos nuestros sujetos experimentaron una subida de este parámetro. Apenas dos de ellos, donde se incluye nuestro sujeto control (12), muestran una subida de tan sólo 10 mg/dL aproximadamente. En el resto de sujetos dicha subida es mucho más acentuada.

31º
390
CERTAMEN
Figura 03
Figura 04
5.2.- ENCUESTA
La encuesta se dividía en dos partes: la primera correspondía a un test general, mientras que la segunda se destinaba tan sólo a los consumidores de bebidas energéticas, suponiendo un 53,2%. De los datos obtenidos podemos deducir que la proporción de jóvenes de Jumilla que consume bebidas energéticas y aquellos que no lo hacen están muy igualadas.
En cuanto a la primera pregunta, 1.- ¿Qué entiende usted por el término “energética”?. El 71% de los encuestados afirmó que dicho vocablo designaba un “Incremento en el estado de alerta”, lo que conlleva evitar el sueño, excitar el metabolismo, etc. En relación a la “Estimulación mental” y/o “Excitación psicológica” apenas alcanza el 20% de respuestas, lo que resulta curioso pues suponen uno de los objetivos que persiguen estas marcas.
Las siguientes preguntas perseguían identificar el nivel de conocimiento de los encuestados acerca de la composición de estas bebidas donde en la pregunta 3-. Marque aquellos componentes de los que desconoce sus efectos en el organismo. Cabe destacar que el 10,8% admitió desconocer totalmente la composición de dichas bebidas. Más a fondo, el 66% de estos sí que las ingieren a pesar de su ignorancia, frente a un 33% que no lo hace.
Pasamos tras esto a la segunda parte de nuestra encuesta. Nuestros investigados fueron preguntados acerca de la frecuencia y cantidad de ingesta de bebidas energéticas, esto suponen las preguntas: 2- ¿Con qué frecuencia las consume?, 3- ¿Cuántas latas de 500 ml puede ingerir en un día/semana/mes/...? y 4-. Si marcó en la pregunta 3 la última opción "4 o más", especifique la cantidad. Destacar que aproximadamente el 44% de los encuestados tan sólo ingiere 1 bote de estas bebidas en algunas ocasiones. Por otra parte, aquellos que semanalmente consumen de 2-3 botes de 0.5L suponen casi un 20% de los encuestados; así como, aquellos que diariamente ingieren la misma cantidad corresponden al 4%. En relación a dichas ingestas, también nos interesó conocer acerca de si estas se acompañaban de otras sustancias. Quedando reflejado en nuestra pregunta: 5-. ¿Consume las bebidas energéticas solas?, donde el 41,3% de los encuestados las mezcla con otras sustancias, como alcohol, en todas o en algunas de sus ingestas.
En cuanto a la edad en la que comenzaron su consumo la mayoría coinciden en que fue entre los 10 y 16 años (69%). Pese a que aquello que motivo su consumo fue “refrescarse”, actualmente como observamos en la pregunta 9-. Actualmente, ¿Por qué razones las tomas?, la mayoría lo hace “Porque les gusta su sabor”. Sin embargo, resaltamos que el 48,3% las ingiere por motivos relacionados con el estudio, ya sea “Para aumentar la concentración” o “Para evitar el sueño”.
Por último, quisimos conocer si nuestros encuestados presentaban efectos adversos tras la toma de bebidas energéticas. Destacamos que el 9,6% de los encuestados admiten presentar efectos adversos pasadas unas horas de la ingesta
12 Terrones y 4 cafés 391
31º CERTAMEN JÓVENES INVESTIGADORES / Tecnologías e Ingenierías
de bebidas energéticas. Los más evidenciados entre nuestros encuestados son: “Insomnio”, “Dolor de cabeza” y “Ansiedad”, muy seguido de “Taquicardias”.
5.3. ESTUDIO DE CAMPO
Concluiremos nuestro análisis de resultados con el estudio de campo (Fig.5). Comenzamos con MERCADONA, cabe decir que agrupa las que 5 marcas que comercializa, sin distinguir entre propias y marcas reconocidas, suponiendo un total de aproximadamente 54L vendidos en el mes de enero de 2018.

Por otro lugar, es apabullante comprobar el nivel de ventas de DÍA en cuanto a su Marca Blanca, respecto a RedBull, pues es superada en 175 L en dicho mes. Las diferencias en la composición de ambas bebidas no distan mucho.
Sin embargo, donde sí encontramos una acusada diferencia entre ellas es en el precio, de 0,91€, siendo más asequible la marca blanca, más vendida.
6. CONCLUSIONES
• La ingesta de bebidas energéticas aumenta el nivel de glucosa en sangre de nuestros sujetos estudiados.
• Más del 50% de los encuestados que admiten desconocer por completo la composición de las bebidas energéticas, sí las ingiere pese a su total desconocimiento.
• Cerca del 10% de los encuestados presentan efectos adversos tras la ingesta de bebidas energéticas.
• La venta de estas bebidas está generalizada ya que pueden encontrarse en cualquier establecimiento.
392
Figura
05
7. BIBLIOGRAFÍA Y WEBGRAFÍA
Chatterjee, I. B., Chatterjee, G. C., Ghosh, N. C., Ghosh, J. J., & Guha, B. C. (1960, August). Biological synthesis of L-ascorbic acid in animal tissues: conversion of D-glucuronolactone and L-gulonolactone into L-ascorbic acid. Retrieved November 15, 2017, from
https://www.ncbi.nlm.nih.gov/pmc/articles/PMC1204705/
World Health Organization. (n.d.). Alimentación sana. Retrieved October 30, 2017, from http://www.who.int/mediacentre/factsheets/fs394/es/
Nicolás, J. (2014, November 14). Bebidas energéticas, deporte... y salud. Retrieved May 25, 2019, from https://scientiablog.com/2014/11/11/bebidas-energeticas-deporte-y-salud/
Editorial, E. (2018, July 28). Química de las bebidas energéticas y sus efectos. Retrieved May 6, 2017, from
https://iquimicas.com/quimica-de-las-bebidas-energeticas-y-sus-efectos/
Rodriguez, R. C., Ciria, M. D., & Sala, M. F. (1987). Bases de la medicina interna: etiología, fisiopatología y semiología (6th ed.). Barcelona (Spain): Toray
Marieb, E. N. (2012). Anatomía y fisiología humana (9th ed.). Madrid (Spain): Pearson Addison Wesley
Aguilar O. M., Galvis-Pedrosa C. F., Heredia-Mauera H. A., Restepo-Pinzón A. (2008) Efecto de las bebidas energizantes con base de taurina y cafeína sobre la atención sostenida y selectiva entre un grupo de jóvenes entre 18 y 22 años. Revista Iberoamericana de Psicología: Ciencia y tecnología (1): 73-85
Botella, J. (2000) Algunos problemas metodológicos en el estudio de la atención selectiva. Universidad Autónoma de Madrid. Psicothema Volumen (12), pp. 91-94
Castellanos R. A, Rossana M. R, Frazer, G.G. (2006) Efectos fisiológicos de las bebidas energizantes. Revisión Facultad de Ciencia médica
González Ramírez, A.M. (2012) ¿De qué se componen las bebidas energéticas? ¿Son realmente negativas para el organismo? MoleQla, Revista de Química de la Universidad Pablo de Olavide, Volumen (7)
Melgarejo, M. (2004) El verdadero poder de las bebidas energéticas. Revista Énfasis Alimentación, Volumen (6)
12 Terrones y 4 cafés 393
/ TERCER PREMIO
AUTORES | CARLOS ESTEBAN NAVARRO Y CARLOS BELLANCO ORTIZ
COORDINADOR | SERGI BONET MARTÍNEZ
CENTRO | ESCOLA MARE DE DÉU DE LA SALUT
CIUDAD | SABADELL-BARCELONA
RESUMEN |
El trabajo consiste en la construcción de un túnel de viento donde poder analizar a escala pequeña las diferentes interacciones entre el flujo y objetos sólidos para hacer la comparación con resultados teóricos obtenidos con un programa de CFD (Computational Fluid Dynamics) para, así, poder probar la veracidad de los resultados obtenidos en el túnel de viento, y, consecuentemente, la fiabilidad de éste.
ABSTRACT |
The project consists in the construction of a wind tunnel, where we can analyze on a small scale the different interactions between the fluid and some solid objects. This will allow us to make a comparison with theoretical results obtained with a CFD program (Computational Fluid Dynamics) and, therefore, be able to test the veracity of the results obtained in the wind tunnel and, consequently, the reliability of it.
Diseño y construcción de un túnel aerodinámico para la visualización del flujo alrededor de objetos y la comparación de estos con dinámica de fluidos computacional
TECNOLOGÍAS E INGENIERÍAS 395
31º CERTAMEN JÓVENES INVESTIGADORES / Tecnologías e Ingenierías
AGRADECIMIENTOS
Este trabajo no habría sido posible sin la ayuda de varias personas. Es por eso por lo que agradezco primero de todo a Sergi Bonet, por dirigir nuestro trabajo de una manera excelente y por aportar ideas cuando surgían dificultades. También, agradecer el apoyo de Juan Ignacio Córcoles, profesor de mecánica de fluidos de la UCLM (Universidad de Castilla la Mancha), por ayudarme a la hora de entender la mecánica de fluidos, y a “Espai Creactiu”, por ayudarme con los diseños del túnel de viento e imprimir las diferentes piezas que forman el túnel.
INTRODUCCIÓN
Se conoce como aerodinámica a la parte de la mecánica que estudia el movimiento de los gases sobre los cuerpos estacionados y el comportamiento de los cuerpos que se mueven por el aire. Nuestro trabajo consiste primero en construir un túnel de viento donde, posteriormente, poder analizar las diferentes interacciones entre el gas y el objeto sólido para compararlas con resultados teóricos obtenidos con un programa de CFD (Computational Fluid Dynamics) y, así, probar la veracidad de los resultados obtenidos en el túnel.
Al finalizar bachillerato me gustaría estudiar o bien ingeniería informática o bien ingeniería aeroespacial y este trabajo me pareció la mejor forma de poner un pie en la carrera ya que por una parte se estudia mecánica de fluidos y por otro se lleva esto a una fase computacional, lo cual hace que este trabajo toque aspectos de ambos campos del conocimiento.
Antes de empezar el trabajo, mi conocimiento en la mecánica de fluidos era prácticamente nulo, entonces antes de todo tuve que aprender las bases de esta parte de la mecánica para poder entender los resultados obtenidos y poder hacer un análisis detallado del comportamiento del fluido alrededor del objeto. También, tuve que aprender cómo funcionan los programas de CFD de forma básica ya que estos son de alta complejidad.
El trabajo se divide en tres grandes partes: la construcción del túnel de viento, la obtención de resultados teóricos por ordenador y la posterior comparación de estos con los resultados prácticos obtenidos en el túnel.
La metodología utilizada para la construcción del túnel de viento es la estándar en un trabajo tecnológico: identificación de la necesidad, que es poder realizar análisis aerodinámicos con facilidad, diseño del túnel y finalmente la construcción del túnel basándose en los diseños realizados. Para obtener los resultados teóricos por ordenador se utiliza un programa de CFD, en nuestro caso este se llama ANSYSStudentDiscoveryLive, que analiza la aerodinámica de cualquier objeto en 3D que se importe en el programa dadas unas condiciones iniciales invariables. Finalmente, para poder unir las dos partes del trabajo se realiza
396
Diseño y construcción de un túnel aerodinámico para la visualización del flujo alrededor de objetos y la comparación de estos con dinámica de fluidos computacional
una comparación entre los resultados teóricos y los prácticos, así que primero se tienen que obtener estos últimos mediante la grabación de dos vídeos de cada objeto en cada posición que se quiere estudiar (uno en cámara lenta y otro normal) con una cámara de buena resolución, en este caso la de un iPhone 6 Plus. Para poder visualizar el flujo aerodinámico con facilidad el túnel debe tener una buena iluminación y la cámara tiene que estar a la misma altura que el objeto estudiado ya que esto hace que la superficie estudiada sea un plano, lo que simplifica la comparación de los objetos. Una vez obtenidos los resultados prácticos y teóricos de cada objeto se comparan las imágenes, se buscan diferencias y se explican los fenómenos aerodinámicos.
ESTADO DE LA CUESTIÓN
La aerodinámica es la rama de la mecánica de fluidos que se ocupa del movimiento del aire y otros fluidos gaseosos, y de las fuerzas que actúan sobre los cuerpos que se mueven en dichos fluidos. Y la mecánica de fluidos es la rama de la mecánica de medios continuos, y por lo tanto, rama de la física, que estudia el movimiento de fluidos, (tanto gaseosos como líquidos) y de las fuerzas que lo provocan.
Perfil alar: Se entiende por perfil alar o perfil aerodinámico, a la forma del área transversal de un elemento, que al desplazarse a través del aire es capaz de crear a su alrededor una distribución de presiones que genere sustentación.
Capa límite, flujo laminar y flujo turbulento: Para saber que es la capa límite, primero hay que saber lo que significa el concepto de líneas de corriente. Las líneas de corriente son curvas imaginarias dibujadas a través de un fluido en movimiento y que indican la dirección de este en los diversos puntos del fluido. Entonces, con las líneas de corriente surge el concepto de capa límite, que es donde tienen lugar una parte importante de los fenómenos que generan las fuerzas aerodinámicas. La capa límite es la zona existente alrededor de un cuerpo que se desplaza por un fluido, en la cual la velocidad del fluido respecto al cuerpo varía desde cero hasta el 99% de la velocidad de la corriente exterior. Esto se debe a que el aire viaja a una cierta velocidad y en el inicio del movimiento alrededor del ala, este aire que se encuentra libre, pasa inmediatamente a estar en contacto con el perfil alar, y a tener una velocidad nula debido a la condición de adherencia. Además de esto, el espesor de la capa límite en la zona del borde de ataque es pequeño, pero aumenta a lo largo de la superficie.
En la capa límite, el flujo puede ser laminar o turbulento, los cuales tienen características diferentes.
• Flujo laminar: este flujo se caracteriza porque el movimiento de las partículas del fluido se produce siguiendo trayectorias bastante regulares, separadas y perfectamente definidas
• Flujo turbulento: este otro flujo se caracteriza por el movimiento caótico de
397
las partículas, donde estas se mueven desordenadamente y las trayectorias de las partículas se encuentran formando pequeños remolinos.
En el proceso de desprendimiento de la capa límite, el flujo pasa de laminar a turbulento. Pero este proceso no se hace de manera instantánea, sino que entremedio se produce lo que se conoce como zona de transición, en donde se pasa del flujo laminar al flujo turbulento.
Túnel aerodinámico: El túnel aerodinámico o, más comúnmente llamado túnel de viento, es un instrumento científico-tecnológico cuya aplicación es la generación de una corriente fluida de propiedades conocidas para la medida de las acciones del viento sobre obstáculos de muy diversa naturaleza, y para el estudio de los fenómenos físicos en los que el aire en movimiento juega un papel dominante. Los objetos que se suelen estudiar son edificios, automóviles, aviones, cascos, y cualquier otra cosa más. Generalmente se utilizan maquetas a escala, ya que, por ejemplo, es muy costoso disponer de un túnel de viento donde quepa un avión a escala real. Pero esto tiene un inconveniente, y es que el tamaño de la maqueta influye en los resultados del ensayo, y por lo tanto, cuanto más grande sea la maqueta y más parecida al objeto real, mejores serán los resultados del ensayo.
Por lo tanto, el túnel aerodinámico permite estudiar el movimiento relativo entre el objeto y el aire. Por lo que los ingenieros utilizan esta herramienta para obtener datos de presiones, fuerzas, información de la capa límite, y también para poder visualizar las líneas de corriente alrededor de un objeto.
Dinámica de fluidos computacional: La dinámica de fluidos computacional es una rama de la mecánica de fluidos que utiliza métodos numéricos y estructuras de datos para resolver y analizar problemas sobre el flujo de fluidos. Para esto se utilizan ordenadores que realizan los cálculos necesarios para simular la interacción de líquidos y gases con superficies definidas por condiciones de frontera o contorno. Estos cálculos son más precisos y rápidos si se utilizan superordenadores para realizarlos, pero, debido a la complejidad del tema, estos resultados son solo aproximaciones.
OBJETIVOS
Este trabajo tecnológico tiene unos objetivos, los cuales se tienen que conseguir realizar, y al finalizar el trabajo se analizará si se han cumplido o no, sacando unas conclusiones de lo que se haya obtenido.
El objetivo principal de este trabajo es construir un túnel de viento, el cual reúna las siguientes características:
• Fácil y barato de construir
• Fácil de transportar
31º CERTAMEN
398
JÓVENES INVESTIGADORES / Tecnologías e Ingenierías
Diseño y construcción de un túnel aerodinámico para la visualización del flujo alrededor de objetos y la comparación de estos con dinámica de fluidos computacional
• Útil en el ámbito de la investigación y la enseñanza, tanto en institutos y como en universidades
• Poder observar el efecto del aire al incidir en objetos, así como visualizar la capa límite y el punto de desprendimiento
• Fiable a la hora de extraer conclusiones de la experimentación
A raíz de este objetivo principal de construir el túnel de viento, surgen otros objetivos, con tal de saber si el túnel de viento funciona, y si es fiable a la hora de llegar a unas conclusiones después de realizar un experimento. Estos objetivos son los siguientes:
• Hacer pruebas en el túnel de viento con un perfil alar y con distintos cuerpos geométricos, para ver en cada uno el comportamiento de la capa límite
• Realizar simulaciones de estos mismos objetos con un programa de dinámica de fluidos computacional (DFC)
• Observar las semejanzas y las diferencias del comportamiento de la capa límite en pruebas experimentales y en simulaciones teóricas
• Comparar los vídeos e imágenes de los diferentes objetos estudiados en el túnel de viento con las respectivas simulaciones teóricas realizadas con un programa informático.
METODOLOGÍA
Materiales: Metacrilato transparente y negro, leds, cartulinas negras, madera, pajitas, tubos y accesorios de PVC, aspirador, máquina de humo, ventilador y varillas roscadas.
Diseño: Antes de construir el túnel, se realizan los diseños 2D y 3D. El diseño 2D se ha hecho con el programa LayOut2018, y el diseño 3D con el programa SketchUp2018. Los diferentes componentes del túnel de viento son; ventilador (V), máquina de humo (M), tubo de PVC, malla acondicionadora de flujo, cámara de ensayos y aspirador (A).
Procedimiento de construcción: Para construir el túnel de viento se han seguido bastantes pasos, y a medida que se iba construyendo el túnel se iban realizando diferentes pruebas experimentales, para saber si se avanzaba o no por el buen camino. En más de una ocasión se ha tenido que alguna parte del túnel para conseguir que las líneas de corriente se vieran mejor. A continuación, se mencionan los pasos más importantes y los errores que se han ido superando mientras se construía el túnel.
Primero de todo, la cámara de ensayos está constituida por diferentes piezas de metacrilato, encajadas entre ellas como si fueran piezas de puzle, y enganchadas con silicona para darle más firmeza a la estructura. Estas piezas de me-
399
31º CERTAMEN JÓVENES INVESTIGADORES / Tecnologías e Ingenierías
tacrilato de han cortado con una máquina de corte láser. Destacar también que en la cámara de ensayos hay bastantes luces led para poder visualizar mejor el humo. Entonces, en un lado de la cámara de ensayos se colocó un ventilador, y en el otro la máquina de humo y la malla acondicionadora de flujo, que era una madera de 5 cm de grosor, con 64 orificios, para convertir el aire turbulento en laminar. Pero después de hacer una prueba experimental, se decidió cambiar muchos aspectos del túnel, ya que no se conseguía diferenciar las diferentes líneas de corriente, y las turbulentas.

Entonces, se pensó en mejorar la malla acondicionadora de flujo y todo el sistema por donde pasaba el flujo. Por eso, se decidió poner cuatro pajitas de 15 cm de longitud y 8 mm de diámetro, para darle más forma al humo y saliera más laminar. Pero después de hacer una prueba, se observó que el humo no salía con suficiente fuerza, por lo que se decidió de poner un tubo de PVC de un metro de longitud con la finalidad de canalizar más el humo. Además de esto, se puso un pequeño ventilador dentro del tubo de PVC para impulsar un poco más al humo, y que llegara con suficiente fuerza a la cámara de ensayos, pasando por la malla acondicionadora de flujo.
Además de esto, también se mejoró el sistema de aspiración del humo, debido a que al principio de todo se utilizaba un extractor para absorber el humo, pero este lo que hacía era producir turbulencias extras, cosa que perjudicaba a los resultados. Por lo tanto, se decidió poner un aspirador, para que en vez de absorber el humo lo succionara, y así no producía turbulencias. También, se hace un soporte con varillas roscadas para sujetar en el aire los objetos a estudiar, y así el humo puede pasar tanto por la parte superior del objeto como por la parte inferior.
Realización simulaciones: Antes de empezar con las simulaciones se tienen que crear figuras cuyas medidas son prácticamente iguales a las reales, para así minimizar la diferencia entre el túnel de viento y las simulaciones.
Una vez se dispone de las medidas, las figuras se crean con el programa 3D Builder y se tienen que guardar con el formato “stl” para poder así importarlas al programa donde, posteriormente, se realizan las simulaciones.
400
Figura 01
Túnel aerodinámico construido. Fuente: Propia.
Diseño y construcción de un túnel aerodinámico para la visualización del flujo alrededor de objetos y la comparación de estos con dinámica de fluidos computacional
El programa que se utiliza para realizar las simulaciones es el ANSYS Student Discovery Live, un programa de CFD ideal para principiantes en este tema dada su sencillez a la hora de realizar las simulaciones.

Una vez se abre el programa te da la opción de simular directamente varias situaciones donde estudiar el comportamiento del fluido. Se elige Wind tunnel o túnel de viento y se elige la figura guardada anteriormente en cualquier formato que acepte formas en 3D (3MF, STL, OBJ, PLY, GLTF, GLB), en este caso, en formato STL. Una vez abierto el archivo elegido, en el programa aparece se clica en Create Solution y se elige desde donde se quiere lanzar el fluido, en este caso, se elige el lado izquierdo. El resultado, después de elegir la configuración deseada, es el que se puede ver en los resultados de las simulaciones teóricas También se puede elegir la velocidad del fluido en la parte izquierda en Flow Velocity para adaptar la simulación a las condiciones dadas en el túnel de viento.
RESULTADOS
Para obtener unos resultados fiables, se ha realizado la comparación entre simulaciones teóricas y pruebas experimentales con bastantes formas geométricas diferentes y también, con un perfil alar con diferentes ángulos de inclinación. En la ilustración 2, se puede observar un ejemplo de todos los resultados obtenidos. En este caso, es un prisma triangular, en el que tanto en la imagen de la izquierda (prueba experimental realizada en el túnel de viento) como en la de la derecha (simulación teórica realizada con un programa que se llama ANSYSStudentDiscoveryLive) se observa que el punto de desprendimiento de la capa límite coincide, así como también coincide el vacío que se forma detrás del objeto.
Comparación prueba experimental-simulación teórica del prisma triangular.
Fuente: Propia.
Aparte de comparar las simulaciones teóricas con las pruebas experimentales, también se ha introducido en el túnel de viento un coche de juguete, para así poder visualizar lo que pasa cuando un coche se mueve a través del aire, y el efecto que tiene el alerón trasero a la hora de separar el aire del coche, y así poderse agarrar mejor al suelo y poder ir a más velocidad. Las imágenes de la prueba experimental del coche son las imágenes 3.
401
Figura 02
CONCLUSIONES
A partir de los objetivos establecidos al principio del trabajo, y después de llevar a cabo un diseño tecnológico, se ha obtenido un producto, un túnel aerodinámico. Este producto diseñado y construido tiene unas características, las cuales la mayoría se ajustan a lo establecido en los objetivos, y algunas otras no.
Primero de todo, el túnel de viento reúne características preestablecidas, como, por ejemplo, que es fácil de construir y fácil de transportar por piezas en coche. También, que es útil en el ámbito de la investigación y la enseñanza, y se puede observar el efecto del aire al incidir en objetos, así como visualizar el desprendimiento de la capa límite. A parte de estas características, hay una que no se ajusta a lo que se deseaba, y es que construir el túnel ha salido bastante caro, ya que nos hicimos una idea de no gastar más de 100 euros, y, el material necesario para construirlo ha costado 230 euros. Por lo tanto, el objetivo principal del trabajo que era construir un túnel de viento que cumpliera las características anteriores, se ha cumplido con gran satisfacción.
A raíz de este objetivo principal, surgen otros objetivos más experimentales, científicos, con la finalidad de implementar el producto construido, y darle validez. Estos objetivos se basan en realizar pruebas experimentales en el túnel aerodinámico con diferentes objetos, realizar simulaciones teóricas con un programa DFC, y comparar los resultados entre pruebas experimentales y simulaciones teóricas. Estos, se han efectuado con creces, ya que las simulaciones teóricas y las pruebas experimentales en el túnel de viento se han realizado perfectamente. En cambio, a la hora de hacer la comparación, no ha salido del todo bien, porque, en algunas de las formas geométricas, las cuales eran más detalladas, más precisas, se observaban bastantes diferencias entre las pruebas experimentales y las simulaciones teóricas. Aun así, en la mayoría de los objetos estudiados la comparación ha salido bastante bien.
Después de haber construido un túnel de viento y haber realizado una gran implementación, se puede concluir que se ha diseñado y construido un túnel aerodinámico que reúne las características deseadas, y, que es fiable para poder llevar a cabo experimentos relacionados con la visualización del flujo alrededor de objetos, tanto a nivel de investigación como a nivel de enseñanza.

31º CERTAMEN
402
JÓVENES INVESTIGADORES / Tecnologías e Ingenierías
Figura 03
Prueba experimental automóvil.
Diseño y construcción de un túnel aerodinámico para la visualización del flujo alrededor de objetos y la comparación de estos con dinámica de fluidos computacional
BIBLIOGRAFÍA LIBROS
Anderson, J. (1995). Computational Fluid Dynamics: The BasicsWith Applications. Nueva York: Mc-Graw Hill.
Anderson, J. (2001). Fundamentals of Aerodynamics. Nueva York: Mc-Graw Hill.
Barlow, J., Rae, W. & Pope, A. (1999). Low-Speed wind tunnel testing. Canadá: John Wiley & Sons.
Çengel, Y. & Cimbala, J. (2004). Mecánica de fluidos: fundamentos y aplicaciones. Mc-Graw Hill.
Tipler, P. & Mosca, G. (2010). Física para la ciencia y la tecnología. Nueva York: Editorial Reverté.
ARTÍCULOS
Barba, S. (2016, enero). El túnel de vent com eina d’assaig aerodinàmic, 114.
Bazán, D. (2013, febrero). Perfiles aerodinámicos: familias y tipos. Instituto Politécnico Nacional, 14.
Bertran, F. (2009, mayo 28). Estudi comparatiu de les prestacions aerodinàmiques d’un aleró d’un automòbil de competició Formula 1 (F-1), 78
Botella, M. (2013). Uso del cálculo numérico CFD para el estudio de actuaciones de una motocicleta de competición. Universidad Politécnica de Madrid, 173.
Chicas, F. (2012, mayo). Diseño y construcción de un túnel de viento, 170.
Sadraey, M. (2012). Wing Design. Daniel Webster College, 5, 109.
SITIOS WEB
(2010). Túneles de viento (I). Julio 5, 2018.
Sitio web: https://www.f1aldia.com/10650/tuneles-de-viento-i/ (2010). Túneles de viento (II). Julio 5, 2018.
Sitio web: https://www.f1aldia.com/10680/tuneles-de-viento-ii/
Esteban, S. & Gavilán, F. (2009). Aeronaves y vehículos espaciales. Julio 20, 2018, de Escuela Superior de Ingenieros de la Universidad de Sevilla. Sitio web: http://aero.us.es/AVE/archivos/Y0910/Tema4_parte1(WEB).pdf
Hall, N. (2015). Aerodynamics. Junio 15, 2018, de National Aeronautics and Space Administration. Sitio web: https://www.grc.nasa.gov/www/k- 12/airplane/short.html
403
Generating success – ecomochila
/ PREMIO ESPECIAL DE LA UNIVERSIDAD POLITÉCNICA DE MADRID
AUTORES | SERGIO BRAVO RODRÍGUEZ Y MARCOS JÁTIVA MUÑOZ
COORDINADORA | MARÍA JOSÉ GARCÍA QUIJANO
CENTRO | COLEGIO FILIPENSE SAGRADO CORAZÓN DE JESÚS
CIUDAD | ALCALÁ DE HENARES-MADRID
RESUMEN |
Como contribución al desarrollo sostenible proponemos un nuevo diseño de mochila con ruedas que aprovecha fuentes de energía renovables al alcance de cualquier persona, como la temperatura y el movimiento, que no son generalmente utilizadas, para cargar dispositivos móviles. Para ello se combina una dinamo con dos placas peltier que, instaladas en el asa de la mochila, generan electricidad gracias al gradiente de temperatura entre las manos calientes y el interior del metal. También se conectaron dos pequeñas placas solares sobre la mochila, para aprovechar todas las formas de energía disponibles. En conclusión, nuestra investigación busca formas creativas, al mismo tiempo que eficientes, para transformar estas energías desaprovechadas en electricidad utilizable.
ABSTRACT |
As a contribution to sustainable development, this report describes the design for a new backpack with wheels that uses renewable energy sources within the reach of anyone, such as temperature and movement. These energy sources, which are not commonly harvested, are used for charging mobile devices. In order to achieve this objective, a dynamo is combined with two peltier plates that, installed in the handle of the backpack, generate electricity thanks to the temperature gradient between the hot hands and the interior of the metal. Two small solar panels were also connected to the backpack, to take advantage of all available energy sources. In conclusion, our research looks for innovative and creative ways to transform these wasted energy sources into usable electricity.
TECNOLOGÍAS E INGENIERÍAS 405
CERTAMEN JÓVENES INVESTIGADORES / Tecnologías e Ingenierías
INTRODUCCIÓN
Uno de los problemas principales al que nos enfrentamos actualmente es el cambio climático acelerado. Adaptarnos al cambio global exige que encontremos alternativas sostenibles a nuestro estilo de vida. Por ello, es muy importante que pongamos nuestro talento y esfuerzo al servicio de este problema, que puede que determine nuestra supervivencia.
Como contribución al desarrollo sostenible proponemos un nuevo diseño de mochila con ruedas que aprovecha fuentes de energía al alcance de cualquiera, como la temperatura y el movimiento. Pensamos que es importante desarrollar soluciones que aprovechen fuentes de energía renovables para cubrir la demanda de electricidad a todos los niveles. Nosotros, como alumnos de E.S.O. lo hemos aplicado principalmente a cargar el móvil, pero es una solución que se puede extrapolar a otros usos - desde cargar patinetes eléctricos, hasta aprovechar el calor que puedes generar durmiendo sobre tu colchón -. En resumen, buscamos formas creativas, al mismo tiempo que eficientes para transformar estas energías desaprovechadas en electricidad utilizable.
ANTECEDENTES
ENERGÍA ELÉCTRICA
En la actualidad uno de los recursos más valiosos es la electricidad. Ésta, puede ser transportada, para ser aprovechada mediante diferentes receptores. Por ello, la energía eléctrica es la sangre que mantiene nuestra economía.
La energía eléctrica se obtiene a partir de varias fuentes. La mayor parte de la electricidad generada se obtiene de plantas nucleares y eólicas, mientras la producción en plantas de ciclo combinado ha disminuido de forma importante en la última década.
GENERACIÓN DE CORRIENTE CONTINUA MEDIANTE DINAMOS
Una dinamo es un tipo de generador cuya finalidad es transformar la energía mecánica en corriente directa a partir del uso de campos magnéticos. Las dinamos se componen de un imán exterior que actúa como inductor, y un rotor compuesto por espiras metálicas, donde se induce corriente continua. Las dinamos no son usadas en la generación eléctrica a nivel industrial, pues la corriente continua que generan sufriría muchas pérdidas durante su transporte. Sin embargo, el mismo diseño de las dinamos se aplica a los motores eléctricos de corriente continua (Figura 1). Estos motores se pueden usar para generar electricidad. El fundamento de esos usos de las dinamos (el aprovechamiento in situ de un movimiento) podría aplicarse a las ruedas de una mochila escolar.
31º
406
Generating success – ecomochila
En conclusión, consideramos que nuestra propuesta es factible, ya que existen aplicaciones similares de la dinamo para generar electricidad a partir del movimiento. Pero, al mismo tiempo, es una propuesta novedosa, pues no se encuentran mochilas con este sistema, y potencialmente sería muy útil para la población escolar.
Motor eléctrico.
Autor: Miguel Angel
GENERACIÓN DE CORRIENTE CONTINUA MEDIANTE PLACAS PELTIER
Una placa o célula peltier funciona gracias al efecto termoeléctrico que se genera en los termopares, o uniones de diferentes metales. Gracias a estos descubrimientos, se obtienen placas de pequeño tamaño y bajo coste capaz de funcionar y mantener su rendimiento durante 20 años.
EFECTO SEEBECK:
Thomas J. Seebeck descubrió en 1821 que si unimos una lámina de cobre y una de bismuto en un circuito cerrado, al calentar una de las láminas, se producía magnetismo. Aunque Seebeck no supo explicar correctamente el motivo, a posteriori se encontró que era debido a la generación de una corriente eléctrica en el termopar (Rof, 2015). Para que se produzca este efecto basta con que tengamos dos conductores distintos que se encuentren a diferente temperatura para que se genere una diferencia de potencial, producida por la naturaleza de ambos conductores. Cuanto mayor sea la diferencia de temperatura entre ambas caras de la placa, mayor será la diferencia de potencial generada.

407
Figura 01
Rodríguez Pozueta. 2010
Atribución 3.0.
Licencia: Creative Commons.
CERTAMEN JÓVENES INVESTIGADORES / Tecnologías e Ingenierías
EFECTO PELTIER:
Jean C. A. Peltier tras investigar a fondo el efecto Seebeck, descubrió que era reversible. Esto es, observó que al aplicar una corriente eléctrica al termopar se producía una diferencia en sus temperaturas. Este efecto peltier es ampliamente aplicado en la actualidad para disipación de calor en componentes electrónicos, como en microprocesadores de ordenadores, y domésticos, como neveras eléctricas portátiles.
El funcionamiento de una placa Peltier como generador de corriente eléctrica se explica mediante la siguiente ecuación (McCormick School of Engineering, 2019):
V=αΔT - IR
V : Diferencia de potencial que se genera.
α: coeficiente de Seebeck
ΔT: Diferencia de temperatura que se aplica.
I: Intensidad de la corriente generada.
R: Resistencia interna de la placa.
Analizando esta ecuación resulta evidente que cuanto mayor sea la diferencia de temperaturas entre los lados de la placa, mayor será la corriente generada.
METODOLOGÍA
HIPÓTESIS Y OBJETIVOS
Buscábamos crear algo que mejorase nuestra vida cotidiana y protegiera el medio ambiente, promoviendo el desarrollo sostenible. Deseábamos producir una energía limpia y accesible que haga nuestro estilo de vida más sostenible. La solución eran nuestras mochilas.
¿CÓMO MODIFICAR UNA MOCHILA ESCOLAR PARA QUE GENERE Y ALMACENE ENERGÍA ELÉCTRICA?
La energía no se crea ni se destruye, sólo se transforma. Esto nos hizo pensar en la existencia de algún mecanismo capaz de transformar la energía del movimiento de las ruedas en energía eléctrica. Encontramos otros medios de producir electricidad: Las placas Peltier, y las placas solares.
Inmediatamente nos animamos a incorporarlas al prototipo.
31º
408
MATERIALES Y MÉTODOS
Generadores
(1) Motor eléctrico reversible FisherTechnic de 2V DC: 2,8 €
(2) Células Peltier tipo TEC1-12726 de 400 W: 6,4 €
(2) placas solares de 1V y 440mA: 2 €
Circuitos integrados
(1) Módulo Controlador de Carga TP4056 input 5V 1A a batería de Litio
4,2V: 1,5€ - (1) Módulo elevador TECNOIOT, input 0.9V-5V DC, output
5V DC: 1,8 €
Acumulador
(1) 3.7V 500mAh Batería de Li-po: 5,99 €
Otros fungibles
(1) Cables: 0€ (reciclados)
(1) Polea y correa de transmisión Fisher Technic: 2 €
(1) Carrito para mochila: 11, 82 €
(1) tubo de espuma aislante EPE: 1 €
Materiales Inventariables
Termómetro infrarrojo, polímetro y soldador de lápiz
PROCEDIMIENTO
PRIMER PROTOTIPO DE ECOMOCHILA
Usando listones de madera y una placa de PVC transparente como base construimos la primera Ecomochila: Dimóvil. Fuimos capaces de generar voltaje con la dinamo, pero nuestras medidas con el polímetro mostraban dos proble-

409
Generating success – ecomochila
Figura 02
Fila a la salida de alumnos de nuestro centro escolar.
CERTAMEN JÓVENES INVESTIGADORES / Tecnologías e Ingenierías
mas: (1) El voltaje generado por la dinamo no llegaba a los 5 voltios; (2) Sólo se generaba electricidad cuando la mochila rodaba. Por ello decidimos explorar fuentes alternativas para generar más voltaje.
SEGUNDO PROTOTIPO DE ECOMOCHILA

Realizamos una nueva versión, con las siguientes características:
• Usa un carrito estándar de mochila.
• Incluye un motor eléctrico reversible, usado como dinamo, y una polea en la rueda. Por su mayor diámetro, con cada giro de las ruedas se genera más tensión que en la versión 1, donde se empleaba el eje de las ruedas.
• El asa está recubierta de espuma de poliuretano, que aparte de ser un buen aislante térmico, cobija en su interior una pequeña bolsa de gel refrigerante sobre la que se colocan las placas Peltier. Estas últimas están en contacto con la mano al agarrar el asa, a través de una abertura en la espuma.
• Sobre la mochila se han instalado dos placas solares, como fuente de energía alternativa.
EVALUACIÓN PLACAS PELTIER
Localizamos un componente nuevo para nosotros, la placa Peltier. Esta placa puede invertir su uso y generar voltaje a partir de un gradiente de temperatura. Pensamos que sería interesante explorar su incorporación a la mochila para aprovechar el calor de las manos.
Polaridad de las placas:
Las placas Peltier vienen con dos cables de conexión. Uno rojo, que indicar el ánodo, y uno negro, que corresponde al cátodo. Comenzamos por determinar qué lado de la placa generaba calor y cuál frío, marcando con una “F” el lado frío y con una “C” el caliente. Colocamos el lado marcado “F” en contacto con una bolsa de gel refrigerante y el lado marcado “C” contra la palma de la mano.
31º
410
03
Figura
Generating success – ecomochila
Medición del voltaje de las placas Peltier en función de su configuración
Primero medimos una placa por separado, apoyándola en una bolsa de gel y apretando contra la palma de la mano, mientras medimos el voltaje producido. Posteriormente, se decidió montar dos placas juntas. De esta forma se aprovecha todo el espacio ocupado por la palma de una mano. Se comparó su rendimiento conectadas en serie y en paralelo. Las medidas de voltaje fueron mayores cuando conectamos las dos placas en serie.
DISEÑO DEL CIRCUITO PROPUESTO
El objetivo del circuito es generar una tensión de salida de 5 voltios, adecuado para conectar dispositivos móviles. Cada uno de los generadores empleados, basados en energías alternativas y renovables, quedaba muy por debajo de esos 5 voltios requeridos y tras comprobar que las conexiones en serie realmente aumentan el voltaje final, decidimos unir los componentes en serie.

Tras analizar el trabajo de Reddy (2014), entre otros proyectos “maker”, determinamos que sería útil utilizar un módulo elevador de corriente, que admite voltajes desde 0,9 V y los eleva hasta 5 voltios. Además, este módulo incorpora un puerto USB, lo que lo convierte en un elemento ideal para el objetivo propuesto de cargar dispositivos móviles.

411
Figura 04
Circuito eléctrico en forma de diagrama y componentes.
31º CERTAMEN JÓVENES INVESTIGADORES / Tecnologías e Ingenierías
Por último, se incluye un acumulador, para aquellos momentos en los que no se está cargando ningún móvil, pero se está recibiendo energía: Bien a través de las placas solares, bien porque existe una diferencia de temperatura suficiente para las placas Peltier, o bien porque estamos moviendo la mochila. Este acumulador emplea un módulo integrado TP4056 y una batería de polímero de litio (LiPo). El módulo TP4056 actúa como control de carga, para impedir sobrecargar la batería de Litio, lo que podría provocar explosiones o incendios. TP4056 corta la carga cuando detecta que la temperatura es demasiado alta, o cuando detecta que la batería se ha terminado de cargar. Tiene un cargador mini-USB, por lo que puede conectarse con seguridad a la salida del módulo elevador, usando un cable de cargador normal. Estas conexiones las hemos representado, en forma de diagrama y esquema eléctrico utilizando el software para diseño de circuitos Fritzing.

CONEXIÓN Y SOLDADO DE LOS COMPONENTES
Durante las pruebas, las conexiones se hicieron mediante contacto directo y cinta aislante. Tras obtener resultados prometedores en estas mediciones preliminares, para el prototipo final se decidió soldar todos los componentes entre sí. De esta forma se favorece la estabilidad y durabilidad de las uniones.
PRUEBA Y EVALUACIÓN DEL PROTOTIPO
El último paso en nuestro proceso de innovación tecnológica consistió en la prueba del prototipo. Para ello se empleó un cable cargador USB conectado al módulo elevador de tensión, y a éste se conectó un móvil para determinar si recibía carga. Al desplazar la mochila, se encendió el piloto de alimentación del módulo, así como la pantalla del móvil que se usó para la prueba. De manera que se puede concluir que logramos nuestro principal propósito, que era diseñar una fuente alternativa para cargar nuestros dispositivos sin depender de la red, aprovechando fuentes de energía alternativas y menos contaminantes.
Mochila ochila detenida y móvil sin recibircarga (izda.) y mochila en movimiento, piloto de carga y móvil cargándose (dcha.).

412
Figura 05
RESULTADOS
Dentro de los resultados cuantitativos obtenidos durante nuestra investigación se incluye el voltaje generado por la dinamo en el prototipo final. Para un desplazamiento de la mochila de 2,25 m/s, que corresponde a una velocidad caminando de 8,1 Km/h, se obtuvo un voltaje de 1.40 V. También reseñamos los resultados de las pruebas que se realizaron con las placas peltier, para determinar la mejor configuración para las placas peltier. Usando la bolsa de gel refrigerado como fuente de frío a 0-1 °C, y como fuente de calor la palma de una mano, una placa peltier genera 0.14 voltios. Usando dos placas, en serie se midieron 0.350 voltios (Más que la suma de dos placas individuales, lo que puede deberse a que el gradiente de temperaturas fuera mayor tras estabilizarse el contacto de la placa con el tiempo). En paralelo se obtuvieron 0.170 voltios, de nuevo es mayor que el resultado obtenido con una única placa, lo que sugiere que nuestra explicación anterior puede ser válida.
A pesar de estos valores de tensión tan bajos, se logra una carga suficiente para alimentar un móvil a 5 voltios, lo que probablemente sea gracias a la utilización de un módulo elevador de voltaje.
CONCLUSIONES
Demostramos, gracias a nuestro prototipo, que podemos ser capaces de cargar nuestros móviles sin sobrecargar la red doméstica y empleando recursos energéticos que no son generalmente aprovechados usando un dispositivo que hemos sido capaces de construir con un coste económico muy reducido.
El prototipo desarrollado es, además, técnica y económicamente viable y transferible a prácticamente la totalidad de la población escolar española, ya que las mochilas de ruedas son muy populares.
Generating
– ecomochila 413
success
Esferificaciones de lactasa como tratamiento para la intolerancia a la lactosa: Efectividad de la lactasa inmovilizada sobre dos variables: concentración de alginato de sodio y tiempo transcurrido
/ ACCESIT
AUTOR | JAVIER RODRÍGUEZ CASTELLÓ
COORDINADOR | RODRIGO FERNÁNDEZ PERIÁÑEZ
CENTRO | CC RETAMAR
CIUDAD | POZUELO DE ALARCÓN-MADRID
RESUMEN |
El objetivo de este trabajo es estudiar dos factores que afectan a un tratamiento para la intolerancia a la lactosa basado en la capacidad enzimática de lactasa inmovilizada.
El primer factor es la relación entre la efectividad de la lactasa inmovilizada y la concentración del alginato de sodio, uno de los reactivos utilizados en la inmovilización. El segundo factor es la actividad de la lactasa inmovilizada respecto al tiempo transcurrido.
Basándonos en la teoría encontrada en diversos libros, tesis o artículos científicos, decidimos la línea metodológica a adoptar. Primero inmovilizamos la lactasa utilizando diversas concentraciones de alginato de sodio y medimos su actividad catalítica midiendo la glucosa producida en la hidrolisis de la lactosa. En segundo lugar, medimos la actividad enzimática de la enzima inmovilizada durante una semana para determinar la efectividad en el tiempo.
Los resultados nos indicaron una correlación positiva entre la actividad enzimática y la concentración de alginato de sodio, teniendo la mayor capacidad enzimática las lactasas inmovilizadas con 2% de alginato de sodio. Los resultados con la variable del tiempo transcurrido nos indicaron que la duración útil de las esferificaciones con nuestro método es de 4 días, aunque la efectividad se reduce de forma significativa con el paso del tiempo. Esta es una de las principales limitaciones de este método, por lo que sería conveniente seguir investigando para hallar un método que permita alargar la vida útil.
TECNOLOGÍAS E INGENIERÍAS 414
ABSTRACT |
The objective of this work is to study two factors that affect a treatment for lactose intolerance based on the enzymatic capacity of immobilized lactase.
The first factor is the relationship between the effectiveness of immobilized lactase and the concentration of sodium alginate, one of the reagents used in the immobilization. The second factor is the effectiveness of immobilized lactase with respect to the time elapsed since its immobilization.
Based on theory found in various books, we decided the methodological line to adopt. First, we immobilized the lactase using different concentrations of sodium alginate and we measured its catalytic activity by measuring the glucose produced in the hydrolysis of the lactose. Secondly, we measured the enzymatic activity of the immobilized enzyme for a week to determine the enzymatic effectiveness over time
The results indicated a positive correlation between the enzymatic activity and the concentration of sodium alginate, having the highest enzymatic capacity the lactases immobilized with 2% sodium alginate. The results with the variable of the time elapsed indicated that the useful duration of the spherifications with our method is 4 days, although the effectiveness is significantly reduced with the passage of time This is one of the main limitations of this method, so it would be convenient to continue the research to find a method that allows to extend the useful time
415
CERTAMEN JÓVENES INVESTIGADORES / Tecnologías e Ingenierías
TRABAJO DE INVESTIGACIÓN
A pesar de que en España la intolerancia a la lactosa solo afecta a una minoría, la realidad es que 2/3 de la población mundial es intolerante a la lactosa. Esto es debido a una disminución de los niveles de lactasa tras la lactancia que se pueden producir tanto de forma natural (deficiencia primaria de lactasa) como de forma accidental (deficiencia secundaria de lactasa) (Deng, et al., 2015, pp 8020-8035). En cualquiera de los dos casos, los síntomas afectan gravemente al sistema digestivo (cólicos, distensión abdominal, diarrea, etc.)
Por esta razón, mi investigación busca desarrollar un método que facilite la ingesta de productos lácteos mediante el uso de lactasa inmovilizada, la cual permite eliminar la lactosa de los alimentos mediante su hidrólisis. De esta forma, los intolerantes a la lactosa pueden consumir productos lácteos y disfrutar de todos sus beneficios sin preocuparse por su intolerancia.
Para realizar esta investigación ha sido necesario un estudio de la lactasa y de los diferentes métodos para mejorar su acción.
La lactasa presenta una actividad metabólica basada en la ruptura del disacárido lactosa en sus componentes glucosa y galactosa, hidrolizando su enlace glucosídico. Esta actividad la engloba en la familia de las enzimas disacaridasas.

La lactosa se conoce también como el azúcar de la leche, ya que la encontramos al 28% en peso de la leche. Los cachorros de los mamíferos, para digerir esta leche, segregan por sus vellosidades intestinales la lactasa, permitiendo la ruptura de la lactasa y facilitando así la absorción de los monosacáridos, glucosa y galactosa.
Esta producción de lactasa disminuye en los mamíferos al finalizar la lactancia debido a la ausencia de un consume continuada de leche (Vitoria enero-junio 1999, pp 18-23). En los seres humanos, la actividad lactasa intestinal es máxima en el momento del nacimiento y tras los primeros meses de vida, la actividad lactasa comienza a disminuir. En la mayoría de las personas, esta actividad se reduce hasta niveles indetectables como consecuencia de la inhibición de la expresión de la lactasa.
31º
416
Figura 01
Hidrólisis de la lactosa por el efecto de la lactasa. (Leskomono, et al., 2018.)
Esferificaciones de lactasa como tratamiento para la intolerancia a la lactosa: Efectividad de la lactasa inmovilizada sobre dos variables: concentración de alginato de sodio y tiempo transcurrido
La falta de lactasa produce un trastorno metabólico conocido como intolerancia a la lactosa. Las personas afectadas por este trastorno sufren una malabsorción de la lactosa tras su ingestión permitiendo su llegada al colon, donde es fermentada por bacterias colónicas que generan gases y provocan cólicos, distensión abdominal, diarrea o estreñimiento, entre otras.
Las personas que, a pesar de ser intolerantes, no pueden evitar su consumo o deciden consumir lácteos, pueden servirse de alimentos “sin lactosa” (alimentos que han sido tratados de forma previa con lactasa), o directamente suplementos de la enzima lactasa para poder absorber la lactosa correctamente (Massimo, et al, 2006, pp. 187-191). En cualquier caso, el tratamiento con lactasa permite una reducción significativa de los síntomas de la intolerancia a la lactosa (He, et al., 1999, pp. 309-311).
Pero la enzima es, como ya he mostrado anteriormente, sensible a los ambientes ácidos y a las altas temperaturas, lo que podría disminuir su eficacia.
Para disminuir la sensibilidad de la enzima se suele inmovilizar. Una enzima inmovilizada es una enzima que se ha englobado en un material inerte e insoluble. Entre otros beneficios:
• La inmovilización aumenta la estabilidad de las enzimas ante los cambios de temperatura y pH, con lo que se reduce la tasa a la que se degradan y han de ser reemplazadas.
• Permite la separación de la enzima de la mezcla de la reacción y permite su reutilización, por lo que es un proceso más eficiente y económico y, por ello, es ampliamente utilizada en la industria para las reacciones catalizadas por enzimas (Allot A, 2015, pp. 104-113).
Como desventaja, supone una reducción del rendimiento enzimático, pues el sustrato tiene que atravesar la sustancia inmovilizadora.
Entre los métodos de inmovilización enzimática encontramos su atrapamiento en esferas de alginato de calcio (esferificación), que es uno de los métodos más simples. Este método de atrapamiento es rápido, seguro, barato y versátil.
La esferificación se debe a la gelificación de la solución debido a la unión entre moléculas de alginato con los iones de calcio. Todas las uniones que se producen entre las cadenas de moléculas del alginato y los átomos de calcio se disponen formando una malla con forma de “caja de huevos” (Diaz, 2015). El alginato es un polisacárido natural derivado de la pared celular de las algas pardas. Estructuralmente, el alginato es un polisacárido lineal formado a partir de dos monómeros de ácidos urónicos β-D-manuronato (M) y α-L-guluronato (G), unidos por enlaces glucosídicos beta y alfa (1-4).
417
El otro compuesto que interviene en la gelificación es la solución de calcio. Generalmente se usa el cloruro de calcio (CaCl2) ya que es un gran donador de iones de calcio, permitiendo una esferificación casi instantánea.
El alginato de calcio es una sustancia gelatinosa e insoluble en agua que se crea mediante la reacción del alginato de sodio y el cloruro de calcio. Se obtiene al añadir la solución de alginato de sodio sobre la solución de cloruro, produciéndose una polimerización y la precipitación de las esferas de alginato seguida de una gelificación gradual del interior según penetren los iones de calcio. Por tanto, el ritmo de gelificación depende de la cantidad de iones de calcio y del alginato. El gel resultante es inerte bioquímicamente y estable mecánicamente, presentando espacios intersticiales adecuados para la inmovilización enzimática.
“La conformación proteica tiene un rol crucial al determinar la eficiencia catalítica de las enzimas. Inevitablemente, la inmovilización altera el ambiente natural enzimático al reducir la accesibilidad al centro activa perdido de las propiedades enzimáticas y la alteración de la conformación integral de la enzima”. (Secundo, 2013, pp. 6250-6251).
HIPÓTESIS DE TRABAJO Y OBJETIVOS DE LA INVESTIGACIÓN
El objetivo de esta investigación es estudiar independientemente la efectividad de la enzima según dos variables, la concentración de alginato de sodio y el tiempo transcurrido desde la inmovilización de la lactasa.
El primer factor afectará a la propia inmovilización de la enzima, ya que afecta a la gelificación de la esfera, como ya se ha explicado en la introducción. La concentración de alginato de sodio esta medida en % masa/ volumen y he realizado el procedimiento con 5 concentraciones de alginato de sodio, desde 0% hasta 2%, en intervalos de 0,5%. Es importante mencionar que en la concentración de 0% tan solo mediré la actividad enzimática de la lactasa en un medio con lactosa, es decir mediré la efectividad de la enzima lactasa sin inmovilizar.

31º CERTAMEN
418
JÓVENES INVESTIGADORES / Tecnologías e Ingenierías
Figura 02
Modelo caja de huevos.
Esferificaciones de lactasa como tratamiento para la intolerancia a la lactosa: Efectividad de la lactasa inmovilizada sobre dos variables: concentración de alginato de sodio y tiempo transcurrido
El segundo factor, la efectividad de la enzima en el tiempo, permitirá comprobar cuántas veces es posible reutilizar la enzima una vez inmovilizada. Estas mediciones fueron realizadas cada dos días hasta que la actividad enzimática dejó de ser mensurable.
Para estudiar estar variables independientes, mediremos la variable dependiente, el resultado obtenido en los experimentos, que será siempre la efectividad de la enzima lactasa indicada como concentración de glucosa en mg/dl a diversos tiempos, ya que la glucosa es uno de los productos finales de la reacción enzimática y la pude determinar con un medidor de glucosa comercial como el que utilizan los pacientes de diabetes para su control diario.
Para poder alcanzar estos objetivos debemos tener en cuenta las variables controladas: los tiempos en los que la enzima estaba reaccionando, pues al ser un estudio comparativo de la efectividad entre las distintas enzimas inmovilizadas es fundamental que estas hayan estado actuando el mismo tiempo. Otras variables controladas son la concentración del cloruro de calcio en la reacción de gelificación, la concentración de lactasa, pues la enzima es la que permite la reacción, y la concentración de lactosa, temperatura y pH, pues afectan a la actividad enzimática.
Mi hipótesis en cuanto a la concentración de alginato es que, como a mayor concentración más rápido se realizará la gelificación de la esfera, menos enzimas se perderán en el medio de cloruro de calcio y, por tanto, las esferas con mayor concentración tendrán mayor efectividad porque habrán perdido menos enzimas. Además, debido a que la inmovilización provoca una pérdida de la efectividad, las enzimas libres en el medio de lactosa tendrán una mayor actividad catalítica.
Respecto a la efectividad de la enzima en el tiempo, creo que su efectividad bajará con el paso del tiempo debido a que las enzimas, a pesar de que no se consumen en las reacciones, terminan degradándose. Por esto, hipotetizo que la efectividad de la enzima inmovilizada se reducirá drásticamente con el paso del tiempo.
MATERIALES Y MÉTODOS
Enzima lactasa liquida (Ref. 12415, BioCare) (70 unidades /ml)
Alginato de sodio (E-401) (Ref.14021, Innovative cooking SL)
Cloruro de calcio (E-509) (Ref. 14018, Innovative cooking SL)
Lactosa
Agua destilada
Medidor de glucosa SD Codefree Meter (SD Biosensor) (Rango 10-600 mg/dl) (±15% mg/dl)
419
31º CERTAMEN JÓVENES INVESTIGADORES / Tecnologías e Ingenierías
Vasos de precipitados (100 y 250 ml)
Matraz Erlenmeyer (100 ml)
Probeta (100 ml)
Cuentagotas
Micropipeta
Cronómetro
Balanza electrónica (Mettler Toledo PG2002) (±0,01 g)
PROCEDIMIENTOS
Inmovilización de lactasa con serie de concentraciones de alginato de sodio:
1. Preparamos las diferentes concentraciones de alginato de sodio (0,5%; 1%, 1,5%; 2%). Para ello mezclamos 0,5 ± 0,01 g de alginato de sodio con 25 ± 0,5 ml de agua destilada en un matraz Erlenmeyer consiguiendo una disolución al 2%.
2. Ahora preparamos 8 ± 0,5 ml de alginato con distintas concentraciones. Para preparar la de 2%, tan solo tomamos 8 ± 0,5 ml, ya que la disolución que hemos preparado está a esa concentración.
3. Para las concentraciones de 1,5%, 1% y 0,5%, añadimos 6, 4 y 2 ml de alginato y añadimos agua destilada hasta los 8 ml.
4. Una vez realizadas las concentraciones añadiremos 2 ml de lactasa con una micropipeta a los 8 ml de las disoluciones. Obtendremos así, 10 ml de una disolución de lactasa y alginato.
5. Para preparar la disolución de cloruro de Calcio, diluimos 1,5 g de cloruro de calcio en 100 ml de agua destilada, para obtener una disolución al 15%.
6. Con un cuentagotas, añadimos la disolución de alginato-lactasa, a un vaso de precipitados que contenga la disolución de cloruro de calcio.
7. Tras 1 minuto, retiramos las esferificaciones que se habrán formado (aproximadamente realizamos 60 esferificaciones). Repetimos el mismo procedimiento con las demás concentraciones.
Comprobación de la efectividad enzimática
8. Preparamos 500 ml de disolución de lactosa con una concentración de lactosa al 70% añadiendo 35 g de lactasa a 500 ml de agua.
9. Dividimos las esferas de concentración al 2% entre 3 e introducimos cada porción en un vaso con 20 ml de la disolución de lactosa.
10. Al mismo tiempo iniciamos un cronometro que medirá el tiempo que llevan catalizando las enzimas. Repetimos este paso con las esferas de las demás
420
Esferificaciones de lactasa como tratamiento para la intolerancia a la lactosa: Efectividad de la lactasa inmovilizada sobre dos variables: concentración de alginato de sodio y tiempo transcurrido
concentraciones.
11. Medimos con el medidor de glucosa cuando han transcurrido 15, 30, 45 y 60 minutos.
12. Al mismo tiempo, en otros 3 vasos de precipitados añadimos 0,67 ml de lactasa (2 ml entre 3, para que tenga la misma proporción que las esferas) directamente a los 20 ml de lactosa.
13. En los minutos 15, 30, 45 y 60 minutos medimos la glucosa con los medidores. Efectividad en el tiempo
14. Cuando ha transcurrido una hora, colamos las esferas con la concentración del 2% y las almacenamos en la nevera en recipientes de cristal con agua para conservarlos.
15. Tras dos días, volvemos a introducir las esferas en una disolución de lactosa. Tras una hora, medimos la glucosa con el medidor de glucosa.
16. Repetimos este paso cada 2 días hasta que la actividad enzimática es nula.
RESULTADOS
Tabla 01
Concentración de Glucosa respecto al Alginato de Sodio y al tiempo

421
31º CERTAMEN JÓVENES INVESTIGADORES / Tecnologías e Ingenierías
Concentración Glucosa dependiendo de tiempo y concentraciones de Alginato de sodio.
Gráficamente estos datos:


Los resultados de la concentración de glucosa frente al tiempo en días.

422
Figura 03
Figura 04 n [Glucosa] frente a días transcurridos.
Esferificaciones de lactasa como tratamiento para la intolerancia a la lactosa: Efectividad de la lactasa inmovilizada sobre dos variables: concentración de alginato de sodio y tiempo transcurrido
DISCUSIÓN
Apoyándome en la teoría recogida en la investigación, discutiré los resultados obtenidos.
En el primer gráfico, podemos ver un aumento de la efectividad a medida que aumenta la concentración de alginato de sodio, exceptuando la enzima libre (0%). Explicado teóricamente esto se debe a que, a menor concentración de alginato de sodio, hay una menor inmovilización de la lactasa y por tanto esta se puede escapar de las esferas. Si la enzima lactasa se escapa en el proceso de gelificación de las esferas, obtenemos esferas con menores cantidades de enzima y por tanto esferas con menor actividad enzimática, como se ve en el gráfico.
Es necesario mencionar que debido a que las bandas de confianza que aparecen en el gráfico de las concentraciones de 1,5% y 2% se solapan, estos resultados no son válidos y por tanto no se puede hacer una distinción entre esas concentraciones. En cambio, sí que se puede sacar conclusiones de las demás concentraciones, ya que las desviaciones típicas no se solapan.
En cuanto a la efectividad en el tiempo de la enzima, podemos comprobar que, aunque la enzima no se consume en las reacciones que cataliza y por tanto se puede reutilizar, también termina degradándose como cualquier proteína. Esta es la razón de porque en los resultados obtenidos vemos una reducción drástica de la actividad enzimática, que se vuelve insignificante a partir del día
4. Además, el gráfico nos muestra que la decadencia enzimática con el tiempo sigue un decrecimiento exponencial. Esto se puede deducir porque el eje y, está expresado en forma logarítmica.
Como en cualquier investigación, en este trabajo hay limitaciones que han impedido obtener unos resultados libres de errores. Estas limitacinoes se pueden dividir en limitaciones materiales y limitaciones personales.
Las limitaciones materiales han condicionado mi experimentación desde el momento inicial. Solo disponía de 15 ml de lactasa, por lo que me he enfocado exclusivamente en un único aspecto de la esferificación, prescindiendo por tanto de variar la concentración de cloruro de calcio. Esta limitación, también me ha impedido realizar las variaciones de concentración de alginato al nivel de precisión deseado.
En cuanto a las limitaciones personales podemos incluir la incapacidad para asegurar una misma cantidad de enzima inmovilizada pues durante la inmovilización tuve que aproximar la cantidad inmovilizada.
Tomando en cuenta estas limitaciones, podemos establiecer una línea de mejor en diversos aspectos. Con el uso de micropipetas, podemos controlar la canti-
423
CERTAMEN JÓVENES INVESTIGADORES / Tecnologías e Ingenierías
dad de lactasa añadida y el número de lactasa por esferificación. Adicionalmente, contando con una mayor cantidad tanto de lactasa como de tiras de glucosa podemos concretar la concentración óptima de alginato de sodio.
CONCLUSIONES
Hay un incremento general de la actividad enzimática de las enzimas inmovilizadas cuanto mayor sea la concentración de alginato de sodio. Las esferas con una concentración de alginato al 2% presentan una mayor actividad enzimática que las esferificaciones con menor concentración, aunque la lactasa sin inmovilizar es significativamente menos efectiva.
La efectividad enzimática en el tiempo ha mostrado un descenso abrupto de la actividad enzimática entre las medias de las primeras y segundas mediciones (202 mg/dl a 35 mg/dl), al cabo de dos días, y otro descenso de la actividad en la media de la tercera medición (7,6 mg/dl). Estos datos permiten concluir que aunque la inmovilización con alginato de sodio permite la reutilización de la enzima y ayuda a estabilizarla, la poca efectividad en el momento y en su reutilización son defectos demasiados severos como para ser un método viable. Por tanto, aunque la inmovilización enzimática es una idea prometedora, es necesario una labor investigadora para hallar un método para afrontar los defectos descritos.
AGRADECIMIENTOS
En primer lugar, debo agradecer a mi profesor coordinador Rodrígo Fernández Periáñez por dirigir, corregir, acompañarme y apoyar al trabajo y a mí hasta el final. Al Colegio Retamar tanto por las instalaciones como por el material necesario, además de todos aquellos profesores que trabajaron en mi formación como Enrique Robles, Javier García de Herreria y Eduardo Díaz. Al Dr. Garcimartín Montero y al Dr. Montuenga. A mis amigos Carlos Tejedor, Iñigo Rios y Andres Pelayo, sin los cuales nunca habría salido este trabajo. Por último, a mi familia, especialmente a mi hermano Mateo por ser mi inspiración.
31º
424
Esferificaciones de lactasa como tratamiento para la intolerancia a la lactosa: Efectividad de la lactasa inmovilizada sobre dos variables: concentración de alginato de sodio y tiempo transcurrido
BIBLIOGRAFÍA:
Deng, Y., Misselwitz, B., Dai, N. & Fox, M., 2015. Lactose Intolerance in Adults: Biological Mechanism and Dietary Management. Nutrients, 7(9), pp. 80208035.
He, M., Yang., Y., Bian, L. & Cui, H., 1999. Effect of exogenous lactase on the absorption of lactose and its intolerance symptoms (in Chinese). Journal of Hygiene Research, 30 September, 28(5), pp. 309-311.
Leskomono, C. S. et al., 018. Measuring Lactase Enzymatic Activity in the Teaching Lab. Journal of Visualized experiments, Volume 138.
Marianne Wolfa, L. A. B. E. B. T. A. T. P., 2019. Production of low-dosage lactose milk using lactase immobilised in hydrogel. International Dairy Journal, mayo, Volume 92, pp. 77-83.
Massimo, M., Curigliano, V. & Santo, L., 2006. Management and treatment of lactose malabsorption. World Journal of Gastroenterology, 14 January, 12(2), pp. 187-191.
Secundo, F., 2013. Conformational changes of enzymes upon immobilisation. Chemical Society Reviews, pp. 6250-6251.
Vitoria, J., enero-junio de 1999. Intolerancia a la lactosa. BOL. S VASCO-NAV PEDIATR, Volumen 33, pp. 18-23.
425
CIENCIAS FÍSICAS, QUÍMICAS Y MATEMÁTICAS
PREMIO ESPECIAL DEL CERTÁMEN DE JÓVENES INVESTIGADORES |
- 429 -
Levitación acústica
NADIA WERONIKA BRZOSTOWICZ
SEGUNDO PREMIO |
- 440- 450 -
Construcción de un detector de muones cósmicos MIGUEL MARTÍN GONZÁLEZ, DANIEL MONTESINOS CAPACETE Y ADRIÁN FERNÁNDEZ TORRES
Cálculo del mínimo número de cuadrados que teselan un rectángulo de lados enteros PABLO SOTO MARTÍN
TERCER PREMIO Y PREMIO ESPECIAL REAL SOCIEDAD DE FÍSICA |
- 465 -
Estudio espectrofotométrico de fuentes de luz artificiales y de la luz solar JAVIER SÁNCHEZ-BONILLA MARTÍNEZ Y JUAN ÁLVAREZ ORDINAS
TERCER PREMIO |
- 476 -
¿En qué medida la geometría de los imanes y la separación entre ellos afecta a la velocidad de salida de un acelerador magnético (cañón de Gauss)?
ESTHER REVENGA VILLAGRA
- 493 -
Estudio del tratamiento tradicional del caqui “rojo brillante”: ¿Cuál es la relación entre la graduación del alcohol utilizado para el tratamiento y el tiempo requerido para eliminar la astringencia?
SOFÍA LLÀCER CARO
427
Levitación acústica
/ PREMIO ESPECIALDEL CERTAMEN JÓVENES INVESTIGADORES
AUTORA | NADIA WERONIKA BRZOSTOWICZ
COORDINADORA | HELENA RUBIO FRANCO
CENTRO | IES PALAS ATENEA
CIUDAD | TORREJÓN DE ARDOZ-MADRID
RESUMEN |
En este proyecto, se investiga el fenómeno de la Levitación Acústica utilizando tractores de una y dos matrices. El objetivo principal de este proyecto de investigación, basado en las investigaciones del Doctor Asier Marzo, es probar la efectividad de este método y explorar sus posibles aplicaciones en diversas áreas.
ABSTRACT |
In this project, the phenomenon of Acoustic Levitation is investigated using one and two-matrix tractors. The main objective of this research project, based on the research of Doctor Asier Marzo, is to test the effectiveness of this method and explore its possible applications in various areas
MATEMÁTICAS 429 REPRESENTANTE DE ESPAÑA EN LA XXXI CONVOCATORIA DEL CERTAMEN EUROPEO DE JÓVENES INVESTIGADORES 2019
CIENCIAS FÍSICAS, QUÍMICAS Y
30º CERTAMEN JÓVENES INVESTIGADORES / Ciencias Físicas, Químicas y Matemáticas
1. INTRODUCCIÓN
La levitación de objetos ha suscitado desde hace décadas un gran interés por parte de la comunidad científica. La levitación acústica, en concreto, a pesar de ser una técnica relativamente reciente, ofrece un amplio abanico de posibilidades, diversidad de condiciones experimentales y muestras. El objetivo de este proyecto de investigación es el de analizar la tecnología de levitación acústica tanto desde un punto de vista tanto teórico como práctico, construyendo dos dispositivos de levitación acústica, basados en los trabajos desarrollados por Asier Marzo, Doctor en Ingeniería Informática de la Universidad Pública de Navarra [1].
2. ESTADO DE LA CUESTIÓN
2.1. LIMITACIONES
La levitación acústica permite manipular cualquier tipo de muestra, de cualquier material y densidad [2]. Sin embargo, esta técnica tiene limitaciones. Las partículas deben ser estrictamente menores a media longitud de onda. Puesto que las ondas menores a 20 kHz entrarían en el espectro audible para el ser humano, emitir ondas de frecuencia menor a 20 kHz resulta peligroso para la audición, debido a la elevada intensidad de las ondas. Dada la ecuación de la longitud de onda: λ = c/f, donde λ es la longitud de onda en metros, c es la velocidad de propagación del sonido en el aire (344m/s) y f es la frecuencia en Hz, se obtiene que la mayor longitud de onda que se puede obtener es de 0,0172 m. Por lo tanto, 8,6 mm es el máximo tamaño de partículas que pueden ser levitadas con esta técnica (λ/2).
2.2. APLICACIONES
Dependiendo de propiedades físicas de las muestras a levitar, estas pueden moverse a nodos de presión acústica (regiones donde la presión es mínima), o antinodos de presión (donde esta es máxima). De esta forma es posible manipular pequeñas muestras, controlando la posición de los nodos de presión, lo que permite que las técnicas de levitación acústica tengan aplicaciones en áreas que van desde la biología, la medicina y la farmacología (manipulación de organismos mediante transductores interdigitales o IDTs, que emplean ondas acústicas superficiales, SSAW, cristalización amorfa de medicamentos en suspensión acústica, la espectroscopía de fuerza acústica) hasta la ingeniería (cristales líquidos dispersos en polímeros, PDLCs, orientados mediante ondas acústicas).
3. HIPÓTESIS Y OBJETIVOS
Mediante este trabajo se tratará de analizar desde un punto de vista teórico y práctico el fenómeno de la levitación acústica. Para ello se pretende construir dos levitadores acústicos cuyo principio de funcionamiento difiera debido a
430
Levitación acústica la disposición de los transductores. Esto permitirá analizar su capacidad para mantener muestras en suspensión, sometiéndolos a una serie de pruebas. La hipótesis de este trabajo consiste, en la realización de levitadores simples y efectivos, cuyo rendimiento sea independiente de las condiciones externas. Además, se pretende realizar una serie de experimentos físicos y químicos para visualizar las propiedades y posibilidades de la levitación acústica, así como analizar las aplicaciones actuales de esta tecnología en diferentes áreas de la ciencia.
13: Li, S., Ma, F., Bachman, H., Cameron, C., Zeng, X. and Huang, T. (2017). Acoustofluidic bacteria separation .



4. MÉTODOS Y MATERIALES
4.1. ANÁLISIS TEÓRICO
14: NASA Technical Reports Server (NTRS) - Microgravity Science and Applications Program Tasks, 1984 Revision. 2018. NASA Technical Reports Server (NTRS)Microgravity Science and Applications Program Tasks, 1984 Revision. [ONLINE]
4.1.1. LEVITACIÓN CON DOS MATRICES
Available at:https://ntrs.nasa.gov/search.jsp?R=19860000586.[Accessed 23 Jul. 2018]
16: Ding, X., Lin, S., Kiraly, B., Yue, H., Li, S., Chiang, I., Shi, J., Benkovic, S. and Huang, T. (2012). On-chip manipulation of single microparticles, cells, and organisms using surface acoustic waves. Proceedings of the National Academy of Sciences, 109(28), pp.11105-11109.

Imágenes 1-7: https://aip.scitation.org/doi/full/10.1063/1.4972407 Última consulta: septiembre 2018.8-9, Imágenes 11-16: Autoría propia.
Imagen 10: https://www.instructables.com/id/Acoustic-Tractor-Beam/
8. IMÁGENES
La levitación acústica de partículas en dispositivos con dos matrices provistas de transductores es posible gracias a la fuerza de radiación acústica producida por una onda estacionaria. Para que la levitación se produzca, necesitamos que la partícula a levitar esté a una distancia múltiplo de media longitud de onda, es decir L= n (λ/2) = n (c/2f) donde n = 1, 2, 3 ... es un número entero, c es la velocidad de propagación de la onda, f es la frecuencia y λ es la longitud de onda. En este proyecto, concretamente, se presenta un levitador de un solo eje de levitación y compuesto por dos matrices con 72 transductores electroacústicos piezoeléctricos. Las partículas quedan atrapadas en los nodos de la onda
estacionaria. La imagen 2 muestra el campo de presión de una onda estacionaria, producida invirtiendo la polaridad en cada matriz. Es este tipo de campo de presión con el que se realizarán todos los experimentos y pruebas relacionados con el levitador de dos matrices. Sin embargo, si se invierte la polaridad en cada mitad de la matriz, como se representa en la imagen 3 (polaridades opuestas de los transductores marcadas en cada mitad de matriz, en azul y rojo) esta genera una trampa gemela (imagen 4) compuesta por dos regiones de alta presión con una región de baja presión entre ambas, creando unas “pinzas acústicas“ que sujetan la partícula desde los lados. Las trampas acústicas serán explicadas más
431
Imagen 1: Campo de amplitud Los puntos Imagen 2 Imág. 3, 4 y 5 verdes representan los nodos de la onda estacionaria
CERTAMEN JÓVENES INVESTIGADORES / Ciencias Físicas, Químicas y Matemáticas
a fondo en la levitación con una sola matriz, pues en este modelo se utilizará únicamente el campo de presión de la onda estacionaria. El punto verde indica la posición de los nodos de presión, y la línea azul discontinua en la imagen 3 indica el plano de las imágenes 2 y 4.
4. 1. 2. LEVITACIÓN CON UNA MATRIZ
En los tractores de dos matrices, la partícula queda atrapada en los nodos de la onda estacionaria, formada por superposición de las ondas provenientes de los transductores de las matrices opuestas. Los sitios donde la muestra levita se denominan trampas. En el caso del levitador anterior, estas estaban dispuestas sobre el eje central del levitador, coincidiendo a su vez con los mínimos de presión de la onda estacionaria (nodos). Si el levitador es de una sola matriz, no se utilizan ondas estacionarias, y existen distintos tipos de trampas capaces de levitar muestras. Estas trampas acústicas se realizan ajustando la modulación de los transductores, y se pueden analizar en función del origen de las fuerzas ejercidas. Estas son las fuerzas de radiación, que se pueden generar por gradientes de presión (amplitud) y por gradientes de velocidad. Para analizar estas trampas, un equipo de investigadores de la Universidad Pública de Navarra (UPNA) dirgido por el Doctor en Informática Asier Marzo [1], desarrolló un novedoso método utilizando elementos acústicos holográficos. Esto es, obtener un holograma de la trampa, obteniendo una imagen de esta que es invariable a la posición de levitación, y se basa en los gradientes de velocidad y presión. Se ha conseguido representar los tres tipos de trampas realizados por este equipo mediante hologramas acústicos en forma de pinzas (twin traps), en forma de tornado o vórtice (vortex traps) y en forma de botella (bottle traps) (imágenes 5, 6 y 7). Las trampas transfieren el momento angular orbital a la partícula levitada en la misma dirección en la que son rotadas. Si la mitad de la matriz es excitada fuera de fase, se producen las trampas gemelas; si un círculo central es excitado fuera de fase, se produce una trampa en forma de botella; y si se impone una rampa de fase helicoidal (es decir, progresivamente recorrer todo el espectro de modulaciones de fase, desde -π hasta +π en todos los transductores de la matriz) resulta en una trampa de vórtice. En este levitador, excitando cada mitad de los transductores de la matriz en fases opuestas, se generan trampas gemelas, con las que se llevará a cabo todas las pruebas de rendimiento, fuerza de captura y resistencia a las condiciones de temperatura y humedad.
El sistema de levitación acústica con dos matrices (ANEXO I) está compuesto por un panel de control y un levitador de un solo eje con 72 transductores (Manorshi, MSO-A1640H10T) dispuestos en dos matrices, cada una con 36
432
30º
4. 2. CONSTRUCCIÓN Y ANÁLISIS PRÁCTICO
4. 2. 1. LEVITACIÓN CON DOS MATRICES
4. 2. 1. 1. Circuito electrónico
transductores (imagen 8, primer diseño). En cada matriz, de 15’6 cm de radio hay 3 anillos de 6, 12 y 18 transductores. Para construir el panel de control se emplean elementos eléctricos de bajo precio y comercialmente disponibles. Se utiliza ondas cuadradas como la señal de excitación ya que son algo más fáciles de generar digitalmente en comparación con las ondas sinusoidales. Aplicar ondas cuadradas es una práctica común ya que los transductores tienen un comportamiento resonante, y por ello la salida es casi sinusoidal. Utilizando un voltaje de 9V de CC (corriente continua) controlado por un interruptor se alimenta un Driver (controlador) L297N Dual H-Bridge para suministrar una
en suspensión
levitadas con el vo ltaje mínimo necesario para mantenerlas
Imagen 08
Mapa de conexiones del levitador de dos matrices con placa Arduino Nano.
Imagen 11: Gráfica que relaciona la densidad de las muestras
Imagen 12
Imagen 09
Imagen 13
Mapa de conexiones del levitador de dos matrices, tras el cambio de placa y montaje del potenciométro y leds.
m atrices con placa Arduino Nano. de una matriz
14: NASA Technical Reports Server (NTRS) Microgravity Science and Applications Program Tasks, 1984 Revision. 2018. NASA Technical Reports Server (NTRS)Microgravity Science and Applications Program Tasks, 1984 Revision. [ONLINE]
Available at: Accessed 23 Jul. 2018]
16: Ding, X., Lin, S., Kiraly, B., Yue, H., Li, S., Chiang, I., Shi, J., Benkovic, S. and Huang, chip manipulation of single microparticles, cells, and organisms using surface acoustic waves. Proceedings of the National Academy of Sciences, 109(28), pp.11105
Imagen 8 : Mapa de conexio nes del levitador de dos
Imágenes 1 https://aip.scitation.org/doi/full/10.1063/1.4972407 Última consulta: septiembre 2018.8
16: Autoría propia.
Imagen 10: https://www.instructables.com/id/Acoustic-Tractor-Beam/

8. IMÁGENES
tensión de 5V a una placa Arduino Nano. La placa Arduino Nano se programa (ANEXO II) para generar señales de onda cuadrada de 5 V y a continuación amplificarlas en el Driver para obtener 12 V que permitan que los transductores piezoeléctricos generen una frecuencia de 40 kHz. Uno de los dos canales que alimenta las matrices se mantiene en fase constante, mientras que la fase del otro canal (el de la matriz opuesta) se invierte con respecto a la primera para generar la onda estacionaria. Una vez finalizada la construcción del levitador, se procede a la construcción de una carcasa (ANEXO III), utilizando una lámina de aglomerado de madera de 5mm, entre cuyas funciones figuran la protección de los componentes electrónicos y el sostén del levitador. Además, utilizando un convertidor Boost CC-CC, 4 LEDs (2 de luz blanca y 2 de UV), otro interruptor de dos posiciones y un potenciómetro de 20 kΩ se consigue la efectiva regulación del voltaje con el que se alimenta el (Imagen 9, diseño definitivo).


Imagen 10 : Mapa de conexiones del levitador
Imagen 1:
Imagen 2
Imág. 3, 4 y 5 verdes representan los nodos de la onda estacionaria
Imagen 9: Mapa de conexiones del levitador de dos matrices, tras el cambio de placa y montaje del potenciómetro y leds.
Levitación acústica 433
13: Li, S., Ma, F., Bachman, H., Cameron, C., Zeng, X. and Huang, T. (2017). Acoustofluidic
30º CERTAMEN JÓVENES INVESTIGADORES / Ciencias Físicas, Químicas y Matemáticas
Imagen 8: Mapa de conexiones del levitador de dos Imagen 10: Mapa de conexiones del levitador matrices con placa Arduino Nano. de una matriz
La principal medida de rendimiento del levitador es la densidad máxima de las partículas que puede levitar. Si las partículas están en el régimen de dispersión de Rayleigh (es decir, más pequeño que la mitad de la longitud de onda), entonces la fuerza de captura es proporcional al volumen, por lo que solo la densidad limita las muestras que pueden ser levitadas. Para medir el rendimiento del levitador experimentalmente se colocaron muestras de densidades variadas en el levitador, conectado a una fuente de alimentación de corriente continua (EP613A DC) que permitía ajustar los voltajes de entrada. Partiendo de un voltaje de 9 V en cada muestra levitada, este se comenzaba a reducir paulatinamente hasta que la muestra caía fuera de la trampa. El gráfico (imagen 11) se ha realizado para visualizar la relación entre la densidad de las muestras y el voltaje
Imagen 11: Gráfica que relaciona la densidad de las muestras Imagen 12 Imagen 13 levitadas con el voltaje mínimo necesario para mantenerlas en suspensión


Arduino Nano. de una matriz
Imagen 11
Gráfica que relaciona la densidad de las muestras levitadas con el voltaje mínimo necesario para mantenerlas en suspensión.
Imagen 16
9. ANEXO
Imagen 14
Imagen 15
Imagen 11: Gráfica que relaciona la densidad de las muestras Imagen 12
Imagen 13 levitadas con el voltaje mínimo necesario para mantenerlas en suspensión
Imagen 16
Dado el formato de la mayoría de anexos (.stl, .ino, .mp4) se ha creado un enlace a una carpeta en Google Drive en la cual se han incluido todos los anexos:
https://drive.google.com/drive/u/0/folders/1z_axBFMarj9lTuJGdl3tFlhpUEDp9jzw
Imagen 14 Imagen 15
9. ANEXO
Imagen 16
mínimo necesario para que estas leviten. Se han representado 6 muestras de diferentes densidades junto a sus respectivos voltajes. Ordenadas de menor a mayor densidad son: Alcohol etílico 98% (nº1), agua (nº2), poliestireno (nº3), silicona (nº4), magnesio (nº5) y aluminio (nº6). Se ha probado la capacidad de levitación de una esfera de estaño de 1mm de diámetro, sin embargo, la suspensión no ha sido efectiva debida a la elevada densidad de este elemento (ρ=7,31 g/cm3). Además, con 9V se ha conseguido levitar pequeños insectos, entre ellos la mosca de la fruta (Drosophila Melanogaster). (imagen 16).

Dado el formato de la mayoría de anexos (.stl, .ino, .mp4) se ha creado un enlace a una carpeta en Google Drive en la cual se han incluido todos los anexos:
https://drive.google.com/drive/u/0/folders/1z_axBFMarj9lTuJGdl3tFlhpUEDp9jzw
Las pruebas con el levitador demostraron que funciona de manera efectiva desde el momento en que se enciende, y durante períodos prolongados, resistiendo de manera adecuada a cambios de temperatura en el ambiente. La levitación continua y estable de muestras durante más de 2 horas se midió mediante la suspensión de varias gotas de disoluciones de agua azucarada y su posterior evaporación. Su resistencia a cambios de temperatura en el ambiente se midió colocando un soldador (350°C) a 1 cm de la muestra durante 20 minutos, observando que la muestra permanecía atrapada establemente.
434
4. 2. 1. 2. Fuerza de las trampas (rendimiento del levitador)
4. 2. 1. 3. Resistencia del levitador
Imagen 8: Mapa de conexiones del levitador de dos Imagen 10: Mapa de conexiones del levitador matrices con placa
Imágenes 14 y 15
4. 2. 1. 4. Fenómenos químicos
A) Oxidación de magnesio
Imagen 8: Mapa de conexiones del levitador de dos Imagen 10: Mapa de conexiones matrices con placa Arduino Nano. de una matriz
Imagen 8: Mapa de conexiones del levitador de dos Imagen 10: Mapa de conexiones matrices con placa Arduino Nano. de una matriz
En esta reacción se procedió a tomar trozos de entre 1 y 4 mm de cinta de magnesio, para posteriormente colocarlos en el eje de la onda estacionaria. Una vez que estos se hallaban levitando establemente, se aplicó con una jeringuilla una gota de ácido clorhídrico de concentración 37 % en peso, obteniendo cloruro de magnesio e hidrógeno. Dado que la energía de las moléculas de los productos es inferior a la energía de las moléculas de los reactivos, la reacción llevada a cabo fue una reacción exotérmica. Al producirse la reacción en el interior de un nodo de presión, este ejercía fuerzas sobre la muestra de magnesio con ácido para mantenerla en su interior. Sin embargo, a medida que la reacción avanzaba, comenzaba a liberar energía, ejerciendo una fuerza sobre el medio circundante. Esta fuerza era inferior a la que aplicaban todos los transductores del levitador, por lo que la muestra de magnesio comenzó a girar dentro de uno de los nodos de la onda estacionaria. De este modo, girando a elevada velocidad y siendo frenada por el campo de presión acústico, se podía apreciar una figura en forma de circunferencia en el eje del levitador (ANEXO IV) (imágenes 14 y 15).
Imagen 11: Gráfica que relaciona la densidad de las muestras Imagen 12 levitadas con el voltaje mínimo necesario para mantenerlas en suspensión
Imagen 11: Gráfica que relaciona la densidad de las muestras Imagen 12 levitadas con el voltaje mínimo necesario para mantenerlas en suspensión
Imagen 14
Imagen 14
Imagen 15
Imagen 15
Imagen 16
Imagen 16
9. ANEXO
9. ANEXO
B) Disminución del volumen del poliestireno con acetona
En este experimento se procedió a añadir gotas de acetona pura a una esfera de poliestireno, previamente depositada en uno de los nodos de la onda estacionaria. Lo que se pudo observar (ANEXO V) es que esta disminuía su tamaño visiblemente, pues se disolvía en la acetona. Dado que tanto la acetona como el poliestireno expandido (EPS) son derivados del petróleo, cuya polaridad es muy reducida, ambos reactivos son poco polares y por tanto, miscibles entre sí. Al mezclarse, la acetona disuelve el poliestireno, y sobre la esfera de EPS se forman burbujas, generadas a partir del hidrógeno que se encuentra dentro de la espuma de poliestireno (imágenes 12 y 13).



Dado el formato de la mayoría de anexos (.stl, .ino, .mp4) se ha creado un una carpeta en Google Drive en la cual se han incluido todos los anexos:
Dado el formato de la mayoría de anexos (.stl, .ino, .mp4) se ha creado una carpeta en Google Drive en la cual se han incluido todos los anexos:
https://drive.google.com/drive/u/0/folders/1z_axBFMarj9lTuJGdl3tFlhpUEDp9jzw
https://drive.google.com/drive/u/0/folders/1z_axBFMarj9lTuJGdl3tFlhpUEDp9jzw
Levitación acústica 435
Imágenes 12 y 13
Imagen 14
ANEXO
A) Reflexión
Dado que los transductores emiten a una frecuencia de 40 kHz, su sonido debería resultar inaudibles para el oído humano. Sin embargo, al acercarse al levitador se puede apreciar un sonido característico de frecuencia muy elevada. Esto se debe a que las ondas acústicas se reflejan en las matrices del transductor y en los objetos cercanos, lo que disminuye su frecuencia hasta el rango audible. Este efecto se percibe introduciendo papel de aluminio entre las dos matrices, puesto que es el punto de mayor intensidad del campo acústico (ANEXO VI).
Imagen 15
B) Extinción del fuego
Imagen 16
el formato de la mayoría de anexos (.stl, .ino, .mp4) se ha creado un enlace a carpeta en Google Drive en la cual se han incluido todos los anexos: https://drive.google.com/drive/u/0/folders/1z_axBFMarj9lTuJGdl3tFlhpUEDp9jzw
El campo de presión acústica generado por las ondas de ultrasonidos crea una diferencia de presión con respecto a la presión atmosférica. En el caso del levitador construido, la presión acústica generada durante la rarefacción de las ondas dependerá de la intensidad aplicada a los transductores. La presión acústica generada por el levitador es lo suficientemente elevada como para apagar pequeños fuegos (ANEXO VII), lo que podría resultar muy interesante a la hora de patentar sistemas de extintores que funcionen basándose en el principio de la presión acústica.

El sistema de levitación acústica con una matriz (imagen 10) consta de una plato hemisférico impreso en 3D con 24 transductores piezoeléctricos (MSOA1640H10T), además de una pieza de PVC sobre la que está montado el circuito. El plato tiene 110 mm de diámetro, y una altura de 41,5 mm. En el interior del plato hemisférico hay, en total, 4 filas de transductores, dos en cada mitad, con 24 transductores y 4 señales independientes en total. Se utiliza una placa Arduino Nano, programada (ANEXO VII) para generar una señal de 40 kHz y

30º
436
CERTAMEN JÓVENES INVESTIGADORES / Ciencias Físicas, Químicas y Matemáticas
4. 2. 1. 5. Fenómenos físicos
4. 2. 2. LEVITACIÓN CON UNA MATRIZ
4. 2. 2. 1. Circuito electrónico
Mapa de conexiones del levitador de dos Imagen 10: Mapa de conexiones del levitador con placa Arduino Nano. de una matriz
11: Gráfica que relaciona la densidad de las muestras Imagen 12 Imagen 13 con el voltaje mínimo necesario para mantenerlas suspensión
Imagen 10
Mapa
5 Vpp, que a su vez se envía a un Driver L298N para amplificarla hasta 25 Vpp. Esta placa Arduino está alimentada por una batería de 7,3 V. Esta misma batería alimenta el Driver, aumentando previamente el voltaje de 7,3V a 25V a través de un convertidor Boost CC-CC. Los 24 transductores tienen de 16 mm de diámetro y una frecuencia de 40 kHz. Al estar distribuidos en la superficie interna del plato, las ondas emitidas por cada uno de ellos confluyen en un único punto, situado a 1,8 cm por encima de la parte superior del plato.

Imagen 11: Gráfica que relaciona la densidad de las muestras Imagen 12 Imagen 13 levitadas con el voltaje mínimo necesario para mantenerlas en suspensión
El rendimiento del dispositivo se midió experimentalmente mediante la levitación de una esfera de poliestireno de 1 mm con una trampa en forma de pinza. La fuerza de atrapamiento de los levitadores con una matriz es inferior a la fuerza de los de de onda estacionaria (dos matrices), por lo que con este levitador sólo se ha conseguido levitar poliestireno. Disminuyendo progresivamente el voltaje, se llegó a la conclusión que la señal mínima de activación para levitar la esfera es de 14 V, pues, aunque la frecuencia permanezca constante, la presión acústica generada por un emisor (transductor) es proporcional al voltaje de la señal de conducción. Si disminuye la presión acústica generada, disminuye la fuerza de las ondas acústicas emitidas por los transductores y por ello la muestra levitada cae.
Imagen 14 Imagen 15
9. ANEXO
Dada la menor fuerza del levitador a la hora de mantener en suspensión materiales de densidades superiores a la del poliestireno, no se ha podido levitar disoluciones o mantener un soldador caliente cerca, pues el poliestireno no era capaz de aguantar elevadas temperaturas sin quemarse. Sin embargo se ha comprobado su capacidad de levitar partículas durante periodos prolongados de tiempo. Al igual que en el levitador con dos matrices, se ha depositado una partícula de poliestireno y se ha dejado en suspensión. La muestra ha podido ser levitada ininterrumpidamente durante dos horas.
Imagen 16
Dado el formato de la mayoría de anexos (.stl, .ino, .mp4) se ha creado un enlace a una carpeta en Google Drive en la cual se han incluido todos los anexos: https://drive.google.com/drive/u/0/folders/1z_axBFMarj9lTuJGdl3tFlhpUEDp9jzw
437
Levitación acústica
4. 2. 2. 2. Fuerza de las trampas (Rendimiento del levitador)
4. 2. 2. 3. Resistencia del levitador
Imagen 8: Mapa de conexiones del levitador de dos Imagen 10: Mapa de conexiones del levitador matrices con placa Arduino Nano. de una matriz
de conexiones del levitador de una matriz.
30º CERTAMEN JÓVENES INVESTIGADORES / Ciencias Físicas,
Químicas y Matemáticas
5. RESULTADOS Y CONCLUSIONES
Mediante este proyecto de investigación, se ha logrado construir un par de levitadores resistentes, realizados utilizando componentes electrónicos económicos, y un circuito electrónico sencillo. El resultado de la investigación sobre la construcción y funcionamiento de los levitadores acústicos ha permitido analizar de forma práctica y teórica los principios físicos en los que se basan estos dispositivos, así como comparar distintos aspectos y características entre los levitadores acústicos de una y dos matrices. A partir de esta comparativa, se dedujo que los levitadores de dos matrices (onda estacionaria) son mucho más efectivos a la hora de levitar diferentes tipos de muestras. El análisis teórico y práctico de estos dispositivos ha permitido obtener una visión general de la levitación acústica, así como de sus aplicaciones y su enorme potencial en prácticamente todas las áreas de la ciencia. La versatilidad de esta técnica tiene varios aspectos. Por una parte, permite la manipulación de partículas independientemente de su forma y propiedades físico-químicas, y de longitudes desde el micrómetro hasta varios milímetros. Su precisión, versatilidad y biocompatibilidad convierten esta técnica es una excelente plataforma para estudios en áreas que van desde la química, la medicina o la biología, hasta campos como la ingeniería o la física. Además de su actual éxito en innovadoras y complejas técnicas de laboratorio, y de su enorme potencial aún sin explorar, se ha conseguido demostrar de un modo visual y tangible, mediante sencillas experimentos físicos, el carácter práctico de estos dispositivos. Gracias a su sencillez en comparación con otras técnicas de levitación, estos pequeños dispositivos podrían servir de herramienta didáctica para explicar de forma menos abstracta las propiedades de las ondas y los campos acústicos en colegios e institutos. Esto facilitaría el aprendizaje de los alumnos, y el acceso a la tecnología a un mayor número de personas.
6. BIBLIOGRAFÍA
Marzo, A., Seah, S., Drinkwater, B., Sahoo, D., Long, B. and Subramanian, S. (2015). Holographic acoustic elements for manipulation of levitated objects. Nature Communications, 6(1).
Spruce, G. and Pringle, R. (1992). Polymer dispersed liquid crystal (PDLC) films. Electronics & Communications Engineering Journal, 4(2), p.91.
King, L. (1934). On the acoustic radiation pressure on spheres. Proceedings of theRoyalSocietyof London.SeriesA-MathematicalandPhysicalSciences, 147(861), pp.212-240.
438
Bucks, K. and Muller, H. (1933). ber einige Beobachtungen an schwingenden Piezoquarzen und ihrem Schallfeld. Zeitschrift fur Physik, 84(1-2), pp.75-86.
Fuchs, N., Daisley, R.,Fuchs, M.,Davies, C. and Straumanis, M.(1965). The Mechanics of Aerosols. Physics Today, 18(4), pp.73-73.
Gor'kov, L. (2019). On the Forces Acting on a Small Particle in an Acoustical Field in an Ideal Fluid.[online] Available at: http://adsabs.harvard.edu/abs/1962SPhD....6..773G [Accessed 13 Jan. 2019].
Trinh, E. (1985). Compact acoustic levitation device for studies in fluid dynamics and material sciencme in the laboratory and microgravity. Review of Scientific Instruments, 56(11), pp.2059-2065.
Xie, W. and Wei, B. (2001). Parametric study of single-axis acoustic levitation. Applied Physics
Berry, M. and Geim, A. (1997). Of flying frogs and levitrons. European Journal of Physics, 18(4), pp.307 -313.
Physical Review Letters. 2018. Phys. Rev. Lett. 89, 104304 (2002) - Levitation of Iridium and Liquid Mercury by Ultrasound. [ONLINE] Available at:
https://journals.aps.org/prl/abstract/10.1103/PhysRevLett.89.104304
[Accessed 20 Jul. 2018].
Rayleigh (1902). XXXIV. On the pressure of vibrations. [online] Taylor & Francis. Available at:
https://www.tandfonline.com/doi/abs/10.1080/14786440209462769
[Accessed 1 Aug 2018].
Xie, W., Cao, C., Lü, Y., Hong, Z. and Wei, B. (2006). Acoustic method for levitation of small living animals. Applied Physics Letters, 89(21), p.214102.
Li, S., Ma, F., Bachman, H., Cameron, C., Zeng, X. and Huang, T. (2017). Acoustofluidic bacteria separation
NASA Technical Reports Server (NTRS) - Microgravity Science and Applications Program Tasks, 1984 Revision. 2018. NASA Technical Reports Server (NTRS) - Microgravity Science and Applications Program Tasks, 1984 Revision. [ONLINE] Available at:
https://ntrs.nasa.gov/search.jsp?R=19860000586 [Accessed 23 Jul. 2018]
Ding, X., Lin, S., Kiraly, B., Yue, H., Li, S., Chiang, I., Shi, J., Benkovic, S. and Huang, T. (2012). On-chip manipulation of single microparticles, cells, and organisms using surface acoustic waves. Proceedings of the National Academy of Sciences, 109(28), pp.11105-11109.
Imágenes 1-7: https://aip.scitation.org/doi/full/10.1063/1.4972407
Última consulta: septiembre 2018.8-9, Imágenes 11-16: Autoría propia.
Imagen 10: https://www.instructables.com/id/Acoustic-Tractor-Beam/
Levitación acústica 439
CIENCIAS FÍSICAS, QUÍMICAS Y MATEMÁTICAS
Construcción de un detector de muones cósmicos
/ SEGUNDO PREMIO
AUTORES | MIGUEL MARTÍN GONZÁLEZ, DANIEL MONTESINOS CAPACETE Y ADRIÁN FERNÁNDEZ TORRES.
COORDINADORA | CAROLINA AUMONT AUMONT CENTRO | IES ÍTACA e IES MARTÍN RIVERO CIUDAD | TOMARES-SEVILLA y RONDA-MÁLAGA
RESUMEN |
La idea general del proyecto es crear un detector de muones portátil para poder transportarlo e ir con él a distintos lugares con el objetivo de ir analizando a diferentes alturas el flujo de muones. Los muones son unas partículas que se generan en las capas exteriores de la Tierra debido al choque de lo protones que vienen de los rayos cósmicos contra los núcleos de los átomos de nitrógeno o de oxígeno de la atmósfera. De esta forma se pueden encontrar diferentes concentraciones de muones dependiendo de la altitud, cuanto mayor es la altitud, mayor es la cantidad de radiación y muones que se pueden observar. El detector de muones funciona en primer lugar con un plástico centelleador llamado Bicrón que emitirá fotones azules al pasar muones sobre él. Los fotones son dirigidos a un fotocátodo que, gracias al efecto fotoeléctrico, liberan electrones. Estos electrones son propulsados por una placa con polaridad negativa y pasan por el fotomultiplicador para generar una avalancha de electrones y amplificar la señal. (Se usó un fotomultiplicador de Silicio, SiPM, en vez de uno de vacío porque son más seguros y necesitan voltajes menores para funcionar). El detector detectará los pulsos de electrones y generará gráficas que señalarán la presencia de un muón.
440
ABSTRACT |
The main idea of the project is to build a portable muon detector in order to carry it to several places with the objective of analyzing the muon flux at different heights. The muons are particles that are generated in the exterior layers of the atmosphere because of the collision between high energy protons (which have arrived from cosmic rays) and the nucleuses of oxygen or nitrogen atoms in the atmosphere. This way different concentrations of muons can be found depending on the height, the higher the height, the bigger the amount of muons and radiation that can be seen. Firstly, the muon detector works with a plastic scintillator called “bicrón” which will emit blue photons when muons pass through it. Photons are led to a photocathode, where they release electrons thanks to the photoelectric effect. These electrons are propulsed by a plate with negative polarity and they pass through the silicon photomultiplier in order to create an electron avalanche and amplify the signal. (A silicon photomultiplier, SiPM, was used instead of vacuum ones because they are safer and they need fewer voltage for working). The detector will detect electron pulses and it will generate graphics which will show us the presence of a muon.
441
CIENCIAS FÍSICAS, QUÍMICAS Y MATEMÁTICAS
CERTAMEN JÓVENES INVESTIGADORES / Ciencias Físicas, Químicas y Matemáticas
1. INTRODUCCIÓN
La física de partículas no es un campo de especulaciones alejadas de la realidad, sino que está muy presente en la vida cotidiana. A diario son observables los efectos que las partículas causan en la naturaleza y que se explican desde la física de partículas. La famosa Aurora Boreal no es más que el resultado de la interacción de partículas con la atmósfera. Esta investigación se centra en un tipo de partículas elementales, los muones.
2. ANTECEDENTES
Los muones se detectaron por primera vez con el experimento de Victor Hess en 1912 con sus ascensos en globo, con tres medidas (1911, 1912, 1913) con un electrómetro. Es importante señalar que una de las medidas (7 abril 1912) se realizó durante un eclipse solar, los rayos ionizantes no podían venir del Sol. Usó un globo aerostático y subió hasta los 5,5km de altitud. Al ir subiendo, subía cada vez más la radiactividad que medía, confirmando que la radiación también proviene del espacio y no solamente de la tierra, como se creía hasta entonces. El aumento de la radiactividad se debía a los rayos cósmicos.
En el espacio exterior, sin embargo, los niveles de radiación son mucho mayores, ya que no hay “escudos” como la atmósfera o el campo magnético terrestre. Ejemplo de esto es la experiencia de los astronautas, que ven manchas blancas y destellos en el interior de sus ojos al cerrar los párpados. Producidas por la radiación a la que estaban expuestos, transformando sus propios ojos en detectores de rayos cósmicos.
Pero fue Carl David Anderson en 1936 mientras estudiaba las radiaciones cósmicas quien descubrió el muón. Observó que existían unas partículas que al pasar por un campo electromagnético se curvaban de manera distinta que el protón y el electrón, el muón.
Del espacio, las estrellas, las supernovas, los agujeros negros, provienen enormes cantidades de radiación en forma de rayos cósmicos. Afortunadamente la atmósfera y los campos magnéticos terrestre y solar protegen la superficie de sus efectos, que pueden ser dañinos para la vida, al igual que esenciales para su existencia.
Debido a que los rayos cósmicos poseen carga eléctrica son desviados hacia las regiones polares debido a la fuerza de Lorentz. El choque de estas partículas cargadas con los átomos del aire origina las auroras boreales.
Los muones son partículas elementales, en concreto leptones de segunda generación, 200 veces más pesados que los electrones. Por esoson muy inestables y tienden a desintegrarse en partículas más estables. Además, su gran densidad les permite penetrar metros de roca antes de detenerse, pudiendo ser detec-
30º
442
enormes cantidades de radiación en forma de rayos cósmicos. Afortunadamente la atmósfera y los campos magnéticos terrestre y solar protegen la superficie de sus efectos, que pueden ser dañinos para la vida, al igual que esenciales para su existencia.
Construcción de un detector de muones cósmicos
Debido a que los rayos cósmicos poseen carga eléctrica son desviados hacia regiones polares debido a la fuerza de Lorentz. El choque de estas partículas cargadas con los átomos aire origina las auroras boreales.
tados hasta a 700 metros de profundidad. Los muones interaccionan con las cuatro fuerzas fundamentales
muones son partículas elementales, en concreto leptones segunda generación, 200 veces pesados que los electrones. esoson muy inestables y tienden a desintegrarse en partículas más estables. Además, su gran densidad les permite penetrar metros de roca antes de detenerse, pudiendo ser detectados hasta a 700 metros de profundidad. Los muones interaccionan con las cuatro fuerzas fundamentales
Cuando los rayos cósmicos (normalmente protones) entran en la atmósfera a unos 50-60 km de altitud impactan principalmente con núcleos de Nitrógeno y Oxígeno, desintegrándose en kaones y piones. Que durante su descenso se desintegran a su vez en muones, cuya vida media es de 2,2µs, sin embargo, debido a las elevadas velocidades a las que viajan, la dilatación relativista del tiempo prolonga su vida y contrae su recorrido, pudiendo llegar a la superficie, donde se detectarán. Finalmente los muones dan lugar a electrones, neutrinos y antineutrinos al desintegrarse.

Se ha estudiado que existe una relación entre los rayos cósmicos y la formación de nubes por la creación de núcleos de condensación para el agua con la ionización del aire. Confirmando que la actividad magnética solar es un factor importante en los cambios climáticos de la Tierra, afectando a la cantidad de rayos cósmicos que llegan al planeta. Y aunque aún se está estudiando, los rayos cósmicos también podrían tener un papel en las tormentas eléctricas.
3. HIPÓTESIS DE TRABAJO Y OBJETIVOS DE LA INVESTIGACIÓN
Los objetivos del proyecto son:
• - Construcción de un detector de muones cósmicos.
• - Diseño de los componentes que forman el detector.
• - Análisis de los datos obtenidos.
Se construirá primero una Cámara de nubes que permitirá ver rastros de partículas cargadas en niebla de isopropanol, como introducción a detectores de partículas.
Y luego, se construirá el detector de muones, que debe indicar la presencia de muones con pulsos parecidos a los mostrados en la figura, generados por simulación.
443
Diseño de los componentes que forman el detector.
Análisis de los datos obtenidos.
30º CERTAMEN JÓVENES INVESTIGADORES / Ciencias Físicas, Químicas y Matemáticas

construirá primero una Cámara de nubes que permitirá ver rastros de partículas cargadas en niebla de isopropanol, como introducción a detectores partículas.
luego, se construirá el detector de muones, que debe indicar la presencia de muones pulsos parecidos a los mostrados en la figura, generados por simulación.

Materiales y métodos

4. MATERIALES Y MÉTODOS

4.1. Diseño del utillaje experimental y de los instrumentos de recogida de información
4.1. DISEÑO DEL UTILLAJE EXPERIMENTAL Y DE LOS INSTRUMENTOS DE RECOGIDA DE INFORMACIÓN
4.1.1. PARTES DE LA CÁMARA DE NIEBLA:
4.1.1. Partes de la Cámara de Niebla:
Materiales: bandeja inferior de plásticocon hielo seco (CO2 en estado sólido), pecera de plástico, láminas de fieltro, bandeja de acero inoxidable, isopropanol.
Materiales: bandeja inferior de plásticocon hielo seco (CO2 en estado sólido), pecera de plástico, láminas de fieltro, bandeja de acero inoxidable, isopropanol.
La pecera con el fieltro empapado en isopropanol se coloca junto a un calefactor enfocando hacia su interior durante unos minutos. Luego se coloca la pecera boca abajo sobre la bandeja de acero inoxidable, que a su vez está sobre la bandeja de plástico con el hielo seco. El frío del hielo seco se transmite hacia el interior de la cámara, a su vez más caliente que el ambiente por el calefactor. El gradiente térmico es el que genera la niebla que hará de detector de partículas
La pecera con el fieltro empapado en isopropanol se coloca junto a un calefactor enfocando hacia su interior durante unos minutos. Luego se coloca la pecera boca abajo sobre la bandeja de acero inoxidable, que a su vez está sobre la bandeja de plástico con el hielo seco. El frío del hielo seco se transmite hacia el interior de la cámara, a su vez más caliente que el ambiente por el calefactor. El gradiente térmico es el que genera la niebla que hará de detector de partículas cargadas.

4.1.2. COMPONENTES DEL DETECTOR DE MUONES:
4.1.2. Componentes del detector de muones:
- Plástico Centelleador: BC412, bicrón; un policarbonato dopado de flúor. Al pasar radiación ionizante, (en este caso, muones) a través de él, emite fotones a 480 nm, de luz azul, detectable por
- Plástico Centelleador: BC412, bicrón; un policarbonato dopado de flúor. Al pasar radiación ionizante, (en este caso, muones) a través de él, emite fotones a 480 nm, de luz azul, detectable por el fotorreceptor. Con forma de prisma trapezoidal y forrado de papel de aluminio para reflejar y canalizar la luz hasta la cara más pequeña donde se encontrará el SiPM. El material centelleador es
La pecera con el fieltro empapado isopropanol se coloca junto a un calefactor enfocando hacia su interior durante unos minutos. Luego se coloca la pecera boca abajo sobre la bandeja de acero inoxidable, que a vez está sobre la bandeja de plástico con el hielo seco. El frío del hielo seco se transmite hacia el interior de la cámara, a su vez más caliente que el ambiente por el calefactor. El gradiente térmico es el que genera la niebla que hará de detector de partículas cargadas.

4.1.2. Componentes del detector de muones:

444
el fotorreceptor. Con forma de prisma trapezoidal y
hacia el interior de la cámara, a caliente que el ambiente por el gradiente térmico es el que genera hará de detector de partículas
Construcción de un detector de muones cósmicos
con el hielo seco. El frío del hielo seco se transmite hacia el interior de la cámara, a su vez más caliente que el ambiente por el calefactor. El gradiente térmico es el que genera la niebla que hará de detector de partículas cargadas.
4.1.2. Componentes del detector de muones:
Componentes del detector de

sensible a la energía y de respuesta rápida, debe ser eficiente convirtiendo energía en fluorescencia, y transparente para transmitir la luz.

- Plástico Centelleador: BC412, bicrón; un policarbonato dopado de flúor. Al pasar radiación ionizante, (en este caso, muones) a través de él, emite fotones a 480 nm, de luz azul, detectable por el fotorreceptor. Con forma de prisma trapezoidal y forrado de papel de aluminio para reflejar y canalizar la luz hasta la cara más pequeña donde se encontrará el SiPM. El material centelleador es sensible a la energía y de respuesta rápida, debe ser eficiente convirtiendo energía en fluorescencia, y transparente para transmitir la luz.
Centelleador: BC412, bicrón; un dopado de flúor. Al pasar radiación caso, muones) a través de él, 480 nm, de luz azul, detectable por Con forma de prisma trapezoidal y de aluminio para reflejar y hasta la cara más pequeña donde se encontrará el SiPM. El centelleador es sensible a la energía y de respuesta rápida, debe ser convirtiendo energía en fluorescencia, y transparente para transmitir la del detector, con los diferentes circuitos:
- Placa electrónica del detector, con los diferentes circuitos:
- Placa electrónica del detector, con los diferentes circuitos:




- SPM, fotomultiplicador de silicio. Detecta los fotones producidos por el centelleador y los transforma en una cascada de electrones. Por cada fotón que recibe el fotomultiplicador, se liberarán 1000000 de electrones.
- DC-DC booster: El fotomultiplicador es un componente muy sensible, funciona a 70V. El DC-DC booster se encargará de aumentar el voltaje y alimentar
- Circuito Amplificador: Amplifica la señal emitida por fotomultiplicador para
- Circuito Detector de Picos: Detecta cuándo se produce un pico y lo dilata en
- Placa Arduino Nano: Procesará la información recibida por el detector y enviarla a la Raspberry Pi 3.

445
fotomultiplicador, se liberarán 1000000 de electrones.
centelleador y los transforma en una cascada de electrones. que recibe el fotomultiplicador, se liberarán 1000000 de
fotomultiplicador es un componente muy sensible, funciona booster se encargará de aumentar el voltaje y alimentar el
CERTAMEN JÓVENES INVESTIGADORES / Ciencias Físicas, Químicas y
- DC-DC booster: El fotomultiplicador es un componente a 70V. El DC-DC booster se encargará de aumentar SiPM.
Amplifica la señal emitida por fotomultiplicador para ser Arduino, de los 3V a los 5V.
- Raspberry Pi 3: Recibe la información procesada por la placa Arduino Nano para mostrar los datos y gráficas.
- SPM, fotomultiplicador de silicio. Detecta los fotones producidos por el centelleador y los transforma en una cascada de electrones. Por cada fotón que recibe el fotomultiplicador, se liberarán 1000000 de electrones.
- SPM, fotomultiplicador de silicio. Detecta los fotones producidos por el centelleador y los transforma en una cascada de electrones. Por cada fotón que recibe el fotomultiplicador, se liberarán 1000000 de electrones.
- Circuito Amplificador: Amplifica la señal emitida por detectable por la placa Arduino, de los 3V a los 5V.


Picos: Detecta cuándo se produce tiempo para ser detectable.
- DC-DC booster: El fotomultiplicador es un componente muy sensible, funciona a 70V. El DC-DC booster se encargará de aumentar el voltaje y alimentar el SiPM.
- DC-DC booster: El fotomultiplicador es un componente muy sensible, funciona a 70V. El DC-DC booster se encargará de aumentar el voltaje y alimentar el SiPM.
- Circuito Detector de Picos: Detecta cuándo se produce un pico y lo dilata en el tiempo para ser detectable.
Nano: Procesará la información recibida por el detector y enviarla a la Raspberry Pi 3.
- Circuito Amplificador: Amplifica la señal emitida por fotomultiplicador para ser detectable por la placa Arduino, de los 3V a los 5V.
- Circuito Amplificador: Amplifica la señal emitida por fotomultiplicador para ser detectable por la placa Arduino, de los 3V a los 5V.
La placa del detector se fabrica mediante ataque químico y posterior soldadura.
- Placa Arduino Nano: Procesará la información recibida por el detector y enviarla Raspberry Pi 3.
- Raspberry Pi 3: Recibe la información procesada por la placa Arduino Nano para mostrar los datos y gráficas.
- Circuito Detector de Picos: Detecta cuándo se produce un pico y lo dilata en el tiempo para ser detectable.
- Circuito Detector de Picos: Detecta cuándo se produce un pico y lo dilata en el tiempo para ser detectable.
- Raspberry Pi 3: Recibe la información placa Arduino Nano para mostrar



- Placa Arduino Nano: Procesará la información recibida por el detector y enviarla a la Raspberry Pi 3.
- Placa Arduino Nano: Procesará la información recibida por el detector y enviarla a la Raspberry Pi 3.



Vista del prisma de plástico Bicron forrado al completo. En la mitad de cara
- Raspberry Pi 3: Recibe la información procesada por la placa Arduino Nano para mostrar los datos y gráficas.
- Raspberry Pi 3: Recibe la información procesada por la placa Arduino Nano para mostrar los datos y gráficas.
Imagen 01
La placa del detector se fabrica mediante ataque químico y posterior soldadura.
Imagen 02
Vista del prisma de plástico Bicron forrado al completo. En la mitad de cara derecha del prisma se encuentra el SiPM.
mediante ataque químico soldadura.
de datos
La
Vista del prisma de plástico Bicron forrado al completo. En la mitad de cara derecha del prisma se encuentra el SiPM.
4.2. RECOGIDA DE DATOS
Vista del prisma de plástico Bicron forrado al completo. En la mitad de cara derecha del prisma se encuentra el SiPM.
La placa del detector se fabrica mediante ataque químico y posterior soldadura. Vista del prisma de En la mitad de cara SiPM.






4.2. Recogida de datos
4.2. Recogida de datos
Tras subir el código al arduino proporcionado por la web del Cosmic Watch a la placa, se analizan los resultados. Los pulsos detectados por el Arduino y enviados a la Raspberry Pi 3 se obtienen cada 5.8 μs. Se pueden analizar los datos sincronizando el detector con la página de Cosmic Watch o a través de los programas de análisis de señal. Otra alternativa es utilizar un osciloscopio.
arduino proporcionado por la web del Cosmic Watch a la los resultados. Los pulsos detectados por el Arduino y Raspberry Pi 3 se obtienen cada 5.8 μs. Se pueden analizar los
Tras subir el código al arduino proporcionado por la web del Cosmic Watch a la placa, se analizan los resultados. Los pulsos detectados por el Arduino y enviados a la Raspberry Pi 3 se obtienen cada 5.8 μs. Se pueden analizar los datos sincronizando el detector con la página de Cosmic Watch o a través de los programas de análisis de señal. Otra alternativa es utilizar un osciloscopio.
Tras subir el código al arduino proporcionado por la web del Cosmic Watch a la placa, se analizan los resultados. Los pulsos detectados por el Arduino y enviados a la Raspberry Pi 3 se obtienen cada 5.8 μs. Se pueden analizar los datos sincronizando el detector con la página de Cosmic Watch o a través de los programas de análisis de señal. Otra alternativa es utilizar un osciloscopio.
4.2. Recogida de datos
Tras subir el código al arduino proporcionado por la web placa, se analizan los resultados. Los pulsos detectados
446
30º
Matemáticas
detector con la página de Cosmic Watch o a través de
enviados a la Raspberry Pi 3 se obtienen cada 5.8 μs.
La placa del detector se fabrica mediante ataque químico y posterior soldadura.
Vista del prisma de plástico Bicron forrado al completo. En la mitad de cara derecha del prisma se encuentra el SiPM.
placa del detector se fabrica mediante ataque químico y posterior soldadura.
Resultados
Construcción de un detector de muones cósmicos
5. RESULTADOS
PRIMEROS RESULTADOS
Obtenidos conectando el fotomultiplicador directamente a un osciloscopio, es posible ver dos picos, correspondiéndose con dos muones.
5. Resultados
Resultados
conectando el fotomultiplicador
a un osciloscopio, es posible ver dos correspondiéndose con dos
procesadas
Primeros Resultados
Obtenidos conectando el fotomultiplicador directamente a un osciloscopio, es posible ver dos picos, correspondiéndose con dos muones
GRÁFICAS PROCESADAS
Gráficas procesadas
gráfica se puede apreciar lo que se espera tras el paso del muón. Un señal que alcanza un valor de voltaje apreciable (0.6V) que se extiende de un tiempo apreciable también (10ms) y la detección de una señal segundos o 1 minuto, ajustada a la media a nivel del mar aproximadamente, de 1 muón por centímetro cuadrado cada minuto. Sin embargo, como en toda investigación científica, no todos los resultados obtenidos tienen por qué tener este aspecto (y no lo hacen). Es aquí donde debe actuar el investigador y analizar los resultados




En esta gráfica se puede apreciar lo que se espera tras el paso del muón. Un pico de señal que alcanza un valor de voltaje apreciable (0.6V) que se extiende a lo largo de un tiempo apreciable también (10ms) y la detección de una señal cada 45 segundos o 1 minuto, ajustada a la media a nivel del mar aproximadamente, de 1 muón por centímetro cuadrado cada minuto. Sin embargo, como en toda investigación científica, no todos los resultados obtenidos tienen por qué tener este aspecto (y no lo hacen). Es aquí donde debe actuar el investigador y analizar los resultados adecuadamente.





En esta gráfica se puede apreciar lo que se espera tras el pico de señal que alcanza un valor de voltaje apreciable (0.6V) a lo largo de un tiempo apreciable también (10ms) y la detección cada 45 segundos o 1 minuto, ajustada a la media aproximadamente, centímetro cuadrado Sin embargo, investigación científica, resultados obtenidos tener este aspecto Es aquí donde investigador y analizar adecuadamente.

directamente
tener este aspecto (y no lo hacen).
Es aquí donde debe actuar el investigador y analizar los resultados adecuadamente.
6. CONCLUSIONES
6. Conclusiones
En general la realización del proyecto ha sido muy compleja por la dificultad que supone la construcción de un detector de este tipo. Surgieron problemas tanto en la construcción como la programación del detector. Resultó muy complicado soldar el DC-DC booster por ser una pieza muy pequeña, teniendo que soldar a mano. Además, hubo que depurar el código descargado de la página de Cosmicwatch, y adaptarlo para utilizar una Raspberry Pi como salida de datos, con la que también se superaron ciertas dificultades con el software. Todos los problemas se solucionaron aplicando el método científico.
En general la realización del proyecto ha sido muy compleja por la dificultad que supone la construcción de un detector de este tipo. Surgieron problemas tanto en la construcción como la programación del detector. Resultó muy complicado soldar el DC-DC booster por ser una pieza muy pequeña, teniendo que soldar a mano. Además, hubo que depurar el código descargado de la página de Cosmicwatch, y adaptarlo para utilizar una Raspberry Pi como salida de datos, con la que también se superaron ciertas dificultades con el software. Todos los problemas se solucionaron aplicando el método científico.




Es posible concluir que este proyecto ha sido realmente interesante en el campo de la física, ya que gracias a él se puede observar el rastro que deja tras él un muón, una partícula de tamaño más que microscópico. No solo la ejecución del proyecto ha aumentado nuestra conciencia de la importancia de la investigación científica, sino que también ha levantado más interés en nosotros por el ámbito de la física de partículas.
7. AGRADECIMIENTOS
En primer lugar agradecer al investigador Rogelio Palomo por su labor de divulgación de la ciencia y por haber diseñado este proyecto y habernos guiado y a Luis Tovar Muniz por su colaboración. A Jose Manuel Sanchez por la valiosa ayuda prestada. Gracias también a la Escuela Técnica Superior de Ingeniería de la Universidad de Sevilla por hacer posible la realización de este proyecto y cedernos sus instalaciones. Al CERN por ceder material utilizado en el proyecto ya que de otra forma no hubiese sido factible su realización. A la organización de Jóvenes con Investigadores de Sevilla, destacando a la coordinadora Carolina Clavijo por su gran trabajo a la hora de organizar todos estos proyectos y por habernos dado la oportunidad de pertenecer a ellos. A la página web de Cosmicwatch, por habernos servido como fuente de información para documentarnos sobre la detección de muones y guiarnos en la construcción del detector.
Ciencias
448
Físicas, Químicas y Matemáticas
Construcción de un detector de muones cósmicos
BIBLIOGRAFÍA
Przewłocki, P., Frankiewicz, K. (2017). CosmicWatch: http://www.cosmicwatc h.lns.mit.edu/about
Ladrón de Guevara, P. (2012, Junio). Principios de los detectores de partículas, Cern Talk II: https://indico.cern.ch/event/195014/contributions/361287/attachments/28 3538/396485/talk_1_25_06_12.pdf
Ladrón de Guevara, P. (2013, Febrero). Principios de los detectores de partículas. CERN Talk II: http://teorica.fis.ucm.es/ft11/PARTICULAS.DIR/Detect ores_2.pdf
Musienko, Y. (2017, Junio 30). Recent progress and perspectives in solid state photomultipliers [Archivo PDF]. Recuperado de:
https://seaquest-docdb.fnal.gov/cgi-bin/RetrieveFile?docid=2291&filename=Musienko-SiPMs-CERN-seminar_30.06.2017.pdf&version=1
Geeky Theory. Arduino + Raspberry Pi Lectura de datos. (s.f.). Recuperado de https://geekytheory.com/arduino-raspberry-pi-lectura-de-datos
CERN. Cloud (s.f.). Recuperado de https://home.cern/about/experiments/cloud
Chodos, A. (2010, Enero). This Month in Physics History. APS Physics. Volumen 19, número 1:
https://www.aps.org/publications/apsnews/201001/physi cshistory.cfm
Johnson, A. (2015, Abril 29). Cosmic rays illuminate the fields that cause lightning physicsworld: http://physicsworld.com/cws/article/news/2015/apr/29/c osmic-rays-illuminate-the-electric-fields-that-cause-lightning
Svensmark, H., Enghoff, M. B., Shaviv, N. J. & Svensmark, J. (2017, Diciembre 19). Increased Ionisation supports growth of aerosols into cloud condensation nuclei. Nature:
https://www.nature.com/articles/s41467-017-02082-2
Svensmark, H. Cosmic rays, clouds and climate [Archivo PDF]. Recuperado de: https://wattsupwiththat.files.wordpress.com/2017/12/svensmarkepn_46-2-2_ 2015.pdf
Cartlidge, E. (2013, Septiembre 9). Physicists claim further evidence of link between cosmic rays and cloud formation. physics world:
http://physicsworld.com/cws/article/news/2013/sep/09/physicists-claim-further-evidence-of-linkbetween-cosmic-rays-and-cloud-formation
Aberrón. (2009, Junio 27). ¿Qué ven los astronautas cuando cierran los ojos? Fogonazos:
http://www.fogonazos.es/2009/06/que-ven-los-astronautas-cuando-cierran.html
449
/ SEGUNDO PREMIO
AUTOR | PABLO SOTO MARTÍN
COORDINADORA | MARÍA GASPAR ALONSO-VEGA
CENTRO | IES SAN MATEO
CIUDAD | MADRID
RESUMEN |
Estudio de investigación sobre el problema abierto del cálculo del número mínimo de cuadrados de lado entero que teselan un rectángulo de lados también enteros. Se planteará el problema con criterios que ya otros investigadores han establecido. Al tratarse de un problema NP-completo, se intenta llegar a la solución mediante algoritmos de aproximación. Los algoritmos en los que nos hemos centrado en este estudio han sido el algoritmo de Euclides, un algoritmo clásico que se utiliza para calcular el máximo común divisor de dos números, y un algoritmo propio al que se le ha llamado Algoritmo Simplificado Recursivo (ASR). Estos algoritmos se han implementado en lenguaje Python, se han estudiado las soluciones que aportan, así como su error comparado con los resultados ya conocidos (Massimo Ortolano y otros investigadores han calculado hasta el rectángulo de dimensiones 388x388). El objetivo ha sido obtener patrones para extrapolarlos con la finalidad de obtener las soluciones a los casos todavía no conocidos. Tras analizar los resultados que el algoritmo de Euclides da para el problema plantado hemos visto que no era muy exacto, pero tras estudiar su error hemos podido crear una mejor aproximación. Al contrario, el ASR presentó una notable mejora y ha resultado más exacto que el algoritmo de Euclides. Por ello, se extrapoló hasta valores mucho mayores de los conocidos. Además, se ha procedido a hacer una comparación de ambos algoritmos.
Cálculo del mínimo número de cuadrados que teselan un rectángulo de lados enteros
450
CIENCIAS FÍSICAS, QUÍMICAS Y MATEMÁTICAS
ABSTRACT |
Research study on the open problem of calculating the minimum number of integer-side squares that tessellate a rectangle of also integer size. The problem will be set out with the criteria that other researchers have already established. As the problem is NP-complete, we try to arrive at the solution by the means of approximation algorithms. The algorithms that we have focused on in this study have been the Euclid’s Algorithm, an algorithm that is used to calculate the greatest common divisor of two numbers, and an own-created algorithm called the Simplified Recursive Algorithm (ASR). These algorithms have been implemented in Python language, the solutions that they provide have been studied, as well as their error compared with the already known results (Massimo Ortolano and other researchers have computed up to the rectangle of dimensions 388x388). The objective has been to obtain patterns to extrapolate them in order to obtain the solutions to cases not known yet. After implementing Euclid’s algorithm, we have seen that it was not very accurate, but after studying its error we have been able to create a better approximation. On the other hand, the Simplified Recursive Algorithm presented a remarkable improvement and has been more accurate than the Euclid’s Algorithm. Therefore, it was extrapolated to values much higher than the ones known. In addition, we have proceeded to make a comparison of both algorithms.
451
CIENCIAS FÍSICAS, QUÍMICAS Y MATEMÁTICAS
CERTAMEN JÓVENES INVESTIGADORES / Ciencias Físicas,
Químicas y Matemáticas
INTRODUCCIÓN
Las teselaciones han sido utilizadas por los humanos desde hace muchos años. Por ejemplo, en la construcción de la Alhambra ya se emplearon los 17 tipos básicos de teselaciones que se ha demostrado que existen [1]. Las teselaciones forman parte de nuestro día a día. Estas, no solo tienen aplicaciones en el arte, sino también las tienen en muchos campos más como en la construcción y la fabricación para optimizar costes; en computación y programación; en diseños 3D, en topografía, etcétera.
Toda teselación debe cumplir dos propiedades: tiene que cubrir la totalidad del espacio que ocupe el objeto al que tesele y no puede haber superposiciones entre las teselas.
Un problema interesante es encontrar la teselación que utiliza el menor número de teselas que cumplan una determinada propiedad. Por ejemplo, si queremos teselar un cuadrado con triángulos, utilizando el mínimo número de estos, necesitaremos dos triángulos. En este proyecto, nos centraremos en un problema de teselaciones de este tipo, el de teselar un rectángulo utilizando cuadrados, pero usando el mínimo número de estos.
ANTECEDENTES
Llamaremos h(m,n) a la función que expresa el número mínimo de cuadrados de lado entero necesarios para teselar un rectángulo de dimensiones mxn. Se clasifican las soluciones en cuatro casos distintos [3]:
• Caso cuadrado: Se dice de un rectángulo que tiene los lados iguales. Por lo tanto, h(m,n) =1 ya que con un cuadrado se tesela este rectángulo y no existe ninguna teselación que utilice menos de un cuadrado.
• Caso reducción: Se dice de un rectángulo de lados (dm,dn) cuya solución se puede reducir a la solución de un rectángulo de lados (m,n) (no se sabe si esta reducción se puede hacer para todo m y n).
• Caso división: Se dice de un rectángulo cuando la teselación que da la solución se puede dividir mediante un corte vertical u horizontal en dos rectángulos sin romper ningún cuadrado.
• Caso básico: Se dice de un rectángulo que no se puede expresar como ninguno de los casos anteriores. El primer rectángulo de caso básico es el 11x13.
Aunque actualmente no se haya conseguido expresar h(m,n) de forma general, sí que hay estudios matemáticos que demuestran la existencia de ciertas cotas para la función.
• Teorema 1: h(m,n) ≤ máx(m,n) [3]
• Teorema 2: Si 3m≥n2 entonces h(m+n,n) = h(m,n)+1 [3]
30º
452
Cálculo del mínimo número de cuadrados que teselan un rectángulo de lados enteros
Diferentes investigadores han propuesto varias conjeturas que podrían ayudar en la resolución del problema:
• Conjetura 1: En conexión con el Teorema 2, una conjetura era que ∀m≥n,h(m,n)+1 =h (m+n,n). Esta conjetura se demostró falsa con el contraejemplo: h(112,53) = h(59,53) = 11 [11].
• Diferentes investigadores han propuesto varias conjeturas que podrían ayudar en la resolución del problema:
• Conjetura 1: En conexión con el Teorema 2, una conjetura era que ∀m≥n,h(m,n)+1 =h (m+n,n). Esta conjetura se demostró falsa con el contraejemplo: h(112,53) = h(59,53) = 11 [11].
• Conjetura 2: ∀ m,n;h(m,n) = h(km,kn). Aún no se ha encontrado ningún contraejemplo de ella, pero se cree que es falsa ya que existe una base de datos en la que se exponen muchos posibles contraejemplos, aunque ninguno de ellos ha sido demostrado todavía [10].
• Conjetura 2: ∀m,n;h(m,n) = h(km,kn). Aún no se ha encontrado ningún contraejemplo de ella, pero se cree que es falsa ya que existe una base de datos en la que se exponen muchos posibles contraejemplos, aunque ninguno de ellos ha sido demostrado todavía [10].
• Conjetura 3: ∀m,n tal que 2n≥m≥n con m,n coprimos;
• Conjetura 3: ∀ m,n tal que 2n≥m≥n con m,n coprimos;
Hipótesis, Objetivos y Metodología
HIPÓTESIS, OBJETIVOS Y METODOLOGÍA
En este proyecto de investigación se quiere dar respuesta a esta cuestión: ¿Cuál es el mínimo número de cuadrados de lado entero que se necesitarán para teselar un rectángulo también de lado entero? Dar solución a esta pregunta puede ser útil para distintos ámbitos: se puede aplicar a técnicas de integración de circuitos eléctricos (de hecho, hay físicos que actualmente están estudiando el problema [9]) y también para resolver el problema de asignación de subtramas de enlace en la tecnología WiMAX [7] (una gran red Wifi que suele abarcar grandes territorios como ciudades), entre otros.
En este proyecto de investigación se quiere dar respuesta a esta cuestión: ¿Cuál es el mínimo número de cuadrados de lado entero que se necesitarán para teselar un rectángulo también de lado entero? Dar solución a esta pregunta puede ser útil para distintos ámbitos: se puede aplicar a técnicas de integración de circuitos eléctricos (de hecho, hay físicos que actualmente están estudiando el problema [9]) y también para resolver el problema de asignación de subtramas de enlace en la tecnología WiMAX [7] (una gran red Wifi que suele abarcar grandes territorios como ciudades), entre otros.
Por los estudios previos publicados por distintos investigadores entre los que destacan Monaci y Santos [8], conocemos que el problema del cálculo del mínimo número de cuadrados es NP-completo, por lo que será imprescindible abordarlo con otro tipo de algoritmos que no sea el de fuerza bruta. De todos modos, Massimo Ortolano y otros investigadores han aplicado este algoritmo hasta el rectángulo de dimensiones 388x388 [9].
Por los estudios previos publicados por distintos investigadores entre los que destacan Monaci y Santos [8], conocemos que el problema del cálculo del mínimo número de cuadrados es NP-completo, por lo que será imprescindible abordarlo con otro tipo de algoritmos que no sea el de fuerza bruta. De todos modos, Massimo Ortolano y otros investigadores han aplicado este algoritmo hasta el rectángulo de dimensiones 388x388 [9].
Debido a la complejidad que presenta, la metodología seguida para resolver este problema ha sido la de buscar otros algoritmos que, aunque no den la solución exacta, se acerquen lo más posible a ella sin requerir demasiada capacidad de cálculo.
Debido a la complejidad que presenta, la metodología seguida para resolver este problema ha sido la de buscar otros algoritmos que, aunque no den la solución exacta, se acerquen lo más posible a ella sin requerir demasiada capacidad de cálculo.
En una primera fase de la investigación hemos realizado una búsqueda de posibles algoritmos que dieran una solución aceptable al problema, para en una segunda fase, centrarnos en algunos de ellos y realizar un estudio más profundo de las soluciones aportadas. Principalmente nos hemos centrado en el estudio del algoritmo de Euclides y de un algoritmo propio llamado Algoritmo Simplificado Recursivo (ASR).
En una primera fase de la investigación hemos realizado una búsqueda de posibles algoritmos que dieran una solución aceptable al problema, para en una segunda fase, centrarnos en algunos de ellos y realizar un estudio más profundo de las soluciones aportadas. Principalmente nos hemos centrado en el estudio del algoritmo de Euclides y de un algoritmo propio llamado Algoritmo Simplificado Recursivo (ASR).
453
CERTAMEN JÓVENES INVESTIGADORES / Ciencias Físicas,
Químicas y Matemáticas
RESULTADOS
algoritmo que se ha implementado ha sido el algoritmo de Euclides. conocido algoritmo que se utiliza para calcular el máximo común dos números. Este algoritmo se puede aplicar también a distancias geométricas, que es de hecho como lo formula Euclides originalmente, y como utilizar en este proyecto [2]. Así, el valor que dará el algoritmo de para h(m,n) será el de la suma de los coeficientes de la fracción continua del lado mayor entre el lado menor. Este algoritmo es muy eficiente, tiene una complejidad de O(log(n)) [12]. Por ello, es muy fácil llegar a resultados de rectángulos con lados muy grandes. Este algoritmo no da la solución exacta al problema, así que vamos a analizar su error comparándolo con los resultados ya existentes. En la figura 1 se muestra la diferencia entre los datos generados por el algoritmo de Euclides y los datos de soluciones ya calculados por [9]. Si analizamos valores estadísticos como la media de error absoluto, la media de error relativo y la típica, que son 8.8912, 73.931% y 21.13857 respectivamente, el error cometido por es bastante grande. 1 podemos ver con el error que comete. tabla, se expresa el puntos en los cuales el comete un error menor valor dado. Además, muestra el porcentaje que representa ese sobre el total. Podemos ver que solo un quinto de los valores calculados no tiene error. Además, la



El primer algoritmo que se ha implementado ha sido el algoritmo de Euclides. Este es un conocido algoritmo que se utiliza para calcular el máximo común divisor de dos números. Este algoritmo se puede aplicar también a distancias geométricas, que es de hecho como lo formula Euclides originalmente, y como se va a utilizar en este proyecto [2]. Así, el valor que dará el algoritmo de Euclides para h(m,n) será el de la suma de los coeficientes de la fracción continua del lado mayor entre el lado menor. Este algoritmo es muy eficiente, tiene una complejidad de O(log(n)) [12]. Por ello, es muy fácil llegar

El primer algoritmo que se ha implementado ha sido el algoritmo Este es un conocido algoritmo que se utiliza para calcular el divisor de dos números. Este algoritmo se puede aplicar también geométricas, que es de hecho como lo formula Euclides originalmente, se va a utilizar en este proyecto [2]. Así, el valor que dará Euclides para h(m,n) será el de la suma de los coeficientes continua del lado mayor menor. Este algoritmo es tiene una complejidad de Por ello, es muy fácil llegar de rectángulos con lados Este algoritmo no da la solución problema, así que vamos error comparándolo con los existentes. En la figura 1 diferencia entre los datos el algoritmo de Euclides las soluciones ya calculados por [9]. Si analizamos valores generales como la media de error absoluto, la media de error desviación típica, que son 8.8912, 73.931% y 21.13857 respectivamente, vemos que el error cometido por el algoritmo es bastante grande.
a resultados de rectángulos con lados muy grandes. Este algoritmo no da la solución exacta al problema, así que vamos a analizar su error comparándolo con los resultados ya existentes. En la figura 1 se muestra la diferencia entre los datos generados por el algoritmo de Euclides y los datos de las soluciones ya calculados por [9]. Si analizamos valores estadísticos generales como la media de error absoluto, la media de error relativo y la desviación típica, que son 8.8912, 73.931% y 21.13857 respectivamente, vemos que el error cometido por
En la tabla 1 podemos ver con más detalle el error que comete. En esta tabla, se expresa el s, muestra el porcentaje que Podemos ver que solo un quinto calculados no tiene error. mitad de los datos tiene un igual que tres. Por lo tanto, por sí solo no consigue aproximación eficaz al problema.

figura 1 podemos observar

454
30º
Tabla 1: Error algoritmo de
Fig. 1: Error absoluto del algoritmo de Euclides
Tabla 1: Error algoritmo de Euclides
absoluto del algoritmo de Euclides
Figura 01
Error absoluto del algoritmo de Euclides.
Tabla 01
Error algoritmo de Euclides.
el algoritmo es bastante grande. En la tabla 1 podemos ver con más detalle el error que comete. En esta tabla, se expresa el número de puntos en los cuales el algoritmo comete un error menor o igual al valor dado. Además, muestra el porcentaje que representa ese número sobre el total. Podemos ver que solo un quinto de los valores calculados no tiene error. Además, la mitad de los datos tiene un error mayor o igual que tres. Por lo tanto, este algoritmo por sí solo no consigue hacer una aproximación eficaz al problema. En la figura 1 podemos observar que existe una mayor densidad de error alrededor de ciertas rectas de pendiente entera que se cortan en el origen. El patrón que parece seguir el error hace que sea más fácil un estudio con la intención de conseguir eliminarlo. La distribución de este error absoluto se asemeja mucho a la figura 2 donde se representan el número de divisiones u operaciones necesarias para llevar a cabo el algoritmo de Euclides. Ahora procederemos a estudiar cada gráfico y a compararlos para buscar patrones en común.
el algoritmo de Euclides las soluciones ya calculados por [9]. Si analizamos valores generales como la media de error absoluto, la media de error desviación típica, que son 8.8912, 73.931% y 21.13857 respectivamente, vemos que el error cometido por el algoritmo es bastante grande. En la tabla 1 podemos ver con más detalle el error que comete. En esta tabla, se expresa el número de puntos en los cuales el algoritmo comete un error menor o igual al valor dado. Además, muestra el porcentaje que número sobre el total. Podemos ver que solo un quinto calculados no tiene error. mitad de los datos tiene un igual que tres. Por lo tanto, por sí solo no consigue aproximación eficaz al problema. figura 1 podemos observar una mayor densidad de de ciertas rectas de pendiente se cortan en el origen. parece seguir el error hace fácil un estudio con la conseguir eliminarlo. La este error absoluto se asemeja la figura 2 donde se representan el número de divisiones

Por lo general, parece que existe una correlación entre ambos gráficos, ya que comparten algunas propiedades como se desarrolla en más detalle en el artículo completo. Definamos el número necesario de operaciones del algoritmo de Euclides para dos números a y b como D(a,b). Para un estudio más profundo se ha procedido a separar los puntos de coordenadas (a,b) que tengan distinto valor para D(a,b). El valor máximo para D(a,b) en el gráfico va a ser 12. Así pues, el gráfico del error se subdividirá en 12 gráficos de detalle. En estas imágenes vemos dos ejemplos, con el valor 7 y 8. Si se analizan más detenidamente, podemos observar que si partimos uno de los gráficos con valor de D(a,b) = n de forma que contenga a todos los puntos con coordenadas menores a F m , donde F m es el m-ésimo número de Fibonacci, el siguiente gráfico con dimensiones Fm+1 x Fm+1 tiene una distribución muy parecida y valores bastante parecidos al anterior. Por lo tanto, sería interesante aproximar un gráfico en el que por cada punto sus coordenadas (a,b) cumplan que D(a,b) = n y tenga dimensiones F m x F m mediante un gráfico que cumpla que D(a,b) = n−1 y que tenga dimensiones Fm-1 x Fm-1 . Para la aproximación cada punto del nuevo gráfico puede tomar el valor del punto más cercano del gráfico anterior. Debido


455
error comparándolo con los existentes. En la figura 1
diferencia entre los datos
Tabla 1: Error algoritmo de
Fig. 1: Error absoluto del algoritmo de Euclides
Fig. 2: Número de operaciones hechas por el algoritmo de Euclides
Figura 02
Número de operaciones hechas por el algoritmo de Euclides.
Cálculo del mínimo número de cuadrados que teselan un rectángulo de lados enteros
meros a y b como D(a,b). Para un estudio más separar los puntos de coordenadas (a,b) que D(a,b). El valor máximo para D(a,b) en el gráfico va a error se subdividirá en 12 gráficos de detalle. En ejemplos, con el valor 7 y 8. Si se analizan más observar que si partimos
cada punto sus coordenadas (a,b) cumplan D(a,b) = n y tenga dimensiones
CERTAMEN JÓVENES INVESTIGADORES / Ciencias Físicas, Químicas y
D(a,b) = n de forma puntos con coordenadas m-ésimo número de con dimensiones distribución muy parecida y anterior. Por lo tanto, gráfico en el que por (a,b) cumplan que mediante


D(a,b) = n−1 y que tenga dimensiones . punto del nuevo gráfico puede tomar el valor del anterior. Debido a que ambos gráficos tienen tamaños diferentes, para conseguir la aproximación se puede dividir cada coordenada entre las dimensiones del gráfico. Así se consigue fracción sobre el total a la que está cada coordenada. Así se haría posible aproximar, a partir de un gráfico inicial, el gráfico siguiente. Si hace este proceso individualmente para cada fico de detalle, se podría obtener una aproximación completa desde un gráfico de dimensiones a otro de para todos los valores de sirve para el 1 ya que no existe una soluci el algoritmo de Euclides en los rect siempre es cero. Como consecuencia este (ya que estos puntos ha tomado para arreglar este desajuste en el de h(m,n) siguiendo la conjetura 3 para estos puede evitar generar un pequeño error, pero así aproximación. Se hará una implementación de fico 233x233 = a uno de 377x377
Matemáticas
un gráfico que cumpla que D(a,b) = n−1 Para la aproximación cada punto del punto más cercano del gráfico anterior.
tamaños aproximaci entre las la fracció coordenada. partir de se hace gráfico de aproximaci
dimensiones
comprobar la efectividad de la aproximación; y una gráfico 377x377 hasta el 610x610 = siguiendo proyecto. Tras la implementación, se han obtenido los analizamos valores estadísticos generales, la absoluto medio de 8.078, un error relativo medio de típica de 20.872. En cambio, hasta el 377x377 el un error absoluto medio de 8.863, un error relativo desviación típica de 21.045. En comparación, esta todo exacta, pero se parece bastante. La siguiente entre los datos de la aproximación y los datos del El color predominante corresponde a un error nulo o podemos observar que en acumula mayor error son rectilíneas donde el producía mayor error. En observar el número total de aproximación comete indicado (en valor muestra el porcentaje de representa ese número de puntos. Podemos ver que datos tiene un error 0. Esto supone un gran avance
a que ambos gráficos tienen tamaños diferentes, para conseguir la aproximación se puede dividir cada coordenada entre las dimensiones del gráfico. Así se consigue la fracción sobre el total a la que está cada coordenada. Así se haría posible aproximar, a partir de un gráfico inicial, el gráfico siguiente. Si se hace este proceso individualmente para cada gráfico de detalle, se podría obtener una aproximación completa desde un gráfico de dimensiones F m x F m a otro de dimensiones Fm+1x Fm+1 . Este método sirve para todos los valores de n tal que D(a,b) =n excepto para el 1 y para el 2. No sirve para el 1 ya que no existe una solución a D(a,b) =0. El error que comete el algoritmo de Euclides en los rectángulos de lados a, b tales que D(a,b)=1 siempre es cero. Como consecuencia este método tampoco sirve para el 2 (ya que estos puntos no tienen error 0 en la realidad). La medida que se ha tomado para arreglar este desajuste en el método ha sido suponer el valor de h(m,n) siguiendo la conjetura 3 para estos valores. Esta medida no puede evitar generar un pequeño error, pero así quedaría completo el método de aproximación. Se hará una implementación de este método desde el gráfico 233x233 = F1ax F 1a a uno de 377x377 = F14x F 14 para comprobar la efectividad de la aproximación; y una aproximación desde el gráfico 377x377 hasta el 610x610 = F15x F 15 siguiendo con los objetivos del
. Este método sirve para excepto para el 1 y para el 2. No sirve D(a,b) =0. El error que comete el algoritmo lados a, b tales que D(a,b)=1 siempre método tampoco sirve para el 2 (ya que realidad). La medida que se ha tomado método ha sido suponer el valor de h(m,n) valores. Esta medida no puede evitar quedaría completo el método de aproximaci este método desde el gráfico 233x233

456
30º
Fig. 3: Error absoluto del algoritmo de Euclides con D(a,b)=7
Fig. 5: Comparación del error absoluto tras aproximación al 377
Fig. 4: Error absoluto del algoritmo de Euclides con D(a,b)= 8
Figura 03
Error absoluto del algoritmode Euclides con D(a,b)=7
Figura 04
Error absoluto del algoritmo de Euclides con D(a,b)= 8
Figura 05
Comparación del error absoluto tras aproximación al 377.
proyecto. Tras la implementación, se han obtenido los siguientes resultados. Si analizamos valores estadísticos generales, la aproximación tiene un error absoluto medio de 8.078, un error relativo medio de 67.74 % y una desviación típica de 20.872. En cambio, hasta el 377x377 el algoritmo de Euclides tiene un error absoluto medio de 8.863, un error relativo medio de 73.77 % y una desviación típica de 21.045. En comparación, esta aproximación no es del todo exacta, pero se parece bastante. La siguiente figura muestra la diferencia entre los datos de la aproximación y los datos del error absoluto conocidos. El color predominante es el verde, que corresponde a un error nulo o pequeño. Además, podemos observar que en las zonas donde se acumula mayor error son otra vez las mismas zonas rectilíneas donde el algoritmo de Euclides producía mayor error. En la tabla 2 se puede observar el número total de puntos para los cuales la aproximación comete un error menor o igual al indicado (en valor absoluto). Además, se muestra el porcentaje de los puntos totales que repre-
figura muestra la diferencia entre los datos de la aproximaci error absoluto conocidos. El color predominante es el verde, que corresponde a un error nulo o pequeño. Además, podemos observar que en las zonas donde se acumula mayor error son otra vez las mismas zonas rectilíneas donde el algoritmo de Euclides producía mayor error. En la tabla 2 se puede observar el número total de puntos para los cuales la aproximación comete un error menor o igual al indicado (en valor absoluto). Además, se muestra el porcentaje de los puntos totales que representa ese número de puntos. alrededor del 70% de los datos tiene un error 0. Esto supone en comparación con el algoritmo de Euclides que acierta 19.5% de los rect Los porcentajes no son perfectos, notablemente la algoritmo de Euclides. Sin embargo, el método tiene errores negativos, lo que provoca que la incertidumbre de la solució

senta ese número de puntos. Podemos ver que alrededor del 70% de los datos tiene un error 0. Esto supone un gran avance en comparación con el algoritmo de Euclides que acierta sin errores solo el 19.5% de los rectángulos (Tabla 1). Los porcentajes de acierto, aunque no son perfectos, mejoran notablemente la actuación del algoritmo de Euclides. Sin embargo, el método tiene errores positivos o negativos, lo que provoca que la incertidumbre de la solución sea más grande. El 90 % de los datos se encuentran en un intervalo de longitud 11 (exactamente el [-5,5]). Además, al querer aproximar el error del algoritmo de Euclides a valores bastante más altos, el error se volvería cada vez más grande ya que al tener que hacerse la aproximación de forma escalonada (se pasa de dimensiones F m x F m a dimensiones Fm+1x Fm+1 ) el error se acumula y arrastra. Esto se debe a que no siempre se puede partir de un gráfico con error 0 como es este caso. El método de aproximación, además de para este caso, también se ha implementado para aproximar el gráfico del error absoluto cometido por el algoritmo de Euclides hasta dimensiones 610x610 utilizando los datos del gráfico de dimensiones 377x377.
Con objeto de mejorar los resultados obtenidos por el algoritmo de Euclides, he diseñado un nuevo algoritmo, basado en los casos de división, al que he denominado Algoritmo Simplificado Recursivo (ASR). Como indica su nombre, es simplificado ya que no calcula todas las distintas teselaciones para sacar la aproximación de h(m,n), y es recursivo ya que basa su respuesta en las soluciones que ha calculado previamente. El algoritmo funciona de la siguiente

El 90 % de los datos se encuentran en un intervalo (exactamente el [-5,5]). Además, al querer aproximar el error Euclides a valores bastante más altos, el error se volve grande ya que al tener que hacerse la aproximación de forma pasa de dimensiones a dimensiones ) y arrastra. Esto se debe a que no siempre se puede partir error 0 como es este caso. El método de aproximación, adem caso, también se ha implementado para aproximar el gráfico cometido por el algoritmo de Euclides hasta dimensiones los datos del gráfico de dimensiones 377x377.
Con objeto de mejorar los resultados obtenidos por el algoritmo diseñado un nuevo algoritmo, basado en los casos de denominado Algoritmo Simplificado Recursivo (ASR). Como
457
aproximaci n no es del todo exacta, per parece
Fig. 5: Comparación aproximación
Tabla 2
Tabla
02
Cálculo del mínimo número de cuadrados que teselan un rectángulo de lados enteros
distinguen dos casos:
es simplificado ya que no calcula todas las distintas teselaciones para sacar la aproximación de h(m,n), y es recursivo ya que basa su respuesta en las soluciones que ha calculado previamente. El algoritmo funciona de la siguiente manera: dado un rectángulo del que se quiere conocer la teselación mínima, se distinguen dos casos:
JÓVENES INVESTIGADORES / Ciencias Físicas, Químicas y Matemáticas


• El primer caso ocurriría cuando el lado menor del rectángulo lado mayor. Entonces el algoritmo devuelve el cociente (esto se demostró cierto anteriormente).
• El primer caso ocurriría cuando el lado menor del rectángulo divide al lado mayor. Entonces el algoritmo devuelve el cociente de ambos lados (esto se demostró cierto anteriormente).
manera: dado un rectángulo del que se quiere conocer la teselación mínima, se distinguen dos casos:
• El segundo caso es para las demás posibilidades. Dado que no cumpla la condición del primer caso:
• El segundo caso es para las demás posibilidades. Dado un rectángulo que no cumpla la condición del primer caso:
• El primer caso ocurriría cuando el lado menor del rectángulo divide al lado mayor. Entonces el algoritmo devuelve el cociente de ambos lados (esto se demostró cierto anteriormente).
• El segundo caso es para las demás posibilidades. Dado un rectángulo que no cumpla la condición del primer caso:
1. Se hace un corte vertical separando al rectángulo en dos rectángulos con uno de los lados más pequeños. Al ser los dos rectángulos más pequeños, sus soluciones ya se habrían calculado previamente.
1. Se hace un corte vertical separando al rectángulo rectángulos con uno de los lados más pequeños. rectángulos más pequeños, sus soluciones calculado previamente.


1. Se hace un corte vertical separando al rectángulo en dos rectángulos con uno de los lados más pequeños. Al ser los dos rectángulos más pequeños, sus soluciones ya se habrían calculado previamente.
2. Después, ambas soluciones se suman.
2. Después, ambas soluciones se suman.
2. Después, ambas soluciones se suman.
3. Análogamente, esto se repite con todos los posibles cortes verticales y horizontales.
3. Análogamente, esto se repite con todos los posibles cortes verticales y horizontales.
3. Análogamente, esto se repite con todos los verticales y horizontales.
Entonces el algoritmo devuelve la menor suma de las obtenidas. nte eficiente, ya que para cada rectángulo de lados m y m2 operaciones. Por es fácil obtener resultados de rectángulos con lados muy grandes. Como ocurría con el algoritmo de Euclides, este algoritmo no da la solución exacta al problema, así que analizaremos su error comparándolo con las soluciones ya conocidas. En la figura 6 podemos observar el gráfico que muestra el error absoluto que da este algoritmo hasta el rectángulo de lados 380x380. Estadísticamente, el error cometido por este algoritmo es pequeño: su media de error absoluto es de
Entonces el algoritmo devuelve la menor suma de las obtenidas. Este algoritmo es bastante eficiente, ya que para cada rectángulo de lados [m2]+[n2] operaciones. Por ello, es fácil obtener resultados de rectángulos con lados muy grandes. Como ocurría con el algoritmo de Euclides, este algoritmo no da la solución exacta al problema, así que analizaremos su error compa rándolo con las soluciones ya conocidas. En la figura 6 podemos observar el gráfico que muestra el error absoluto que da este algoritmo hasta el rectángulo de lados 380x380. Estadísticamente, el error cometido por este algoritmo es pe-
Entonces el algoritmo devuelve la menor suma de las obtenidas. Este algoritmo es bastante eficiente,
necesitan operaciones. ello, obtener resultados de rectángulos con lados muy grandes. Como algoritmo de Euclides, este algoritmo no da la solución exacta que analizaremos su error comparándolo con las soluciones ya

n

30º
458
CERTAMEN
Figura 06
ngulo del que se quie
Error absoluto del algoritmode ASR.
cada rectángulo
se
Tabla 3
03
Fig. 6: Error absoluto del algoritmo Tabla
queño: su media de error absoluto es de 0.691662, su media de error relativo es de 5.832 % y su desviación típica es de 1.0457. La distribución de error es bastante dispersa y no se aprecia a primera vista un patrón claro. Aun así, se aprecia una mayor densidad de error alrededor de las rectas con pendiente entera, como en el algoritmo de Euclides. Al igual que con los demás algoritmos, procederemos a analizar su error mediante la tabla 3. En la esta tabla se puede observar el número de puntos en los que la aproximación ha cometido un error menor o igual al indicado. También se muestran los porcentajes sobre el total de datos. Podemos observar que con este algoritmo calculamos correctamente más del 50 % de los resultados (frente al 20 % del algoritmo de Euclides), lo que supone una mejora importante, aunque sigue estando lejos del 100 %. Lo destacado de este algoritmo es que más del 95 % de los datos tienen un error menor o igual que dos, lo que hace que sea bastante preciso y con una incertidumbre baja. Además, el número de datos que tienen un error grande o mayor
0.691662, su media de error relativo es de 5.832 % y su desviación típica es de 1.0457. La distribución de error es bastante dispersa y no se aprecia a primera vista un patrón claro. Aun así, se aprecia una mayor densidad de error alrededor de las rectas con pendiente entera, como en el algoritmo de Euclides. Al igual que con los demás algoritmos, procederemos a analizar su error mediante la tabla 3. En la esta tabla se puede observar el número de puntos en los que la aproximación ha cometido un error menor o igual al indicado. También se muestran los porcentajes sobre el total de datos. Podemos observar que con este algoritmo calculamos correctamente más del 50 % de los resultados (frente al 20 % del algoritmo de Euclides), lo que supone una mejora importante, aunque sigue estando lejos del 100 %. Lo destacado de este algoritmo es que más del 95 % de los datos tienen un error menor o igual que dos, lo que hace que sea bastante preciso y con una incertidumbre baja. Además, el número de datos que tienen un error grande o mayor que 4 es ínfimo (menor que el 0.8 %). Podemos concluir que este algoritmo es muy eficaz y nos permite hallar las soluciones sin demasiado error. Siguiendo con los objetivos del proyecto procedemos a realizar una extrapolación de los resultados para todos los rectángulos que tengan lados menores a 1000. La figura 7 es el resultado de esta implementación. En ella, se han suprimido los valores que cumplían el Teorema 2 para una mejor visión de los resultados. En la zona central, se puede apreciar en color verde, que según la leyenda indica un error ligeramente mayor al de color azul, los puntos que tienen mayor error absoluto.
que 4 es ínfimo (menor que el 0.8 %). Podemos concluir que este algoritmo es muy eficaz y nos permite hallar las soluciones sin demasiado error. Siguiendo con los objetivos del proyecto procedemos a realizar una extrapolación de los resultados para todos los rectángulos que tengan lados menores a 1000. La figura 7 es el resultado de esta implementación. En ella, se han suprimido los valores que cumplían el Teorema 2 para una mejor visión de los resultados. En la zona central, se puede apreciar en color verde, que según la leyenda indica un error ligeramente mayor al de color azul, los puntos que tienen mayor error absoluto.
Tras estudiar el error de los algoritmos propuestos, analizar los patrones que este sigue y hacer una extrapolación a los resultados no conocidos, procedemos a comparar todos estos datos. En cuanto al error, hemos observado que el ASR es bastante más exacto que el algoritmo de Euclides. Esto es así ya que, por definición del algoritmo, el ASR engloba todas las soluciones queda el algoritmo de Euclides y muchas más. Para ver que esto se cumple no solo en los rectángulos de lados menores que 380, se ha calculado esta misma media de error en función de las dimensiones de los gráficos conocidos (desde dimensiones 1x1
Tras estudiar el error de los algoritmos propuestos, analizar los patrones que este sigue y hacer una extrapolación a los resultados no conocidos, procedemos a comparar todos estos datos. En cuanto al error, hemos observado que el ASR es bastante más exacto que el algoritmo de Euclides. Esto es así ya que, por definición del algoritmo, el ASR engloba todas las soluciones queda el algoritmo de Euclides y muchas más. Para ver que esto se cumple no solo en los


459
Fig. 7: Extrapolación hasta 1000x1000
Extrapolación hasta 1000x1000
Figura 07
Cálculo del mínimo número de cuadrados que teselan un rectángulo de lados enteros
apreciar en color verde, que según la leyenda indica un error mayor al de color azul, los puntos que tienen mayor error absoluto. estudiar el error de los algoritmos propuestos, analizar los patrones que y hacer una extrapolación a los resultados no conocidos, procedemos a comparar todos estos datos. En cuanto al error, hemos que el ASR es bastante más exacto que el algoritmo de Euclides. í ya que, por definición del algoritmo, el ASR engloba todas las queda el algoritmo de muchas más. Para ver que cumple no solo en los de lados menores que ha calculado esta misma error en función de las dimensiones de los gráficos conocidos dimensiones 1x1 hasta Los resultados se pueden
visualizar corresponden ASR respectivamente. la evoluci forma parecida, escalas de del ASR el del algoritmo suavidad figura 9, estudio más detallado. En cuanto a la algoritmos son bastante eficientes. El algoritmo eficiente (complejidad logarítmica) ya que ambos son viables para su ejecución. Finalmente, ser recursivo, cuando comete error lo acumula gráfico de dimensiones 380x380 el 52.22 % 34.26 % de los puntos tenían error 1 (tabla 3). el error se incremente conforme aumentan las
hasta 380x380). Los resultados se pueden visualizar en la figura 9 y la figura 8, que corresponden al algoritmo de Euclides y al ASR respectivamente. Podemos ver como la evolución del error medio sigue una forma parecida, pero si se observan las escalas de los gráficos, se puede ver que el del ASR siempre es mucho más exacto que el del algoritmo de Euclides. Destaca la suavidad que presenta la función de la figura 9, que podría ser objeto de un estudio más detallado. En cuanto a la eficiencia computacional, ambos algoritmos son bastante eficientes. El algoritmo de Euclides es un poco más eficiente (complejidad logarítmica) ya que debe calcular menos casos, pero ambos son viables para su ejecución. Finalmente, cabe destacar que el ASR, al ser recursivo, cuando comete error lo acumula y lo arrastra. Por ejemplo, en el gráfico de dimensiones 380x380 el 52.22 % de los puntos tenían error 0 y un 34.26 % de los puntos tenían error 1 (tabla 3). Debido a esto, se esperará que el error se incremente conforme aumentan las dimensiones del rectángulo.


CONCLUSIONES
Conclusiones
Por los estudios previos publicados por distintos destacan Monaci y Santos [8], conocemos mínimo número de cuadrados es NP-completo, abordarlo con otro tipo de algoritmos que no Por ello, la estrategia seguida para resolver este otros algoritmos que, aunque no den la soluci posible a ella sin requerir demasiada capacidad centrado en el estudio del algoritmo de Euclides llamado Algoritmo Simplificado Recursivo (ASR).
Por los estudios previos publicados por distintos investigadores entre los que destacan Monaci y Santos [8], conocemos que el problema del cálculo del mínimo número de cuadrados es NP-completo, por lo que sería imprescindible abordarlo con otro tipo de algoritmos que no sea el algoritmo de fuerza bruta. Por ello, la estrategia seguida para resolver este problema ha sido la de buscar otros algoritmos que, aunque no den la solución exacta, se acerquen lo más posible a ella sin requerir demasiada capacidad de cálculo. Nos hemos centrado en el estudio del algoritmo de Euclides y de un algoritmo propio llamado Algoritmo Simplificado Recursivo (ASR).
Después del estudio detallado de estos algoritmos,
• El algoritmo de Euclides ha resultado sí muy eficiente computacionalmente.
Después del estudio detallado de estos algoritmos, podemos concluir que:
• El algoritmo de Euclides ha resultado no ser demasiado exacto, aunque sí muy eficiente computacionalmente. Sin embargo, su error se distribuye de una forma muy característica, lo que nos ha permitido realizar un estudio sobre su error, y
distribuye de una forma muy característica, realizar un estudio sobre su error, y aproximarlo tener una solución más exacta que la
• El ASR, ha resultado ser un algoritmo tanto como el algoritmo de Euclides, computacionalmente. Sin embargo, su más caótica y no se han podido identificar
30º
460
CERTAMEN JÓVENES INVESTIGADORES / Ciencias Físicas, Químicas y Matemáticas
Fig. 8: Error medio del algoritmo ASR
Fig. 9: Error medio del algoritmo de Euclides
Figura 08
Error medio del algoritmo ASR.
Figura 09
Error medio del algoritmo de Euclides.
Cálculo del mínimo número de cuadrados que teselan un rectángulo de lados enteros
aproximarlo de forma que podamos tener una solución más exacta que la que da el algoritmo inicialmente.
• El ASR, ha resultado ser un algoritmo bastante exacto y, aunque no tanto como el algoritmo de Euclides, es también eficiente computacionalmente. Sin embargo, su error se distribuye de una forma más caótica y no se han podido identificar patrones claros.
No se ha conseguido encontrar la solución exacta al problema, pero sí que hemos conseguido aproximarnos a ella cometiendo un pequeño error y sin la necesidad de disponer de demasiada capacidad de cálculo, como era el objetivo del proyecto. Con vistas al futuro, sería interesante seguir investigando en incorporar mejoras al algoritmo ASR, especialmente para mejorar los casos donde se produce mayor error, así como ver cómo evitar la propagación del error que se produce por la recursividad. Solventados estos problemas se podría dar una solución más precisa al problema planteado.
461
30º CERTAMEN JÓVENES INVESTIGADORES / Ciencias Físicas, Químicas y Matemáticas
BIBLIOGRAFÍA
ARDILA, F. y STANLEY, R. P. Tilings, 2005.
URL: https://arxiv.org/abs/math/0501170v3
EUCLIDES. The thirteen books of Euclid’s elements. Dover books explaining science and mathematics. Dover Publications Cambridge University Press, New York London, 2nd ed. rev. with additions. Edicio´n, 1956. ISBN: 0486600882.
FELGENHAUER, B. Filling rectangles with integer-sided squares, 2017.
URL: http://int-e.eu/~bf3/squares/
KENYON, R. A note on tiling with integer-sided rectangles. Journal of Combinatorial Theory, Series A, 74(2):321-332, 1996. DOI: 10.1006/jcta.1996.0053
URL: https://www.sciencedirect.com/science/article/pii/S0097316596900539
KENYON, R. Tiling a rectangle with the fewest squares. Journal of Combinatorial Theory, Series A, 76(2):272-291, 1996. DOI: 10.1006/jcta.1996.0104
URL: https://www.sciencedirect.com/science/article/pii/S0097316596901041
KURZ, S. Squaring the square with integer linear programming. Journal of Information Processing, 20(3):680-685, 2012. DOI: 10.2197/ipsjjip.20.680.
LODI, A., MARTELLO, S., MONACI, M., CICCONETTI, C., LENZINI, L., MINGOZZI, E., EKLUND, C. y MOILANEN, J. Efficient two-dimensional packing algorithms for mobile wimax. Management Science, 57:2130-2144, dic. de 2011. DOI: 10.2307/41406337
MONACI, M. y SANTOS, A. G. dos. Minimum tiling of a rectangle by squares. Annals of Operations Research, 2018. DOI: 10 . 1007 / s10479 - 017 - 2746 - 2.
URL: https://doi.org/10.1007/s10479-017-2746-2
ORTOLANO, M., ABRATE, M. y CALLEGARO, L. On the synthesis of quantum hall array resistance standards. Metrologia, 52(1):31-39, feb. de 2015. DOI: 10.1088/0026-1394/52/1/31
PEGG, E. Possible counterexamples to the minimal squaring conjecture, Jul, 2017.
URL: https://goo.gl/Mvurme
PEGG, E. Minimally squared rectangles, 2013.
URL: http://demonstrations.wolfram.com/MinimallySquaredRectangles/ WALTERS, M. Rectangles as sums of squares. Discrete mathematics, Volume 309, Issue 9:2913-2921, 2009. DOI://doi.org/10.1016/j.disc.2008.07.028
462
463
CIENCIAS FÍSICAS, QUÍMICAS Y MATEMÁTICAS
Estudio espectrofotométrico de fuentes de luz artificiales y de la luz solar
/ TERCER PREMIO
AUTORES | JAVIER SÁNCHEZ-BONILLA MARTÍNEZ Y JUAN ÁLVAREZ ORDINAS
COORDINADOR | JOSÉ FRANCISCO ROMERO GARCÍA
CENTRO | CC RETAMAR
CIUDAD | POZUELO DE ALARCÓN-MADRID
RESUMEN |
Este trabajo consiste en un estudio espectrofotométrico de diversas fuentes de luz del laboratorio y un estudio del espectro de la luz recibida del Sol. Para ello, construimos un espectrofotómetro y escribimos un programa informático para analizar los datos obtenidos y calibrar la longitud de onda. El espectrómetro está compuesto por una webcam y un DVD actuando como red de difracción. Gracias a este instrumento hemos podido obtener datos de calidad científica sin tener que pagar miles de euros. El estudio de la luz que pasa a través de la atmósfera nos permite obtener mucha información sobre su composición.
ABSTRACT |
This paper consists of a spectrometric study of many light sources found in our laboratory as well as of the spectrum of sunlight received at ground level. To do so, we built a spectrometer and coded a program to analyse data obtained and calibrate the wavelength. The spectrometer is composed of a webcam and a DVD used as a diffraction grating. Thanks to this instrument we have been able to obtain scientific quality data without having to pay thousands of euros. The study of the light that passes through the atmosphere allows us to obtain a lot of information about its composition.
465 PREMIO ESPECIAL REAL SOCIEDAD DE FÍSICA, OTORGADO POR LA REAL SOCIEDAD ESPAÑOLA DE FÍSICA
CERTAMEN JÓVENES INVESTIGADORES / Ciencias Físicas, Químicas y Matemáticas
1. INTRODUCCIÓN
La primera vez que aprendimos sobre los espectros de las sustancias fue en una clase sobre el modelo atómico de Bohr. Allí nos explicaron que este permitía entender el espectro discontinuo del átomo de hidrógeno. Desde entonces nos sentimos intrigados por el tema de la espectroscopía y lo que nos permite estudiar sobre las propiedades de la materia.
La creciente importancia del cuidado del medio ambiente nos hizo querer estudiar la atmósfera de Madrid y ver si la contaminación atmosférica u otros factores afectan al espectro solar recibido desde el nivel del suelo. Para ello, elaboramos un espectrofotómetro “casero” utilizando una red de difracción (un DVD) y una webcam normal a la que se le quitó el filtro de infrarrojos. Se utilizó este instrumento para medir el espectro solar bajo diferentes condiciones.
2. ANTECEDENTES Y BASE TEÓRICA
Antes de describir el experimento realizado, explicaremos la base teórica necesaria en la que se basa.
2.1 EL ESPECTRO SOLAR
Hay fundamentalmente dos tipos de dispersión de la luz: la de Rayleigh y la de Mie. La dispersión de Rayleigh se produce cuando la luz choca en su camino con partículas mucho menores a su longitud de onda. Estas son principalmente partículas de gases. La luz es absorbida por la partícula y emitida en todas direcciones. La intensidad de la luz dispersada es inversamente proporcional a la longitud de onda a la cuarta. Esto quiere decir que la luz de menor longitud de onda, como el azul y el violeta es dispersada con mayor intensidad.
Por otro lado, la dispersión de Mie está causada por partículas mucho más grandes que la longitud de onda, los aerosoles. Los aerosoles son coloides formados por partículas líquidas o sólidas suspendidas en un gas. Estas partículas tienen orígenes muy distintos: polvo del desierto, cenizas de incendios forestales, volcanes… La contaminación antropogénica también crea aerosoles, ya que el dióxido de azufre y los óxidos de nitrógeno producidos por combustión se convierten en sulfatos y nitratos (aerosoles) al estar en la atmósfera. Las nubes son gotas de agua suspendidas en la atmósfera, por lo tanto también son aerosoles.
La dispersión de Mie ocurre cuando la luz se choca contra una de estas partículas grandes. La mayor parte de la luz reflejada se dirige hacia delante (en el sentido del rayo) (Nave, 2010) y una parte es absorbida por la partícula. Según el tipo de partícula el espectro de absorción varía. La intensidad de la luz reflejada es prácticamente independiente de la longitud de onda (AstroMía, n.d.).
30º
466
Estudio espectrofotométrico de fuentes de luz artificiales y de la luz solar
Estos dos fenómenos explican la composición espectral de la luz que nos llega del Sol. Cuando nos llega la luz de forma indirecta, la dispersión de Rayleigh tiene lugar y predomina el color azul (el violeta no lo vemos tanto por los fotorreceptores de nuestra retina, es un tema biológico). Al mirar a una nube, vemos luz de color blanco ya que predomina la dispersión de Mie y todas las longitudes de onda la sufren por igual. Durante el atardecer el cielo se vuelve de color rojizo debido a los dos fenómenos. El recorrido que recorre la luz a través de la atmósfera es más largo que en el resto del día. La luz de color azul se dispersa más que la roja según Rayleigh y pierde más energía.


La dispersión de Mie acrecienta el color rojizo de la luz, debido a la acumulación de aerosoles que deja pasar en mayor medida la luz rojiza. Por eso el cielo del atardecer es rojizo o anaranjado.
Imagen 01
Dispersión de la luz que llega de manera directa e indirecta.
Elaboración propia.
2.2 Diseño y
Dispersión de la luz que llega de manera directa e indirecta. Elaboración propia.
funcionamiento de un espectrofotómetro con una webcam
2.2 DISEÑO Y FUNCIONAMIENTO DE UN ESPECTROFOTÓMETRO CON UNA WEBCAM
2.2 Diseño y funcionamiento de un espectrofotómetro con una webcam
El espectrómetro que utilizamos tiene dos componentes principales: la red de difracción (un DVD) y la webcam. La luz entra en una caja oscura (forrada por dentro con cartulina negra para evitar reflejos) por una estrecha rendija. El haz de luz que entra llega a la red de difracción. La red de difracción dispersa la luz en sus diferentes longitudes de onda creando un espectro. Cuando la luz del espectro llega a la webcam, esta toma una fotografía.
El espectrómetro que utilizamos tiene dos componentes principales: la red de difracción (un DVD) y la webcam. La luz entra en una caja oscura (forrada por dentro con cartulina negra para evitar reflejos) por una estrecha rendija. El haz de luz que entra llega a la red de difracción. La red de difracción dispersa la luz en sus diferentes longitudes de onda creando un espectro. Cuando la luz del espectro llega a la webcam, esta toma una fotografía.
El espectrómetro que utilizamos tiene dos componentes principales: la red de difracción (un DVD) y la webcam. La luz entra en una caja oscura (forrada por dentro con cartulina negra para evitar reflejos) por una estrecha rendija. El haz de luz que entra llega a la red de difracción. La red de difracción dispersa la luz en sus diferentes longitudes de onda creando un espectro. Cuando la luz del espectro llega a la webcam, esta toma una fotografía.
Una red de difracción está compuesta de muchas ranuras muy juntas. La luz sale de la red de difracción en un determinado ángulo dependiendo del ángulo de incidencia y de la longitud de onda según la ecuación
Una red de difracción está compuesta de muchas ranuras muy juntas. La luz sale de la red de difracción en un determinado ángulo dependiendo del ángulo de incidencia y de la longitud de onda según la ecuación
Una red
de difracción está compuesta de muchas ranuras muy juntas.
La luz sale de la red de difracción en un determinado ángulo dependiendo del ángulo de incidencia y de la longitud de onda según la ecuación
donde d es la distancia entre las rayas, α es el ángulo de incidencia respecto a la normal del plano de la red, β es el ángulo con el que sale la luz difractada,
λ es la longitud de onda del rayo y n es el orden de difracción. n puede tomar cualquier valor entero positivo o negativo.
donde d es la distancia entre las rayas, �������� es el ángulo de incidencia respecto a la normal del plano de la red, �������� es el ángulo con el que sale la luz difractada, �������� es la longitud de onda del rayo y n es el orden de difracción. n puede tomar cualquier valor entero positivo o negativo.
donde d es la distancia entre las rayas, �������� es el ángulo de incidencia respecto a
El DVD tiene unos surcos circulares conceptualmente similares a los de un disco de vinilo. Estas líneas circulares actúan como una red de difracción. El espectro producido es ligeramente curvo pero este efecto es despreciable.
467
Dispersión de la luz que llega de manera directa e indirecta. Elaboración propia.
30º CERTAMEN JÓVENES INVESTIGADORES / Ciencias Físicas, Químicas y Matemáticas
El DVD tiene unos surcos circulares conceptualmente similares a los de un disco de vinilo. Estas líneas circulares actúan como una red de difracción. El espectro producido es ligeramente curvo pero este efecto es despreciable. Usar un DVD de 4,7 GB es preferible a un CD ya que tiene más líneas por mm (1351 frente a 625 líneas por mm). Una separación menor entre las líneas, según la ecuación de las redes de difracción, hace que el espectro se disperse más y tengamos una mayor resolución espectral, ya que las líneas estarán más separadas.
Los datos del espectro se recogen en una fotografía. La imagen se utiliza para obtener dos datos: la posición de la luz (longitud de onda) y su intensidad. Primero hay que realizar una calibración que se explica más adelante.
Cada píxel contiene tres números entre el 0 y el 255 según el sistema RGB (Red Green Blue). Corresponden a la intensidad del color rojo, verde y azul de cada pixel. La intensidad que debemos tomar es el máximo de esos tres.
3. OBJETIVOS
• Los objetivos de este trabajo de investigación son:
• Construir un espectrofotómetro funcional
• Calibrarlo y analizar espectros de diferentes fuentes de luz
• Creación de un software de análisis de los datos propio
• Comprobar el efecto de la dispersión de Rayleigh y de Mie
• Estudiar la evolución de la contaminación en Madrid
Nuestra hipótesis es que la contaminación y otros aerosoles en el aire influyen en el espectro solar volviéndolo más rojizo. Para tratar de demostrarla haremos un análisis espectrofotométrico.
4. MATERIALES Y METODOLOGÍA
4.1 MATERIALES
Los materiales utilizados además de aquellos necesarios para la infraestructura son:
• Para la construcción del espectrofotómetro:
Una webcam Trust Exis 640p
Un DVD de 4,7 GB
Etanol
468
Estudio espectrofotométrico de fuentes de luz artificiales y de la luz solar
• Para el análisis de los datos y la calibración del instrumento: Anaconda (distribución de Python para uso científico)
Programa informático de elaboración propia (escrito en Python)
Lámpara fluorescente como fuente de luz conocida
Espectrofotómetro profesional Ocean Optics Red Tide (ofrecido por la Universidad Complutense de Madrid)
• Fuentes de luz estudiadas:
Láseres: verde (532 nm), violeta, rojo de Helio-Neón.
LED blanco y rojo.
Lámpara de sodio.
4.2 METODOLOGÍA
Este experimento tiene cuatro fases: construir el espectrofotómetro, calibrarlo, estudiar las fuentes de luz artificiales y estudiar el espectro de la luz solar.
4.2.1 CONSTRUCCIÓN DEL ESPECTROFOTÓMETRO
Lo primero que hicimos fue hacer una caja de madera pegando varias tablas de contrachapado de madera previamente cortadas. Como ya hemos indicado antes, revestimos el interior de las tablas con cartulina negra para evitar reflejos dentro de la caja oscura. En la parte frontal de la caja hay una rendija formada por dos cuchillas para espátula ligeramente separadas entre sí para permitir que entre la luz.
preparación del DVD es sencilla. Con ayuda de un cúter separamos las dos capas del DVD. Nos quedamos con la parte que no tiene espejo y desechamos
Las cuchillas de espátula son una gran opción para esta rendija. La separación entre las dos debía ser muy pequeña para aumentar la precisión del instrumento. Al ser más fina la rendija aumenta la precisión, pero disminuye la cantidad de luz que entra. Para evitar que entre la luz exterior y produzca alteraciones en las medidas se pone cinta americana en las partes en las que la madera no tapa bien.
Para poder utilizar la webcam y el DVD debemos prepararlos primero. A la webcam le quitamos la carcasa de plástico decorativa para que no ocupe tanto espacio dentro de la caja oscura. Desenroscamos la lente (es una lente manual) para poder quitarle el filtro de infrarrojos. Es un pequeño vidrio de color verdoso que se encuentra en la parte trasera. Al hacer esto, podremos hacer mediciones en el infrarrojo cercano. Después volvemos a enroscar la lente.
otra. El trozo con el que nos hemos quedado tiene un tinte orgánico fotosensible morado que debemos quitar para que no afecta a las medidas tomadas. Se desprende fácilmente al lavarlo con etanol y dejarlo escurrir. El etanol es un disolvente orgánico que disuelve con facilidad el tinte orgánico morado. Para esto también sirve la acetona. Luego cortamos un trozo de la exterior del disco, donde los surcos son menos curvos, para usarlo como

469
CERTAMEN JÓVENES INVESTIGADORES / Ciencias Físicas, Químicas y Matemáticas
La preparación del DVD es sencilla. Con ayuda de un cúter separamos las dos capas del DVD. Nos quedamos con la parte que no tiene espejo y desechamos la otra. El trozo con el que nos hemos quedado tiene un tinte orgánico fotosensible morado que debemos quitar para que no afecta a las medidas tomadas. Se desprende fácilmente al lavarlo con etanol y dejarlo escurrir. El etanol es un disolvente orgánico que disuelve con facilidad el tinte orgánico morado. Para esto también sirve la acetona. Luego cortamos un trozo de la parte exterior del disco, donde los surcos son menos curvos, para usarlo como red de difracción.
la otra. El trozo con el que nos hemos quedado fotosensible morado que debemos quitar para que no tomadas. Se desprende fácilmente al lavarlo con etanol etanol es un disolvente orgánico que disuelve con fac morado. Para esto también sirve la acetona. Luego parte exterior del disco, donde los surcos son menos curvos, red de difracción.
4.2.2 CALIBRACIÓN DE LA LONGITUD DE ONDA Y MÉTODO DE ANÁLISIS DE DATOS

4.2.2 Calibración de método de análisis de datos
La fuente de luz que utilizamos instrumento es una lámpara tipo de lámparas presenta característicos de longitud
En concreto, usaremos nm y el de 611,6 nm. Conociendo dos píxeles y sus longitudes de onda correspondientes modelo de regresión lineal que relaciona la columna cada píxel con la longitud de onda que le corresponde.
La fuente de luz que utilizamos para calibrar el instrumento es una lámpara fluorescente. Este tipo de lámparas presenta varios picos característicos de longitud de onda conocida. En concreto, usaremos dos de ellos, el de 546,5 nm y el de 611,6 nm. Conociendo la posición de dos píxeles y sus longitudes de onda correspondientes podemos hacer un modelo de regresión lineal que relaciona la columna en la que se encuentra cada píxel con la longitud de onda que le corresponde.

Utilizamos como medida de la intensidad relativa el según el sistema RGB dividido entre 255 (el máximo píxel) y expresamos la intensidad en porcentaje.
Utilizamos como medida de la intensidad relativa el valor máximo del píxel según el sistema RGB dividido entre 255 (el máximo valor posible para un píxel) y expresamos la intensidad en porcentaje.
El programa informático lo escribimos en Python por su flexibilidad. Utilizamos la librería OpenCV para analizar las imágenes píxel a píxel, NumPy para trabajar con grandes cantidades de números y Matplotlib para mostrar los resultados de manera visual. El modelo de regresión lineal (recta de calibración) también lo implementamos en Python.
30º
470
Estudio espectrofotométrico de fuentes de luz artificiales y de la luz solar
También se apuntó el inclinaciones con respecto al horizonte, para dispersión de Mie y de Rayleigh. Además, al hacer días, se observó el efecto de la meteorología lámpara fluorescente fue muy satisfactoria. Se instrumento tiene una precisión muy buena. Gracias a
Madrid,
Como parte de nuestro estudio, tomamos datos de fuentes de luz como bombillas fluorescentes, un láser verde, un láser violeta, un láser rojo de Helio-Neón, una lámpara de sodio, la linterna de un móvil (LED blanco) y un LED rojo.
4.2.3 ESTUDIO DEL ESPECTRO DE LA LUZ SOLAR
Se tomaron medidas variando las condiciones. También se apuntó el instrumento en distintas inclinaciones con respecto al horizonte, para comprobar el efecto de la dispersión de Mie y de Rayleigh. Además, al hacer mediciones a lo largo de varios días, se observó el efecto de la meteorología (cielo nublado o despejado).
5. RESULTADOS
La calibración utilizando una lámpara fluorescente fue muy satisfactoria. Se pudo comprobar que el instrumento tiene una precisión muy buena. Gracias a la Universidad Complutense de Madrid, pudimos utilizar un espectrofotómetro con el que mejorar la calibración. Lo utilizamos para analizar ciertas fuentes de luz para la calibración y para comparar los resultados obtenidos con los nuestros.





luz para la resultados obtenidos con
obtenida del LED blanco es un espectro continuo. Esto tiene sentido luz que emite está formada por todos los colores. Pudimos observar interesante fenómeno al analizar el espectro del láser verde y del violeta. En
La imagen obtenida del LED blanco es un espectro continuo. Esto tiene sentido ya que la luz que emite está formada por todos los colores. Pudimos observar un interesante fenómeno al analizar el espectro del láser verde y del violeta. En
La imagen obtenida del LED blanco es un espectro continuo. Esto tiene sentido ya que la luz que emite está formada por todos los colores. Pudimos observar un interesante fenómeno al analizar el espectro del láser verde y del violeta.
presentar un único pico como cabía esperar, se veían pico de un poco menor correspondiente a una longitud de onda más alta, en
lugar de presentar un único pico como cabía esperar, se veían pico de intensidad un poco menor correspondiente a una longitud de onda más alta, en
471
solar las condiciones.
F Fluorescente FFluorescente
pudimos utilizar mejorar la calibración. fuentes de
LED blanco Láser verde (Red Tide)
30º CERTAMEN JÓVENES INVESTIGADORES / Ciencias Físicas, Químicas y Matemáticas
En lugar de presentar un único pico como cabía esperar, se veían pico de intensidad un poco menor correspondiente a una longitud de onda más alta, en el rango infrarrojo. En el caso del láser verde, por ejemplo, además de la línea de 532-533 nm, había una línea en los 808 nm. La línea secundaria del láser violeta está justo en el límite de nuestro rango de medición (es el orden 2 de la red de difracción). La observación que realizamos del láser verde se debe al mecanismo de funcionamiento del láser, que primero genera una radiación infrarroja y luego transforma su frecuencia. Los láseres pueden ser usados para calibrar el espectrofotómetro, mientras que los LEDs no sirven ya que no tienen una longitud de onda concreta.


Cuando tomamos los datos de la luz solar, pudimos observar que es mucho más variable de lo que imaginábamos previamente.

472
Láser He-Ne rojo
Láser violeta
Neón (lámpara de sodio fría)
Estudio espectrofotométrico de fuentes de luz artificiales y de la luz solar

6. CONCLUSIONES
Hemos sido capaces de construir un espectrofotómetro funcional, calibrarlo con una lámpara fluorescente y utilizarlo para medir el espectro de emisión de varias fuentes de luz del laboratorio. El programa que creamos en Python funcionó como se esperaba y se obtuvieron resultados satisfactorios. Cabe resaltar que al estudiar los láseres hallamos una línea de emisión secundaria en el rango infrarrojo, debida a un fallo de fabricación. Esto no se puede ver a simple vista ya que esa línea secundaria está fuera del espectro visible por el ojo humano.
En el estudio de la luz solar nos dimos cuenta de que son muchos los factores que afectan a la luz que recibimos. Algunos de los que identificamos fueron el momento del día (amanecer, mediodía, atardecer…), la presencia de nubes y apuntar directamente al Sol o a otro lugar del cielo. Al apuntar a las nubes en lugar de al cielo azul pudimos comprobar el efecto de la dispersión de Rayleigh (en el cielo) y de Mie (en las nubes).

473
Día nublado (analizado con Theremino)
Día nublado (analizado con Theremino)
30º CERTAMEN JÓVENES INVESTIGADORES / Ciencias Físicas, Químicas y Matemáticas
BIBLIOGRAFÍA Y WEBGRAFÍA
AstroMía (n.d.) “Efecto Rayleigh y efecto Mie”. Disponible en: https://www.astromia.com/astronomia/rayleighmie.htm (Consultado el 15/04/2019)
Ford, A. y Roberts, A. (1998) “Colour space conversions”, Westminster, Universidad de Westminster. Disponible en: http://www.photo-lovers.org/pdf/coloureq.pdf (Consultado el 16/04/2019)
Nave, R. (2010) “Rayleigh and Mie dispersion”, Hyperphysics. Disponible en: http://hyperphysics.phy-astr.gsu.edu/hbasees/atmos/blusky.html#c4 (Consultado el 15/04/2019)
Nave, R. (2010) “Diffraction gratings”, Hyperphysics. Disponible en: http://hyperphysics.phy-astr.gsu.edu/hbasees/phyopt/grating.html (Consultado el 15/04/2019)
474
475
CIENCIAS FÍSICAS, QUÍMICAS Y MATEMÁTICAS
/
TERCER PREMIO
AUTORA | ESTHER REVENGA VILLAGRA
COORDINADOR | ENRIQUE CAO RODRÍGUEZ
CENTRO | IES ROSALÍA DE CASTRO
CIUDAD | SANTIAGO DE COMPOSTELA-A CORUÑA
RESUMEN |
En este trabajo se ha comprobado como varía la velocidad de salida de un Cañón de Gauss dependiendo de la geometría de los imanes utilizados (rectangulares o cilíndricos) y como afecta la separación entre ellos a lo largo del raíl. Para ello, se dispusieron en primer lugar los imanes rectangulares sobre el raíl, y se midió el alcance horizontal de la última bola para distintas separaciones. Posteriormente, se hizo lo mismo con los imanes cilíndricos.
Se pudo comprobar casi de forma inmediata que los cilíndricos proporcionaban una mayor velocidad de salida, sin embargo, no había una relación lógica entre las velocidades que se obtenían al ir aumentando la distancia entre ellos. Por ello, se buscó la fuente del error, que resultó ser que, a pequeñas distancias entre imanes, sus campos magnéticos interactúan entre sí cuando no estaban orientados de la misma forma, alterando la geometría del mismo. Una vez identificado el error, se realizaron nuevas medidas, llegando a la conclusión de que existe una distancia óptima entre imanes, para la cual la velocidad de salida es máxima. También se ha teorizado sobre el hecho de que, a partir de esa distancia ideal, la velocidad de salida descienda de un modo exponencial hasta el punto en el que los imanes no proporcionan suficiente energía cinética a las bolas como para romper la barrera de potencial.
¿En qué medida la geometría de los imanes y la separación entre ellos afecta a la velocidad de salida de un acelerador magnético (cañón de Gauss)?
476
ABSTRACT |
In this study it has been checked how the final speed in a Gaussian Cannon varies according to the geometry of the magnets used (rectangular or cylindrical) and the separation between them along the rail. To do so, firstly, the rectangular magnets were placed on the rail and the horizontal displacement of the last metallic ball was measured for several different separations. Then, the same procedure was carried out with the cylindrical magnets.
Almost instantly it could be seen that these last magnets produced a larger final speed, however, there was no logical relation between the speeds that were obtained as the separation between them was increased. Therefore, the error was searched and ended up being observed that it was related with the orientation of the magnets when they were at very short distances between each other. In this situation, the magnetic field of the magnets interact with each other and alter the geometry of it. Once the error was identified, new measures were taken, reaching the conclusion that there is an optimal separation between magnets, at which the final speed is greatest. It has also been guessed that beyond that ideal separation, the final speed decreases exponentially up to the point in which the magnets cannot transmit to the balls enough kinetic energy so as to break the potential barrier.
CIENCIAS
477
FÍSICAS, QUÍMICAS Y MATEMÁTICAS
¿En qué medida la geometría de los imanes y la separación entre ellos afecta a la velocidad de salida de un acelerador magnético (cañón de Gauss)?






instantánea del objeto. La unidad de momento lineal en el Sistema Internacional es el kg·m·s-1. Cabe mencionar que, si una fuerza neta se aplica sobre un sistema, dicho sistema se verá acelerado, lo que provocará una variación en la velocidad del cuerpo y consecuentemente también cambiará su momento
variación en la velocidad del cuerpo y consecuentemente también cambiará su momento lineal, de acuerdo con la siguiente fórmula: .
variación en la velocidad del cuerpo y consecuentemente también cambiará su momento lineal, de acuerdo con la siguiente fórmula:
2.1.1. Colisiones
variación en la velocidad del cuerpo y consecuentemente también cambiará su momento lineal, de acuerdo con la siguiente fórmula:
lineal, de acuerdo con la siguiente fórmula:
2.1.1. Colisiones
2.1.1. COLISIONES
Se considera una colisión cualquier interacción que conlleva una transferencia de momento lineal. Como dicta el Principio de Conservación del Momento Lineal, mientras no haya una fuerza externa al sistema que haga trabajo, el momento lineal permanece constante. Muchas colisiones cumplen con este Principio, y se pueden clasificar dependiendo de su conservación de la energía cinética en colisiones elásticas y colisiones inelásticas (estas últimas no serán tratadas en este trabajo pues no son de relevancia para el mismo).
2.1.1. Colisiones
Se considera una colisión cualquier interacción que conlleva una transferencia de momento lineal. Como dicta el Principio de Conservación del Momento Lineal, mientras no haya una fuerza externa al sistema que haga trabajo, el momento lineal permanece constante. Muchas colisiones cumplen con este Principio, y se pueden clasificar dependiendo de su conservación de la energía cinética en colisiones elásticas y colisiones inelásticas (estas últimas no serán tratadas en este trabajo pues no son de relevancia para el mismo).
Se considera una colisión cualquier interacción que conlleva una transferencia de momento lineal. Como dicta el Principio de Conservación del Momento Lineal, mientras no haya una fuerza externa al sistema que haga trabajo, el momento lineal permanece constante. Muchas colisiones cumplen con este Principio, y se pueden clasificar dependiendo de su conservación de la energía cinética en colisiones elásticas y colisiones inelásticas (estas últimas no serán tratadas en este trabajo pues no son de relevancia para el mismo).
Se considera una colisión cualquier interacción que conlleva una transferencia de momento lineal. Como dicta el Principio de Conservación del Momento Lineal, mientras no haya una fuerza externa al sistema que haga trabajo, el momento lineal permanece constante. Muchas colisiones cumplen con este Principio, y se pueden clasificar dependiendo de su conservación de la energía cinética en colisiones elásticas y colisiones inelásticas (estas últimas no serán tratadas en este trabajo pues no son de relevancia para el mismo).
2.1.1.1. Colisiones Elásticas
2.1.1.1. Colisiones Elásticas
2.1.1.1. Colisiones Elásticas
Para que una colisión elástica tenga lugar, no debe haber una deformación permanente en los objetos que colisionan, no debe haber variaciones de energía y el momento lineal debe conservarse. Esto puede resumirse en forma de las siguientes ecuaciones:
2.1.1.1. Colisiones Elásticas
Para que una colisión elástica tenga lugar, no debe haber una deformación permanente en los objetos que colisionan, no debe haber variaciones de energía y el momento lineal debe conservarse. Esto puede resumirse en forma de las siguientes ecuaciones:
Para que una colisión elástica tenga lugar, no debe haber una deformación permanente en los objetos que colisionan, no debe haber variaciones de energía y el momento lineal debe conservarse. Esto puede resumirse en forma de las siguientes ecuaciones:
Para que una colisión elástica tenga lugar, no debe haber una deformación permanente en los objetos que colisionan, no debe haber variaciones de energía y el momento lineal debe conservarse. Esto puede resumirse en forma de las siguientes ecuaciones:
Estas ecuaciones serán las que explican parte de lo que sucederá en este experimento. Otra parte será explicada por el Principio de Conservación de la Energía. La energía cinética debe conservarse tras la colisión de modo que:
Estas ecuaciones serán las que explican parte de lo que sucederá en este experimento. Otra parte será explicada por el Principio de Conservación de la Energía. La energía cinética debe conservarse tras la colisión de modo que:
Estas ecuaciones serán las que explican parte de lo que sucederá en este experimento. Otra parte será explicada por el Principio de Conservación de la Energía. La energía cinética debe conservarse tras la colisión de modo que:
Estas ecuaciones serán las que explican parte de lo que sucederá en este experimento. Otra parte será explicada por el Principio de Conservación de la Energía. La energía cinética debe conservarse tras la colisión de modo que:
2.2. Magnetismo
2.2. Magnetismo
2.2. Magnetismo
En lo que respecta al magnetismo, para este trabajo los únicos puntos teóricos que hay que tener en cuenta son: funcionamiento de imanes, líneas de campo e intensidad del campo magnético.
En lo que respecta al magnetismo, para este trabajo los únicos puntos teóricos que hay que tener en cuenta son: funcionamiento de imanes, líneas de campo e intensidad del campo magnético.
2.2. MAGNETISMO
2.2.1. Imanes
En lo que respecta al magnetismo, para este trabajo los únicos puntos teóricos que hay que tener en cuenta son: funcionamiento de imanes, líneas de campo e intensidad del campo magnético.
2.2.1. Imanes
En lo que respecta al magnetismo, para este trabajo los únicos puntos teóricos que hay que tener en cuenta son: funcionamiento de imanes, líneas de campo e intensidad del campo magnético.
2.2.1. Imanes
Los imanes permanentes son materiales que generan campos magnéticos. Esta característica se debe principalmente a motivos cuánticos relacionados con el ordenamiento de los electrones de los átomos que forman dicho material.
Los imanes permanentes son materiales que generan campos magnéticos. Esta característica se debe principalmente a motivos cuánticos relacionados con el ordenamiento de los electrones de los átomos que forman dicho material.
Todos los átomos tienen un momento dipolar magnético generado por los espines de las partículas cargadas. Esto significa que los electrones de los átomos generan un momento dipolar magnético neto, que, en la mayoría de los compuestos, se cancela con el de los
Los imanes permanentes son materiales que generan campos magnéticos. Esta característica se debe principalmente a motivos cuánticos relacionados con el ordenamiento de los electrones de los átomos que forman dicho material.
2.2.1 IMANES



Los imanes permanentes son materiales que generan campos magnéticos. Esta característica se debe principalmente a motivos cuánticos relacionados con el ordenamiento de los electrones de los átomos que forman dicho material.
Todos los átomos tienen un momento dipolar magnético generado por los espines de las partículas cargadas. Esto significa que los electrones de los átomos generan un momento dipolar magnético neto, que, en la mayoría de los compuestos, se cancela con el de los
Todos los átomos tienen un momento dipolar magnético generado por los espines de las partículas cargadas. Esto significa que los electrones de los átomos generan un momento dipolar magnético neto, que, en la mayoría de los compuestos, se cancela con el de los
479
CERTAMEN JÓVENES INVESTIGADORES / Ciencias Físicas, Químicas y Matemáticas
Todos los átomos tienen un momento dipolar magnético generado por los espines de las partículas cargadas. Esto significa que los electrones de los átomos generan un momento dipolar magnético neto, que, en la mayoría de los compuestos, se cancela con el de los átomos vecinos. Sin embargo, en algunos materiales, se alinea con el momento dipolar magnético del resto de átomos, reforzándolos y creando de este modo un dominio magnético.
Representación de los dominios magnéticos y de los momentos dipolares magnéticos.

Fuente: elaboración propia.
Los dominios magnéticos son zonas del material en las que el momento dipolar magnético de sus átomos está alineado (Figura 1). En metales ferromagnéticos, los distintos dominios se encuentran enfrentados de manera aleatoria, lo que hace que, desde un punto de vista macroscópico, se cancelen. Por ello, metales como el hierro no generan campos magnéticos, sino que reaccionan a ellos porque al ser expuestos a ellos, sus dominios se alinean, reforzándose y convirtiéndose en un imán temporal, dado que cuando el campo externo se suprime, sus dominios vuelven a desalinearse.

Para que exista un imán permanente, sus dominios magnéticos deben encontrarse alineados permanentemente (Figura 2). Este caso se da al enlazarse fuertemente las paredes de los dominios con las del dominio contiguo, de modo que no cambian de posición en ningún momento, haciendo que se refuerce de manera constante el campo magnético.
Representación de los dominios magnéticos y de los momentos dipolares magnéticos en u imán permanente.
Fuente: elaboración propia.
30º
480
Figura 01
Figura 02
¿En qué medida la geometría de los imanes y la separación entre ellos afecta a la velocidad de salida de un acelerador magnético (cañón de Gauss)?
2.2.3 LÍNEAS DE CAMPO MAGNÉTICO
Las líneas de campo magnético se definen de la siguiente forma: si se colocara una brújula ideal (que pudiera apuntar en cualquier dirección del espacio), esta apuntaría a lo largo de unas líneas imaginarias que se denominan líneas de campo magnético. Cuanto más juntas se encuentren las líneas, mayor es la intensidad del campo. Todos los imanes forman un dipolo magnético. Esto quiere decir que existe un punto del que salen las líneas de campo y otro en el que entran. Cada punto del dipolo en el que convergen las líneas de campo magnético se llama polo. La fuerza magnética o la intensidad del campo magnético es más fuerte cuanto menor es la distancia a un polo.
3. MONTAJE EXPERIMENTAL
El proceso de selección de materiales para este trabajo fue de extrema importancia, al igual que la determinación del montaje más conveniente de los mismos, para medir del modo más preciso posible la velocidad de la última bola metálica.
3.2 MATERIALES
MATERIAL DESCRIPCIÓN
Raíl de madera Formado por dos barras de madera unidas con gomas elásticas.
Gomas elásticas Gomas anchas y fuertes.
Bolas de metal 4 bolas de metal del tamaño de una canica. Deben pesar todas lo mismo.
Canicas 3 canicas de cristal o plástico.
Imanes 12 imanes cilíndricos de neodimio (agrupar de 4 en 4)12 imanes rectangulares de neodimio (agrupar de 4 en 4)
Plomada Formada por una varilla de madera y un peso atada a una cuerda. En este caso, el peso fue una bola de plastilina
Nivel
Balanza Se usó una balanza con una precisión de 0.01 g
Tiza de colores Recomendable usar tiza roja, pero azul también vale.
Cinta métrica Es necesario poder medir con una precisión de 0.001 m. No vale una regla, pues hay que medir distancias del orden de 0.5 – 1 m
Cartón Recomendable su uso para evitar que las bolas metálicas y las canicas rueden por el suelo y reboten.
481
canicas de cristal o plástico.
12 imanes cilíndricos de neodimio (agrupar de 4 en 4)
Cartón Recomendable su uso para evitar que las bolas metálicas y las canicas rueden por el suelo y reboten.
12 imanes rectangulares de neodimio (agrupar de 4 en 4)
Formada por una varilla de madera y un peso atada a una cuerda. En este caso, el peso fue una bola de plastilina.
30º CERTAMEN JÓVENES INVESTIGADORES / Ciencias Físicas, Químicas y Matemáticas
3.1.1. Selección de materiales
Se usó una balanza con una precisión de 0.01 g Recomendable usar tiza roja, pero azul también vale.
3.1.1. SELECCIÓN DE MATERIALES
Es necesario poder medir con una precisión de 0.001 m. No vale una regla, pues hay que medir distancias del orden de 0.5 – 1 m
Se propuso el montaje del raíl con dos barras de madera idénticas que se unieron una al lado de la otra con gomas elásticas. Esta superficie proporcionaba un rozamiento mínimo y ambos tipos de imanes se podían colocar de manera sencilla sobre el raíl.
Recomendable su uso para evitar que las bolas metálicas y las canicas rueden por el suelo y reboten.
lección de materiales
Por otro lado, se disponía de dos tamaños de bolas metálicas y de canicas. En un inicio se planteó la idea de analizar que ocurría cuando se variaba la masa de las esferas. Sin embargo, tras un par de intentos, se pudo comprobar que las bolas de mayor tamaño no llegaban con suficiente impulso al segundo paquete de imanes, por lo que la siguiente bola no salía despedida hacia delante.
Se propuso el montaje del raíl con dos barras de madera idénticas que se unieron una al lado de la otra con gomas elásticas. Esta superficie proporcionaba un rozamiento mínimo y ambos tipos de imanes se podían colocar de manera sencilla sobre el raíl.

Por otro lado, se disponía de dos tamaños de bolas metálicas y de canicas. En un inicio se planteó la idea de analizar que ocurría cuando se variaba la masa de las esferas. Sin embargo, tras un par de intentos, se pudo comprobar que las bolas de mayor tamaño no llegaban con suficiente impulso al segundo paquete de imanes, por lo que la siguiente bola no salía despedida hacia delante.
montaje del raíl con dos barras de madera idénticas que se lado de la otra con gomas elásticas. Esta superficie rozamiento mínimo y ambos tipos de imanes se podían sencilla sobre el raíl.
3.2. Disposición de los materiales
3.2. DISPOSICIÓN DE LOS MATERIALES
3.2.1. Descripción del acelerador magnético
disponía de dos tamaños de bolas metálicas y de canicas. En la idea de analizar que ocurría cuando se variaba la masa embargo, tras un par de intentos, se pudo comprobar que mayor tamaño no llegaban con suficiente impulso al segundo imanes, por lo que la siguiente bola no salía despedida hacia
3.2.1 DESCRIPCIÓN DEL ACELERADOR MAGNÉTICO
Un acelerador magnético consiste en lo que se conoce como una reacción en cadena. Un primer evento desencadena otro, y este desencadena otro diferente, y así sucesivamente (ver Figura 3 para seguir la explicación).
Un acelerador magnético consiste en lo que se conoce como una reacción en cadena. Un primer evento desencadena otro, y este desencadena otro diferente, y así sucesivamente (ver Figura 3 para seguir la explicación).

Figura 03
de los materiales
Esquema lateral del acelerador magnético. Fuente: elaboración propia.
Figura 04
El primer evento es el hecho de soltar una bola metálica cerca de un imán, que tiene al otro lado una canica y otra bola metálica. El imán atrae a la bola inicial, transformando energía potencial magnética en energía cinética. La bola colisiona
Montaje del acelerador magnético. Fuente: elaboración propia.
Descripción del acelerador magnético magnético consiste en lo como una reacción en primer evento desencadena otro, y este desencadena otro sucesivamente (ver Figura 3 para seguir la explicación).
es el hecho de soltar una bola un imán, que tiene al otro lado bola metálica. El imán atrae a la transformando energía potencial energía cinética. La bola colisiona
El primer evento es el hecho de soltar una bola metálica cerca de un imán, que tiene al otro lado una canica y otra bola metálica. El imán atrae a la bola inicial, transformando energía potencial magnética en energía cinética. La bola colisiona entonces con el imán, transmitiéndole toda su energía cinética a la bola metálica del otro lado. Si la energía es suficiente como para romper la barrera de potencial (energía necesaria para librarse de la atracción del imán en ese punto), la bola metálica se libera de la atracción del primer imán y se ve atraída por el siguiente imán en el raíl, desencadenando la siguiente reacción (que es la misma que la que se acaba de describir).
Se realizó el montaje de un acelerador magnético tal y como se indica en el proyecto OSCAR de la Universidad Complutense de Madrid (Figura 4):
482
0
Figura 3: Esquema lateral del acelerador magnético (fuente propia)
Figura 4: Montaje del acelerador magnético (fuente propia)
0 Cinta métrica Es necesario poder medir con una precisión de 0.001 m. No vale una regla, pues hay que medir distancias del orden de 0.5 – 1 m
Figura 3: Esquema lateral del acelerador magnético (fuente propia)
Figura 4: Montaje del acelerador magnético (fuente propia)
¿En qué medida la geometría de los imanes y la separación entre ellos afecta a la velocidad de salida de un acelerador magnético (cañón de Gauss)?
imanes se separaron homogéneamente.
coloca una bola de metal, separada del mismo por una canica en medio de la bola y del imán es atraída con tanta fuerza que la energía cinética sea capaz de romper la barrera de potencial del el imán número 3 debe colocarse de modo que esté justo al final del raíl, de manera que lo salga despedida. Por lo tanto, el último imán debe centímetros del final, y mantenerse fijo durante el experimento.
• Un raíl sobre el que se anclan imanes de gran potencia. Para este trabajo, los imanes se separaron homogéneamente.
• Detrás de cada imán se coloca una bola de metal, separada del mismo por una canica de cristal.
El objetivo de colocar una canica en medio de la bola y del imán es evitar que la bola sea atraída con tanta fuerza que la energía cinética que se le transmita no sea capaz de romper la barrera de potencial del imán.
Atendiendo a la Figura 6, el imán número 3 debe colocarse de modo que la última bola de metal esté justo al final del raíl, de manera que lo abandone en cuanto salga despedida. Por lo tanto, el último imán debe colocarse a unos centímetros del final, y mantenerse fijo durante el transcurso del experimento.
• La bola de metal que se encuentra en la posición 0 (ver Figura 3) no debe recibir ningún tipo de impulso por parte del experimentador, pues de ser así, se le otorgaría una velocidad inicial incapaz de controlar. En su lugar, debe situarse en el punto en el que el imán la comienza a atraer y dejar que parta desde una velocidad inicial nula.

3.2.2. ¿CÓMO MEDIR LA VELOCIDAD DE SALIDA?
La disposición de los materiales está íntimamente ligada con cómo se midió la velocidad de salida de la última bola. Tras un análisis de distintos sistemas de medida se propuso el siguiente, dada su habilidad para medir únicamente el desplazamiento de la bola metálica (otros sistemas habían demostrado ser menos fiables, dadas las interferencias que produce la última canica, que también suele salir despedida del cañón).
encuentra en la posición 0 (ver Figura 3) no debe impulso por parte del experimentador, pues de ser velocidad inicial incapaz de controlar. En su lugar, en el que el imán la comienza a atraer y dejar velocidad inicial nula.
por la colocación del raíl en el borde de una mesa, de manera que la cayera hacia el suelo al salir del raíl. El objetivo fue entonces medir el desplazamiento horizontal de la bola de metal y, dada la altura de la mesa y el la gravedad terrestre, podría obtenerse la de salida de la bola.
Se optó por la colocación del raíl en el borde de una mesa, de manera que la bola cayera hacia el suelo al salir del raíl. El objetivo fue entonces medir el desplazamiento horizontal de la bola de metal y, dada la altura de la mesa y el valor de la gravedad terrestre, podría obtenerse la velocidad de salida de la bola.
velocidad de materiales está cómo se midió la última bola. Tras un de medida se habilidad para desplazamiento de la bola habían demostrado ser menos fiables, dadas las última canica, que también suele salir despedida
llevar esto a cabo, se colocó un papel blanco en sobre el que se tomaron las medidas de la recorrida (Figura 5). Con el objetivo de determinar dónde caía la bola metálica, se cubrió la con tiza líquida (Figura 6). De este modo, al sería la única marca sobre el papel.
Figura 5: Montaje del sistema de toma de medidas (fuente propia)

483
anclan
imanes de gran potencia.
DE DATOS 6
Figura 05
Montaje del sistema de toma de medidas. Fuente: elaboración propia.
Figura 06
Imagen de la tiza triturada y mezclada con agua.
Fuente: elaboración propia.
30º CERTAMEN JÓVENES INVESTIGADORES / Ciencias Físicas, Químicas y Matemáticas
Para llevar esto a cabo, se colocó un papel blanco en el suelo sobre el que se tomaron las medidas de la distancia recorrida (Figura 5). Con el objetivo de determinar dónde caía la bola metálica, se cubrió la misma con tiza líquida (Figura 6). De este modo, al caer, sería la única marca sobre el papel.
4. TOMA DE DATOS
Inicialmente se comprobó con un nivel que la mesa donde se iba a realizar el experimento fuera horizontal y se midió su altura (0.955 m +/- 0.001 m). Tras determinar que se usarían las bolas de metal pequeñas, se pesaron con una balanza para comprobar que tuvieran la misma masa (8.44 g +/- 0.01 g). Posteriormente, se colocó una plomada en el borde de la mesa para marcar el punto de desplazamiento nulo en el suelo.
A continuación, se anclaron los imanes rectangulares al raíl con gomas elásticas. Dado que no se disponía de un imán grande y potente, se juntaron 4 imanes de neodimio suficientemente potentes en distintos “paquetes” (se asumirá que cada paquete equivale a un único imán). Se midieron 7 disparos en 9 separaciones de imanes (de 5 cm a 14 cm, avanzando 1 cm por cada tanda de medidas). Se procedió a la repetición del proceso con los imanes cilíndricos, pero dado que estos imanes eran más potentes, hubo que comenzar desde los 7 cm.
Una vez obtenidos los datos, se procedió al tratamiento de estos.
5. TRATAMIENTO DE DATOS
484
SEPARACIÓN (cm) ALCANCE DE LA BOLA (CM) MEDIA (cm) EST. (cm) ABS. (cm) REL. (%) 5,0 36,1 39,8 40,5 40,7 45,4 36,7 37,8 39,57 3,15 3,15 7,96 6,0 40,6 34,3 38,2 37,8 37,5 36,2 36,9 37,36 1,93 1,93 5,16 7,0 37,7 38,9 39,3 37,6 38,1 39,2 40,0 38,69 0,90 0,90 2,34 8,0 37,6 36,3 34,3 32,5 33,4 31,3 31,9 33,90 2,33 2,33 6,87 9,0 38,0 36,1 34,4 35,2 35,9 36,4 34,5 35,79 1,25 1,25 3,48 10,0 32,5 33,1 33,9 34,9 32,5 34,6 31,6 33,30 1,21 1,21 3,64 11,0 31,7 32,9 34,1 36,5 35,5 36,3 34,9 34,56 1,78 1,78 5,14 12,0 39,4 39,8 35,4 39,8 36,7 34,8 35,1 37,29 2,31 2,31 6,19 13,0 39,9 38,5 35,6 32,9 40,6 32,3 37,7 36,79 3,28 3,28 8,92 14,0 37,4 38,5 37,4 32,2 36,8 35,8 34,4 36,07 2,15 2,15 5,97
Tabla 5: Imanes Rectangulares INCERTIDUMBRES
¿En qué medida la geometría de los imanes y la separación entre ellos afecta a la velocidad de salida de un acelerador magnético (cañón de Gauss)?
También se calculó la incertidumbre (desviación) estándar de las medidas, la incertidumbre absoluta (considerado el valor máximo entre la desviación estándar y la incertidumbre asociada a la precisión, que en este caso era de 0.1 cm) y la incertidumbre relativa. Todo ello se muestra en las Tablas 5 y 6.
Comparativa entre las distintas geometrías de imanes.
Fuente: elaboración propia.
También se calculó la incertidumbre (desviación) incertidumbre absoluta (considerado el valor máximo estándar y la incertidumbre asociada a la precisión, 0.1 cm) y la incertidumbre relativa. Todo ello se muestra
5.2 REPRESENTACIÓN GRÁFICA DE LOS DATOS OBTENIDOS
A continuación, se representaron los datos en una gráfica comparativa entre los imanes rectangulares y los cilíndricos (Gráfica 1). En ella se añadieron las barras de error correspondientes a la incertidumbre absoluta y líneas de tendencia para cada geometría, indicando sendas ecuaciones de mejor ajuste a dicha línea y su coeficiente de aproximación (R2).

5.2. Representación gráfica de los datos obtenidos A representaron gráfica imanes cilíndricos añadieron correspondientes incertidumbre de tendencia para cada geometría, indicando sendas
Gráfica 1: Comparativa entre las distintas geometrías de imanes
485
SEPARACIÓN (cm) ALCANCE DE LA BOLA (CM) MEDIA (cm) EST. (cm) ABS. (cm) REL. (%) 7,0 55,0 50,9 49,5 48,4 53,5 54,0 50,9 51,74 2,46 2,46 4,76 8,0 55,4 56,2 56,3 56,6 57,0 57,1 55,8 56,34 0,62 0,62 1,09 9,0 49,6 55,3 55,9 50,6 51,0 54,9 52,6 52,84 2,54 2,54 4,80 10,0 55,2 56,3 55,5 57,4 56,7 53,8 55,2 55,73 1,18 1,18 2,12 11,0 54,3 57,4 56,4 57,2 56,8 53,9 57,5 56,21 1,50 1,50 2,66 12,0 54,9 57,5 57,9 56,8 55,7 56,3 53,3 56,06 1,59 1,59 2,84 13,0 52,7 52,1 54,7 54,1 51,8 53,0 52,6 53,00 1,05 1,05 1,98 14,0 52,3 52,9 55,2 51,5 52,9 52,5 52,3 52,80 1,16 1,16 2,20
Tabla 6: Imanes cilíndricos INCERTIDUMBRES
ajuste a dicha línea y su coeficiente de aproximación 11,0 31,7 32,9 34,1 36,5 35,5 36,3 34,9 34,56 12,0 39,4 39,8 35,4 39,8 36,7 34,8 35,1 37,29 13,0 39,9 38,5 35,6 32,9 40,6 32,3 37,7 36,79 14,0 37,4 38,5 37,4 32,2 36,8 35,8 34,4 36,07 Tabla 6: Imanes
Separación (cm) Alcance de la bola (cm) MEDIA (cm) 7,0 55,0 50,9 49,5 48,4 53,5 54,0 50,9 51,74 8,0 55,4 56,2 56,3 56,6 57,0 57,1 55,8 56,34 9,0 49,6 55,3 55,9 50,6 51,0 54,9 52,6 52,84 10,0 55,2 56,3 55,5 57,4 56,7 53,8 55,2 55,73 11,0 54,3 57,4 56,4 57,2 56,8 53,9 57,5 56,21 12,0 54,9 57,5 57,9 56,8 55,7 56,3 53,3 56,06 13,0 52,7 52,1 54,7 54,1 51,8 53,0 52,6 53,00 14,0 52,3 52,9 55,2 51,5 52,9 52,5 52,3 52,80
cilíndricos
Gráfica 01
cada geometría, indicando sendas ecuaciones de mejor coeficiente de aproximación (R2).
datos obtenidos
CERTAMEN JÓVENES INVESTIGADORES / Ciencias Físicas, Químicas y Matemáticas
hipótesis inicial, se puede apreciar que la distancia recorrida utilizan los imanes cilíndricos. Esto se deba a que su localización de los polos magnéticos hace que tanto la energía momento lineal se transmitan con mayor eficacia.
5.3 ANÁLISIS DE LOS DATOS OBTENIDOS
De acuerdo con la hipótesis inicial, se puede apreciar que la distancia recorrida es mayor cuando se utilizan los imanes cilíndricos. Esto se deba a que su geometría y localización de los polos magnéticos hace que tanto la energía cinética como el momento lineal se transmitan con mayor eficacia.
Sin embargo, podemos observar en la Gráfica 1 que el coeficiente de aproximación dista mucho de ser el idóneo, lo que hace pensar que muy probablemente, las funciones que vemos en la gráfica no sean las de mejor ajuste. Evidentemente, aumentar el orden de la función hace que esta se ajuste mejor, pero dicha mejoría apenas es perceptible y, a pesar de todo, sigue estando muy lejos de un coeficiente de aproximación aceptable.
Hierro en polvo esparcido por un papel blanco encima de los imanes colocados con los polos enfrentados. Fuente: elaboración propia.
4.2 CAUSA DE ERRORES
podemos observar en la Gráfica 1 que el coeficiente de mucho de ser el idóneo, lo que hace pensar que muy funciones que vemos en la gráfica no sean las de mejor aumentar el orden de la función hace que esta se ajuste mejoría apenas es de todo, sigue estando coeficiente de aproximación errores obtenidos no mostraban lógica, se dedujo que hubiera cometido algún tipo de error. Se planteó la hipótesis de los imanes en el propio raíl fuera algo relevante, algo en ninguna de las fuentes.
Dado que los datos obtenidos no mostraban una correlación lógica, se dedujo que probablemente se hubiera cometido algún tipo de error. Se planteó la hipótesis de que la orientación de los imanes en el propio raíl fuera algo relevante, algo que no se mencionaba en ninguna de las fuentes.
Se planteo que tal vez la cercanía entre los imanes afectara al campo magnético, y para comprobar si era así se utilizaron limaduras de hierro sobre un folio blanco para poder ver las líneas de campo magnético. Se esperaba encontrar


vez la cercanía entre los imanes afectara al campo comprobar si era así se hierro sobre un folio las líneas de campo esperaba encontrar que los tres sus propias líneas de entre sí, sin embargo, lo que se muestra en la puede apreciar claramente como el campo magnético entre
Esquema de la colocación incorrecta de los imanes. Fuente: elaboración propia.
30º
486
Figura 11: Esquema de la colocación incorrecta de los imanes (fuente propia)
Figura 10
Figura 11
¿En qué medida la geometría de los imanes y la separación entre ellos afecta a la velocidad de salida de un acelerador magnético (cañón de Gauss)?
comprobar si era así se hierro sobre un folio las líneas de campo esperaba encontrar que los tres sus propias líneas de entre sí, sin embargo, lo lo que se muestra en la puede apreciar claramente como el campo magnético entre homogéneo. La orientación de los polos en ese momento se de la Figura 11.
que los tres imanes generaban sus propias líneas de campo independientes entre sí, sin embargo, lo que se descubrió fue lo que se muestra en la Figura 10.
En dicha figura se puede apreciar claramente como el campo magnético entre los imanes no es homogéneo. La orientación de los polos en ese momento se muestra en el esquema de la Figura 11.


Esto provocaba que las líneas de campo que entraban en el polo sur del primer imán no fueran sólo las de su propio polo norte, sino también las del polo norte del segundo. Lógicamente, esto estaba afectando a las medidas, pues cada vez que se ampliaba la distancia entre imanes había que desmontarlos y volverlos a montar, lo que se estaba haciendo sin ningún tipo de control sobre la orientación de estos. De modo que, ante la evidencia de que el campo magnético se estaba viendo afectado, se decidió repetir las medidas con los imanes cilíndricos antes de continuar con la investigación, pues eran los que previamente habían demostrado ser más aptos para la eficiencia del acelerador.
líneas de campo que entraban en el polo sur del primer de su propio polo norte, sino también las del polo norte Lógicamente, esto estaba afectando a las medidas, pues cada la distancia entre imanes había que desmontarlos y que se estaba haciendo sin ningún tipo de control sobre estos. De modo que, ante la evidencia de que el campo viendo afectado, se decidió repetir las medidas con los antes de continuar con la investigación, pues eran los que demostrado ser más aptos acelerador.
5.4.1. NUEVA TOMA DE DATOS Y TRATAMIENTO DE LOS MISMOS
Habiendo colocado los imanes cilíndricos correctamente, es decir, con todos los polos norte en el mismo sentido, y tras comprobar que el campo magnético intermedio era homogéneo (Figura 12), se procedió a volver a tomar las medidas anteriores, sobre las que se calculó la media y sus respectivas incertidumbres. Todo siguiendo el procedimiento indicado previamente. Los datos, con todas las medidas e incertidumbres se muestran en la Tabla 8.
Hierro en polvo esparcido por un papel blanco encima de los imanes colocados con los polos enfrentados. Fuente: elaboración propia.
toma de datos y tratamiento de los mismos
los imanes cilíndricos decir, con todos los polos sentido, y tras comprobar magnético intermedio era homogéneo (Figura 12), se procedió a medidas anteriores, sobre las que se calculó la media y sus incertidumbres. Todo siguiendo el procedimiento indicado , con todas las medidas e incertidumbres se muestran
Seguidamente, se procedió a calcular la velocidad de salida de las bolas metálicas para esta configuración de imanes (recordemos que ya se comprobó que los imanes rectangulares no eran los idóneos para este análisis). Para ello, se convirtieron todas las medidas a la misma unidad (metros).
487
: Imanes Cilíndricos INCERTIDUMBRES Alcance de la bola (cm) MEDIA (cm) EST. (cm) ABS. (cm) REL. (%)
Figura 11: Esquema de la colocación incorrecta de los imanes (fuente propia)
Figura 12
30º CERTAMEN JÓVENES INVESTIGADORES / Ciencias Físicas,
Seguidamente, se procedió a calcular la velocidad de salida de las bolas metálicas para esta configuración de imanes (recordemos que ya se comprobó que los imanes rectangulares no eran los idóneos para este análisis). Para ello, se convirtieron todas las medidas a la misma unidad (metros)
Para calcular la velocidad, se utilizaron las fórmulas de caída libre
Para calcular la velocidad, se utilizaron las fórmulas de caída libre y de movimiento rectilíneo uniforme

( ) y de movimiento rectilíneo uniforme ( ). Dado que la velocidad inicial tiene como única componente la horizontal, se despejó t en la segunda ecuación y se sustituyó en la primera. Entonces se despejó la velocidad
Seguidamente, se procedió metálicas para esta configuración que los imanes rectangulares se convirtieron todas las medidas
Para calcular la velocidad, ( ) y de movimiento que la velocidad inicial tiene en la segunda ecuación y velocidad


Dado que la velocidad inicial tiene como única componente la horizontal, se despejó t en la segunda ecuación y se sustituyó en la primera. Entonces se despejó la velocidad en la ecuación resultante y se aplicó en la Tabla 9. También se calcularon las incertidumbres relativas y absolutas de las velocidades.
en la ecuación resultante y se aplicó en la Tabla 9. También se calcularon las incertidumbres relativas y absolutas de las velocidades.
en la ecuación resultante aplicó en la Tabla 9 También calcularon las incertidumbres relativas y absolutas de velocidades.
5.4.2. Nueva representación
5.4.2. Nueva representación gráfica
Estos nuevos datos se representaron en una gráfica, añadiendo la línea de tendencia y su coeficiente de aproximación, así como la ecuación de dicha línea. Como se puede comprobar, en este caso la función de mejor ajuste tiene un coeficiente de aproximación más aceptable, por lo que se deduce que efectivamente la orientación de los polos era un factor relevante.
5.4.2. NUEVA REPRESENTACIÓN GRÁFICA
en este caso la función de más aceptable, por lo que polos era un factor relevante.
Estos nuevos datos se representaron en una gráfica, añadiendo la línea de tendencia y su coeficiente de aproximación, así como la ecuación de dicha línea. Como se puede comprobar, en este caso la función de mejor ajuste tiene un
5.4.3. Nuevo análisis de datos
Tal y como se puede apreciar en la gráfica previa, los datos se ajustan a una función
5.4.3. Nuevo datos

Tal y como se puede apreciar previa, los datos se ajustan polinómica de orden

488
Químicas y Matemáticas
SEPARACIÓN (cm) ALCANCE DE LA BOLA (CM) MEDIA (cm) EST. (cm) ABS. (cm) REL. (%) 7,0 47,6 51,3 50,6 50,1 48,7 49,8 51,3 49,91 1,37 1,37 2,74 8,0 53,6 52,0 52,6 53,4 53,6 51,9 50,8 52,56 1,06 1,06 2,01 9,0 54,7 54,1 53,6 54,6 55,2 56,5 53,3 54,57 1,07 1,07 1,97 10,0 54,8 53,3 52,4 50,5 54,9 54,8 54,2 53,56 1,64 1,64 3,05 12,0 52,4 54,0 54,4 52,0 53,1 52,5 50,9 52,76 1,20 1,20 2,27 14,0 50,6 50,3 50,8 51,2 48,5 51,3 49,0 50,24 1,08 1,08 2,16
IMANES
MEDIDAS Separación (m) 0,07 0,08 0,09 0,10 0,12 0,14 Alcance medio (m) 0,499 0,526 0,546 0,536 0,528 0,502 abs. (m) 0,014 0,011 0,011 0,016 0,012 0,011 Rel. (%) 2,74 2,01 1,97 3,05 2,27 1,131 1,191 1,237 1,214 1,196 0,070 0,054 0,055 0,084 0,061 6,18 4,57 4,47 6,88 5,14
Tabla 8: Imanes cilíndricos INCERTIDUMBRES
Tabla 9
CILÍNDRICOS
3.
Tabla
Imanes cilíndricos Medidas Separación (m) 0,07 0,08 0,09 0,10 0,12 0,14 Alcance medio (m) 0,499 0,526 0,546 0,536 0,528 0,502 Err. abs. (m) 0,014 0,011 0,011 0,016 0,012 0,011 Rel. (%) 2,74 2,01 1,97 3,05 2,27 2,16 Velocidad (m/s) 1,131 1,191 1,237 1,214 1,196 1,139 Err. abs. (m/s) 0,070 0,054 0,055 0,084 0,061 0,056 rel. (%) 6,18 4,57 4,47 6,88 5,14 4,90
9
la velocidad, se utilizaron las fórmulas de caída libre
relativas y absolutas de las velocidades.


¿En qué medida la geometría de los imanes y la separación entre ellos afecta a la velocidad de salida de un acelerador magnético (cañón de Gauss)?
) y de movimiento rectilíneo uniforme ( ). Dado inicial tiene como única componente la horizontal, se despejó t ecuación y se sustituyó en la primera. Entonces se despejó la resultante y se Tabla 9. También se incertidumbres absolutas de las
5.4.2. Nueva representación gráfica
coeficiente de aproximación más aceptable, por lo que se deduce que efectivamente la orientación de los polos era un factor relevante.
5.4.2. Nueva representación gráfica

5.4.3. NUEVO ANÁLISIS DE DATOS
Estos nuevos representaron añadiendo la línea su coeficiente así como la ecuación línea. Como se en este caso la función de mejor ajuste tiene un coeficiente más aceptable, por lo que se deduce que efectivamente la polos era un factor relevante.
Estos nuevos datos se representaron en una gráfica, añadiendo la línea de tendencia y su coeficiente de aproximación, así como la ecuación de dicha línea. Como se puede comprobar, función de mejor ajuste tiene un coeficiente de aproximación por lo que se deduce que efectivamente la orientación de los actor relevante.
5.4.3. Nuevo análisis de datos
Tal y como se puede apreciar en la gráfica previa, los datos se ajustan a una función polinómica de orden 3. Esto fue una sorpresa, dado que se esperaba que tuvieran una correlación lineal, o cuando menos, exponencial. Podría discutirse elevar el orden para conseguir mejor ajuste, pero entonces la correlación entre separación y velocidad sería demasiado complicada como para predecirla. Si se presta suficiente atención a la forma de la línea de tendencia de la última gráfica, se puede apreciar como tiene un cierto parecido con la forma indicada en la figura 13. Inicialmente se comporta como una parábola, pero una vez pasado el vértice de esta, comienza a decaer exponencialmente.
Consecuentemente, se puede formular la siguiente hipótesis (ver Figura 13): tal vez existe una separación óptima en la que la velocidad de salida es máxima (máximo absoluto: punto A) y después de esa separación entre imanes la velo cidad va disminuyendo (zona B) según una función potencial. Evidentemente, la separación no puede ser infinita, pero, aunque pudiera, el rozamiento entre


5.4.3. Nuevo análisis de datos puede apreciar en la gráfica datos se ajustan a una función orden 3. Esto fue una que se esperaba que correlación lineal, o cuando exponencial. Podría discutirse orden para conseguir mejor entonces la correlación entre velocidad sería demasiado como para predecirla. Si se
Tal y como se puede apreciar en la gráfica previa, los datos se ajustan a una función polinómica de orden 3. Esto fue una sorpresa, dado que se esperaba que tuvieran una correlación lineal, o cuando menos, exponencial. Podría discutirse elevar el orden para conseguir mejor ajuste, pero entonces la correlación entre separación y velocidad sería demasiado complicada como para predecirla. Si se
489
Alcance medio (m) 0,499 0,526 Err. abs. (m) 0,014 0,011 Rel. (%) 2,74 2,01 Velocidad (m/s) 1,131 1,191 Err. abs. (m/s) 0,070 0,054 rel. (%) 6,18 4,57
Figura 13: Esquema de propia
Tabla 9 Imanes cilíndricos Medidas Separación (m) 0,07 0,08 0,09 0,10 0,12 0,14 Alcance medio (m) 0,499 0,526 0,546 0,536 0,528 0,502 Err. abs. (m) 0,014 0,011 0,011 0,016 0,012 0,011 Rel. (%) 2,74 2,01 1,97 3,05 2,27 2,16 Velocidad (m/s) 1,131 1,191 1,237 1,214 1,196 1,139 Err. abs. (m/s) 0,070 0,054 0,055 0,084 0,061 0,056 rel. (%) 6,18 4,57 4,47 6,88 5,14 4,90
Figura 13: Esquema de la función de la hipótesis (fuente propia
Figura 13
Esquema de la función de la hipotésis.
Fuente: elaboración propia.
CERTAMEN JÓVENES INVESTIGADORES / Ciencias Físicas, Químicas y Matemáticas
las bolas de metal y el raíl haría que estas se fueran frenando y por lo tanto no llegarían al siguiente imán con la velocidad suficiente como para romper la barrera de potencial y liberar la siguiente bola. Por ello, habría un punto C en el que se contraría la función, pues habría demasiada pérdida de energía cinética y la bola final no saldría del cañón.
6. CONCLUSIONES
Finalmente, se concluyó que, ante la evidencia, debía haber una separación idónea entre imanes que permitiera una mayor aceleración de la última bola. También se observó que, una vez sobrepasado esa separación, la velocidad de salida disminuye (se cree que de manera exponencial) dado que la fuerza de rozamiento actúa durante más tiempo, haciendo que se pierda energía cinética en forma de calor. Ello conllevará que, a grandes separaciones entre imanes, llegue un punto en el que se pierda tanta energía cinética que la que se transmite a la siguiente bola metálica no sea suficiente para romper la barrera de potencial generada por el imán.
Se ha podido comprobar que la geometría cilíndrica es de mayor eficacia y se descubrió que la orientación de los imanes es de especial relevancia, pues altera completamente el resultado del trabajo.
Posibles mejoras a la investigación incluyen el uso de imanes de neodimio de mayor tamaño, de modo que no hubiera la necesidad de juntar cuatro para formar cada “paquete”, y la posibilidad de usar distintas intensidades. Se intentó tomar medidas con tres imanes por “paquete” en vez de cuatro, pero el agarre de los imanes al raíl no era el adecuado dado que eran demasiado finos.
30º
490
¿En qué medida la geometría de los imanes y la separación entre ellos afecta a la velocidad de salida de un acelerador magnético (cañón de Gauss)?
7. BIBLIOGRAFÍA
Bleaney, B. y Kashy, E., Magnetism: Induced and permanent atomic magnetic dipoles. Encyclopædia Britannica. Disponible en: https://www.britannica.com/science/magnetism/Induced-and-permanent-atomic-magnetic-dipoles [Consultado el 28 Dec. 2018].
Homer, D. y Bowen-Jones, M., 2014. Physics: Course Companion. Oxford University Press.
Hubert, A. y Schäfer, R., 2008. Magnetic domains: the analysis of magnetic microstructures. Springer Science & Business Media.
Souza, J.A. y Jardim, R.F., 2009. Electrical transport in disordered and ordered magnetic domains under pressures and magnetic fields. Journal of Physics D: Applied Physics, 42(3), p.032006.
Stern, David P., 2004. Líneas Del Campo Magnético. NASA. Disponible en: https://www-spof.gsfc.nasa.gov/Education/Mfldline.html [Consultado el 3 Ene. 2019]
Anon, OSCAR, física visual a un click. Universidad Complutense de Madrid. Disponible en: https://www.ucm.es/theoscarlab/canon-de-Gauss [Consultado el 22 Dec. 2018].
Anon, Q & A: How do magnets work? Q & A: How do magnets work? | Department of Physics | University of Illinois at Urbana-Champaign. Disponible en: https://van.physics.illinois.edu/qa/listing.php?id=434 [Consultado el 28 Dec. 2018].
491
Estudio del tratamiento tradicional del caqui “rojo brillante”:
/ TERCER PREMIO
AUTORA | SOFÍA LLÀCER CARO
COORDINADORA | MARÍA ROSA MONTSERRAT JOVER
CENTRO | IES PERE BOÏL
CIUDAD | MANISES-VALENCIA
RESUMEN |
Mi familia es originaria de Alcàsser, un pequeño pueblo ubicado en la Huerta Valenciana, y se ha dedicado tradicionalmente a las actividades agrícolas. Hace cerca de 15 años, mi abuelo supo por otros compañeros del oficio de la existencia de una variedad de caqui de nueva plantación denominada “Rojo Brillante”. Se interesó entonces por este fruto e hizo crecer un árbol para consumo doméstico. Sin embargo, la variedad requería de un tratamiento tras la cosecha para poder ser consumido con normalidad, ya que, de lo contrario, su gusto resulta astringente.
El método tradicional consiste en introducir en un recipiente grande cerrado herméticamente un vaso pequeño con alrededor de 0,15 dm3 de alcohol junto con unos 8 caquis. A continuación, debe dejarse reposar de 3 a 8 días. Recientemente, mi padre y yo comenzamos a realizar el tratamiento. Fue así como decidí darle una razón científica al proceso que había visto hacer a mi familia desde que soy pequeña. Además, he orientado también mi investigación a conocer si la graduación del alcohol utilizado para el tratamiento tradicional del caqui guarda algún tipo de relación con tiempo de tratamiento necesario para eliminar su astringencia
ABSTRACT |
My family comes from Alcàsser, a small village located in the valencian county side, and has been traditionally dedicated to agricultural activities. About 15 years ago, my grandfather got to know about the existence of a new variety of kaki named “Rojo Brillante” and grew a tree for the household consumption of this fruit. For the purpose of making it edible, the fruit has to overcome a treatment that was carried in the traditional way for years in my family. This treatment consists of putting a small glass of alcohol (around 0,15 dm3) as well as about 8 kakis into a sealed container between 3 and 8 days. The aim of this research is to study the chemical processes behind this traditional treatment.
¿Cuál es la relación entre la graduación del alcohol utilizado para el tratamiento y el tiempo requerido para eliminar la astringencia?
493
CIENCIAS FÍSICAS, QUÍMICAS Y MATEMÁTICAS
CERTAMEN JÓVENES INVESTIGADORES / Ciencias Físicas,
Químicas y Matemáticas
1. INTRODUCCIÓN
Mi familia es originaria de Alcàsser, un pequeño pueblo ubicado en la Huerta Valenciana (España), y se ha dedicado tradicionalmente a las actividades agrícolas, como el cultivo de la naranja. Hace cerca de 15 años, mi abuelo supo por otros compañeros del oficio de la existencia de una variedad de caqui de nueva plantación denominada “Rojo Brillante”. Esta variedad, que todavía no era cultivada en grandes extensiones, comenzó a plantarse en los márgenes de los campos de naranjos. Mi abuelo se interesó por este fruto e hizo crecer un árbol para consumo doméstico. Sin embargo, el fruto requería de un tratamiento tras la cosecha para poder ser consumido con normalidad, ya que, de lo contrario, su gusto resulta astringente. Junto a las semillas, mi abuelo recibió varios consejos para el tratamiento poscosecha del caqui. El principal método utilizado era su tratamiento con alcohol.
El método consiste en introducir en un recipiente grande cerrado herméticamente un vaso pequeño con alrededor de 0,15 dm3 de alcohol, junto con unos 8 caquis. A continuación, debe dejarse reposar de 3 a 8 días.
Al principio tuvimos varios problemas a la hora de elegir el alcohol con el que proceder al tratamiento. Primero, utilizamos alcohol sanitario, puesto que era más puro. Sin embargo, los caquis no tenían buen sabor y no pudieron ser consumidos. A continuación, probamos con diversos alcoholes etílicos de diferente graduación, como la cazalla o el ron, con los que obtuvimos pequeños matices de sabor. En general, se suele utilizar el licor destilado que se encuentre disponible sin necesidad de adquirir una botella con este propósito específico.
Con el paso del tiempo, se ha plantado cada vez más cantidad de árboles. En la actualidad, la mayor parte de la producción va destinada a la cooperativa agrícola del pueblo, donde el tratamiento poscosecha se lleva a cabo mediante otros métodos a nivel industrial (Besada, Navarro, Vendrell, & Salvador, 2015, pág. 313). Aun así, una pequeña parte de la producción todavía es destinada al consumo doméstico. Recientemente, mi padre y yo comenzamos a realizar el tratamiento. Fue así como decidí darle una razón científica al proceso que había visto hacer a mi familia desde que soy pequeña. Además, he orientado también mi investigación a conocer si la graduación del alcohol utilizado para el tratamiento tradicional del caqui guarda algún tipo de relación con tiempo de tratamiento necesario para eliminar su astringencia.
Preguntas previas a la investigación: ¿Cuál es la sustancia que provoca la astringencia del caqui?, ¿cuál es la reacción que tiene lugar entre estas sustancias y el alcohol para que el fruto deje de ser astringente?
Pregunta de investigación: ¿Cuál es la relación entre la graduación del alcohol utilizado para el tratamiento y el tiempo requerido para eliminar la astringencia del caqui “Rojo Brillante”?
30º
494
Estudio del tratamiento tradicional del caqui “rojo brillante”: ¿Cuál es la relación entre la graduación del alcohol utilizado para el tratamiento y el tiempo requerido para eliminar la astringencia?
Hipótesis: La hipótesis inicial fue que ambas variables sí que estaban relacionadas. En principio, se propuso que una mayor graduación del alcohol contribuiría a que el tratamiento se produjese en un menor tiempo.
2. CUERPO
2.1 CONTEXTO CIENTÍFICO
En primer lugar, se realizó una investigación en el contexto científico con tal de conocer cuál es la sustancia que provoca la astringencia del caqui “Rojo Brillante” (Dysprosius Kaki), para poder responder a la primera pregunta previa a la investigación. El resultado encontrado fue que los agentes químicos que provocan la astringencia del fruto son los “taninos”, compuestos polifenólicos que se encuentran presentes en numerosas especies del reino vegetal (Álvarez & Lock de Ugaz, 1992).
En concreto, se trata de taninos solubles o hidrolizables (principalmente ácido gálico), que se encuentran en las vacuolas de las células tánicas presentes en la pulpa del fruto. Estos compuestos, en contacto con las proteínas salivares, forman complejos insolubles. Son dichos complejos los que disminuyen la lubricación salivar y provocan una sensación de astringencia (Besada, et al., 2015, p. 307).
El tratamiento tradicional se basa en la receptividad del fruto al ser expuesto a etanol exógeno tras la recolección (Besada, et al., 2010, p. 301). Esta exposición induce la maduración del fruto, ya que provoca una reacción química entre los taninos y el alcohol etílico.
A continuación, nos dispusimos a responder a la segunda pregunta previa a la investigación: ¿Cuál es la reacción que tiene lugar entre los taninos y el alcohol para que el fruto deje de ser astringente?
Desgraciadamente, tras realizar una búsqueda de información para conocer la reacción, no se encontró bibliografía al respecto por dos motivos principales: la gran variedad de taninos existente y la falta de contexto relacionado con el tema tratado.
Con lo cual, se asumió que la mayor parte de los taninos que provocan la astringencia en el caso del caqui estaban conformados por ácido gálico (Besada, et al., 2015, p. 305), para poder así expresar en rasgos generales la reacción química que tiene lugar: al tratarse de un ácido carboxílico y un alcohol, deduje que podría tratarse de una reacción de esterificación (Talbot, et al., 2015, p. 340):
495
CERTAMEN JÓVENES INVESTIGADORES / Ciencias Físicas, Químicas y Matemáticas
2.2. COMPROBACIÓN EXPERIMENTAL PREVIA
Antes de seguir adelante con la investigación a nivel cuantitativo, se decidió llevar a cabo una valoración cualitativa con tal de confirmar si los taninos hidrolizables eran los que provocaban la astringencia.
Según indicaba el contexto científico, los caquis más astringentes (fases iniciales o previa al tratamiento) deberían de contar con una mayor concentración de taninos que los que habían sido sometido al tratamiento.
Teniendo en cuenta que los taninos hidrolizables toman un color azul oscuro al entrar en contacto con sales férricas (Álvarez & Lock de Ugaz, 1992) (Muñoz Pinto, 2016, p. 7), se llevó a cabo una titulación con FeCl3·6H2O al 5% para comprobar si se cumplía la relación expuesta anteriormente. Los resultados fueron los esperados, lo que permitió llevar adelante la investigación, tal y como se muestra en la figura (izquierda, caqui sin tratar; derecha, caqui sometido a tratamiento).
2.3. DESARROLLO
2.3.1. MÉTODO EXPERIMENTAL
Tras haber comprobado de forma cualitativa lo anterior, nos propusimos responder a la pregunta central de investigación: ¿Cuál es la relación matemática entre la graduación del alcohol utilizado para el tratamiento y el tiempo requerido para eliminar la astringencia del fruto?

30º
496
hidrolizables toman un con sales férricas
Pinto, 2016, p. 7), se FeCl3·6H2O al 5% para expuesta anteriormente. que permitió llevar muestra en la figura caqui sometido a
cualitativa lo anterior, nos propusimos
graduación del alcohol utilizado para el tratamiento y el eliminar la astringencia del fruto?
2.3.1. MÉTODO EXPERIMENTAL
Estudio del tratamiento tradicional del caqui “rojo brillante”: ¿Cuál es la relación entre la graduación del alcohol utilizado para el tratamiento y el tiempo requerido para eliminar la astringencia?
Tras haber comprobado de forma cualitativa lo anterior, nos propusimos responder a la pregunta central de investigación: ¿Cuál es la relación matemática entre la graduación del alcohol utilizado para el tratamiento y el tiempo requerido para eliminar la astringencia del fruto?
investigación se desarrolló en base a la siguiente relación en el contexto científico (Hart & Fisher, 1984): realizarse un seguimiento de la concentración de lo largo del tiempo para alcoholes de diferente cabo una reacción redox entre los taninos solubles conformados en su mayoría por ácido gálico) (Besada, et al., para responder a la pregunta de investigación.


El método de investigación se desarrolló en base a la siguiente relación estequiométrica obtenida en el contexto científico (Hart & Fisher, 1984):
El método de investigación se desarrolló en base a la siguiente relación estequiométrica obtenida en el contexto científico (Hart & Fisher, 1984):
Esto indicaba que podía realizarse un seguimiento de la concentración de taninos en los caquis a lo largo del tiempo para alcoholes de diferente graduación llevando a cabo una reacción redox entre los taninos solubles (asumimos que conformados en su mayoría por ácido gálico) (Besada, et al., 2015, p. 305) y el KMnO4 para responder a la pregunta de investigación.
Esto indicaba que podía realizarse un seguimiento de la concentración de taninos en los caquis a lo largo del tiempo para alcoholes de diferente graduación llevando a cabo una reacción redox entre los taninos solubles (asumimos que conformados en su mayoría por ácido gálico) (Besada, et al., 2015, p. 305) y el KMnO4 para responder a la pregunta de investigación.
La primera parte del método experimental consistió en someter los caquis al tratamiento. Para ello, se recolectaron los frutos directamente de los campos de mi familia.
La primera parte del método experimental consistió en someter los caquis al tratamiento. Para ello, se recolectaron los frutos directamente de los campos de mi familia.
método experimental consistió en someter los caquis al recolectaron los frutos directamente de los campos de laboratorio, se mediante el cual modo tradicional tal y como se continuación (se concentraciones introducir una cuarta parte de un caqui junto con 5·10-3 de precipitados de 0’600 dm3 de capacidad.
A continuación, ya en el laboratorio, se llevó a cabo un montaje mediante el cual se pretendía imitar el modo tradicional de realizar el tratamiento, tal y como se muestra en la figura a continuación (se utilizó alcohol etílico a concen traciones del 30%, 50%, 70% y 85%.
A continuación, ya en el laboratorio, se llevó a cabo un montaje mediante el cual se pretendía imitar el modo tradicional de realizar el tratamiento, tal y como se muestra en la figura a continuación (se utilizó alcohol etílico a concentraciones del 30%, 50%, 70% y 85%.
El montaje consistió en introducir una cuarta parte de un caqui junto con 5·10-3 dm3 de alcohol en un vaso de precipitados de 0’600 dm3 de capacidad.
Sin embargo, se modificaron algunos aspectos con respecto al método tradicional con tal de llevar a cabo un estudio más riguroso:
El montaje consistió en introducir una cuarta parte de un caqui junto con 5·10-3 dm3 de alcohol en un vaso de precipitados de 0’600 dm3 de capacidad.
Sin embargo, se modificaron algunos aspectos con respecto al método tradicional con tal de llevar a cabo un estudio más riguroso:
modificaron algunos aspectos con respecto al método a cabo un estudio más riguroso:
• Se trató cada muestra por separado para no alterar la concentración de alcohol en el ambiente con la apertura del recipiente en cada valoración.
• No se introdujo el caqui entero para el tratamiento, sino que se cortó el caqui en 4 trozos para utilizar el mínimo número posible de frutos y reducir la variabili-
497
- Se trató cada muestra por separado para no alterar la concentración de alcohol en el ambiente con la apertura del recipiente en cada valoración.
CERTAMEN JÓVENES INVESTIGADORES / Ciencias Físicas, Químicas y
Matemáticas
- No se introdujo el caqui entero para el tratamiento, sino que se cortó el caqui en 4 trozos para utilizar el mínimo número posible de frutos y reducir la variabilidad genética. Se cubrió la superficie cortada con papel de film, dejando al descubierto la superficie que mantenía la piel.
dad genética. Se cubrió la superficie cortada con papel de film, dejando al descubierto la superficie que mantenía la piel.
- Se selló herméticamente el recipiente usando papel de film. Puesto que no se consiguió ningún tipo de “tapa” para los vasos de precipitados, se utilizó este medio para mantener el sistema químico cerrado.
• Se selló herméticamente el recipiente usando papel de film. Puesto que no se consiguió ningún tipo de “tapa” para los vasos de precipitados, se utilizó este medio para mantener el sistema químico cerrado.
Con tal de responder a la pregunta de investigación, debía realizarse un seguimiento de la concentración de taninos en diferentes etapas del tratamiento para diferentes alcoholes:
Con tal de responder a la pregunta de investigación, debía realizarse un seguimiento de la concentración de taninos en diferentes etapas del tratamiento para diferentes alcoholes:
Como punto de partida, se determinó la concentración de taninos de un caqui que no había sido sometido a tratamiento (en adelante, “Día 0”).
Como punto de partida, se determinó la concentración de taninos de un caqui que no había sido sometido a tratamiento (en adelante, “Día 0”).
El tiempo transcurrido entre cada fase fue de 24h. El primer día, se determinó la cantidad de taninos para cada uno de los alcoholes (de 30%, 50%, 70% y 85%) con el objetivo de realizar un seguimiento de la concentración de taninos. Lo mismo se hizo en los días 2 y 3. Cabe apuntar que el tratamiento se detuvo el día 3 (incluyendo este último) porque en este día, los valores de concentración de taninos ya rondaban el 0 % en masa, y eran muy parecidos en cada una de las muestras. A partir de lo anterior, se dedujo que se había terminado el tratamiento, y se decidió dejar de realizar las valoraciones.
El tiempo transcurrido entre cada fase fue de 24h. El primer día, se determinó la cantidad de taninos para cada uno de los alcoholes (de 30%, 50%, 70% y 85%) con el objetivo de realizar un seguimiento de la concentración de taninos. Lo mismo se hizo en los días 2 y 3. Cabe apuntar que el tratamiento se detuvo el día 3 (incluyendo este último) porque en este día, los valores de concentración de taninos ya rondaban el 0 % en masa, y eran muy parecidos en cada una de las muestras. A partir de lo anterior, se dedujo que se había terminado el tratamiento, y se decidió dejar de realizar las valoraciones.
La determinación de la concentración de taninos para realizar un seguimiento del efecto de cada alcohol se llevó a cabo mediante una valoración volumétrica, la segunda parte del método experimental. Esta determinación cuantitativa se desarrolló mediante el método volumétrico de Lowenthal (Diaz Yanevich, et al., s.f., p. 2 y 3), basado en una reacción redox entre los taninos y el KMnO4 (disolución preparada anteriormente).
La determinación de la concentración de taninos para realizar un seguimiento del efecto de cada alcohol se llevó a cabo mediante una valoración volumétrica, la segunda parte del método experimental. Esta determinación cuantitativa se desarrolló mediante el método volumétrico de Lowenthal (Diaz Yanevich, et al., s.f., p. 2 y 3), basado en una reacción redox entre los taninos y el KMnO4 (disolución preparada anteriormente).
En la reacción, uno de los grupos alcoholes del ácido gálico se oxidaban por la acción del permanganato de potasio, mientras este segundo experimentaba la

30º
498
Estudio del tratamiento tradicional del caqui “rojo brillante”: ¿Cuál es la relación entre la graduación del alcohol utilizado para el tratamiento y el tiempo requerido para eliminar la astringencia?
reducción, obedeciendo a la relación estequiométrica expresada en la ecuación de la pág. 3.
Los pasos que se siguieron fueron los siguientes:
1. Se pesaron 2’500 ± 0’001 g de caqui.
2. Se trituraron en 0’200 ± 0’001 dm3 de agua destilada para elaborar la muestra.
3. Se llevó a ebullición la muestra durante 30 minutos.
4. Se introdujo la muestra en un matraz aforado de 0,250 dm3 y se enrasó con agua destilada.
5. Se tomaron 0’025 ± 0’002 dm3 de la muestra y se le añadieron 3 gotas de indicador universal de pH.
6. Se valoraron las muestras dejando caer desde la bureta el KMnO4 tomando los datos de los volúmenes necesarios para hacer virar las muestras del verde claro al amarillo.
Cabe apuntar que se usó indicador universal de pH por lo siguiente: En primer lugar, no se contaba con azul índigo en el laboratorio (indicador usado en la investigación que se tomó como ejemplo de la valoración de Lowenthal. En un principio se pensó en no utilizar indicador, porque el KMnO4 cambia de un color púrpura a incoloro al cambiar su estado de oxidación en la reacción (Muñoz Pinto, 2016). Sin embargo, las muestras ya contaban con una cierta coloración, con lo que se pensó que lo mejor sería utilizar un indicador. El elegido fue el indicador universal de pH porque se pensó que en la oxidación del grupo alcohol del ácido gálico (carácter ácido) a una cetona (carácter neutro), el pH cambiaría, y sería fácil apreciar el cambio de color.
Se pretendía obtener los datos para el estudio de la concentración de taninos (variable dependiente) en función del tiempo (variable independiente). Además, se estudiaron las diferencias en el proceso al someter los caquis al tratamiento con alcoholes de diferente graduación. Con el objetivo de realizar un estudio más riguroso, se controlaron determinadas variables como el volumen de alcohol, la temperatura, etc.
2.3.2. DATOS Y ANÁLISIS
Tras ajustar la fórmula original de equivalencia de taninos a nuestro caso concreto, se calculó el porcentaje en masa de taninos en la muestra. Se realizó asimismo una propagación de errores mediante los errores relativos de los instrumentos utilizados en el laboratorio. Los resultados se muestran en la siguiente gráfica:
499
CERTAMEN JÓVENES INVESTIGADORES / Ciencias Físicas, Químicas y Matemáticas
instrumentos utilizados en el laboratorio. Los resultados se muestran en la siguiente gráfica:
3. CONCLUSIÓN Y EVALUACIÓN
3. CONCLUSIÓN Y EVALUACIÓN
En la anterior gráfica se puede observar una tendencia al descenso en la concentración de taninos a medida que aumenta el tiempo de tratamiento (como se había comprobado también en la comprobación experimental previa.
En la anterior gráfica se puede observar una tendencia al descenso en la concentración de taninos a medida que aumenta el tiempo de tratamiento (como se había comprobado también en la comprobación experimental previa.
La pendiente de la recta tangente a la gráfica es menor a medida que disminuye la concentración del alcohol etílico. Es decir, que el tratamiento se completa en un menor tiempo a medida que aumentamos la graduación, ya que aumenta la velocidad de la reacción. En todos los casos partimos de un 0’418 % en masa para el caqui sin tratar. Sin embargo, el ritmo de disminución de la concentración de taninos varía en cada caso: el primer día de tratamiento, la concentración de taninos para el alcohol al 30% se sigue manteniendo relativamente alta en comparación con el resto (0,044% en masa), seguido por el de 50% (0,101% en masa), y luego por el de 70% (0,056% en masa), teniendo una concentración menor el de 85% (0,038% en masa). Esto ocurre de manera paralela en el segundo día de tratamiento: un 0,056% en masa para el alcohol al 30%, un 0,050% en masa para el alcohol al 50%, un 0,021% en masa para el alcohol al 70%, un 0,011% en masa para el alcohol al 85%.
La pendiente de la recta tangente a la gráfica es menor a medida que disminuye la concentración del alcohol etílico. Es decir, que el tratamiento se completa en un menor tiempo a medida que aumentamos la graduación, ya que aumenta la velocidad de la reacción. En todos los casos partimos de un 0’418 % en masa para el caqui sin tratar. Sin embargo, el ritmo de disminución de la concentración de taninos varía en cada caso: el primer día de tratamiento, la concentración de taninos para el alcohol al 30% se sigue manteniendo relativamente alta en comparación con el resto (0,044% en masa), seguido por el de 50% (0,101% en masa), y luego por el de 70% (0,056% en masa), teniendo una concentración menor el de 85% (0,038% en masa). Esto ocurre de manera paralela en el segundo día de tratamiento: un 0,056% en masa para el alcohol al 30%, un 0,050% en masa para el alcohol al 50%, un 0,021% en masa para el alcohol al 70%, un 0,011% en masa para el alcohol al 85%.

Por último, al tercer día de tratamiento todas las muestras rondan valores muy cercanos al 0% en masa de taninos, lo que demuestra que el tratamiento aplicado fue efectivo en todos los casos. Es decir, que la astringencia de los frutos había sido prácticamente eliminada tras tres días de tratamiento en el laboratorio.
Cabe destacar que la disminución de la concentración de taninos fue especialmente acusada el primer día en todos los casos, y el ritmo se fue reduciendo a medida que transcurrieron los días de tratamiento. Tras llevar a cabo una evaluación del coeficiente de correlación con diferentes tipos de funciones, se ha concluido que podemos modelizar la relación entre ambas variables
Por último, al tercer día de tratamiento todas las muestras rondan valores muy cercanos al 0% en masa de taninos, lo que demuestra que el tratamiento aplicado fue efectivo en todos los casos. Es decir, que la astringencia de los frutos había sido prácticamente eliminada tras tres días de tratamiento en el laboratorio.
Cabe destacar que la disminución de la concentración de taninos fue especialmente acusada el primer día en todos los casos, y el ritmo se fue
30º
500
reduciendo
a medida que transcurrieron los días de tratamiento. Tras llevar
a
Estudio del tratamiento tradicional del caqui “rojo brillante”: ¿Cuál es la relación entre la graduación del alcohol utilizado para el tratamiento y el tiempo requerido para eliminar la astringencia?
mediante una función exponencial de exponente negativo, como muestran las ecuaciones presentes de la gráfica. Se ha deducido que la ecuación asociada a la línea de tendencia debería ser la misma en todos los casos. El ajuste matemático mediante una función exponencial cuenta con un coeficiente de correlación entre ambas variables cuyo mínimo valor es 0’8101 (en el caso del alcohol 30%) y cuyo máximo valor alcanza el 0’9736 (en el caso del alcohol de 70%), lo que indicaría una correlación significativa entre ambas variables. Sin embargo, resulta arriesgado afirmar de forma tajante esta relación, puesto que no se ha podido contrastar la información por falta de fuentes bibliográficas al respecto.
En resumen, los datos obtenidos ponen de manifiesto que la relación planteada en la hipótesis se cumple a priori. Sin embargo, resulta muy difícil concluir de forma absoluta por dos razones principales: el error asociado al método experimental y la falta de bibliografía que respalde los resultados obtenidos.
Si bien los datos del volumen de permanganato de potasio requerido en la volumetría son bastante precisos (un bajo error de semidispersión del orden de 10-4 dm3 en la mayoría de los casos), no es posible conocer la exactitud del método ni su desviación, ya que no se han encontrado datos comparables en el contexto científico.
Asimismo, el error de semidispersión presente podría deberse a alguna irregularidad durante el procedimiento experimental. Por ejemplo, podría no haberse triturado bien la muestra antes de realizar la valoración, lo que implicaría que la concentración de taninos en esta presentaría una distribución desigual, pudiendo haber afectado a los resultados.
En todo caso, debemos subrayar que algunas de las valoraciones tuvieron asociado error de semidispersión de 0, lo cual podría deberse a un sesgo de la experimentadora (Shuttleworth, 2019).
Es decir, que la hipótesis de la experimentadora podría haber afectado a las mediciones, al escoger los datos válidos o repetir determinadas pruebas que no se ajustasen al modelo esperado. En este sentido, podemos afirmar que en el método de la valoración existe un mayor riesgo de que tenga lugar este fenómeno. Por lo tanto, sería recomendable utilizar otros métodos a la hora de determinar la concentración de taninos en las muestras en los que el peso de las apreciaciones del experimentador o experimentadora fuese menor, como por ejemplo el espectrómetro de masas.
En cuanto al error relativo, se observa una tendencia al aumento a medida que avanza el día. Esto tiene su explicación en que, en estas fases del tratamiento, se requería de una menor cantidad de KMnO4 para hacer virar la muestra. Con lo cual, al calcular la propagación de errores asociada a la valoración, el cociente resultaba en un valor mayor.
501
CERTAMEN JÓVENES INVESTIGADORES
/ Ciencias Físicas, Químicas y Matemáticas
Sin embargo, resulta evidente que los valores de error relativo son mucho mayores a los del error de semidispersión. Esto se debe en gran medida a que, cuando se realizó el experimento, se desconocían los factores que podían afectar al cálculo de los errores, como, por ejemplo, en lo referente al uso de instrumentos de laboratorio (ver nota al pie 4). Esto se tendrá en cuenta en futuras investigaciones. Además, la gran cantidad de pasos y mediciones contribuyó de forma muy importante al aumento de este error relativo. En futuras investigaciones, sería conveniente desarrollar un método experimental que implicase un menor número de pasos en el procedimiento para minimizar su impacto en la fiabilidad de los datos obtenidos.
Además de esto, existen numerosos factores durante el procedimiento experimental que podrían haber contribuido al aumento de los errores y la incertidumbre con respecto a los resultados finales. En el caso de algunos factores, como por ejemplo en el de la variabilidad genética (a pesar de haberse considerado variable controlada) resulta inevitable que la influencia de éstos sea alta, ya que el presente estudio está basado en seres vivos. Sin embargo, el impacto de otros factores vinculados al método experimental podría reducirse introduciendo algunas mejoras en el procedimiento para la determinación. Algunas de ellas son las siguientes: por un lado, podría haberse controlado de forma más exhaustiva la temperatura y presión ambientales mediante una campana de gases y un termostato, para garantizar que se mantuviesen constantes durante el tratamiento de los caquis. De este modo, se podría realizar una investigación más completa acerca de la velocidad o la cinética de la reacción que se produce entre los taninos y el alcohol.
Por otro lado, debería utilizarse el mismo tipo de alcohol con diferentes concentraciones (se utilizaron diferentes alcoholes: cazalla, licor herbal y absenta en dos concentraciones diferentes), para así garantizar que ésta fuese una variable controlada, y que no interviniesen otras sustancias que pudiesen variar la concentración de taninos y alterar la comparabilidad de los datos.
En definitiva, aunque aparentemente podamos confirmar la hipótesis, sería necesario realizar un estudio más riguroso y contrastado con tal de concluir de forma certera.
502
30º
Estudio del tratamiento tradicional del caqui “rojo brillante”: ¿Cuál es la relación entre la graduación del alcohol utilizado para el tratamiento y el tiempo requerido para eliminar la astringencia?
BIBLIOGRAFÍA Y WEBGRAFÍA
Álvarez, C. & Lock de Ugaz, O., 1992. Taninos. Revista de Química, Junio, VI(1), p.17.
Besada, C., Jackman, R., Olsson, S. & Woolf, A., 2010. Response of "Fuyu" persimmons to ethylene exposure before and during storage. Postharvest Biology Technology.
Besada, C., Navarro, P., Vendrell, M. & Salvador, A., 2015. Tecnología poscosecha del caqui. En: M. L. Badenes Català, D. S. Intrigliolo Molina, A. Salvador Pérez & A. Vicent Civera, edits. El cultivo del caqui. Valencia(Valencia): Generalitat Valenciana, p. 339.
Diaz Yanevich, C., Sánchez, D. & Prokopiuk, D. G. G. S., s.f. Avances en la determinación de la composición química y nutricional de las harinas de los frutos del Prosopis alba, Santa Fe, Argentina: s.n.
Hart, F. L. & Fisher, H. J., 1984. Análisis moderno de los alimentos Ilustrada ed. s.l.:Acribia.
Instituto Nacional de Seguridad e Higiene en el Trabajo, 2004. Fichas Internacionales de Seguridad Química. Cloruro Ferrico (Anhidro)., Madrid: s.n.
Instituto Nacionl de Seguridad e Higinene en el Trabajo, 2003. Ficha Técnica del Permanganato de Potasio, Madrid: s.n.
Muñoz Pinto, F., 2016. Práctica no8. Identificación de grupos funcionales y taninos naturales, Mérida: Laboratorio de química. Ingeniería forestal-Régimen anual.
Shuttleworth, M., 2019. Sesgo de investigación. [En línea] Available at: https://explorable.com/es/sesgo-de-investigacion [Último acceso: 9 Enero 2019].
Talbot, C., Hardwood, R. & Coates, C., 2015. Chemistry. s.l.:Vicens Vives.
503
Colaboran:
ACTAS DEL 31º CONGRESO DE JÓVENES INVESTIGADORES







31

Figura 01
Figura 02
Figura 03
Figura 01
Figura 02
Figura 03








 Figura 07
Tercer modelo de boya.
Figura 10
Trabajando en las piezas de la parte electrónica.
Figura 08
Modelo compacto de boya incorporada en el cuerpo del prototipo
Figura 11
Circuito electrónico para simular el funcionamiento mecánico de las olas.
Figura 09
Sistema piñón-cremallera utilizado para el movimiento vertical del simulador.
Figura 12
Figura 07
Tercer modelo de boya.
Figura 10
Trabajando en las piezas de la parte electrónica.
Figura 08
Modelo compacto de boya incorporada en el cuerpo del prototipo
Figura 11
Circuito electrónico para simular el funcionamiento mecánico de las olas.
Figura 09
Sistema piñón-cremallera utilizado para el movimiento vertical del simulador.
Figura 12

























































































































































